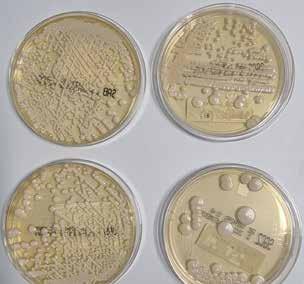

ΘΕΟΔΩΡΟΣ ΚΑΡΟΥΤΖΟΣ ΔΙΕΥΘΥΝΩΝ ΣΥΜΒΟΥΛΟΣ ΟΜΙΛΟΥ AFFIDEA ΑΦΙΕΡΩΜΑ 60 ΣΕΛΙΔΩΝ στα ΔΙΑΓΝΩΣΤΙΚΑ ΚΕΝΤΡΑ Affinity Fidelity Idea ΕΙΔΙΚΗ ΕΚΔΟΣΗ ΓΙΑ ΤΗΝ ΥΓΕΙΑ από το Nextdeal ΟΚΤΩΒΡΙΟΣ - ΝΟΕΜΒΡΙΟΣ 2022



my-Ygeia Νέα εφαρμογή Ο προσωπικός φάκελος υγείας στο κινητό σου. Όλο το ιατρικό σου ιστoρικό από τα νοσοκομεία του Ομίλου online. Σκανάρετε εδώ Σκανάρετε εδώ Mε την αξιοπιστία του Hellenic HealthCare Group www.hhg.gr
σοβαρές χρόνιες
η μη αλκοολική στεατοηπατίτιδα (NASH), η καρδιαγγειακή νόσος και η νόσος Αλτσχάιμερ. Η προσπάθεια μας στηρίζεται σε μακροπρόθεσμες επενδύσεις σε νέες θεραπείες και τεχνολογίες και στην ανάπτυξη καινοτόμων ιατρικών συσκευών και νέων ψηφιακών ιατρικών λύσεων. Ανακαλύψτε πώς μπορούμε μαζί να οδηγήσουμε την αλλαγή στο www.novonordisk.gr

Η Μαρία Καζάκου εργάζεται ως ερευνήτρια στην έρευνα για τα από του στόματος χορηγούμενα
στο
της
Οδηγούμε την αλλαγή στοχεύοντας στην επιστημονική καινοτομία Αγωνιζόμαστε για να κάνουμε τη διαφορά για τα άτομα που ζουν με το σακχαρώδη διαβήτη, την παχυσαρκία,
του
και
GR22NNG00033
σκευάσματα,
Måløv
Δανίας
τις σπάνιες διαταραχές
αίματος, τις σπάνιες ενδοκρινολογικές διαταραχές
άλλες
παθήσεις, όπως
ΥΠΕΥΘ. ΔΙΑΦΗΜΙΣΗΣ: Αφιέρωμα ΔΙΑΓΝΩΣΤΙΚΑ ΚΕΝΤΡΑ
105 57 Αθήνα Τηλ.: 210 3229394, Fax: 210 3257074 Α.Φ.Μ. 095606935, Δ.Ο.Υ. Δ’ ΑΘΗΝΩΝ e-mail: info@nextdeal.gr | website: www.nextdeal.gr Τα 18 38

στέλνονται στην εφημερίδα δεν εκφράζουν απαραιτήτως και τις απόψεις του εντύπου.

4 | ΠΕΡΙΕΧΟΜΕΝΑ
ΛΟΓΙΣΤΗΡΙΟ: Κώστας Παπαντωνόπουλος ΣΥΝΔΡΟΜΕΣ: Γεωργία Καλτσώνη
Γεωργία Καλτσώνη ΔΙΟΡΘΩΣΗ: Ορέστης Σχινάς ΔΗΜΙΟΥΡΓΙΚΟ: Γιάννης Γ. Μπουκουβάλας ΕΠΙΜΕΛΕΙΑ ΠΑΡΑΓΩΓΗΣ: Γιάννης Γ. Μπουκουβάλας ΔΙΑΝΟΜΗ: ΑΡΓΟΣ Α.Ε. ΤΙΜΗ ΦΥΛΛΟΥ: 2,00 ΕΥΡΩ ΕΤΗΣΙΑ ΑΤΟΜΙΚΗ ΣΥΝΔΡΟΜΗ: 50,00 ΕΥΡΩ ΕΤΗΣΙΑ ΕΤΑΙΡΙΚΗ ΣΥΝΔΡΟΜΗ: 100,00 ΕΥΡΩ ΕΠΙΣΤΟΛΕΣ: Φιλελλήνων 3, Σύνταγμα,
ενυπόγραφα άρθρα και σχόλια που
Η Νο 1 δεκαπενθήμερη έκδοση για την ασφαλιστική αγορά και τον χρηματοοικονομικό χώρο ΙΔΙΟΚΤΗΤΗΣ: ΔΙΣΤΡΑΤΟ - ΕΥΑΓΓΕΛΟΣ ΣΠΥΡΟΥ ΕΠΕ e-mail: info@spiroueditions.gr ΕΚΔΟΤΕΣ: Ευάγγελος Σπύρου - Κωστής Σπύρου ΔΙΕΥΘΥΝΤΗΣ ΣΥΝΤΑΞΗΣ: Λάμπρος Καραγεώργος Συντάσσεται από συντακτική ομάδα ΤΡΑΠΕΖΙΚ Α Θ Ε ΜΑΤΑ: Χρήστος Κίτσιος ΧΡΗΜΑΤΙΣΤ Η ΡΙΟ: Εποπτεύων Χ. ΑΝΤΑΠΟΚΡΙΤ Η Σ Κ Υ ΠΡΟΥ: Γιάννης Σεϊτανίδης ΦΩΤΟΓΡΑΦΙΕΣ, ΦΩΤΟΡΕΠΟΡΤΑΖ VIDEO: Κωστής Ε. Σπύρου ΟΜΙΛΟΣ AFFIDEA 48 Σημαντική διεθνής διάκριση για την AFFIDEA 50 ΟΜΙΛΟΣ ΒΙΟΪΑΤΡΙΚΗ 54 ΟΜΙΛΟΣ ΙΑΤΡΙΚΟΥ ΑΘΗΝΩΝ: Ρομποτικό σύστημα προανάλυσης και αναλυτές τεχνολογίας αιχμής στο Βιοπαθολογικό Εργαστήριο
ΕΙΔΙΚΟ ΕΝΘΕΤΟ ΕΚΔΟΤΗΣ: Κωστής Σπύρου ΣΥΝΤΟΝΙΣΜΟΣ ΕΚΔΟΣΗΣ: Ευάγγελος Σπύρου ΚΕΙΜΕΝΑ: Κωστής Σπύρου, Άρης Μπερζοβίτης, Λάμπρος Καραγεώργος, Ανθή Αγγελοπούλου ΔΙΟΡΘΩΣΗ: Παρή Χατζηγεωργίου ΔΗΜΙΟΥΡΓΙΚΟ: PressiousArvanitidis ΕΚΤΥΠΩΣΗ: PressiousArvanitidis ΥΠΕΥΘ. ΔΙΑΦΗΜΙΣΗΣ: Γεωργία Καλτσώνη ΔΙΑΝΟΜΗ: Γιώτα Ζαχαρίου, Πρακτορείο Άργος Α.Ε. 10 Ξέρετε ότι… 14 Πιλοτική η πρώτη εφαρμογή του Ν/Σ για τη Δευτεροβάθμια Φροντίδα Υγείας 18 ΑΦΙΕΡΩΜΑ ΣΤΑ ΔΙΑΓΝΩΣΤΙΚΑ ΚΕΝΤΡΑ 20 Κλαδική Μελέτη ICAP «Ιδιωτικές Υπηρεσίες Υγείας» 24 ΕΛ.ΣΤΑΤ.: Τα Κέντρα Υγείας και οι Δημόσιες Μονάδες ΠΦΥ 28 ΣΥΝΕΝΤΕΥΞΗ ΠΑΝΑΓΙΩΤΗΣ ΨΥΧΑΡΗΣ Πρόεδρος Πανελλήνιας Ομοσπονδίας Συλλόγων Επιστημονικού Προσωπικού ΕΟΠΥΥ 32 ΔΙΑΓΝΩΣΤΙΚΑ ΚΕΝΤΡΑ: 35 χρόνια διαρκής αγώνας για επιβίωση και ανάπτυξη 34 ΠΑΣΙΔΙΚ: Η Ψηφιακή ΠΦΥ παράγοντας της βιωσιμότητας του συστήματος 38 ΝΟΣΟΚΟΜΕΙΟ ΥΓΕΙΑ
44
104 Το εγκεφαλικό επεισόδιο απαιτεί έγκαιρη και σωστή αντιμετώπιση 108 Συμπτώματα, διάγνωση και θεραπεία για το βρογχικό άσθμα 112 Ο ίλιγγος αφορά όλες τις ηλικίες 116 Η σαρκοπενία μεγάλη απειλή για τους καρκινοπαθείς 120 Πώς να προλάβετε και να αντιμετωπίσετε τον σακχαρώδη διαβήτη
123 Νοσοκομείο «ΑΣΚΛΗΠΙΕΙΟ ΒΟΥΛΑΣ»




124 NOVO NORDISK: Είναι στο δικό σου χέρι να προλάβεις τις επιπλοκές του σακχαρώδους διαβήτη


126 Εκπαιδευτικό πρόγραμμα για τη βελτίωση της επικοινωνίας πνευμονολόγου - ασθενούς 128 Συμβουλές για να απολαύσετε τα Χριστούγεννα με έναν άνθρωπο που ξεχνά 132 Αναβαθμίστηκε το ΤΕΠ του ΓΝΑ «ΓΕΝΝΗΜΑΤΑΣ» 134 ALLERGAN AESTHETICS: Χρυσές διακρίσεις για τις καινοτόμες θεραπείες της 136 BOEHRINGER INGELHEIM: Από την καινοτομία στην αειφόρο ανάπτυξη και την ενιαία υγεία

ΕΥΣΤΑΘΙΟΣ ΣΚΛΗΡΟΣ ΠΑΝΑΓΙΩΤΗΣ ΨΥΧΑΡΗΣ ΜΑΡΙΑ ΠΑΓΩΝΗ ΑΛΙΚΗ ΜΑΡΑΒΕΛΙΑ | 5 86 28 98 142 58 Διαγνωστικά Κέντρα HEALTHSPOT 62 ΟΜΙΛΟΣ EUROMEDICA 66 ΕΡΡΙΚΟΣ ΝΤΥΝΑΝ HOSPITAL CENTER: Η ιατρική του Διαδικτύου και η αξία του προσυμπτωματικού ελέγχου 70 Διαγνωστικό Κέντρο GENERAL HEALTH CARE 74 Τεχνολογικές εξελίξεις στην υπηρεσία των ασθενών 80 Μηχάνημα με τεχνητή νοημοσύνη για έγκαιρη διάγνωση του καρκίνου του δέρματος 84 Διαγνωστικό εργαλείο για τον καρκίνο του πνεύμονα από μεταπτυχιακούς φοιτητές 86 ΣΥΝΕΝΤΕΥΞΗ ΕΥΣΤΑΘΙΟΣ ΣΚΛΗΡΟΣ Πρόεδρος Εταιρείας Έρευνας και Εκπαίδευσης στην ΠΦΥ 90 ΕΡΕΥΝΑ: Γιατί μειώνεται η ερωτική επιθυμία στις δυτικές κοινωνίες 94 Όλα όσα πρέπει να γνωρίζετε για να προλάβετε την υπέρταση 98 ΣΥΝΕΝΤΕΥΞΗ ΜΑΡΙΑ ΠΑΓΩΝΗ Πρόεδρος Ελληνικής Αιματολογικής Εταιρείας
τα
από τη σεξουαλική κακοποίηση 142 ΣΥΝΕΝΤΕΥΞΗ ΑΛΙΚΗ ΜΑΡΑΒΕΛΙΑ Πρόεδρος Ελληνικού Ινστιτούτου Αιγυπτιολογίας 148 GSK Ελλάδος: Ο ANTONINO BIROCCIO νέος πρόεδρος και γενικός διευθυντής 150 ΟΜΙΛΟΣ INTERAMERICAN - ΠΟΛΥΪΑΤΡΕΙΑ MEDIFIRST 156 ΓΝΑ «Ο ΕΥΑΓΓΕΛΙΣΜΟΣ» - Ιστορική αναδρομή 156 62 44
138 Πως θα προστατεύσουμε
παιδιά










H ειδική έκδοση HEALTH Nextgeneration, By NextDeal, βρίσκεται για μια ακόμη φορά στα χέρια σας και ελπίζουμε να είναι ενδιαφέρουσα. Αποφασίσαμε να ασχοληθούμε στην παρούσα έκδοση με τα ιδιωτικά δι αγνωστικά κέντρα τα οποία προσφέρουν πολύ σημαντικές υπηρεσίες στην υγειονομική εξασφάλιση του πληθυσμού. Από τα τέλη της δεκαετίας του 1908, όταν ακόμη τα ιδιωτικά διαγνωστικά κέντρα ήταν «παράνομα», μέχρι σήμερα έχει διανυθεί μια πολύ μεγάλη απόσταση, καθιστώντας τις ιδιωτικές μονάδες Πρωτοβάθμιας Φροντίδας Υγείας απολύτως απαραίτητες, καθώς αναβάθμισαν το επίπεδο των παρεχόμενων υπηρεσιών και επίσης μείωσαν σημαντικά τις ροές προς τα νοσοκομεία. Η δημιουργία μεγάλων μονάδων με συνεχείς επενδύσεις στην επέκτασή τους και τον τεχνολογικό εκσυγχρονισμό τους καθόρισαν εν πολλοίς και το ρόλο των διαγνωστικών κέντρων ως βασικού πυλώνα του συστήματος υγείας της χώρας μας. Η συνεργασία τους με ασφαλιστικά ταμεία και ασφαλιστικές εταιρείες ενί σχυσαν περαιτέρω το ρόλο τους. Ειδικά οι ασφαλιστικές εταιρείες βρήκαν στα διαγνωστικά κέντρα ένα σύμμαχο στην προσφορά υψηλού επιπέδου υπη ρεσιών προς τους ασφαλισμένους τους έναντι μικρού κόστους. Παράλληλα, οι ασφαλιστικές εταιρείες αξιοποιούν τη συνεργασία τους με τα διαγνωστικά κέντρα για να προωθήσουν τις πολιτικές πρόληψης που υλοποιούν τα τελευ ταία χρόνια. H ειδική έκδοση HEALTH Nextgeneration, By NextDeal, όπως και στα προηγούμενα τεύχη θα συνεχίσει και στα επόμενα να φέρνει κοντά τις μονάδες υγείας όλων των βαθμίδων με το θεσμό της ιδιωτικής ασφάλι σης, καθώς από μια στενή συνεργασία των δύο αυτών πλευρών βγαίνουν όλοι κερδισμένοι και κυρίως οι πολίτες που έχουν επιλέξει ένα ασφαλιστήριο συμβόλαιο υγείας.
Στο παρόν τεύχος του HEALTH Nextgeneration, By NextDeal, εκτός από το αφιέρωμα στα διαγνωστικά κέντρα, έχετε την ευκαιρία, όπως και στα προηγούμενα, να πληροφορηθείτε τις τελευταίες εξελίξεις στην Ιατρική σε μια σειρά θεμάτων. Στο παρόν τεύχος εστιάζουμε στην έγκαιρη διάγνωση του καρκίνου του δέρματος, στις θεραπευτικές εξελίξεις στον τομέα της Αιματο λογίας και της Μοριακής Γενετικής, στις συμβουλές για μία καλύτερη ζωή και αποτελεσματική αντιμετώπιση ασθενειών, όπως ο ίλιγγος, ο σακχαρώδης διαβήτης κ.ά., πάντα από επιστήμονες εγνωσμένης αξίας και κύρους! Καλή ανάγνωση

8 | ΚΩΣΤΉΣ E. ΣΠΎΡΟΎ
Εκδότης EDITORIAL
Μια
πάντα
έκδοση με έμφαση
στη next generation

MAT-GR-2200145-V1.0-3/2022
Wechasethe miracles ofsciencetoimprove people’slives
■ «Περίπου 10 ενήλικες καπνιστές στους 100 πάσχουν από Χρόνια Αποφρα κτική Πνευμονοπάθεια (ΧΑΠ), δηλαδή περίπου 600.000 Έλληνες νοσούν, το 56% από αυτούς, δηλαδή 300.000, δεν γνωρίζει ότι πάσχει, ενώ οι μισοί πάσχοντες συνεχίζουν να καπνίζουν. Οι άνδρες πάσχουν 2,5 φορές περισ σότερο από τις γυναίκες - 11,6% έναντι 4,8%. Η ΧΑΠ επηρεάζει περισσότερο τον αγροτικό πληθυσμό (15,1%), ενώ στα αστικά κέντρα και στην Αθήνα τα αντίστοιχα ποσοστά είναι 10,1% και 6%. Το ετήσιο συνολικό οικονομικό φορτίο της ΧΑΠ ανά ασθενή ανέρχεται στις €5.582. Το έμμεσο κόστος ανά ασθενή (κόστος απώλειας παραγωγικότητας) ανέρχεται στα €1.398,3, ενώ το άμεσο κόστος στις €2.809. Το άμεσο μη ιατρικό (χρόνος ασθενών, χρόνος φροντιστών) υπολογίζεται στα €1.374 ανά έτος». Τα στοιχεία αυτά ανέφερε η συντονίστρια της Ομάδας ΧΑΠ της Ελληνικής Πνευμονολογικής Εταιρεί ας (ΕΠΕ), Ανδριάνα Παπαϊωάννου, επίκουρη καθηγήτρια Πνευμονολογίας ΕΚΠΑ, A’ Παν. Πνευμονολογική Κλινική, ΓΝΝΘΑ «Η ΣΩΤΗΡΙΑ», με αφορμή την Παγκόσμια Ημέρα για τη Χρόνια Αποφρακτική Πνευμονοπάθεια. Παράλλη λα, ο αντιπρόεδρος της ΕΠΕ, Νίκος Τζανάκης, καθηγητής Πνευμονολογίας, Ιατρική Σχολή Πανεπιστήμιο Κρήτης, δήλωσε ότι περίπου 1.000.000 Έλληνες βρίσκονται σε κίνδυνο να αναπτύξουν μελλοντικά τη νόσο.


■ Έρευνες έχουν δείξει ότι η ζωή με ψωριασική νόσο έχει μεγάλο αντίκτυπο στην ψυχική υγεία και τη συναισθηματική ευεξία ενός ατόμου. Η μη ιάσιμη, χρόνια φύση της ψωριασικής νόσου, η συστηματική φλεγμονή που εμφανίζεται στο σώμα και το γεγονός ότι η ασθένεια είναι ορατή στο δέρμα καθιστούν τους ανθρώπους που ζουν με ψωριασική νόσο σε κίνδυνο να αναπτύξουν κατάθλιψη και άγχος. Το ένα τέταρτο των ανθρώπων που ζουν με ψωριασική νόσο βιώνει κατάθλιψη. Και όσον αφορά το άγχος, ο αριθμός εκτινάσσεται στο εκπληκτικό 48%. Όπως επισημαίνει ο Κώστας Λούμος, πρόεδρος του Σωματείου Υποστήριξης Ανθρώπων με Ψωρίαση, «πέρα από τις επιπτώσεις που μπορεί να έχει η ψωρίαση στο σώμα, μπορεί να καταστρέψει τα συναισθήματα και την ψυχική ευεξία. Σε μια μελέτη, σχεδόν το 20% των ατόμων με ψωρίαση είχε κάποια μορφή κατάθλιψης».
δήλωσε η προϊσταμένη της Ιατροδικαστικής Υπηρεσίας Θεσσαλονίκης, ιατροδικαστής Ελένη Ζαγγελίδου.
10 |
ξέρετε ότι… ■ Τα περιστατικά σωματικής και σεξουαλικής κακοποίησης παιδιών κατά τη διάρκεια της πανδημίας στη χώρα μας αυξήθηκαν σημαντικά, με τη σεξουαλική κακοποίηση στα κορίτσια να είναι σχεδόν διπλάσια από το 2020 μέχρι το 2022. Τα παιδιά που κινδυνεύουν περισσότερο να υποστούν κάποια μορφή κακοποίησης είναι αυτά με ειδικές ανά γκες, διανοητική αναπηρία, νευρολογική διαταραχή, χρόνια νοσήματα και αναγνώριση ομοφυλοφιλίας. Επίσης, τα παιδιά που ζουν με γονείς ή φροντιστές που κάνουν κατάχρηση αλκοόλ ή ναρκωτικών, έχουν ψυχική ή νευρολογική διαταραχή ή εμπλέκονται σε εγκληματικές δρα στηριότητες. Τα παραπάνω στοιχεία παρουσιάστηκαν σε διαδικτυακή εκδήλωση της Ιατρικής Εταιρείας Θεσσαλονίκης. «Το πρόβλημα εί ναι πολύ πιο εκτεταμένο από αυτό που φτάνει και καταγράφεται στις υπηρεσίες»,
■ Τα τελευταία χρόνια έχει γίνει κατανοητό ότι η σωματική άσκηση έχει ευεργετικές επιδράσεις στους











ασθενείς με καρκίνο παχέος
εντέρου και ιδίως σε όσους

υποβάλλονται σε θεραπεία για τη νόσο. Η θετική επίδραση αφορά τόσο στην ποιότητα ζωής και τη μείωση των ανεπιθύμητων
ενεργειών από τη θεραπεία, αλλά και την επιβίωση αυτών των ασθενών. Μάλιστα το Εθνικό και Καποδιστριακό Πανεπιστήμιο

Αθηνών, μέσω του Τμήματος Αθλητικής Αριστείας της Α’ Ορθοπαιδικής Χειρουργικής
Κλινικής της Ιατρικής Σχολής του



■ Στο Σύστημα Ηλεκτρονικής Συνταγογράφησης για αποζημίωση από τον ΕΟΠΥΥ εντάχθηκαν εξειδικευμένες διαγνωστικές εξετάσεις για την πα ρουσία μεταλλάξεων γονιδίων BRCA 1 και 2, που ενοχοποιούνται για την πιθανότητα εμφάνισης κληρονομούμενου καρκίνου του μαστού και ωο θηκών. Ειδικότερα, οι εξετάσεις αυτές αφορούν: κακοήθη νεοπλάσματα των ωοθηκών, κακοήθη νεοπλάσματα του μαστού, οικογενειακό ιστορικό κακοήθους νεοπλάσματος, οικογενειακό ιστορικό κακοήθους νεοπλάσμα τος μαστού, οικογενειακό ιστορικό κακοήθους νεοπλάσματος γεννητικών οργάνων, οικογενειακό ιστορικό κακοήθους νεοπλάσματος άλλων οργά νων ή συστημάτων. Η εξέταση θα εκτελείται μόνο μία φορά ανά ΑΜΚΑ δικαιούχου στο πληροφοριακό σύστημα του ΕΟΠΥΥ. H συμμετοχή των δι καιούχων ΕΟΠΥΥ για την εξέταση BRCA 1,2 (NGS) ορίζεται στα 78,75 ευρώ, έναντι του ποσού των 105 ευρώ που αντιστοιχούν στο 15% της τιμής ΦΕΚ. Όταν απαιτείται και η εκτέλεση της συμπληρωματικής μεθόδου MLPA, η συμμετοχή θα προσαυξάνεται κατά 7,5 ευρώ. ■ Πάνω από το 60% όλων των περιπτώσεων φλεβικών θρομβώσεων συμβαίνουν κατά τη διάρκεια ή εντός 90 ημερών από τη νοσηλεία σε νοσοκομείο, γεγονός που την καθιστά κύρια αιτία θανάτου, που όμως μπορεί να προληφθεί. Ασθενείς με μειωμένη κινητικότητα - λόγω κατά κλισης ή ανάρρωσης ή που νοσηλεύονται λόγω χειρουργικής επέμβα σης ή σοβαρού τραυματισμού είναι πιο πιθανό να αναπτύξουν θρόμβωση. Σύμφωνα με τον Αλέξανδρο Τσελέπη, καθηγητή Βιοχημεί ας-Κλινικής Χημείας του Πανεπιστημί ου Ιωαννίνων, το προσωπικό του νο σοκομείου θα πρέπει να αξιολογεί

νέας πανδημίας θα αυξηθεί
λόγω της κλιματικής αλλαγής. Η κλιματική αλλαγή ενισχύει τη δυνατότητα των ιών να προσβάλουν τον ανθρώπινο οργανισμό πιο εύκολα.
τους ασθενείς κατά την εισαγωγή τους για τον κίνδυνο ανάπτυξης φλεβικής θρομβοεμβολής και να χρησιμοποιεί τις κατάλληλες δια δικασίες πρόληψης και θεραπείας. «Η θρόμβωση είναι μία πολύ κοινή κατάσταση που περίπου οι μισοί

| 11
■ Μελέτη που δημοσιεύθηκε στο επιστημονικό περιοδικό «The Proceedings of the National Academy of Sciences» επισημαίνει ότι η πιθανότητα εμφάνισης μια νέας πανδημίας παρόμοια με την Covid-19 θα τριπλασιαστεί τις επόμενες δεκαετίες. Όπως αναφέρει ο William Pan, καθηγητής παγκόσμιας περιβαλλοντικής υγείας στο Πανεπιστήμιο του Duke, η πιθανότητα εμφάνισης μιας
Πανεπιστημίου, έχει ξεκινήσει το πρόγραμμα «Θεραπευτική Άσκηση: Action for Cancer», που φιλοδοξεί να παρέχει ολοκληρωμένες υπηρεσίες εργοθεραπείας σε ασθενείς με καρκίνο. από εμάς δεν γνωρίζουμε και συχνά παρα βλέπουμε. Ένας στους τέσσερις ανθρώ πους παγκοσμίως πεθαίνει από καταστάσεις που σχετίζονται με τη θρόμβωση. Στη χώρα μας εκτιμάται ότι οι θάνατοι ετησίως φτάνουν τις 50.000», αναφέρει χαρακτηριστικά ο κ. Τσελέπης.
■ Το φιλανθρωπικό σωματείο
«Aurora Μαζί Ενάντια στα Αιμα τολογικά Νοσήματα» εγκαινίασε πρόσφατα στην Πάτρα μια στέγη δωρεάν διαμονής για έμπρακτη και ψυχολογική στήριξη ασθενών με αι ματολογικά νοσήματα. Η Aurora δι αθέτει ήδη δύο στέγες φιλοξενίας στην Αθήνα, ενώ η νέα στέγη στην πρωτεύουσα της Αχαΐας παρέχει δωρεάν διαμονή σε ασθενείς χα μηλού εισοδήματος, των οποίων η κύρια κατοικία τους βρίσκεται εκτός Πάτρας, σε συνδυασμό με μια σειρά από υπηρεσίες που βοηθούν ασθε νείς και οικογένειες να αντεπεξέρ χονται κατά τη διάρκεια αυτής της κρίσιμης περιόδου. Το συγκεκριμένο διαμέρισμα έχει εμβαδό 65 τ.μ., εί ναι πλήρως ανακαινισμένο και επι πλωμένο και βρίσκεται σε πολύ κο ντινή απόσταση από το Πανεπιστη μιακό Γενικό Νοσοκομείο Πατρών. Κατά συνέπεια η πρόσβαση των ασθενών γίνεται χωρίς τη χρήση Μέσων Μαζικής Μεταφοράς, μειώ νοντας την έκθεσή τους σε μικρόβια ενώ βρίσκονται σε ανοσοκαταστο λή. Για πληροφορίες: «Aurora - Μαζί Ενάντια στα Αιματολογικά Νοσήμα τα», Φραγκοκκλησιάς 9, Μαρούσι, τηλ. 2106165232.
■ Κατά 80% αυξήθηκαν οι κλήσεις που δέχθηκε η Τηλεφωνική Γραμμή Ψυ χολογικής Υποστήριξης (210 8237302) της Ελληνικής Εταιρείας Αντιρευμα τικού Αγώνα/ΕΛΕΑΝΑ από τον Σεπτέμβριο του 2021 έως τον Σεπτέμβριο του 2022. Πιο συγκεκριμένα, δέχθηκε 2.662 κλήσεις με μέση διάρκεια τα 10 λεπτά και με κύριο τόπο προέλευσης την Αθήνα. Οι εξυπηρετούμενοι ήταν στη συντριπτική τους πλειοψηφία γυναίκες (σε ποσοστό 87%), ηλικίας κατά μέσο όρο 50 ετών. Το 24% των κλήσεων αφορούσε αποκλειστικά θέματα ψυχικής υγείας (καταθλιπτικό συναίσθημα, άγχος, δυσκολίες στις διαπροσωπικές σχέσεις). Παράλληλα, το 21% των κλήσεων σχετιζόταν με ζητήματα ιατρικής φροντίδας (πρόσβαση στη θεραπεία, φαρμακευτική αγωγή, εμβολιασμός για τον COVID-19 και παρενέργειες), το 10% εργασι ακά και ασφαλιστικά ζητήματα, όπως η απώλεια ασφαλιστικής ικανότητας ή η διαδικασία πιστοποίησης αναπηρίας, και, τέλος, το 45% ζητήματα που αφορούσαν τη λειτουργία του συλλόγου.


12 |
■ Το πρόβλημα της μικροβιακής αντοχής είναι μεγάλο στη χώρα μας, όπου ο επιπολασμός των ενδονοσοκομειακών λοιμώξεων ανέρχεται στο 10% (πράγμα που σημαίνει ότι 1.821 νοσηλευόμενοι ασθενείς τα λαιπωρούνται από κάποιο ενδονοσοκομειακό μικρόβιο),
κατανάλωση των
ξέρετε
ενώ πολύ υψηλή είναι και η
αντιβιοτικών στην κοινότητα, όπου η χώρα μας κατέχει τη δεύτερη θέση στην Ευρώπη μετά την Κύπρο, σύμφωνα με τα επιδημιολογικά δεδομένα του 2020. Μάλιστα η Ελλά δα κατέχει την πρώτη θέση στη χρήση προωθημένων αντιβιοτικών, όπως οι καρβεπενέμες και τα πολυμιξίδια.
ότι…
■ Οι Ευρωπαίοι αντιμετωπίζουν μειωμένη πρόσβαση σε νέα φάρμακα και στην ικανότητα να συμμετάσχουν σε πρωτοποριακές κλινικές δοκι μές, καθώς η έρευνα και η ανάπτυξη νέων θεραπειών κινούνται όλο και περισσότερο προς πιο φιλόδοξους τομείς επιστημών ζωής στις ΗΠΑ και την Ασία. Μια νέα έκθεση που δημοσιεύθηκε πρόσφατα από το γραφείο Charles River Associates και διενεργήθηκε για λογαριασμό της EFPIA φι λοτεχνεί μια δύσκολη εικόνα πτωτικής ανταγωνιστικότητας στην Ευρώπη, με το παγκόσμιο μερίδιο στις επενδύσεις
Η πανδημία και τα πρωτοφανή μέτρα περιορισμού που εφαρμόστηκαν σε παγκόσμιο επίπεδο είχαν άμεσες επιπτώσεις στην ψυχική υγεία όλων των ανθρώπων και ειδικότερα των εργαζομένων, οι οποίοι κλήθηκαν αφενός να διαχειριστούν τα αυξημένα επίπεδα άγχους, θυμού και μοναξιάς που προκάλεσε ο εγκλεισμός, αφετέρου έπρεπε να παραμείνουν παραγωγικοί και προσηλωμένοι στην εργασία τους. Πρόσφατη έρευνα του Ομίλου Adecco κατέγραψε ότι, παρόλο που παρατηρείται μια μικρή βελτίωση σε σχέση με το 2021, η διατάραξη της ψυχικής υγείας συνεχίζει να αποτελεί ένα μεγάλο πρόβλημα για το εργατικό δυναμικό, καθώς 1 στους 4 εργαζομένους διεθνώς ανέφερε ότι η ψυχολογία του χειροτέρεψε τον τελευταίο χρόνο. Η Ελλάδα κατέχει τα πρωτεία σε αυτή την κατηγορία, καθώς οι Έλληνες, σε ποσοστό 37% (10% πάνω από τον μέσο όρο), δηλώνουν ότι η ψυχική τους υγεία έχει χειροτερέψει τους τελευταίους 12 μήνες. Στις επόμενες θέσεις βρίσκεται η Φινλανδία με 34%, η Ισπανία με 32% και η Γαλλία με 31%.

| 13 | ΘΕΜΑΤΑ ΥΓΕΙΑΣ
δοκιμές και βιομηχανική
ση είναι οξύτατη για τα Φαρμακευτικά Προϊόντα Προηγμένης Θεραπείας (ATMPs) -oι μηχανικής ιστών, γονιδιακές και κυτταρικές θεραπείες- που χρησιμοποιούνται για την πρόληψη, αγωγή και θεραπεία σπανίων ασθε νειών, συμπεριλαμβανομένων κάποιων μορφών καρκίνου, όπου οι ΗΠΑ και η Κίνα κυριαρχούν. ■
■ Τρία νέα νοσοκομεία που αναπτύσσονται στην περιφέρεια της Ελλάδας, μέσω της διεθνούς Πρωτοβουλίας για την Υγεία του Ιδρύματος Σταύρος Νιάρχος (ΙΣΝ), στοχεύουν στην παροχή υψηλής ποιότητας υγειονομικής περίθαλψης σε ασθενείς, ενώ εφαρμόζουν πιλοτικά βέλτιστες πρακτικές στον τομέα της βιωσιμότητας. Το ΙΣΝ, σε ένα από κοινού όραμα με τα αρχιτεκτονικά γραφεία που έχουν αναλάβει το σχεδιασμό των νοσοκομείων, το Renzo PianoBuilding Workshop και τη Betaplan, συνεργάζεται με το U.S. Greein Building Council για την ανάπτυξη ενός πλαισίου ετοιμότητας προς την επίτευξη μηδενικών εκπομπών διοξειδίου του άνθρακα, που μπορεί να λειτουργήσει ως πρότυπο για μελλοντικά κατασκευ αστικά έργα.
σε φαρμακευτική Ε&Α, κλινικές
παραγωγή να μειώνεται σταθερά. Η κατάστα
Με αφορμή τις σκληρές αντιδράσεις, το υπουργείο Υγείας διατίθεται, όπως λένε οι πληρο φορίες, να θέσει σε πιλοτική εφαρμογή, σε πρώτη φάση, το νομοσχέδιο και αν αυτό λειτουργήσει, τότε θα εφαρμοστεί πλήρως.

14 | Πιλοτική η πρώτη εφαρμογή του ΝΟΜΟΣΧΕΔ Ι ΟΥ για τη Δευτεροβάθμια Φροντίδα Υγείας Της ΑΝΘ Η Σ ΑΓΓΕΛΟΠΟΥΛΟΥ ΤΟΥΣ ΑΣΚΟΥ Σ ΤΟΥ ΑΙ ΟΛΟΥ άνοιξε το νέο νομοσχέδιο για τη Δευτεροβάθμια Περίθαλψη της αναπληρώτριας υπουργού Υγείας Μίνας Γκάγκα, με τους νοσοκομεια κούς ιατρούς αλλά και τους ιδιωτικούς να έρχονται σε μετωπική σύγκρουση με το υπουργείο, δηλώνοντας κά θετα αντίθετοι.
Συγκεκριμένα το νομοσχέδιο προβλέπει:
1Την ενίσχυση της κλινικής εκπαίδευσης των απο φοίτων Ιατρικής, μέσω προγράμματος εξάμηνης αμειβόμενης κλινικής άσκησης σε κλινικές, καθώς και σε Τμήματα Επειγόντων Περιστατικών σε επιλεγμένα δημόσια νοσοκομεία. Μετά την ολοκλήρωση της κλι νικής άσκησης, οι νέοι γιατροί θα είναι καλύτερα εφο διασμένοι για την υπηρεσία υπαίθρου (αγροτικό), ενώ θα μπορούν και πιο εύκολα να προσανατολιστούν στην επιλογή ειδικότητας.
2Την τροποποίηση του νομικού πλαισίου που διέπει την κρίση και επιλογή των ιατρών κλάδου ΕΣΥ, με στόχο η επιλογή μόνιμου προσωπικού να είναι στοχευ μένη και προσαρμοσμένη στις πραγματικές ανάγκες των νοσοκομείων. Έτσι, προβλέπονται συμβούλια κρί σεων σε κάθε Υγειονομική Περιφέρεια που θα ελέγ χουν τα δικαιολογητικά, τη μοριοδότηση και την ανα μοριοδότηση των υποψηφίων ιατρών. Παράλληλα, συ γκροτούνται σε κάθε νοσοκομείο συμβούλια αρμόδια για τη διεξαγωγή της συνέντευξης και τη διαμόρφωση της τελικής βαθμολογίας των ιατρών. Η διαδικασία αυτή επιταχύνει τις προσλήψεις και συμβάλει στην ορ θολογικότερη επιλογή ιατρικού προσωπικού.
3Την αναβάθμιση της ιατρικής εξειδίκευσης με δύο
τρόπους: α) Η διαδικασία τοποθέτησης ιατρών για ειδίκευση μεταφέρεται από το Υπουργείο Υγείας στα νοσοκομεία που αποτελούν εκπαιδευτικά κέντρα και δημιουργείται ηλεκτρονική πλατφόρμα για την υπο βολή αιτήσεων και τήρηση της σειράς χρονικής προ τεραιότητας. β) Ορίζονται ομάδες νοσοκομείων ανά
ειδικότητα και οι προς εξειδίκευση γιατροί θα ασκού νται κυκλικά σε όλα τα νοσοκομεία της ίδιας ομάδας, με στόχο την απόκτηση μεγαλύτερης εμπειρίας. Επι πλέον, ο αριθμός των θέσεων ανά ειδικότητα και ανά νοσοκομείο καθορίζεται ανάλογα με τις ανάγκες του συστήματος υγείας της χώρας.

4Τον εκσυγχρονισμό του νομικού πλαισίου που διέ πει το καθεστώς απασχόλησης των ιατρών κλάδου ΕΣΥ. Προβλέπεται η δυνατότητα προκήρυξης θέσεων μερικής απασχόλησης, οι οποίες θα καλύπτονται από ιατρούς που θα έχουν τη δυνατότητα άσκησης ιδιω τικού επαγγέλματος. Οι ιατροί πλήρους και αποκλει στικής απασχόλησης που υπηρετούν σε νοσοκομεία του ΕΣΥ και συμμετέχουν στην ολοήμερη λειτουργία θα έχουν τη δυνατότητα υπό συγκεκριμένες προϋπο θέσεις και με πρώτιστο γνώμονα τη στήριξη του δη μόσιου συστήματος να ασκούν περιορισμένα ιδιωτικό έργο ή να παρέχουν υπηρεσίες στον ιδιωτικό τομέα. Παράλληλα, για λόγους ίσης μεταχείρισης, επιτρέπε ται σε πανεπιστημιακούς ιατρούς που υπηρετούν σε νοσοκομεία του ΕΣΥ ή αρμοδιότητας του υπουργείου Παιδείας να παρέχουν ιδιωτικές υπηρεσίες, κατόπιν χορήγησης ειδικής άδειας από τη Σύγκλητο του ΑΕΙ.
5Τη συμπλήρωση του νομοθετικού πλαισίου που δι έπει την οργάνωση της Ιατρικής Υπηρεσίας των νο σοκομείων του ΕΣΥ. Ειδικότερα θεσπίζεται διαδικασία επιλογής και αξιολόγησης Συντονιστών Διευθυντών. Διασαφηνίζεται επίσης η διαδικασία επιλογής προσω ρινού προϊσταμένου τμήματος ή μονάδας νοσοκομεί ου του ΕΣΥ, όπου απαιτείται ο ορισμός του.
6Την ετήσια αξιολόγηση των επικουρικών ιατρών που υπηρετούν στο δημόσιο σύστημα υγείας της χώρας.
7Την προαγωγή της Επείγουσας Ιατρικής μέσω της σύστασης αυτοδύναμων Τμημάτων Επειγόντων Πε ριστατικών (ΤΕΠ) και σε άλλα νοσοκομεία, εκτός από αυτά για τα οποία ήδη προβλέπεται, και της θέσπισης επιδόματος για τους ιατρούς που υπηρετούν σε ΤΕΠ.
ΣΕΙΣ Οφθαλμίατροι, γενικοί ιατροί, παιδίατροι και ωτο ρινολαρυγγολόγοι του ιδιωτικού τομέα θεωρούν ότι το νομοσχέδιο πλήττει τόσο το δημόσιο και δωρεάν σύστημα υγείας όσο και τους ελευθεροεπαγγελματί ες ιατρούς. Δίνοντας το δικαίωμα ιδιωτικού ιατρείου στους μόνιμους, πλήρους και αποκλειστικής απασχό λησης ιατρούς του ΕΣΥ, δημιουργεί συνθήκες αθέμιτου
| 15 | ΕΠΙΚΑΙΡΟΤΗΤΑ
ΟΙ
8Τη διαμόρφωση ειδικότερου θεσμικού πλαισίου για τη μαιευτική περίθαλψη, με έμφαση στην προ αγωγή του φυσικού τοκετού και στην κατ’ οίκον μαιευ τική φροντίδα μέσω της θέσπισης σχετικού προγράμ ματος «Μαίες στο σπίτι».
ΑΝΤΙΔΡΑ
ανταγωνισμού για τον ελευθεροεπαγγελματία ιατρό, οδηγεί στη διάλυση του μικρού ιδιωτικού ιατρείου, ευ νοώντας παράλληλα λόγω της επακόλουθης αύξησης των προσφερόμενων υπηρεσιών μόνο τα μεγάλα ιδι ωτικά πολυϊατρεία. Ο Πανελλήνιος Ιατρικός Σύλλογος εξέφρασε επίσης τη διαφωνία του με σειρά διατάξεων του νομοσχεδίου και ιδιαίτερα ζητά την απόσυρση των διατάξεων που αλλάζουν τις εργασιακές σχέσεις των ιατρών του ΕΣΥ. Επίσης, ζητά την αναθεώρηση του τρόπου κρίσης των ιατρών του ΕΣΥ, μέσω αντικειμενικών κριτηρίων και μικρότερων αριθμητικά Eπιτροπών, στις οποίες δεν έχουν θέση οι διοικητές των νοσοκομείων και των ΥΠΕ, ώστε

με τις μεγάλες ελλείψεις σε υγειονομικό προσωπικό και τον απαρχαιωμένο εξοπλισμό και υποδομές, θα οδηγήσει ασθενείς να γίνουν πελατεία στις μεγάλες κλινικές της ιδιωτικής υγείας». Παράλληλα η ΕΙΝΑΠ υπογραμμίζει ότι «η είσοδος ιδιωτών γιατρών μερι κής απασχόλησης, που θα καλύπτουν τρύπες και κενά
στις δημόσιες μονάδες υγείας, θα οδηγήσει σε τραγική υποβάθμιση της παρεχόμενης περίθαλψης και σε επι κίνδυνες συνθήκες νοσηλείας». Η Ομοσπονδία Ενώσεων Νοσοκομειακών Γιατρών υποστηρίζει πως «το νομοσχέδιο γυρίζει το ΕΣΥ 40 χρόνια πίσω και βάζει οριστική ταφόπλακα στο Δημό σιο Σύστημα Υγείας». Στο ίδιο μήκος κύματος και η Ορ γάνωση Υγειονομικών του ΝΑΡ, που επισημαίνει επίσης ότι «είναι άθλιες οι μεθοδεύσεις της διαβούλευσης του νομοσχεδίου και γίνονται στα μουλωχτά πίσω από τις πλάτες των νοσοκομειακών γιατρών». Ωστόσο, η αναπληρώτρια υπουργός Μίνα Γκάγκα, μιλώντας προ ημερών στην ΕΡΤ, εξήγησε ότι ουσιαστι κά δύο πράγματα αλλάζει το νομοσχέδιο. «Οι ιδιώτες γιατροί μπορούν να έρθουν μέσα στο δημόσιο σύστη μα και να εργαστούν σε μερική απασχόληση, όπως συμβαίνει σε πολλές άλλες χώρες στο εξωτερικό, ενώ ότι δίνει και τη δυνατότητα στους γιατρούς του ΕΣΥ που προσφέρουν όλα αυτά τα χρόνια μέσα στο σύ στημα να μπορούν, εφόσον κάνουν τις υποχρεώσεις τους το πρωί και συμμετέχουν και στα ιατρεία ή τα απογευματινά χειρουργεία, να βγουν περιορισμένα και με έλεγχο ένα-δύο απογεύματα έξω». Παρ’ όλα αυτά το νομοσχέδιο, που κατατίθεται στη Βουλή αυτές τις μέρες, σύμφωνα με πληροφορίες θα έχει αρκετές αλλαγές όσον αφορά στις εργασιακές σχέσεις των γιατρών προκειμένου να σταματήσουν οι πολλές αντιδράσεις. Πηγές του υπουργείου λένε ότι θα εφαρμοστεί πιλοτικά και αν λειτουργήσει χωρίς προ βλήματα, τότε θα μπει σε πλήρη εφαρμογή. ■
16 |
Αθήνας-Πειραιά απορρίπτει κατηγορηματικά στο σύνολό του το νο μοσχέδιο, λέγοντας ότι «αν ψηφιστεί, σε συνδυασμό
οι διαδικασίες να διενεργούνται με ταχύτητα και αποκλειστικά ιατρικά κριτήρια. Η Ένωση Ιατρών Νοσοκομείων



ΜΕΓΑΛΟ ΑΦΙΕΡΩΜΑ σελίδες
των μαιευτικών - γυναικολο γικών κλινικών, των διαγνωστικών κέντρων - κέντρων αιμοκάθαρσης και λοιπών κέντρων, εξετάζοντας την πορεία και τις προοπτικές τους. Τα ιδιωτικά θεραπευτήρια διακρίνονται σε μεγάλες πολυδύναμες κλινικές,

20 | ΑΝΟΔΙΚΑ ΚΙΝΗΘΗΚΑΝ ΤΑ ΣΥΝΟΛΙΚΑ ΕΣΟΔΑ των επι χειρήσεων παροχής ιδιωτικών υπηρεσιών υγείας στην Ελλάδα την περίοδο 2016-2019, ενώ κάμψη καταγρά φεται το 2020 λόγω της πανδημίας του κορονοϊού. Τα έσοδα των ιδιωτών παρόχων υπηρεσιών υγείας τα τε λευταία χρόνια έχουν επιβαρυνθεί αρνητικά από την επιβολή του Νόμου 4172/2013 (μηχανισμός clawback / rebate), βάσει του οποίου οι επιχειρήσεις του κλάδου υποχρεώθηκαν σε «απομείωση» των απαιτήσεών τους για τις παρεχόμενες υπηρεσίες τους σε ασφαλισμένους του ΕΟΠΥΥ. Εξάλλου το τελευταίο χρονικό διάστημα παρατηρούνται στον κλάδο των ιδιωτικών υπηρεσιών υγείας ανακατατάξεις και τάσεις συγκέντρωσης. Τα παραπάνω προκύπτουν από την τελευταία κλα δική μελέτη για τις «Ιδιωτικές Υπηρεσίες Υγείας» που εκπόνησε η Διεύθυνση Οικονομικών Μελετών της ICAP ΑΕ. Η εν λόγω μελέτη πραγματεύεται τους τομείς των γενικών θεραπευτηρίων,
σε μεσαίες και μικρότερες μο νάδες. Σύμφωνα με στοιχεία της ΕΛ.ΣΤΑΤ., επί συνόλου ΚΛΑΔΙΚΗ ΜΕΛΕΤΗ ICAP «IΔΙΩΤΙΚΕΣ ΥΠΗΡΕΣΙΕΣ ΥΓΕΙΑΣ» Κάμψη παρουσίασαν οι ιδιωτικές υπηρεσίες υγείας το 2020 ως αποτέλεσμα της πανδημίας του κορονοϊού!
95 Δείκτης εξέλιξης της αγοράς των ιδιωτικών υπηρεσιών υγείας
45.053 κλινών σε όλα τα θεραπευτήρια της χώρας το 2018, το 1/3 των κλινών ανήκει σε ιδιωτικά θεραπευ τήρια. Σημαντικός είναι και ο αριθμός των ιδιωτικών διαγνωστικών κέντρων, αρκετά δε εξ αυτών ανήκουν σε μεγάλους επιχειρηματικούς ομίλους. Ανακατατάξεις και τάσεις συγκέντρωσης παρατηρούνται στον κλάδο των ιδιωτικών υπηρεσιών υγείας το τελευταίο χρονικό διάστημα, καθώς μεγάλα ιδιωτικά θεραπευτήρια της
100 Ρυθμός μεταβολής βασικών οικονομικών μεγεθών εταιρειών του κλάδου (2019/18)
κέντρα, κέντρα αιµοκάθαρσης Σύνολο Ενεργητικού -5,00% 0,00% 5,00% 10,00% 15,00% 20,00%
EBITDA
30,00%
(2014-2020) 0,00%




και λοιπά κέντρα Ίδια Κεφάλαια 0,00% 2,00% 4,00% 6,00% 8,00% 10,00% 12,00%
20,00%
10,00%
105 110 115 120 2020 2019 2018 2017 2016 2015 2014 Κλινικές Μαιευτήρια ∆ιαγνωστικά Διάρθρωση της αγοράς των ιδιωτικών υπηρεσιών υγείας 0,00% 2,00% 4,00% 6,00% 8,00% 10,00% 12,00% 14,00% Γενικές κλινικές Μαιευτικές κλινικές ∆ιαγνωστικά κέντρα Γενικές κλινικές Μαιευτικές κλινικές ∆ιαγνωστικά κέντρα κλινικές κλινικές κέντρα Γενικές κλινικές Μαιευτικές κλινικές ∆ιαγνωστικά κέντρα
Κύκλος Εργασιών -10,00%
| 21 | ΜΕΛΕΤΗ
Αθήνας άλλαξαν ιδιοκτησιακό καθεστώς, ενώ το ίδιο συνέβη και για συγκεκριμένα διαγνωστικά κέντρα. Όπως αναφέρει η Σταματίνα Παντελαίου, διευθύ ντρια Οικονομικών - Κλαδικών Μελετών της ICAP, η συνολική αγορά των ιδιωτικών υπηρεσιών υγείας (βά σει αξίας) παρουσίασε μείωση της τάξης του 8% το 2020 σε σχέση με το 2019 ως αποτέλεσμα της πανδη μίας του κορονοϊού. Σύμφωνα με Yπουργική Aπόφα
90 25% 60% 15%
ση, κατά τη διάρκεια του πρώτου lockdown, ανεστάλη προσωρινά η λειτουργία όλων των τακτικών χειρουρ γείων των ιδιωτικών κλινικών της χώρας, ενώ η επι σκεψιμότητα στα ιδιωτικά διαγνωστικά κέντρα σχεδόν μηδενίστηκε. Επίσης, οι ιδιώτες πάροχοι υπηρεσιών υγείας με έδρα στις τουριστικές περιοχές της χώρας επηρεάστηκαν σε σημαντικό βαθμό από τη μεγάλη πτώση του τουρισμού. Ειδικότερα κατά κατηγορία, μείωση της τάξης του 9% εμφανίζουν τα συνολικά έσο δα των κλινικών (γενικές, ειδικές, νευροψυχιατρικές κ.ά.), ενώ μείωση της τάξης του 6,5% καταγράφουν τα έσοδα των μαιευτικών - γυναικολογικών κλινικών. Σε χαμηλότερα επίπεδα εκτιμάται ότι θα κυμανθεί και η αγορά των διαγνωστικών κέντρων, κέντρων αιμοκά θαρσης και λοιπών κέντρων, εμφανίζοντας μείωση της τάξης του 6% την περίοδο 2020/19. Σύμφωνα με τον Κωνσταντίνο Παλαιολόγο, Senior Consultant Οικονομικών Μελετών της ICAP, o οποίος επιμελήθηκε της εν λόγω κλαδικής μελέτης, οι κλινι κές αποσπούν το μεγαλύτερο μερίδιο στο σύνολο της αγοράς των ιδιωτικών υπηρεσιών υγείας, το οποίο εκτιμάται στο 60% περίπου για το 2019. Οι μαιευτικές κλινικές συγκεντρώνουν περίπου το 15% των συνολι κών εσόδων, ενώ το υπόλοιπο 25% μοιράζονται τα ιδιωτικά διαγνωστικά κέντρα κέντρα αιμοκάθαρσης & λοιπά κέντρα. Ειδικότερα, όσον αφορά στον τομέα των κλινικών, οι γενικές κλινικές αντιπροσωπεύουν με ρίδιο της τάξης του 84%, οι νευροψυχιατρικές κλινικές και οι κλινικές αποκατάστασης μοιράζονται από κοινού μερίδιο περίπου 11% και το υπόλοιπο μοιράζονται οι ειδικές, μικτές και άλλες κατηγορίες κλινικών. Στα δυνατά σημεία του κλάδου περιλαμβάνονται το γεγονός της δραστηριοποίησης μεγάλων και καλά οργανωμένων επιχειρηματικών ομίλων με μακρά εμπειρία, η τάση της σταδιακής γήρανσης του πληθυ σμού, η εξέλιξη της ιατρικής επιστήμης και βέβαια οι χρόνιες αδυναμίες του δημόσιου συστήματος υγείας. Στα αδύνατα σημεία εντάσσεται το σχετικά αυστηρό θεσμικό πλαίσιο σε σχέση με την ίδρυση νέων ιατρι κών μονάδων. Ευκαιρίες για τον κλάδο συνιστούν, με ταξύ άλλων, η επέκταση των υφιστάμενων εταιρειών σε αγορές του εξωτερικού, η ανάπτυξη του ιατρικού τουρισμού, η σύναψη συμβάσεων με ιδιωτικές ασφα λιστικές εταιρείες, καθώς και η εξειδίκευση σε τομείς όπου υπάρχουν περιθώρια ανάπτυξης. Τέλος, ως απει λή για τον κλάδο μπορούν να εκληφθούν, εκτός από την πανδημία του κορονοϊού η οποία πλήττει τη χώρα από τις αρχές του 2020, τα προβλήματα ρευστότητας του δημοσίου τομέα, η στενότητα στην τραπεζική χρη ματοδότηση και βέβαια τα μέτρα της Πολιτείας περί μείωσης των δαπανών υγείας. Στο πλαίσιο της μελέτης έγινε εκτεταμένη χρημα


τοοικονομική ανάλυση των επιχειρήσεων του κλάδου βάσει 16 επιλεγμένων αριθμοδεικτών για την τελευ ταία πενταετία. Επίσης, συνετάχθη ομαδοποιημένος ισολογισμός (για τη 2ετία 2018-2019) βάσει αντιπρο σωπευτικού δείγματος 45 επιχειρήσεων εκμετάλλευσης ιδιωτικών κλινικών, 10 επιχειρήσεων εκμετάλλευσης μαιευτικών κλινικών και 35 επιχειρήσεων εκμετάλλευ σης διαγνωστικών κέντρων μονάδων αιμοκάθαρσης & λοιπών κέντρων. Από την ανάλυση των ομαδοποιημένων ισολογι σμών προκύπτουν τα εξής: Το σύνολο του ενεργητικού των ιδιωτικών κλινικών παρουσίασε αύξηση 2,4% το 2019 σε σχέση με το 2018 κυρίως λόγω της αύξησης των διαθεσίμων αλλά και των παγίων. Αντίθετα, τα ίδια κεφάλαια μειώθηκαν κατά 1,1%. Μειωμένες εμφανίζονται οι μεσομακρο πρόθεσμες υποχρεώσεις και προβλέψεις κατά 13,1% σε αντίθεση με τις βραχυπρόθεσμες υποχρεώσεις οι οποίες αυξήθηκαν κατά 18%. Τα συνολικά έσοδα των ιδιωτικών κλινικών του δείγματος παρουσίασαν αύξηση 7,2% το 2019/18. Σε σχέση με το τελικό καθαρό αποτέλεσμα των γενικών κλινικών, κέρδη καταγράφονται το 2019 έναντι ζημιών το 2018 λόγω της αύξησης του λειτουργικού αποτελέ σματος. Τα EBITDA αυξήθηκαν κατά 20,5%. Αναφορικά με τις μαιευτικές γυναικολογικές κλινικές, αυξημένο κατά 8,6% εμφανίζεται το σύνο λο του ενεργητικού το 2019 σε σχέση με το 2018 ως αποτέλεσμα της αύξησης των καθαρών παγίων. Τα ίδια κεφάλαια αυξήθηκαν κατά 5,7%. Αύξηση 22,6% καταγράφουν οι μεσομακροπρόθεσμες υποχρεώσεις και προβλέψεις σε αντίθεση με τις βραχυπρόθεσμες υποχρεώσεις οι οποίες μειώθηκαν κατά 9,2%. Αύξη ση εμφάνισαν τα συνολικά έσοδα των κλινικών του δείγματος σε ποσοστό 4,8% το 2019/18. Αναφορικά με το τελικό καθαρό αποτέλεσμα, σημαντικότατη αύξηση εμφανίζουν τα κέρδη προ φόρου εισοδήματος λόγω της μεγάλης μείωσης των μη λειτουργικών εξόδων. Τα EBITDA μειώθηκαν κατά 4,4%. Τέλος, σε ό,τι αφορά τα διαγνωστικά κέντρα - κέ ντρα αιμοκάθαρσης & λοιπά κέντρα, το σύνολο του ενεργητικού εμφάνισε αύξηση 12,3% το 2019 σε σχέ ση με το 2018 κυρίως λόγω της αύξησης των παγίων. Επίσης, τα ίδια κεφάλαια αυξήθηκαν κατά 15,3%. Ελα φρώς αυξημένες εμφανίζονται οι μεσομακροπρόθε σμες υποχρεώσεις και προβλέψεις (2,6%), ενώ μεγαλύ τερη είναι η αύξηση για τις βραχυπρόθεσμες υποχρε ώσεις (14,6%). Τα συνολικά έσοδα των εταιρειών του δείγματος παρουσίασαν αύξηση 10,6% το 2019/18. Σε σχέση με το τελικό καθαρό αποτέλεσμα, αύξηση 18,4% εμφανίζουν τα κέρδη προ φόρου εισοδήματος. Τα EBITDA αυξήθηκαν κατά 22,8%. ■




22 |























24 | Η ΕΛΛΗΝΙΚ Η ΣΤΑΤΙΣΤΙΚ Η ΑΡΧ Η (ΕΛ.ΣΤΑΤ.) ανακοίνω σε πρόσφατα τα στοιχεία αναφορικά με τις Μονάδες Πρωτοβάθμιας Φροντίδας Υγείας (ΠΦΥ) για το έτος 2021. Η παρακολούθηση της Πρωτοβάθμιας Φροντίδας Υγείας από την ΕΛ.ΣΤΑΤ. μέχρι το έτος 2016 περιορι ζόταν
Εθνι κού Δικτύου Υγείας (ΠΕΔΥ). Μετά τη θέσπιση του
4486/2017
τη «Μεταρρύθμιση
Φροντίδας Υγείας», ο όρος «Κέντρο Υγείας» διευρύν θηκε και περιλαμβάνει επιπλέον τις αποκεντρωμένες μονάδες, όπου στο πρώτο επίπεδο ΠΦΥ παρέχονται Π Ι ΝΑΚΑΣ 1 Μονάδες παροχής υπηρεσιών πρωτοβάθμιας φροντίδας υγείας ανά κατηγορία, έτη 2020-2021 Κέντρα Υγείας* Περιφερειακά Ιατρεία Πολυδύναμα Περιφερειακά Ιατρεία Ειδικά Περιφερειακά Ιατρεία Τοπικά Ιατρεία Λοιπές Μονάδες ToMY 2020 308 1427 93 49 220 10 127 2021 310 1432 95 52 220 10 127 *Περιλαμβάνονται και οι Μονάδες Υγείας του Πρωτοβάθμιου Δικτύου Υγείας (ΠΕΔΥ Ν.4238/2014) οι οποίες βάσει του Ν. 4486/2017 μετονομάζονται σε Κέντρα Υγείας ΕΛΛΗΝΙΚ Η ΣΤΑΤΙΣΤΙΚ Η ΑΡΧ Η Τα Κ Ε ΝΤΡΑ ΥΓΕ Ι ΑΣ και οι ΔΗΜ ΟΣΙΕΣ ΜΟΝ Α ΔΕΣ ΠΦΥ το 2021!
στα Κέντρα Υγείας του Πρωτοβάθμιου
Ν.
για
της Πρωτοβάθμιας
Εφήβων*
23
ανά ΥΠΕ
1η ΥΠΕ (Αττικής) 1.356 818 829 3.003
2η ΥΠΕ (Πειραιώς και Αιγαίου) 1.071 695 739 2.505
3η ΥΠΕ (Μακεδονίας) 675 655 476 1.806
4η ΥΠΕ (Μακεδονίας και Θράκης) 691 848 635 2.174
5η ΥΠΕ (Θεσσαλίας & Στερεάς Ελλάδας) 774 781 569 2.124
6η ΥΠΕ (Πελοποννήσου, Ιονίων Νήσων, Ηπείρου και Δυτικής Ελλάδας) 1.002 1.099 1.184 3.285
7η ΥΠΕ (Κρήτης) 511 264 245 1.020 Σύνολα 6.080 5.160 4.677 15.917
Π Ι ΝΑΚΑΣ 4 Μονάδες, προσωπικό (ιατρικό, νοσηλευτικό, λοιπό) και μηχανήματα Κέντρων Υγείας για τα έτη 2020-2021 Κέντρα υγείας Ιατρικό προσωπικό Νοσηλευτικό προσωπικό
Λοιπών ειδικοτήτων προσωπικό Μηχανήματα 2020 308 3.820 4.533 3.573 3.438 2021 310 3.671 5.004 3.469 3.606 Π Ι ΝΑΚΑΣ 5 Προσωπικό κατά Περιφέρεια, έτη 2020-2021 Κέντρα Υγείας Ιατρικό προσωπικό 2020 2021 21/20 %
Σύνολο Χώρας 310 3.820 3.671 -3,9 Ανατολική Μακεδονία, Θράκη 20 165 150 -9,1 Κεντρική Μακεδονία 46 602 565 -6,1 Δυτική Μακεδονία 11 141 139 -1,4 Ήπειρος 20 131 137 4,6 Θεσσαλία 21 170 151 -11,2 Στερεά Ελλάδα 23 174 184 5,7 Ιόνια Νησιά 12 71 70 -1,4 Δυτική Ελλάδα 29 227 218 -4,0 Πελοπόννησος 29 168 160 -4,8 Αττική 57 1.585 1.503 -5,2 Βόρειο Αιγαίο 10 58 52 -10,3 Νότιο Αιγαίο 14 116 116 0,0 Κρήτη 18 212 226 6,6
| 25 | ΑΠΟΓΡΑΦΗ
2020 2021
Π Ι ΝΑΚΑΣ 2 Μονάδες παροχής υπηρεσιών ψυχικής υγείας έτη 2020-2021
Κέντρα Ψυχικής Υγείας Ενηλίκων 31 31 Κέντρα Ψυχικής Υγείας με Κοινοτικές Υπηρεσίες Ψυχικής Υγείας Παιδιών και
17 17 Κέντρα Ψυχικής Υγείας Παιδιών και Εφήβων 23
Σύνολο 71 71 *Υβριδικός τύπος δομής που απευθύνεται τόσο σε ενήλικες όσο και σε παιδιά και εφήβους Π Ι ΝΑΚΑΣ 3 Αριθμός εργαζομένων στα Κέντρα Υγείας, στα Περιφερειακά Ιατρεία (πολυδύναμα και ειδικά), στα Τοπικά Ιατρεία και στις ΤοΜΥ ανά Υγειονομική Περιφέρεια για το έτος 2021 Υγειονομικές Περιφέρειες Ιατρικό προσωπικό Νοσηλευτικό προσωπικό Προσωπικό λοιπών ειδικοτήτων Σύνολα
υπηρεσίες από τις Τοπικές Μονάδες Υγείας (ΤοΜΥ), τα Περιφερειακά Ιατρεία (Π.Ι.), τα Πολυδύναμα Περιφε ρειακά Ιατρεία (ΠΠΙ), τα Ειδικά Περιφερειακά Ιατρεία (ΕΠΙ), τα Τοπικά Ιατρεία (Τ.Ι.) και λοιπές μονάδες ΠΦΥ. Όπως προκύπτει από την έρευνα, τα Κέντρα Υγεί ας το 2021 λειτούργησαν στο σύνολο της χώρας με μειωμένο ιατρικό και λοιπών ειδικοτήτων προσωπικό, ωστόσο υπήρξε αύξηση του νοσηλευτικού προσωπι κού, καθώς και του ιατρικού εξοπλισμού. Ειδικότερα: Στον πίνακα 1 παρουσιάζεται το σύνολο των δομών παροχής Πρωτοβάθμιας Φροντίδας Υγείας για το έτος 2021. Επιπλέον στην Πρωτοβάθμια Φροντίδα Υγείας πε ριλαμβάνονται και δομές παροχής υπηρεσιών ψυχικής
υγείας, οι οποίες εμφανίζονται με τρεις διαφορετικούς τύπους (Πίνακας 2). Στον Πίνακα 3 παρουσιάζεται ο αριθμός των εργα ζομένων στα Κέντρα Υγείας, στα Τοπικά Ιατρεία, στα Περιφερειακά Ιατρεία (πολυδύναμα και ειδικά) και στις ΤοΜΥ για το έτος 2021 ανά Υγειονομική Περιφέρεια. Στους Πίνακες 4 έως 7 παρουσιάζονται στοιχεία αναφορικά με τη διάρθρωση του αριθμού των μηχα νημάτων, καθώς και με το ιατρικό, νοσηλευτικό και λοι πό προσωπικό των 310 Κέντρων Υγείας (Ν. 4486/2017). Ο συνολικός αριθμός των Κέντρων Υγείας το 2021 ανήλθε σε 310. Από την κατανομή των Κέντρων Υγείας στις 13 Περιφέρειες της χώρας παρατηρείται ότι τα περισσότερα Κέντρα Υγείας βρίσκονται στην Αττική (57

2021 21/20 % 2020 2021 21/20 %
Χώρας 4.533 5.004 10,4 3.573 3.469 -2,9 Ανατολική Μακεδονία, Θράκη 352 377 7,1 215 211 -1,9 Κεντρική Μακεδονία 842 901 7,0 578 569 -1,6 Δυτική Μακεδονία 202 211 4,5 107 129 20,6 Ήπειρος 345 344 -0,3 162 161 -0,6 Θεσσαλία 468 482 3,0 229 203 -11,4 Στερεά Ελλάδα 257 311 21,0 216 205 -5,1 Ιόνια Νησιά 65 75 15,4 52 59 13,5 Δυτική Ελλάδα 314 342 8,9 244 228 -6,6 Πελοπόννησος 288 294 2,1 207 203 -1,9 Αττική 930 1.176 26,5 1.085 1.011 -6,8 Βόρειο Αιγαίο 123 114 -7,3 145 149 2,8 Νότιο Αιγαίο 132 123 -6,8 119 119 0,0 Κρήτη 215 254 18,1 214 222 3,7
26 | Π Ι ΝΑΚΑΣ
Περιφέρεια,
Προσωπικό
6 Μη ιατρικό προσωπικό Κέντρων Υγείας κατά
έτη 2020-2021 Νοσηλευτικό προσωπικό
λοιπών ειδικοτήτων 2020
Σύνολο
ΓΡΑΦΗΜΑ 1 Κέντρα Υγείας κατά Περιφέρεια,
Π Ι ΝΑΚΑΣ 7 Ιατρικά μηχανήματα που διέθεταν τα Κέντρα Υγείας, έτη 2020-2021 2020 2021 21/20 %
Σύνολο Χώρας 3.438 3.606 4,9 Ανατολική Μακεδονία, Θράκη 287 321 11,8 Κεντρική Μακεδονία 555 546 -1,6 Δυτική Μακεδονία 120 129 7,5 Ήπειρος 190 206 8,4 Θεσσαλία 252 262 4,0 Στερεά Ελλάδα 187 194 3,7 Ιόνια Νησιά 90 100 11,1
Δυτική Ελλάδα 200 201 0,5 Πελοπόννησος 276 294 6,5
Αττική 688 724 5,2
Βόρειο Αιγαίο 190 218 14,7
Νότιο Αιγαίο 157 155 -1,3 Κρήτη 246 256 4,1
κέντρα), στην Κεντρική Μακεδονία (46 κέντρα), στην Πελοπόννησο (29 κέντρα) και στη Δυτική Ελλάδα (29 κέντρα), ενώ τα λιγότερα βρίσκονται στο Βόρειο Αι γαίο (10 κέντρα) και τη Δυτική Μακεδονία (11 κέντρα) Γράφημα 1). Από τη σύγκριση των στοιχείων των Κέντρων Υγεί ας των τελευταίων ετών 2020-2021 παρατηρούνται τα ακόλουθα: • Ο αριθμός του ιατρικού προσωπικού που απα
σχολείται στα Κέντρα Υγείας παρουσίασε μείωση κατά 3,9% το 2021 σε σχέση με το 2020, στο σύνολο της χώρας. Αύξηση παρατηρείται το 2021 σε σχέση με το 2020 στις Περιφέρειες Κρήτης και Στερεάς Ελλάδας κατά 6,6% και 5,7%, αντίστοιχα. Αντίθετα, μειώσεις πα ρατηρήθηκαν στις περισσότερες περιφέρειες το 2021 σε σχέση με το 2020, με μεγαλύτερες μειώσεις στις Πε ριφέρειες Θεσσαλίας και Βόρειου Αιγαίου κατά 11,2% και 10,3% αντίστοιχα (Πίνακας 5). • Το νοσηλευτικό προσωπικό αυξήθηκε το 2021 σε σχέση με το 2020 κατά 10,4% στο σύνολο της χώρας. Αύξηση παρατηρείται κατά το 2021 σε σχέση με το 2020 σε όλες σχεδόν τις περιφέρειες, με σημαντικό τερη αυτή στις Περιφέρειες Αττικής και Στερεάς Ελλά δας με 26,5% και 21,0% αντίστοιχα. Αντίθετα, μειώσεις παρατηρήθηκαν στις Περιφέρειες Βόρειου Αιγαίου, Νότιου Αιγαίου και Ηπείρου κατά 7,3% 6,8% και 0,3% αντίστοιχα (Πίνακας 6). • Το προσωπικό λοιπών ειδικοτήτων των Κέντρων Υγείας παρουσίασε μείωση το 2021 σε σχέση με το 2020 κατά 2,9% στο σύνολο της χώρας. Σημαντικότερη αύξηση παρατηρείται το 2021 σε σχέση με το 2020 στις Περιφέρειες της Δυτικής Μακεδονίας και Ιόνιων Νήσων κατά 20,6% και 13,5% αντίστοιχα. Αντίθετα, μειώσεις παρατηρήθηκαν κυρίως στις Περιφέρειες Θεσσαλίας και Αττικής κατά 11,4% και 6,8% αντίστοιχα (Πίνακας 6). • Στα ιατρικά μηχανήματα που διαθέτουν τα Κέντρα Υγείας, παρατηρήθηκε αύξηση στο σύνολο της χώρας το 2021 σε σχέση με το 2020 κατά 4,9% (Πίνακας 7). ■
| 27 | ΑΠΟΓΡΑΦΗ
20 46 11 20 21 23 12 29 29 57 10 14 18
2021 0 10 20 30 40 50 60 Κρήτη Νότιο Αιγαίο Βόρειο Αιγαίο Αττική Πελοπόννησος ∆υτική Ελλάδα Ιόνια Νησιά Στερεά Ελλάδα Θεσσαλία Ήπειρος ∆υτική Μακεδονία Κεντρική Μακεδονία Ανατολική Μακεδονία, Θράκη

ΠΑΝΑΓΙΏΤΗΣ ΨΥΧ Α ΡΗΣ Ο Παναγιώτης Ψυχάρης είναι πτυχιούχος της Ιατρικής Σχολής Αθηνών. Κατέχει την ειδικότητα της Ορθοπαι δικής και Τραυματολογίας. Είναι πρόεδρος της ΠΟΣΕΥΠ ΠΦΥ (Πανελλήνιας Ομοσπονδίας Συλλόγων Επιστη μονικού Υγειονομικού Προσωπικού) και μέλος του Δ.Σ. του ΙΣΑ (Ιατρικού Συλλόγου Αθηνών). Έχει θητεύσει μέλος του ΚΕΣΥ (Κεντρικού Συμβουλίου Υγείας).
ΠΦΥ και μέλος του Δ.Σ. του ΙΣΑ, Παναγιώτης Ψυχάρης, ο οποίος επισημαίνει ότι η υποχρηματοδότηση του δημοσίου συστήματος βρί σκεται σε απελπιστική κατάσταση στη χώρα μας. Σύμ
φωνα με τον κ. Ψυχάρη, σαφώς και πρέπει να υπάρχουν κανόνες και ποιοτικά κριτήρια στην παροχή υπηρεσιών υγείας χωρίς εξαιρέσεις και να ισχύουν τα ίδια κριτήρια και στον ευρύτερο δημόσιο τομέα, ωστόσο ο τρόπος που έχουν θεσπιστεί τα κριτήρια δυσκολεύουν τη βιω σιμότητα των μικρών εργαστηρίων. — Πώς μπορεί ένας πολίτης να κάνει διαγνωστικές εξετάσεις στον δημόσιο τομέα σήμερα; Διαγνωστι κές εξετάσεις σε Κέντρα Υγείας γίνονται; Εξετάσεις διαγνωστικές στον ευρύτερο δημόσιο το μέα σήμερα μπορούν να γίνουν θεωρητικά, όπως και στα Κέντρα Υγείας (Κ.Υ.). Το πρόβλημα είναι ότι υπάρ χει μια συρρίκνωση των εργαστηρίων τα οποία δεν έχουν επαρκές προσωπικό, εξάλλου διορισμοί μόνιμου προσωπικού δεν έχουν γίνει τα τελευταία 12 χρόνια. Αιματολογικές και βιοχημικές εξετάσεις γίνονται. Εξε τάσεις υψηλού κόστους, π.χ. απεικονιστικές εξετάσεις, αξονικές και μαγνητικές τομογραφίες, στα Κ.Υ. δεν γί νονται και έτσι μεγάλο τμήμα του Κρατικού Προϋπολο γισμού μεταφέρεται στον ιδιωτικό τομέα. Και ενώ στο Δημόσιο ο ασφαλισμένος δεν πληρώνει συμμετοχή, στον ιδιωτικό τομέα πληρώνει 20% του κόστους της εξέτασης. Στην πράξη ένα μικρό τμήμα των εξετάσε

| 29 | ΣΥΝΕΝΤΕΥΞΗ Συνέντευξη στην ΑΝΘΗ ΑΓΓΕΛΟΠΟΥΛΟΥ ΠΑΝΑΓΙ Ω ΤΗΣ ΨΥΧ Α ΡΗΣ Πρόεδρος της Πανελλήνιας Ομοσπονδίας Συλλόγων Επιστημονικού Υγειονομικού Προσωπικού του ΕΟΠΥΥ και μέλος του Δ.Σ. του ΙΣΑ ΜΙΚΡ Ο ΤΜ Η ΜΑ ΤΩΝ ΔΙΑΓΝΩΣΤΙΚ Ω Ν ΕΞΕΤΑ ΣΕΩΝ ΕΚΤΕΛΕ Ι ΤΑΙ ΣΤΙΣ ΔΗΜ ΟΣΙΕΣ ΔΟΜ Ε Σ , ΛΟ ΓΩ ΑΝΕΠ Α ΡΚΕΙΑΣ ΠΡΟΣΩΠΙΚΟΥ ! ΓΙΑ ΤΑ ΠΡΟΒΛΗΜΑΤΑ ΤΗΣ ΠΡΩΤΟΒΑΘΜΙΑΣ Φροντίδας Υγείας και τη λειτουργία του Εθνικού Οργανισμού Πα ροχής Υπηρεσιών Υγείας μάς μιλά ο πρόεδρος της Πα νελλήνιας Ομοσπονδίας Συλλόγων Επιστημονικού Υγει ονομικού Προσωπικού (ΠΟΣΕΥΠ)
ων εκτελείται στις δημόσιες δομές. Το κράτος δεν έχει επενδύσει στα διαγνωστικά εργαστήρια και αυτό το πληρώνει ακριβά, όπως πληρώνει και ο ασφαλισμέ νος. Είναι και αυτός ένας από τους λόγους που οι ιδι ωτικές δαπάνες για την Υγεία στη χώρα μας είναι από τις υψηλότερες στην Ευρώπη. — Τι αλλάζει με το νέο νομοσχέδιο στον ΕΟΠΥΥ; Σύμφωνα με τη διοίκησή του, ο στόχος είναι να υπάρχει πρόσβαση των πολιτών σε γιατρούς του ΕΟΠΥΥ, τους οποίους θα μπορούν ελεύθερα και δωρεάν να επισκέπτονται. Ισχύει όντως αυτό; Χωρίς γενναία κρατική χρηματοδότηση, δεν μπορεί να σταθεί κανένα υγειονομικό σύστημα στον κόσμο. Στην εφαρμογή του προσωπικού ιατρού δεν έγινε ουσιαστικός διάλογος με τους ιατρικούς φορείς. Και όσο η χρηματο δότηση παραμένει από τις χαμηλότερες στην Ε.Ε., διά λογος ουσιαστικός δεν μπορεί να προκύψει. Η επίσκεψη στον συμβεβλημένο προσωπικό ιατρό θα γίνεται μόνο με ραντεβού σε συγκεκριμένες εργάσιμες ημέρες και ώρες, είτε στους ιδιώτες ιατρούς είτε σε ιατρούς των Κ.Υ. Η απροθυμία να συμβληθούν αρκετοί ιατροί, ώστε να κα λύψουν το μεγαλύτερο κομμάτι του πληθυσμού, είναι ένα ζήτημα που πρέπει να απασχολήσει το υπουργείο. Αυτή τη στιγμή περίπου 1.500 ιδιώτες ιατροί έχουν συμβληθεί με τον οργανισμό και όλοι όσοι υπηρετούν στα Κ.Υ. — Σε ό,τι αφορά στις ιατρικές επισκέψεις, στο νέο σχέδιο δίδεται η δυνατότητα σε όλους τους ιδιώτες γιατρούς να συμβληθούν με τον ΕΟΠΥΥ και οι οποίοι θα αμείβονται με βάση τον αριθμό των ασφαλι σμένων που θα τους επιλέξουν; Δίνεται όντως η δυνατότητα σε όλους τους ιδιώτες να συμβληθούν. Εδώ ακριβώς εστιάζεται το πρόβλημα. Χρεώνεται ο ιατρός έναν συγκεκριμένο αριθμό ασθε νών με μια πάγια αντιμισθία, η οποία βρίσκεται στα χαμηλότερα επίπεδα στην Ευρώπη. Κίνητρα επιστημο νικά και οικονομικά είναι η μαγική λέξη. — Με τη νέα νομοθετική ρύθμιση η κυβέρνηση θέτει καινούργιους κανόνες για τις διαγνωστικές εξετάσεις, βάζοντας ποιοτικά κριτήρια στα μηχα νήματα που θα χρησιμοποιούνται για τους ασφαλισμένους. Όποιος πάροχος δεν τα πληροί δεν θα μπορεί να συμβληθεί με τον ΕΟΠΥΥ; Σαφώς και πρέπει να υπάρχουν κανόνες και ποιοτικά κριτήρια στα μηχανήματα, χωρίς εξαιρέσεις, και να ισχύουν τα ίδια κριτήρια και στον ευρύτερο δημόσιο τομέα (νοσοκομεία και Κ.Υ.). Στην παρούσα φάση αυτό ισχύει για τις αξονικές και μαγνητικές τομογραφίες, που όταν δεν πληρούν τα κριτήρια αποζημιώνονται με κατώτερο τιμολόγιο. Έρχεται μετά και το περίφημο
clawback, που πλήττει τα μικρά και μεσαία εργαστήρια κυρίως, αποζημιώνοντας πρακτικά το 40% επί της ανα γραφόμενης κρατικής αποζημίωσης. Πρέπει όμως να σταθούμε στο εξής ζήτημα της ποιότητας: η ποιότητα δεν χρεώνεται στο μηχάνημα μόνο. Κυρίως χρεώνεται στον ανθρώπινο επιστημονικό παράγοντα, δηλαδή στον επιστήμονα ιατρό που γνωματεύει. Τα ποιοτικά κριτή ρια, όπως έχουν θεσπιστεί, δυσκολεύουν τη βιωσιμότη τα των εργαστηρίων, ιδίως αν επεκταθούν και σε άλλες διαγνωστικές εξετάσεις. Χρειάζεται γενναία χρηματο δότησή τους από ειδικά κρατικά προγράμματα. — Αναφορικά με τις ιδιωτικές κλινικές, θα πρέπει να παρέχουν ποιοτικές υπηρεσίες στους νοσηλευ ομένους και γι’ αυτό θα πρέπει να έχουν συγκεκριμένο αριθμό εργαζομένων, κλίνες ΜΕΘ, καθώς και άλλα ποιοτικά χαρακτηριστικά που σχετίζονται με τις νοσηλείες; Πρέπει να υπάρχουν ενιαίοι κανόνες λειτουργίας στον ιδιωτικό τομέα και στον δημόσιο και εν προκειμένου στις ιδιωτικές κλινικές και στα νοσοκομεία. Να εφαρ μόζονται αυστηρά και χωρίς εκπτώσεις. Τα νοσοκο μεία και τα Κ.Υ. για παράδειγμα είναι δυνατό να λει τουργούν χωρίς οργανόγραμμα και χωρίς συγκεκρι μένους οργανωτικούς και διοικητικούς κανόνες; Όταν υπάρχει ενιαίο σύστημα. μπορούμε να μιλάμε και για ανταγωνισμό. Και εδώ είναι το μεγάλο στοίχημα. — Πού εστιάζονται τελικά τα προβλήματα στην Υγεία σήμερα κατά τη γνώμη σας; Τα τελευταία 10-12 χρόνια η υποχρηματοδότηση του δημοσίου συστήματος βρίσκεται σε απελπιστική κα τάσταση. Η οργάνωση των υπηρεσιών είναι σε χαμη λά επίπεδα. Η χώρα μας βρίσκεται στις χειρότερες θέσεις, όσον αφορά στις ιδιωτικές δαπάνες υγείας, αναγκάζοντας τους ασθενείς να πληρώνουν από την τσέπη τους χρήματα που έπρεπε να χορηγεί το κράτος. Πρέπει να μας προβληματίσει ιδιαίτερα που η χώρα μας βρίσκεται στις χειρότερες θέσεις όσον αφορά τη θνητότητα από Covid. Χρειάζεται χρηματοδότηση στα επίπεδα του ευρω παϊκού μέσου όρου. Χρειάζονται οργάνωση και κίνητρα επιστημονικά και οικονομικά, ώστε να πάψει η ιατρική μετανάστευση. Χρειάζεται εκπόνηση Υγειονομικού Χάρ τη Αναγκών. Χρειάζεται βελτίωση υλικοτεχνικών υπο δομών. Ειδικά στα νοσοκομεία και στα Κ.Υ. χρειάζονται διορισμοί μόνιμου ιατρικού και υγειονομικού προσωπι κού. Έτσι οι συνθήκες εργασίας θα γίνουν ανθρώπινες και ελκυστικές και το δε σύστημα αποτελεσματικό. Το υγειονομικό σύστημα για την κάθε χώρα είναι ουσιαστι κά μια επένδυση, όχι μόνο οικονομική, αλλά μια επένδυ ση πολιτισμού και δημοκρατίας. ■
30 |







«Ε
ΜΕΓΑ
ΜΕΡΟΣ ΤΗΣ ΑΝΟΔΙΚΗΣ μας πορείας οφείλεται στην καλή συνεργασία που έχουμε με τις ασφαλιστικές εταιρείες, οι οποίες πληρώνουν με συ νέπεια και στην αξία τους τις ιατρικές μας υπηρεσίες. Αν στηριζόμασταν μόνο στη συνεργασία μας με τον ΕΟΠΥΥ, δεν θα μπορούσαμε να είχαμε ανάπτυξη». Η φράση αυτή που ανήκει στον αείμνηστο Ευάγγελο Σπανό απηχεί όλη την πραγματικότητα για το πώς λειτουργεί και αναπτύσ σεται ολόκληρος ο κλάδος των διαγνωστικών κέντρων. Από το 1986 που δημιουργήθηκαν τα πρώτα δια γνωστικά κέντρα μέχρι σήμερα, 35 χρόνια μετά, ο κλά δος κάνει έναν διαρκή αγώνα για να επιβιώσει και να αναπτυχθεί. Από τα πρώτα βήματα του κλάδου μέχρι σήμερα, η στάση της Πολιτείας μονίμως εχθρική, με γραφειο κρατικές διαδικασίες, παρατυπίες και παρανομίες. Οι συμφωνίες ποτέ δεν τηρήθηκαν από την πλευρά της Πολιτείας και των ασφαλιστικών ταμείων. Εκ προοιμίου συλλήβδην ολόκληρος ο κλάδος θεωρείται και αντιμετω πίζεται από την Πολιτεία ως «απατεώνας» και κλέφτης. Σίγουρα δεν αμφισβητείται το γεγονός ότι κάποιοι στο χώρο της ιδιωτικής Πρωτοβάθμιας Φροντίδας Υγεί ας χρησιμοποιούν παράνομες μεθόδους για να «κλέ
ψουν» και να κερδοσκοπήσουν σε βάρος των δημόσιων ασφαλιστικών ταμείων με πλασματικές συνταγογραφή σεις και εξετάσεις. Και σίγουρα δεν είναι όλοι «άγιοι». Ωστόσο, ο ηθικός αυτουργός είναι το ίδιο το κράτος, το οποίο δεν εφαρμόζει τους κανόνες του «παιχνιδιού» με τους ελεγκτικούς μηχανισμούς και δεν περιθωριοποιεί και τιμωρεί τους παράνομους, αλλά επιλέγει να διαιω νίζεται αυτό το καθεστώς. Όλα αυτά βέβαια δεν είναι τυχαία. Σήμερα ο ΕΟ ΠΥΥ και πιο παλιά τα δεκάδες κρατικά ασφαλιστικά ταμεία «κερδίζουν» από αυτήν την κατάσταση με το να καθυστερούν υπερβολικά τις πληρωμές στους παρό χους, χωρίς να νοιάζονται πώς αυτές οι επιχειρήσεις θα πληρώσουν τους εργαζομένους τους ή τους προ μηθευτές τους. Ακόμη όλοι οι πάροχοι του κλάδου της Υγείας «έχουν να λαμβάνουν» τεράστια ποσά από τα παλιά ασφαλιστικά ταμεία, τα οποία βέβαια θεωρούνται πλέον ανείσπρακτα. Κάποιοι -ευτυχώς λίγοι- καταφεύγουν στην προμή θεια δεύτερης ποιότητας ιατρικών αναλωσίμων, με αμφίβολης

32 |
ΝΑ
ΛΟ
ποιότητας αποτελέσματα εξετάσεων, προ κειμένου να μειώσουν το κόστος λειτουργίας τους και να αντεπεξέλθουν. Όλα αυτά είναι γνωστά, αλλά αυτό ΔΙΑΓΝΩΣΤΙΚΑ ΚΕΝΤΡΑ 35 χρόνια διαρκής αγώνας για επιβίωση και ανάπτυξη! Στις ασφαλιστικές εταιρείες οφείλεται ένα μεγάλο μέρος της ανοδικής τους πορείας! Του Α ΡΗ ΜΠΕΡΖΟΒ Ι ΤΗ
δεν συγκινεί το κράτος, το οποίο «έχει και το μαχαίρι, έχει και το πεπόνι». Σαν να μην έφθαναν όλα αυτά, από το 2013 προστέ θηκε και το περιβόητο clawback, ένα μέτρο που αφορά και άλλους κλάδους και που αποτελεί τη νόμιμη μορφή «κλοπής» του κράτους σε κάθε πάροχο υπηρεσιών προς αυτό. Η παραμονή του clawback ωθεί την ιδιωτική Πρω τοβάθμια Φροντίδα Υγείας στην καταστροφή. Κατά και ρούς μάλιστα κάποια διαγνωστικά κέντρα
τους στους ασθενείς δρώ ντας ως ανάχωμα για να μην πηγαίνουν οι ασθενείς στα δημόσια νοσοκομεία και έτσι να αντέχουν οι υποδομές
του Εθνικού Συστήματος Υγείας. Ο κλινικο-εργαστηριακός κλάδος των ιατρών υφίστα ται από το 2013 ένα άνευ προηγουμένου κούρεμα των δεδουλευμένων του (οι ιατρικές πράξεις παραμένουν σε τιμές του 1991) με τα γνωστά rebate και clawback. Στην πράξη υφίσταται κούρεμα έως και 65% των δεδου λευμένων μας, ενώ υποχρεούμαστε να κάνουμε όλες τις εξετάσεις, σε επίπεδα κάτω του κόστους σε μερικές εξ αυτών. Ενδεικτικά αναφέρουμε ότι η γενική αίματος αμεί βεται με λιγότερο από 2 ευρώ, η δοκιμασία κοπώσεως με 14 ευρώ και η ακτινογραφία θώρακος με 2,5 ευρώ. Από έτους και προ πανδημίας έχουμε επισημάνει ότι αν δεν ληφθούν μέτρα, πολλά ιατρεία και εργαστήρια θα κλείσουν λόγω οικονομικής αδυναμίας να λειτουργή σουν. Το οφειλόμενο ποσό clawback που φτάνει τα 740 εκατ. € των ετών 2013 έως 2019 από τους φορείς ΠΦΥ ισούται με τον προϋπολογισμό του ΕΟΠΥΥ 2 ετών για τη διάγνωση. Εμείς θα είμαστε στο πλευρό των ασθενών όσο μας επιτρέπουν να είμαστε ανοικτοί». Στις απεγνωσμένες αυτές εκκλήσεις το κράτος συ νεχίζει να κωφεύει. Εμείς να τολμήσουμε την πρόβλεψη ότι μετά από μερικά χρόνια θα συζητάμε πάλι τα ίδια πράγματα!. ■

| 33
έχουν κλείσει, αφήνοντας πίσω χρέη σε εργαζομένους και προμηθευ τές, καθώς και στο Δημόσιο. Στις τελευταίες κινητοποιή σεις του ο κλάδος επεσήμανε χαρακτηριστικά τα εξής: «Οι ιδιωτικοί φορείς ΠΦΥ έχουν δείξει έμπρακτα τη συνδρομή τους στην πανδημία και στη στήριξη των ασθε νών και της δημόσιας υγείας διατηρώντας ανοικτά τις δομές τους με μεγάλη ελάττωση του κύκλου εργασιών τους, ενώ τα λειτουργικά έξοδα παραμένουν ανεπηρέα στα και μάλιστα υψηλότερα λόγω μέτρων προστασίας. Τα ιατρεία και διαγνωστικά εργαστήρια
προσφέρουν τις υπηρεσίες
της γειτονιάς
επιπέδου των υπηρεσιών και, παρότι ξοδεύονται
σημαντικά χρηματικά ποσά, το σύστημα δεν είναι σε θέση να προσαρμοστεί έγκαιρα στις μεταβλητές υγει ονομικές ανάγκες. Η υγειονομική όμως κρίση απέδειξε ότι η καινοτο μία και εφευρετικότητα είναι αναγκαία προϋπόθεση για την αποτελεσματικότητα των υπηρεσιών υγείας. Ποιος μπορεί να ξεχάσει τους ερευνητές σε όλο τον κόσμο να προσπαθούν να βρουν καινοτόμες λύσεις για την έλλειψη αναπνευστήρων με την ψηφιακή εκτύ πωση καινοτόμων εξαρτημάτων, όταν διαπιστώθηκε η τεράστια έλλειψη; Και όλα αυτά συνέβησαν «επί του πεδίου» σε «συνθήκες μάχης»! Η ίδια η χώρα μας ανα γκάστηκε να θεσπίσει την «άυλη συνταγογράφηση» σε μία νύκτα, όταν οι διάφορες υπηρεσίες του Δημοσίου προέβαλαν αστείες δικαιολογίες εδώ και πολλά χρόνια για να αποφύγουν την ψηφιοποίηση της υπηρεσίας. Σήμερα το ελληνικό κράτος εξακολουθεί να έχει την παρωχημένη αντίληψη ότι ο ψηφιακός μετασχηματι σμός είναι χρήσιμος μόνο για τη μέτρηση, την παρα κολούθηση και την αξιολόγηση της ποιότητας υπηρεσι ών Πρωτοβάθμιας Φροντίδας Υγείας. Οι δυνατότητες όμως που προκύπτουν από τη χρήση των πληροφορι ακών συστημάτων της 4ης Βιομηχανικής Επανάστασης είναι πολλαπλάσιες και σίγουρα πολύ περισσότερες από την παροχή μετρήσιμων ποιοτικών στοιχείων. Οι τεχνολογίες αυτές μπορούν να υποκαταστήσουν τη νοσοκομειακή παρακολούθηση (π.χ. monitoring κατ’ οίκον νοσηλευόμενων ασθενών μέσω διασυνδεδεμέ νων με το ιατρείο ή το νοσοκομείο αισθητήρων κ.τ.λ.), αλλά και να βοηθήσουν στην πρόληψη! Το Internet of Things είναι μια πραγματικότητα με την επικράτηση wearables, τα οποία φιλοδοξούν να

34 | Ε Ι ΝΑΙ ΚΟΙΝ Η ΔΙΑΠ Ι ΣΤΩΣΗ πως η υγειονομική κρίση που προκάλεσε η πανδημία κατέδειξε την ανάγκη για ευέλικτα και ευπροσάρμοστα συστήματα υγείας. Κατέ στη για πρώτη φορά σαφές ότι η μονοσήμαντη επέν δυση σε κτιριακές υποδομές (η έλλειψη των οποίων θεωρείτο για πολλές δεκαετίες η αιτία της κακής από δοσης του συστήματος υγείας) δεν επιλύει το πρόβλη μα. Η χώρα μας διαθέτει πληθώρα κτιρίων, τα οποία όμως είναι άδεια από γιατρούς, αφού η Πολιτεία πα ρέλειψε να ασχοληθεί με το μείζον θέμα των όρων
απασχόλησης του ιατρικού προσωπικού. Η χώρα μας προέβη σε επενδύσεις στην Υγεία αλό γιστα, αποσπασματικά και χωρίς μακροπρόθεσμο ορί ζοντα επιτείνοντας το πρόβλημα. Αποτέλεσμα είναι ότι οι δαπάνες της χώρας μας δεν είναι είναι αντίστοιχες του
θεωρηθούν ως
μηχανήματα
και πολύ συχνά πιστοποιούνται ως τέτοια. Η διάχυση ΠΑΝΕΛΛΗΝΙΟΣ ΣΥΝΔΕΣΜΟΣ ΙΑΤΡΙΚΩΝ ΔΙΑΓΝΩΣΤΙΚΩΝ ΚΕΝΤΡΩΝ Η ψηφιακή Πρωτοβάθμια Φροντίδα Υγείας παράγοντας της βιωσιμότητας του συστήματος! Γράφει ο ΕΥΑ ΓΓΕΛΟΣ ΚΑΤΣ Ι ΚΗΣ, Α’ αντιπρόεδρος του Πανελλήνιου Συνδέσμου Ιατρικών Διαγνωστικών Κέντρων.
ιατρικά
(medical devices)
των πηγών λήψης μετρήσεων σημαίνει και επαρκή δε δομένα, τα οποία μπορεί να αξιοποιήσει το επόμενο εξελικτικό στάδιο της Τεχνητής Νοημοσύνης. Η ευκο λία της διαχείρισης της πληροφορίας αλλάζει και τον τρόπο παροχής υπηρεσιών πρωτοβάθμιας φροντίδας υγείας. Σήμερα οι ασθενείς απαιτούν πρόσβαση στις ια τρικές τους πληροφορίες σε πραγματικό χρόνο με ελάχιστη ταλαιπωρία. Έτσι, η συντριπτική πλειοψηφία των ασθενών δηλώνει ότι επιθυμεί να λάβει τα αποτε λέσματα των εξετάσεών τους σε ψηφιακή μορφή (αντί για την έντυπη ανακοίνωσή τους μέχρι πριν από λίγο καιρό), κάτι το οποίο μειώνει το κόστος διαχείρισης για
τον πάροχο έως και κατά 60%. Αντίστοιχα, σε πολλές περιπτώσεις για τη χορήγηση μιας θεραπείας αρκεί η χορήγηση μιας άυλης συντα γής, αφού έχουν προηγηθεί η κλινική εξέταση και η επιβεβαίωση της ιατρικής εκτίμησης από διαγνωστικές εξετάσεις. Και οι ασθενείς όμως στοχεύουν πια στην πρόλη ψη. Σε αυτή την τάση οφείλεται η αυξημένη χρήση ψη φιακών
τοποθέτηση holter) μπορούν να ληφθούν από ένα smartwatch, δίνοντας έτσι μεγαλύτερο έλεγχο στους ασθενείς στη διαχείριση της υγείας τους, καθώς και να λάβουν εξατομικευμέ νες υπηρεσίες. Πριν από λίγα μόνο χρόνια αυτά ακούγονταν εξωτι
κά, όμως σε πολύ μικρό χρονικό διάστημα έγιναν μέρος της καθημερινότητάς μας. Η τεχνολογική εξέλιξη απο δεικνύει καθημερινά τη δυναμική της. Αλλά για να γίνει η χώρα μας δυναμικός εταίρος της εξέλιξης αυτής, θα πρέπει να «ανοίξουμε τα μάτια και τα αυτιά μας». Οι ψηφιακές δυνατότητες μπορούν να οδηγήσουν σε μια νέα «αγορά» ιατρικών υπηρεσιών πέρα από το κλασικό μοντέλο της ιατρικής επίσκεψης. Η συνολική παρακολούθηση του πληθυσμού και η ιατρική διαχεί ριση ασθενών τώρα πια είναι εφικτές και τεχνικά. Εδώ και πολλά χρόνια έχουν υπάρξει προσπάθειες για τη δημιουργία value based συστημάτων αμοιβών, όμως πλέον η προστιθέμενη αξία μπορεί να παρακολουθη θεί και να μετρηθεί μέσω των ψηφιακών υπηρεσιών. Και οι πάροχοι υπηρεσιών πρωτοβάθμιας φρο ντίδας υγείας (ιατροί, διαγνωστικά κέντρα, μονάδες ημερήσιας νοσηλείας κ.τ.λ.) είναι σε ένα επαγγελμα τικό σταυροδρόμι. Η συνεχής αύξηση του λειτουργι κού κόστους αποτελεί αυτή τη στιγμή τον μεγαλύτερο κίνδυνο για τη διασφάλιση σταθερού επιπέδου υπη ρεσιών υγείας. Η «διάγνωση» ως ιατρική πράξη εξαρ τάται σε πολύ μεγάλο βαθμό από ενεργοβόρο ιατρικό εξοπλισμό υψηλής τεχνολογίας. Η παγκόσμια έλλειψη ημιαγωγών ευθύνεται για την αύξηση του κόστους των ιατρικών μηχανημάτων και για τις τεράστιες καθυστε ρήσεις που παρατηρούνται στις παραδόσεις τους. Επίσης ο πληθωρισμός δημιουργεί συνθήκες οικο νομικής ασφυξίας στους παρόχους υπηρεσιών πρω τοβάθμιας φροντίδας υγείας, οι οποίοι καλούνται να αντιμετωπίσουν πολλαπλάσια κόστη ηλεκτρικού ρεύ ματος, αναλωσίμων και μισθοδοσίας, χωρίς όμως να έχουν τη δυνατότητα να μετακυλίσουν το κόστος αυτό, αφού αμείβονται με σταθερές αμοιβές (που καθορί στηκαν το 1991) και μάλιστα με μεγάλες αναγκαστικές

| 35
εφαρμογών υγείας και φορητών συσκευών. Η χρήση αυτών των τεχνολογικών δυνατοτήτων για την παρακολούθηση θεμάτων υγείας, για καταμέτρηση στόχων υγείας και φυσικής κατάστασης, καθώς και για καταγραφή και μετάδοση ιατρικών δεδομένων δίνει πολύ μεγαλύτερη ασφάλεια στη διάγνωση. Μετρήσεις για τις οποίες απαιτείτο στο παρελθόν ειδική διαγνωστική εξέταση (π.χ.
εκπτώσεις επ’ αυτών, λόγω της εφαρμογής του μέ τρου του clawback. Και οι χρηματοδοτικές δυνατότη τες όμως του κοινωνικού κράτους είναι αντικειμενικά πεπερασμένες. Τέλος, το κόστος του χρήματος βαίνει απαγορευτικό για τη χρηματοδότηση λειτουργικών αναγκών μιας υγειονομικής μονάδας. Διέξοδος σε αυτήν την τέλεια καταιγίδα είναι η μείωση του λειτουργικού κόστους με τη δημιουργία οικονομιών κλίμακας για την αύξηση της εργασιακής αποδοτικότητας. Σε αυτό το πρόβλημα η υιοθέτηση ψηφιακών υπηρεσιών και μεθόδων, καθώς και η πα ροχή καινοτόμων υπηρεσιών μπορεί να αποτελέσoυν σημαντικό παράγοντα. Η προσφορά νέων υπηρεσιών (π.χ. κατ’ οίκον ιατρικής παρακολούθησης) με τη χρήση των νέων τεχνολογιών, χαμηλό κόστος για τον πάροχο και υψηλή προστιθέμενη αξία μπορεί να συμβάλει στη βελτίωση των οικονομικών μεγεθών των παρόχων και τη βιωσιμότητά τους. Υπάρχουν σήμερα πολλές και αξιόλογες εφαρ μοσμένες ψηφιακές λύσεις που έχουν προέλθει από ελληνικά μυαλά. Πολύ περισσότερες είναι στο στάδιο της ανάπτυξης. Αν μη τι άλλο, η χώρα μας διαθέτει ευ φυές και καινοτόμο στελεχιακό
πρώτοι φαίνεται να σχεδιάζουν χωρίς να γνωρίζουν σε βάθος τις πραγματικές ανάγκες και οι δεύτεροι να αγνοούν ότι υπάρχουν τεχνολογικές λύσεις που μπο ρούν να βελτιώσουν την αποδοτικότητά τους. Η χώρα μας δεν διαθέτει (ακόμα τουλάχιστον) το αναπτυξιακό οικοσύστημα που να ευνοεί την εγχώρια προσπάθεια του ψηφιακού μετασχηματισμού. Παράγοντας ανάσχεσης στην ανάπτυξη και εφαρ μογή καινοτόμων ψηφιακών λύσεων στη χώρα μας είναι και το αυστηρό ρυθμιστικό πλαίσιο. Η εγγενής φοβία που έχουμε στην Ελλάδα για οτιδήποτε δεν είναι αυστηρά ρυθμισμένο εμποδίζει την ευελιξία και την ταχύτητα ανάπτυξης καινοτόμων προϊόντων και υπη ρεσιών. Απαιτείται συνεπώς να αναθεωρήσουμε την προσέγγιση, να χαλαρώσουμε τους αυστηρούς κανό νες και να δώσουμε χώρο για την καινοτομία υπό τον έλεγχο ικανών ρυθμιστικών αρχών που θα αντιλαμβά νονται και θα ελέγχουν τα όρια της κάθε εφαρμογής, έτσι ώστε να γίνει χρήση της τεχνολογίας χωρίς εκπτώ σεις στην ποιότητα των ιατρικών υπηρεσιών. Απαιτεί ται συνεπώς αλλαγή νοοτροπίας όλων των εμπλεκο μένων, του κράτους, των παρόχων και των ασθενών. Αυτή τη στιγμή φαίνεται ότι οι ασθενείς προηγού νται όλων και έχουν τις περισσότερες απαιτήσεις. Κρί σιμο στοίχημα


36 |
δυναμικό.
ακόμα διασύνδεση μεταξύ των
τις ψηφιακές λύσεις και
υγείας που θα τις χρησιμοποιήσουν. Οι
να
και οι
ποι παράγοντες: οι πάροχοι και κυρίως η Πολιτεία.
ΕΥΑ ΓΓΕΛΟΣ ΚΑΤΣ Ι ΚΗΣ Ο Ευάγγελος Κατσίκης είναι Α’ αντιπρόεδρος του Πανελλήνιου Συνδέσμου Ιατρικών Διαγνωστικών Κέντρων. Επίσης είναι δικηγόρος, διαχειριστής εταίρος της δικηγορικής εταιρείας KKLegal, ηγέτιδας στην παροχή νομικών υπηρεσιών στον κλάδο της Υγείας, νομικός σύμβουλος του Πανελλήνιου Ιατρικού Συλλόγου και πολλών ιατρών και επιχειρήσεων.
Δεν διαθέτει όμως
μηχανικών που αναπτύσσουν
των παρόχων υπηρεσιών
είναι
προσαρμοστούν
υπόλοι
■



Εγκέφαλος Χαλανδρίου Τεχνολογίες αιχμής σε ένα από τα Μεγαλύτερα και Αρτιότερα Διαγνωστικά Κέντρα euromedica.gr Τεχνολογίες βασισμένες στην Τεχνητή Νοημοσύνη Χαμηλότερη δόση ακτινοβολίας* Σημαντικά μειωμένος χρόνος εξέτασης* Πραγματοποίηση ειδικών εξετάσεων ΕΓΚΕΦΑΛΟΣ ΧΑΛΑΝΔΡΙΟΥ · Ριζαρείου 3 & Χρυσ. Σμύρνης, Χαλάνδρι, Αθήνα 152 33 · T 2106891800-3 · euroegefalos@euromedica.gr ΔΙΚΤΥΟ ΔΙΑΓΝΩΣΤΙΚΩΝ ΚΕΝΤΡΩΝ EUROMEDICA: ΑΓΙΑ ΠΑΡΑΣΚΕΥΉ, ΓΑΛΑΤΣΙ, ΚΕΡΑΤΣΙΝΙ, ΚΉΦΙΣΙΑ, ΝΙΚΑΙΑ, ΠΕΡΙΣΤΕΡΙ, ΑΛΕΞΑΝΔΡΟΥΠΟΛΉ, ΉΡΑΚΛΕΙΟ, ΘΕΣΣΑΛΟΝΙΚΉ, ΚΑΤΕΡΙΝΉ, ΛΑΡΙΣΑ, ΡΕΘΥΜΝΟ * Σε σύγκριση με τα διεθνή επίπεδα αναφοράς για αξονική τομογραφία θώρακα

38 |
ΝΟΣΟΚΟΜΕ Ι Ο

ιδιωτικό νοση λευτικό ίδρυμα που λειτούργησε στην Ελλάδα το 1975 και μία από τις μεγαλύτερες ιδιωτικές νοσοκομειακές μονάδες της χώρας μας. Σε μοντέρνους χώρους και με σύγχρονο ιατροτε χνολογικό εξοπλισμό, διενεργείται ολοκληρωμένος προσυμπτωματικός έλεγχος σε διάστημα τριών περί που ωρών. Όλα τα απαραίτητα για τον έλεγχο ιατρι κά τμήματα είναι συγκεντρωμένα στον ίδιο χώρο και υπάρχει απόλυτος προγραμματισμός και συντονισμός, ώστε να ελαχιστοποιούνται τα διαστήματα άσκοπης αναμονής μεταξύ δύο εξετάσεων. Έτσι, τα αποτελέ σματα του check up δίνονται στον ενδιαφερόμενο ή στον γιατρό του μέσα σε τρεις ημέρες, μαζί με ιατρική έκθεση για την κατάσταση της υγείας του από εξειδι κευμένο ιατρό παθολόγο και συγκεκριμένες οδηγίες, εάν και εφόσον χρειάζονται. Αναλυτικότερα, μπορείτε να διενεργήσετε όλες τις εξετάσεις που επιθυμείτε (διαγνωστικές, απεικονιστι κές, ιατρικές). Την ημέρα της εξέτασής σας, θα παρα λάβετε την κάρτα «υγεία», η οποία θα φέρει το ονομα τεπώνυμό σας και έναν αυστηρά προσωπικό κωδικό. Η κάρτα «υγεία» λειτουργεί ως ταυτότητα διασφα

AΦΙΕΡΩΜΑ | ΔΙΑΓΝΩΣΤΙΚΑ ΚΕΝΤΡΑ | 39
ΤΟ ΥΓΕΙΑ Ε Ι ΝΑΙ ΤΟ ΠΡ Ω
ΤΟ ΜΕΓΑ ΛΟ
λίζοντας τον έλεγχο ταυτοπροσωπίας, εξασφαλίζει πολλαπλά προνόμια και μοναδικές υπηρεσίες υγείας για εσάς και την οικογένειά σας, ενώ ελαχιστοποιεί το χρόνο αναμονής σε κάθε σας συναλλαγή με τα νοσο κομεία του Ομίλου ΥΓΕΙΑ (αρκεί μόνο η επίδειξη της κάρτας σας για να έχετε άμεση πρόσβαση και αυτόμα τη αναγνώριση από όλα τα μηχανογραφικά συστήματα του ομίλου). ΕΞΕΙΔΙΚΕΥΜ Ε ΝΑ ΠΑΚ Ε ΤΑ ΠΡΟΛΗΠΤΙΚΟΥ ΕΛ Ε ΓΧΟΥ Το ΥΓΕΙΑ έχει δημιουργήσει τα παρακάτω ειδικά δια μορφωμένα check up για να καλύψουν διαφορετικές ανάγκες:
• FIT2WORK: Ο κάθε εργαζόμενος θα ενημερωθεί για τους εξωτερικούς παράγοντες που τον επηρεάζουν ανάλογα με το είδος της εργασίας του και θα λάβει εξατομικευμένες οδηγίες ώστε να προστατέψει την υγεία του.
• FIT2PLAY: Ο αθλητής θα ενημερωθεί για τους εξωτερικούς παράγοντες που τον επηρεάζουν ανάλο γα με το είδος της άσκησης και θα λάβει εξατομικευμέ νες οδηγίες ώστε να προστατέψει την υγεία του.
• FIT2PLAY ADVANCED: Θα λάβετε σαφείς ιατρικές οδηγίες και στόχους φυσικής άσκησης για να παρακο λουθείτε εύκολα την υγεία σας με τη βοήθεια της τε χνολογίας, αλλά και να βελτιστοποιήσετε την ποιότητα της άθλησής σας.
• FIT2SWIM: Ο κολυμβητής θα ενημερωθεί για τους εξωτερικούς παράγοντες που τον επηρεάζουν και θα λάβει εξατομικευμένες οδηγίες ώστε να προστατεύσει την υγεία του.
• FIT2DRIVE: Ο επαγγελματίας οδηγός θα ενημε ρωθεί για τους εξωτερικούς παράγοντες που τον επη ρεάζουν ανάλογα με το μεταφορικό μέσο που χρησι μοποιεί και θα λάβει εξατομικευμένες οδηγίες ώστε να προστατεύσει την υγεία του.
• FIT2TRAVEL: Ο κάθε ταξιδιώτης θα μπορεί να ενημερωθεί για τους εξωτερικούς παράγοντες που τον επηρεάζουν ανάλογα με τη συχνότητα και το με ταφορικό μέσο που χρησιμοποιεί και θα λάβει εξατο μικευμένες οδηγίες ώστε να προστατεύσει την υγεία του καλύτερα. • FIT2COOK: Οι επαγγελματίες του κλάδου εστία σης θα ενημερωθούν για τους εξωτερικούς παράγο ντες που τους επηρεάζουν στο χώρο εργασίας τους και θα λάβουν εξατομικευμένες οδηγίες ώστε να προ στατεύουν την υγεία τους. • Full check up ανδρών: Περιλαμβάνει Ακτινογρα φία θώρακος (F ή P), Έλεγχο αναπνευστικής λειτουργί ας (σπιρομετρία), Ηλεκτροκαρδιογράφημα, Παθολογι κή εξέταση Τελική έκθεση με οδηγίες, Καρδιολογική εξέταση, Οφθαλμολογική εξέταση (έλεγχο οπτικής
οξύτητας, αχρωματοψίας, βυθού αφθαλμών και πί εσης οφθαλμών), Έλεγχο ακοής (ακοόγραμμα), Γενι κή αίματος, Βιοχημικές εξετάσεις αίματος: ασβέστιο, φωσφόρος, σάκχαρο, ουρικό οξύ, ουρία, κρεατινίνη, χοληστερίνη, HDL, LDL, ολικά λιπίδια, τριγλυκερίδια, SGOT, SGPT (τρανσαμινάσες), λευκώματα ολικά, αλ καλική φωσφατάση,σίδηρος, Γενική ούρων, Ταχύτητα καθιζήσεως ερυθρών, Βάρος, ύψος, αρτηριακή πίεση, PSA (για άνδρες άνω των 40 ετών).
• Full check up γυναικών: Περιλαμβάνει ό,τι και το ανδρικό Full Check Up και επιπλέον Pap-test, Ψηλάφη ση μαστών, U/S Μαστών (κάτω των 40 ετών), Ψηφιακή Μαστογραφία (άνω των 40 ετών). Εκτός από τις εξετάσεις που περιλαμβάνονται στα βασικά αυτά πακέτα, υπάρχει δυνατότητα εμπλουτι σμού με περισσότερες εξετάσεις κατόπιν επιθυμίας του εξεταζομένου ή ιατρικής σύστασης, βάσει ηλικίας, κληρονομικότητας ή συμπτωμάτων. ΠΡΟΛΗΠΤΙΚΟΣ Ε ΛΕΓΧΟΣ ΚΑΙ ΤΟ Σ Α ΒΒΑΤΟ Το ΥΓΕΙΑ, με γνώμονα τη συνεχή και ποιοτική εξυπηρέ τηση των ασθενών του και κυρίως των εργαζομένων και των επιχειρηματιών που δεν μπορούν ή δεν επιθυ μούν να απουσιάσουν από την εργασία τους, προχώ ρησε σε επέκταση της λειτουργίας του Τμήματος Προ ληπτικού Ελέγχου (Check Up) και το Σάββατο, κατόπιν ραντεβού. Οι εξετάσεις που πραγματοποιούνται είναι: • Διενέργεια καρδιογραφημάτων (Προληπτικός έλεγχος-Προεγχειρητικός έλεγχος- Εξωτερικοί ασθε νείς).
• Τοποθέτηση, ανάλυση και καταγραφή Holter ρυθ μού και ΑΠ εσωτερικών-εξωτερικών ασθενών. • Διενέργεια test κοπώσεως σε εξωτερικούς και εσωτερικούς ασθενείς.
• Αιμοληψίες.
• Διενέργεια ακουογραμμάτων - τυμπανογραμμά των.
• Λήψη test Pap.
• Νοσηλευτική φροντίδα και διακίνηση εξεταζομέ νων σε άλλα τμήματα του νοσοκομείου. • Παθολογική, καρδιολογική, οφθαλμολογική, γυ ναικολογική και ορθοπαιδική εξέταση. • Μαστογραφία. • Ακτινογραφίες Προεγχειρητικού Ελέγχου - Πανο ραμικές οδόντων. ΑΣΦΑΛΙΣΤΙΚ Η
40 |
Κ Α ΛΥΨΗ Το ΥΓΕΙΑ έχει σύμβαση με τις περισσότερες ελληνικές και ξένες ιδιωτικές ασφαλιστικές εταιρείες. ΔΙΑΓΝΩΣΤΙΚ Α ΚΑΙ ΑΠΕΙΚΟΝΙΣΤΙΚ Α ΤΜ Η ΜΑΤΑ Το ΥΓΕΙΑ διαθέτει τα εξής Τμήματα:
PET/CT, Ακτινοδια
Πάρκινσον και Κινητικές Διαταραχές, Πολλαπλής Σκλή ρυνσης, Προληπτικού Ελέγχου Υγείας, Ρευματολογία, Τμήμα Σπονδυλικής Στήλης, Γενικοί Υπέρηχοι, Υπέρηχοι Καρδιάς, Φυσικής Ιατρικής και Αποκατάστασης, Ψυχο λογίας, ΩΡΛ κ.ά. ΤΕΧΝΟΛΟΓΙΚΟΣ
ΕΞΟΠΛΙΣΜ ΟΣ Το ΥΓΕΙΑ διαθέτει υπερσύγχρονο ιατρικό εξοπλισμό

AΦΙΕΡΩΜΑ | ΔΙΑΓΝΩΣΤΙΚΑ ΚΕΝΤΡΑ | 41
για όλo
και
Στο
γνωστικό, Ακτινοθεραπεία, Ακτινοχειρουργική Εγκεφά λου, Αναπνευστική Λειτουργία, Αξονική-Μαγνητική Το μογραφία, Απεικόνιση Μαστού, Βραχυθεραπεία Προ στάτη, Βρογχοσκοπικό Εργαστήριο, Γαστρεντερολογι κό, Γενετική Ογκολογία, Δερματολογικό, Διαιτολογία, Διακοπή Καπνίσματος, Καρδιολογικό, Ενδοκρινολογι κό, Ενδοκρινολογίας και Σακχαρώδους Διαβήτη, Ενδο σκοπικό, Ηπατολογικό, Κλινικής Ηλεκτροφυσιολογίας, Ιατρείο Πόνου, Ιατρική Φυσική, Ιατρείο post-Covid, Κυτταρολογικό, Μαγνητική Τομογραφία Καρδιάς, Μα στού, Μελέτη Διαταραχών Ύπνου, Νευροεκφυλιστικών Παθήσεων Εγκεφάλου - Ιατρείο Μνήμης, Νεφρολογικό Κέντρο, Οδοντικών Εμφυτευμάτων, Οστική Πυκνότητα, Οφθαλμολογικό, Ογκολογικό, Παθολογοανατομικό, •
το φάσμα των ιατρικών εξετάσεων
θερα πειών. Ενδεικτικά αναφέρουμε τα εξής:
Ακτινοδιαγνωστικό Τμήμα
Τέσσερα σταθερά μηχανήματα ακτινογραφή σεων, όλα με ψηφιακούς ανιχνευτές τεχνολογίας flat panel, από τα οποία το ένα είναι εγκατεστημένο στο
τμήμα Επειγόντων Περιστατικών. • Τέσσερα τηλεχειριζόμενα ακτινοσκοπικά ψηφιακά μηχανήματα τύπου C-Arm. o Τρία με διαμόρφωση διπλού επιπέδου (Biplane) καλύπτουν τις ανάγκες των επεμβατικών και αιμοδυνα μικών μονάδων και συνοδεύονται από τους αντίστοι χους σταθμούς εργασίας, για ανάλυση και επεξεργα σία ιατρικών εικόνων. o Ένα μονού επιπέδου καλύπτει τις συμβατικές ακτινοσκοπικές εξετάσεις του τμήματος. Το συγκε κριμένο μηχάνημα, με ψηφιακό ανιχνευτή flat panel, είναι εφοδιασμένο με ειδικό λογισμικό παλμικής ακτι νοσκόπησης και ειδικά διαμορφωμένα πρωτόκολλα, για μείωση της ακτινικής επιβάρυνσης. Συνοδεύεται επίσης από σταθμό εργασίας επεξεργασίας και ανά λυσης εικόνας. • Ένας ψηφιακός ορθοπαντογράφος για πανορα μικές γνάθων και κεφαλομετρικές ακτινογραφήσεις.
• Επτά φορητά ακτινογραφικά μηχανήματα με κα σέτες ψηφιακής πινακίδας και τέσσερα ψηφιακά φο ρητά C Arm ακτινοσκοπικά μηχανήματα για τις ακτινο γραφήσεις και ακτινοσκοπήσεις στα χειρουργεία και σε ασθενείς επί κλίνης. • Μία μονάδα ανάγνωσης των ψηφιακών πινακί δων CR (Computer Radiography). • Ένας ψηφιακός μαστογράφος με ανιχνευτή flat panel, στο Απεικονιστικό Τμήμα Μαστού. Συνοδεύεται από σύστημα στερεοτακτικών βιοψιών. Όλα τα μηχανήματα, συμπεριλαμβανομένης και των μονάδων CR για τις ψηφιακές πινακίδες, συνδέ ονται με τα συστήματα ηλεκτρονικών φακέλων HIS και RIS των νοσοκομείων και το σύνολο των ακτινο λογικών εξετάσεων διενεργείται με ηλεκτρονική λίστα εργασίας, περιορίζοντας έτσι στο ελάχιστο την πιθα νότητα λάθους στην καταγραφή των στοιχείων του εξεταζομένου. ΣΤΑ ΤΜ Η ΜΑΤΑ ΑΞΟΝΙΚ Η Σ (ΥΠΟΛΟΓΙΣΤΙΚ
τομογράφοι. Ειδικότερα, στο ΥΓΕΙΑ λειτουργούν 2 πολυτομικοί αξονικοί τομογράφοι 20 και 128 τομών αντιστοίχως, καθώς και ένας πολυτομικός αξονικός τομογράφος 64 τομών διπλής λυχνίας (SIEMENS DEFINITION dual source). Οι δύο τελευταίοι αξονικοί τομογράφοι είναι ιδανικοί για τη διενέργεια ειδικών και σύνθετων εξετάσεων, όπως η αξονική στεφανιο γραφία (αναίμακτη στεφανιογραφία), οι αξονικές αγ γειογραφίες ολόκληρου του σώματος και η αξονική κολονογραφία (εικονική κολονοσκόπηση). Επιπροσθέ τως, στο ΜΗΤΕΡΑ λειτουργεί πολυτομικός αξονικός το μογράφος 64 τομών. Παράλληλα, εφαρμόζονται πρω τόκολλα μείωσης της ακτινοβόλησης που υφίσταται ο ασθενής από τις εξετάσεις αξονικής τομογραφίας, για τη μείωση της δόσης ακτινοβολίας σε ποσοστό έως και 40%.
τις υψηλού επι πέδου ιατρικές υπηρεσίες τους καθ’ όλη τη διάρκεια του 24ώρου, 365 ημέρες το χρόνο. Εκτός από τις δια γνωστικές εξετάσεις, διενεργούνται όλων των τύπων οι διαδερμικές επεμβατικές πράξεις (διαγνωστικές και θεραπευτικές) σε οποιαδήποτε ανατομική περιοχή του σώματος. Αξονική (υπολογιστική) Τομογραφία Στα Τμήματα λειτουργούν 4 πολυτομικοί αξονικοί
Μαγνητική Τομογραφία Στα Τμήματα υπάρχουν εγκαταστημένοι 4 σύγχρονοι μαγνητικοί τομογράφοι. Ειδικότερα, στο ΥΓΕΙΑ λει τουργούν 2 μαγνητικοί τομογράφοι ισχύος 1,5 Tesla, καθώς και κορυφαίας τεχνολογίας μαγνητικός τομο γράφος ισχύος 3 Tesla. Ο τελευταίος θεωρείται ιδα νικός για τη διενέργεια εξετάσεων του μυοσκελετικού και του νευρικού συστήματος. Η τεχνολογία αιχμής του συστήματος ισχύος 3 Tesla επιτρέπει τη διενέργεια κορυφαίας ποιότητας ειδικών εξετάσεων, όπως η πολυπαραμετρική μελέτη του προ στάτη, η μαγνητική φασματοσκοπία του εγκεφάλου (MR spectroscopy), η λειτουργική μαγνητική τομογρα φία του εγκεφάλου (fMRI) και η μαγνητική δεσμιδογρα φία. Το Τμήμα αποτελεί Κέντρο Αναφοράς στην Ελλά δα για τη μαγνητική μαστογραφία, παρέχοντας τη δυ νατότητα διενέργειας και επεμβατικών πράξεων στο μαστό (διαδερμική βιοψία ή σήμανση βλαβών) με την καθοδήγηση του μαγνητικού τομογράφου. Επιπροσθέτως, στο ΜΗΤΕΡΑ λειτουργεί ανοικτός μαγνητικός τομογράφος ισχύος 1 Tesla, ο ισχυρότερος ανοικτός μαγνητικός τομογράφος στην Ελλάδα. Τμήμα Υπερήχων Καρδιάς Είναι πλήρως εξοπλισμένο εργαστήριο με τελευταίας τεχνολογίας μηχανήματα και δυνατότητες δισδιάστα της και τρισδιάστατης απεικόνισης. Καλύπτονται οι ανάγκες τόσο των νοσηλευομένων όσο και των εξω τερικών ασθενών.
ΕΣ Τηλ. 210 68 67 000, Ερυθρού Σταυρού 4 & Κηφισίας, 151 23 Μαρούσι, e-mail: info@hygeia.gr ■
ΠΛΗΡΟΦΟΡ
42 |
Η Σ) ΚΑΙ ΜΑΓΝΗΤΙΚ Η Σ ΤΟΜΟΓΡΑΦ Ι ΑΣ Τα ενοποιημένα Τμήματα Αξονικής (Υπολογιστικής) και Μαγνητικής Τομογραφίας των Nοσοκομείων ΥΓΕΙΑ και ΜΗΤΕΡΑ είναι εξοπλισμένα με μηχανήματα τελευ ταίας τεχνολογίας και
προσφέρουν
ΓΙΑ ΠΕΡΙΣΣΟΤΕΡΕΣ
Ι

ΜικροβιολογίαςΒιοπαθολογίας του Ομίλου Affidea πρωτοπορούν στο χώρο της Υγείας, χρησιμοποιώντας πλήρως αυτοματο ποιημένες διαδικασίες. Καλύπτουν όλο το φάσμα των εργαστηριακών εξετάσεων, ρουτίνας και εξειδικευμένες, που απαιτούνται για τη διάγνωση, παρακολούθηση και θεραπεία των εξεταζομένων. Τα Εργαστήρια της Affidea διαθέτουν έμπειρο και
εξειδικευμένο προσωπικό και εφαρμόζουν διεθνή πρό τυπα και πρακτικές. Διασφαλίζουν και αποδεικνύουν την ποιότητα λειτουργίας τους, εφαρμόζοντας Σύστημα Δι αχείρισης Ποιότητας, σύμφωνα με το Διεθνές Πρότυπο ΕΛΟΤ EN ISO 9001:2015. Τα Βιοπαθολογικά Διαγνωστικά Εργαστήρια του Ομί λου Affidea έχουν διαπίστευση κατά το Διεθνές Πρότυπο ΕΛΟΤ ΕΝ ISO 15189:2012 για τις κλινικές δοκιμές που
Εδώ και αρκετά χρόνια έχουμε επιλέξει το δρόμο των επενδύσεων και της συνεχούς εξέλιξης και ανάπτυξης. Θα συνεχίσουμε όσο πιο δυνατά μπορούμε και τα επόμενα χρόνια. Αυτό τονίζει ο κ. Θεόδωρος Καρούτζος, διευθύνων σύμβουλος της Affidea Ελλάδος, αναφερόμενος στις προοπτικές και τα σχέδια του Στο πλαίσιο αυτό, έχουμε εντάξει στον στρατηγικό σχεδιασμό μας το άνοιγμα νέων διαγνωστικών και δερματολογικών κέντρων, τα οποία έχουν σκοπό να εξυπηρετήσουν τις ανάγκες των κατοίκων σε ευρύτερες περιοχές της Ελλάδας και της Αττικής, αλλά και νέες υπηρεσίες που θα διευκολύνουν την καθημερινότητα και θα βελτιώσουν την ποιότητα ζωής των συμπολι τών μας. Είναι συγκινητικό πόσοι πολίτες μας ρωτούν πότε θα ανοίξουν τα νέα κέντρα. Πολύ σύντομα θα είμαστε κοντά τους, καταλήγει ο κυριος Καρούτζος και συμπληρώνει το μότο «πάνω από όλα είναι η υγεία», για εμάς στην Affidea δεν αποτελεί απλά μια έκφραση. Πρόκειται για μήνυμα απόλυτα συνυφασμένο με τον τρόπο σκέψης μας και τις καθημερινές μας πρακτικές. O κ. Θεόδωρος Καρούτζος.


44 | ΤΑ ΥΠΕΡΣ Υ ΓΧΡΟΝΑ ΕΡΓΑΣΤ Η ΡΙΑ
Ο όμιλος με τα περισσότερα διαπιστευμένα Βιοπαθολογικά Εργαστήρια
διενεργούνται στο χώρο τους. Συγκεκριμένα, ο Όμιλος Αffidea έχει τα περισσότερα διαπιστευμένα Βιοπαθολο γικά Εργαστήρια στα Βαλκάνια κατά το Διεθνές Πρότυπο ΕΛΟΤ ΕΝ ISO 15189:2012. Η τεχνική επάρκεια ενός Ιατρικού Εργαστηρίου για την έκδοση αξιόπιστων αποτελεσμάτων αναγνωρίζεται και βεβαιούται επίσημα μόνο με τη διαπίστευση. Αυτό προκύπτει μετά την επιτυχή αξιολόγηση των Βιοπαθο

λογικών Εργαστηρίων του ομίλου για την πιστή συμ μόρφωσή τους προς τις απαιτήσεις του ειδικού για τα Ιατρικά Εργαστήρια Διεθνούς Προτύπου ΕΛΟΤ ΕΝ ISO 15189:2012 από τον Εθνικό Φορέα, το Εθνικό Σύστημα Διαπίστευσης (ΕΣΥΔ). Τα Βιοπαθολογικά Διαγνωστικά Εργαστήρια της Affidea εφαρμόζουν σε καθημερινή βάση Εσωτερικό Έλεγχο Ποιότητας της Αναλυτικής Φάσης με τη χρήση

αυτά διοργανώνονται από την εταιρεία BIORAD & την Ελληνική Αιματολογική Εταιρεία. Πρόκειται για Διαπι στευμένα Σχήματα, σύμφωνα με το Ευρωπαϊκό Πρότυπο ISO/IEC 17043:2010. Βασική αρχή και δέσμευση των Εργαστηρίων της Affidea είναι να παρέχουν στους εξεταζομένους και θε ράποντες ιατρούς υπηρεσίες που να καλύπτουν πλή ρως τις απαιτήσεις Από την ίδρυσή της και μέχρι σήμερα η Affidea ήταν και παραμένει σταθερή στην παροχή εξελιγμένων, σύγχρονων και εξατομικευμένων υπηρεσιών υγείας για όλους.

Affidea
δεσμευτεί.
46 |
τους και να ικανοποιούν τις ιατρικές υπηρεσίες υψηλού επιπέδου ποιότητας για τις οποίες η
έχει
διαλυμάτων ελέγχου (controls) σε όλα τα επίπεδα συγκέ ντρωσης των παραμέτρων, όπως αυτά διατίθενται στο εμπόριο από τις παρασκευάστριες εταιρείες τους. Με τον Εσωτερικό Έλεγχο Ποιότητας ελέγχονται η επαναληψιμό τητα και η ακρίβεια όλων των αναλυτικών μεθόδων που πραγματοποιούνται. Με αυτόν τον τρόπο εντοπίζονται τα σφάλματα τη στιγμή που προκύπτουν, με συνέπεια τη διασφάλιση της αξιοπιστίας των εργαστηριακών αποτελεσμάτων. Επιπλέον, σχεδιάζονται, τηρούνται και αξιολογούνται διαγράμματα ελέγχου Ποιότητας LeveyJennings, εφαρμόζοντας τις μεθόδους των πολλαπλών κριτηρίων, ευρέως γνωστή ως μέθοδος Westgard. Επιπρόσθετα, τα Βιοπαθολογικά Διαγνωστικά Ερ γαστήρια της Affidea συμμετέχουν σε Διεργαστηριακά Σχήματα Ελέγχου Ικανότητας (Proficiency Testing), γνω στά ως Εξωτερικός Έλεγχος Ποιότητας. Τα σχήματα συγκεκριμένης στρατηγικής για την ποιότητα και την αξιοπιστία. Για τον ίδιο λόγο ο Όμιλος Affidea επενδύει σε τελευ ταίας τεχνολογίας μηχανήματα και σε πρωτοποριακές
Η συνδυαστική εφαρμογή των δύο προτύπων συστημάτων ποιότητας ISO 9001 και ISO 15189 αποτελεί τη βάση για την εφαρμογή μιας
μεθόδους, εφαρμόζοντας διαδικασίες που αποσκοπούν στη διαφύλαξη της ασφάλειας των εξεταζομένων και παράλληλα στη διασφάλιση του βέλτιστου ιατρικού απο τελέσματος. Έτσι το σύστημα της Roche Diagnostics, που έχει εγκατασταθεί στο μητροπολιτικό Βιοπαθολογικό Εργαστήριο της Affidea στην Καλλιθέα, βελτιώνει την παραγωγικότητα, ενισχύει την αξιοπιστία και μειώνει τους χρόνους έκδοσης αποτελεσμάτων. Αξίζει να ση μειωθεί ότι αυτή είναι η πρώτη εγκατάσταση του καινο τόμου συστήματος cobas® pro που πραγματοποιήθηκε στην Ελλάδα. Η σειρά αναλυτών cobas® pro παρέχει ψηφιακές λύσεις για όλα τα στάδια των απαιτητικών εργασι ών του Εργαστηρίου. Σχεδιασμένη για υψηλό όγκο εξετάσεων, επιτυγχάνει νέα επίπεδα σε υψηλή ταχύ τητα, έξυπνη δυναμική δείγματος και βελτιώσεις στη ροή εργασιών, ενώ ταυτόχρονα διασφαλίζει βέλτιστη απόδοση για μεμονωμένους ασθενείς. Συμμορφώνεται με τα υψηλότερα πρότυπα ποιότητας και ασφάλειας, ενώ η έξυπνη διαχείριση δειγμάτων, αντιδραστηρίων και αποτελεσμάτων ενισχύει ακόμα περισσότερο την αποτελεσματικότητα, προσδίδοντας μια νέα διάσταση όσον αφορά στην παραγωγικότητα, στην καινοτομία της διαδικασίας και την ενοποίηση. Για τη μέτρηση κάθε εξέτασης χρησιμοποιούνται οι τελευταίες τεχνολογίες που ελαχιστοποιούν τα σφάλ ματα που μπορεί να επηρεάσουν τη ροή εργασίας του
Εργαστηρίου. Επιπρόσθετα, απλοποιήσεις και αυτομα τοποιήσεις στις συντηρήσεις των αναλυτών βοηθούν στη σταθερή ποιότητα των αποτελεσμάτων. Και το πιο σημαντικό, είναι τελευταίας γενιάς, ελα χιστοποιώντας την ποσότητα πλαστικού που χρησιμο ποιείται τόσο σε αναλώσιμα όσο και σε συσκευασίες αντιδραστηρίων. Έτσι λοιπόν απαιτείται μικρότερος όγκος δείγματος, αντιδραστηρίων και νερού για την εκτέλεση των εξετάσεων, γεγονός που έχει σαν άμεσο αποτέλεσμα να παράγονται μικρότεροι όγκοι αποβλή των. Με τον τρόπο αυτόν ο Όμιλος Affidea μειώνει το οικολογικό αποτύπωμα τόσο στη διαδικασία παραγω γής των υλικών αυτών όσο και στην απόρριψή τους, εφαρμόζοντας βέλτιστες πρακτικές κοινωνικής υπευ θυνότητας και βιώσιμης ανάπτυξης στον στρατηγικό σχεδιασμό του, λειτουργώντας με υπευθυνότητα και ευαισθησία σε κάθε τομέα της δραστηριότητάς του. Από την ίδρυσή της και μέχρι σήμερα η Affidea ήταν και παραμένει σταθερή στην παροχή εξελιγμένων, σύγχρονων και εξατομικευμένων υπηρεσιών υγείας για όλους, κάνοντας πράξη καθημερινά τις αξίες που υποδηλώνει το όνομά της: αμοιβαιότητα στις σχέσεις, αξιοπιστία στη διάγνωση, καινοτομία στις πρακτικές. Η αξιοπιστία των αποτελεσμάτων, η ακρίβεια της διά γνωσης, η τεχνολογία αιχμής και η ηθική δεοντολογία είναι τα κριτήρια που καθοδηγούν καθημερινά όλους τους ανθρώπους του Ομίλου Affidea. ■

| 47 AΦΙΕΡΩΜΑ | ΔΙΑΓΝΩΣΤΙΚΑ ΚΕΝΤΡΑ


48 | Σημαντική διάκριση για την Affidea στα κορυφαία Βραβεία LaingBuisson Health Awards 2022! Η AFFIDEA, Ο ΜΕΓΑΛΥ ΤΕΡΟΣ Π Α ΡΟΧΟΣ προηγμένων διαγνωστικών και εξωνοσοκομειακών υπηρεσιών στην Ευρώπη, απέσπασε μία πολύ σημαντική διάκριση στη Με αφορμή τη σημαντική αυτή διάκριση που έλαβε η AFFIDEA σε διεθνές επίπεδο, η οποία αντανακλά και στα κέντρα της που βρίσκονται στην Ελλάδα, το «Health By NextDeal» επέλεξε να την προβάλει στο εξώφυλλό του! φετινή τελετή απονομής βραβείων LaingBuisson στην κατηγορία «Διαγνωστικά Κέντρα και Πρωτοβάθμια Φροντίδα». Τα βραβεία LaingBuisson είναι από τα πιο υψηλού κύρους βραβεία στον τομέα της Υγείας, τιμώ ντας τις εταιρείες που θέτουν νέα πρότυπα αριστείας και έχουν θετικό αντίκτυπο στην κατηγορία τους. Φέτος, για 17η χρονιά αναγνωρίζεται η αριστεία στον τομέα
της Υγείας, με επίκεντρο τους παρόχους υγείας. Η Affidea τιμήθηκε με το βραβείο αυτής της κατηγο ρίας για το καινοτόμο Πρόγραμμα «Dose Excellence» που εφαρμόζει κατ’ αποκλειστικότητα για την ασφάλεια των ασθενών. Μέσω αυτού του προγράμματος βελτι στοποίησης της δόσης ακτινοβολίας κατά τη διενέργεια αξονικής τομογραφίας, η εταιρεία αναλύει πληροφορίες από περισσότερες από 75.000 αξονικές τομογραφίες κάθε μήνα, επιτυγχάνοντας κατά μέσο όρο 40% μεί ωση του επιπέδου δόσης ακτινοβολίας στις αξονικές τομογραφίες σε όλο το δίκτυό της, για να αυξήσει την ασφάλεια των ασθενών, διατηρώντας παράλληλα την ποιότητα
Imaging Stars από την Ευρωπαϊκή Εταιρεία Ακτινολογίας (European Society of Radiology ESR) για τη συμβολή τους στην ασφάλεια των ασθενών ως προς τη δόση ακτινοβολίας, ενώ κατατάσσονται στη λίστα «Wall of Stars» μαζί με την «αφρόκρεμα» των νοσοκομείων της Ευρώπης.
Ο Guy Blomfield, πρόεδρος του Συμβουλίου και δι ευθύνων σμβουλος της Affidea, δήλωσε: «Είναι τιμή μας να λαμβάνουμε αυτό το βραβείο. Αποτελεί απόδειξη όλων των προσπαθειών και των επιτευγμάτων μας για τη διασφάλιση των υψηλότερων επιπέδων ασφάλειας των ασθενών, εφαρμόζοντας αυστηρά κλινικά πρωτό κολλα και καινοτόμα εργαλεία. Θέλω να ευχαριστήσω όλες τις ομάδες μας, και ιδιαίτερα τα μέλη της ομάδας Dose Excellence, για την αφοσίωση, τη δέσμευση, το πάθος και τη σκληρή δουλειά που κάνουν πίσω από τα παρασκήνια. Αυτή η βράβευση αναγνωρίζει την υψηλή ποιότητα παροχής υπηρεσιών μας και είμαι υπερήφα νος γι’ αυτό». Ο Δρ Alessandro Roncacci, SVP Chief Medical Officer, πρόσθεσε: «Αυτή είναι άλλη μια απόδειξη της ισχυρής συμμόρφωσής μας με την Οδηγία Euratom 2013/59, εντοπίζοντας παραλλαγές σε πραγματικό χρόνο και τυπο ποιώντας και βελτιστοποιώντας τα πρωτόκολλα αξονικής τομογραφίας CT, διατηρώντας τα χρυσά πρότυπα για την ποιότητα της απεικόνισης και την αυξημένη ασφάλεια των ασθενών μας. Το 2023 έχουμε στόχο να επεκτείνουμε τη νέα έκδοση του Προγράμματος Dose Excellence σε όλες τις χώρες όπου δραστηριοποιείται η Affidea, με γνώμονα τη σταθερή δέσμευσή μας για τα υψηλότερα πρότυπα ασφάλειας των ασθενών». Ο Θεόδωρος Καρούτζος, διευθύνων σύμβουλος της Affidea Ελλάδος, τόνισε: «Η σημασία της βράβευ σης είναι μέγιστη, αν αναλογισθεί κανείς ότι πρόκειται για τον μοναδικό πάροχο πρωτοβάθμιας φροντίδας υγείας διεθνώς που βραβεύεται με την ανώτατη αυτή διάκριση για την ασφάλεια των ασθενών από πλευράς ακτινοπροστασίας και για την υψηλή ποιότητα των ια τρικών υπηρεσιών, ενώ κατατάσσεται στη λίστα με τα κορυφαία νοσοκομεία της Ευρώπης. Η προσπάθεια των έμπειρων και καταξιωμένων ιατρών μας ανταμείβεται και ομολογουμένως η διασφάλιση της χαμηλότερης δόσης ακτινοβολίας αποτελεί μία προστιθέμενη αξία για τους εξεταζομένους μας, βελτιώνοντας τις υπηρεσίες υγείας πανευρωπαϊκά». Η τελετή απονομής των βραβείων πραγματοποιήθηκε στο Park Westminster Bridge και την παρακολούθησαν περισσότεροι από 1.000 σημαντικοί εκπρόσωποι από τον κλάδο της Υγείας. Αυτό το βραβείο είναι το δεύτερο που λαμβάνει φέτος η Affidea. Τον Ιούνιο, η εταιρεία βραβεύτηκε με το Βραβείο «Diagnostic Provider of the Year» στα HealthInvestor Awards 2022. ■

| 49 ΑΦΙΕΡΩΜΑ | ΔΙΑΓΝΩΣΤΙΚΑ ΚΕΝΤΡΑ
της εικόνας για ακριβή διάγνωση. Πρόσφατα, η Affidea αναβάθμισε το πρόγραμμα με την έκδοση 3.2 του λογισμικού DoseWatch, σε συν δυασμό με ένα εργαλείο επιχειρηματικής
(BI) για ανάλυση δεδομένων σε πραγματικό χρόνο, με τα κέντρα της Affidea Ουγγαρίας και Ισπανίας να είναι τα πρώτα που το εφάρμοσαν. Το επόμενο βήμα είναι η διαχείριση δεδομένων σκιαγραφικών μέσων, η οποία επιτρέπει ενημερώσεις σχετικά με το κλινικό πλαίσιο και την αθροιστική δόση ιωδίου (παράγοντες
προηγούμενες ανεπιθύμητες ενέργειες),
λεπτομέρειες της χορήγησης (σκιαγραφικό
νοημοσύνης
κινδύνου,
καθώς και τις
μέσο, χο ρηγούμενος όγκος, πρωτόκολλο έγχυσης). Χάρη στην παρακολούθηση και τη βελτιστοποίηση των σκιαγρα φικών μέσων, η εταιρεία μπορεί να εξατομικεύσει την έγχυση σε κάθε ασθενή, αποφεύγοντας την περιττή έγχυση σκιαγραφικού. Στην Ελλάδα, όλα τα κέντρα που συμμετέχουν στο πρόγραμμα έχουν τιμηθεί με αστέρια EuroSafe
Ο ΟΜΙΛΟΣ ΕΤΑΙΡΕΙΩΝ ΥΓΕΙΑΣ ΒΙΟΪΑΤΡΙΚΗ δραστηριο ποιείται στον κλάδο των υπηρεσιών υγείας από το 1981. Σήμερα αποτελεί τον κορυφαίο ιδιωτικό φορέα παροχής ιατρικών υπηρεσιών πρωτοβάθμιας περίθαλψης, με 70 αυτόνομα Διαγνωστικά Κέντρα σε Ελλάδα και Κύπρο, τα οποία δέχονται περισσότερες από 3.000.000 επισκέψεις το χρόνο. Ο Όμιλος ΒΙΟΪΑΤΡΙΚΗ διαθέτει επίσης δύο Κλι νικές, τη Βιοκλινική Αθηνών και Θεσσαλονίκης, οι οποίες αποτελούν πρότυπα σύγχρονων νοσοκομειακών μονά δων υψηλής ποιότητας, ένα Κέντρο Διεθνών Ασθενών και 7 Οδοντιατρικές Μονάδες (σε Αθήνα, Άλιμο, Καλλι θέα, Κηφισιά, Περιστέρι, Θεσσαλονίκη, Καλαμαριά). Ο όμιλος συνεργάζεται με περισσότερες από 400 ιδιωτικές εταιρείες, τις μεγαλύτερες ασφαλιστικές εταιρείες και με όλα τα δημόσια ασφαλιστικά ταμεία. Ο όμιλος κατέχει το πλειοψηφικό πακέτο μετοχών του μεγαλύτερου Κλινικού Εργαστηρίου της Κύπρου, της YIANNOUKAS MEDICAL LABORATORIES LTD, με έδρα τη Λευκωσία, και έχει εξαγοράσει πλήρως το
απεικονιστικό εργαστήριο «ΑΛΦΑ ΕΥΡΕΣΙΣ». Κατόπιν δι εθνούς διαγωνισμού, το Γερμανικό Ογκολογικό Κέντρο ανέθεσε στο Χημείο Γιαννουκά | ΟΜΙΛΟΣ ΒΙΟΪΑΤΡΙΚΗ τον εξοπλισμό, την επάνδρωση και τη λειτουργία του κλινικού εργαστηρίου εντός των εγκαταστάσεών του. Μέσα σε ένα διαρκώς μεταβαλλόμενο κοινωνικό και οικονομικό περιβάλλον, ο όμιλος συνεχίζει την ανα πτυξιακή του πορεία υλοποιώντας ένα πολυδιάστατο επενδυτικό πρόγραμμα με στόχο την επέκταση σε ευ ρωπαϊκές χώρες. Η συνεχής αναβάθμιση των παρεχό μενων υπηρεσιών, με καινοτόμα εργαλεία εύκολα προ σβάσιμα σε όλους και πάντα με στόχο τη βελτίωση της ποιότητας ζωής των ανθρώπων, ήταν το όραμα του ιδρυτή Ευάγγελου Σπανού από την πρώτη

50 |
στιγμή στη ΒΙΟΪΑΤΡΙΚΗ. Μέχρι και σήμερα όλοι στον Όμιλο ΒΙΟΪ ΑΤΡΙΚΗ αγωνίζονται καθημερινά για τον ίδιο στόχο. ΑΛΦΑ ΕΥΡΕΣΙΣ Το Διαγνωστικό Απεικονιστικό Κέντρο ΑΛΦΑ ΕΥΡΕΣΙΣ στη Όμιλος Εταιρειών Υγείας
Λευκωσία ενσωματώθηκε στον Όμιλο ΒΙΟΪΑΤΡΙΚΗ το 2018. Δημιουργήθηκε με στόχο και όραμα την παροχή υπηρεσιών υψηλού επιπέδου στον τομέα της Πρωτοβάθ μιας Φροντίδας Υγείας, με την αξιοποίηση σύγχρονων τεχνολογιών και μεθόδων στη διάγνωση και την επεμ βατική ακτινολογία, αλλά και με συμμετοχή στην έρευνα του τομέα της Ιατροβιοτεχνολογίας. Σήμερα είναι ένα πρότυπο ολοκληρωμένο Απεικονιστικό, Διαγνωστικό και Επεμβατικό Κέντρο, εξοπλισμένο αποκλειστικά με σύγχρονα μηχανήματα χαμηλής ακτινοβολίας, ενώ ξε χωρίζει για την αξιόπιστη αλλά προπάντων ανθρώπινη προσέγγιση που προσφέρει στους εξεταζόμενους. Το ΑΛΦΑ ΕΥΡΕΣΙΣ παρέχει ποιοτικές διαγνωστικές υπηρεσίες σε ιδιώτες, ιατρούς, ασφαλισμένους ιδιω τικών ασφαλιστικών εταιρειών και εργαζομένους σε ιδιωτικές εταιρείες. Παράλληλα, εξυπηρετεί ασθενείς από το εξωτερικό που επισκέπτονται ή διαμένουν στην
Κύπρο. Το Διαγνωστικό Κέντρο ΑΛΦΑ ΕΥΡΕΣΙΣ διενεργεί ένα ευρύ φάσμα απεικονιστικών εξετάσεων στα ακόλουθα
τμήματα:
• Μαγνητική Τομογραφία.
• Αξονική Τομογραφία.
• Ψηφιακή Μαστογραφία.
• Υπερηχοτομογράφος.
• Ενδοσκοπικός Υπέρηχος.
• Ηπατική Ελαστογραφία.
• Ψηφιακό Ακτινολογικό.
• Ψηφιακό Ορθοπαντογράφο 3D Dental.
• Οστεοπόρωση.
Χημείο Γιαννουκά
Το Χημείο Γιαννουκά εντάχθηκε στον Όµιλο ΒΙΟΪΑΤΡΙ ΚΗ Ελλάδας στα τέλη του 2017 και µετονοµάστηκε σε ΧΗΜΕΙΟ ΓΙΑΝΝΟΥΚΑ | ΟΜΙΛΟΣ ΒΙΟΪΑΤΡΙΚΗ. Με τη νέα του πλέον ταυτότητα, έχει επεκτείνει τη δραστηριότη τά του σε όλη την Κύπρο, με παραρτήματα σε: Άγιο Δομέτιο, Αγλαντζιά, Αστρομερίτη, Λακατάμια, Λατσιά, Μακεδονίτισσα, Στρόβολο, Αρεδιού, Τσέρι, Πάφο, Λε μεσό, Λάρνακα. Παράλληλα διαθέτει και ειδικές κινητές μονάδες για κατ’ οίκον αιμοληψία. Στο Χημείο έχει εγκατασταθεί ρομποτικό σύστημα
Γερμανικό Ογκολογικό Κέντρο Το Γερμανικό Ογκολογικό Κέντρο (GOC) προσφέρει υπηρεσίες υψηλού επιπέδου σε καρκινοπαθείς και δι αθέτει μεταξύ άλλων σύγχρονα τμήματα εξωτερικής και επεμβατικής ακτινοθεραπείας, θαλάμους ραδιενεργού ιωδίου και τμήμα PET SCAN.
διαπίστευσης εξετάσεων
ISO 15189. Ως μέλος του Ομίλου ΒΙΟΪΑΤΡΙΚΗ μπορεί πλέον
να προσφέρει πάνω από 400 πιστοποιημένες εξετάσεις
και συνολικά πάνω από 3.000 διαφορετικές εξετάσεις.
ΕΞΟΠΛΙΣΜ ΟΣ Ο Όμιλος Εταιρειών Υγείας ΒΙΟΪΑΤΡΙΚΗ διαθέτει άρτιο εξοπλισμό με μηχανήματα τελευταίας τεχνολογίας, τα οποία συμβάλλουν καθοριστικά στην αξιοπιστία, στη μείωση του χρόνου λήψης των αποτελεσμάτων, αλλά και στην ασφαλέστερη διενέργεια της κάθε εξέτασης. Στη Βιοϊατρική Αμπελοκήπων στην Αθήνα και στη Βιοϊατρική Καλαμαριάς στη Θεσσαλονίκη λειτουργεί το Discovery IQ PET/CT (της GE Healthcare, 5 rings στην Αθήνα, 3 rings στη Θεσσαλονίκη), που αποτελεί την πιο σύγχρονη τεχνολογία στην κατηγορία της ποζιτρονικής αξονικής τομογραφίας. Ο όμιλος είναι εξοπλισμένος με σύγχρονους μα γνητικούς τομογράφους των εταιρειών GE και Philips για την κάλυψη όλων των εφαρμογών. Στο σύνολο των συστημάτων περιλαμβάνονται και δύο ανοικτού τύπου μαγνητικοί τομογράφοι κατάλληλοι για εξεταζόμενους με προβλήματα κλειστοφοβίας. Στη Βιοϊατρική Αμπελοκήπων λειτουργεί μαγνητικός τομογράφος MR Optima 450W with GEM Suite της GE Healthcare, 1.5 Tesla, ένα δυνατό σύστημα, ικανό να αντε πεξέλθει σε όλες τις απαιτήσεις της σύγχρονης μαγνητι κής απεικόνισης. Είναι ένας ευρύς, φωτεινός μαγνητικός τομογράφος, με ανοιχτό σχεδιασμό, χαρακτηριστικά που μπορούν να βοηθήσουν τον υπέρβαρο ασθενή ή τον εξεταζόμενο που αισθάνεται κλειστοφοβία. Το σύστημα έχει δυνατότητα λήψης εικόνων και εκτέλεσης εξετάσεων, χρησιμοποιώντας ακολουθίες silent, μηδενίζοντας ουσιαστικά το θόρυβο που ακούει ο εξεταζόμενος κατά την ώρα της εξέτασης, η οποία γίνεται πλέον ευχάριστη για τον ενήλικα εξεταζόμενο, ενώ οι μικροί ασθενείς μπορούν να κοιμηθούν την ώρα της εξέτασης. Ιδιαίτερη έμφαση έχει δοθεί στις πλέον απαιτητικές εφαρμογές του μαγνητικού τομογράφου, την ολόσωμη Μαγνητική Αγγειογραφία και Μαγνητική Τομογραφία καρδιάς ενηλίκων και παιδιών. Στον εξοπλισμό των τμημάτων Μαγνητικής Τομογρα φίας περιλαμβάνεται σύστημα που δίνει τη δυνατότητα για μία από τις πλέον σύγχρονες εφαρμογές του μαγνη τικού τομογράφου, την ολόσωμη Μαγνητική Τομογραφία (Whole Body Imaging Virtual PET) ως μέθοδο screening και ως μέθοδο παρακολούθησης νεοπλασιών. Ο Όμιλος ΒΙΟΪΑΤΡΙΚΗ διαθέτει ακόμα τον μαγνητικό τομογράφο DISCOVERY MR 750 3.0 Tesla, της General
| 51 AΦΙΕΡΩΜΑ | ΔΙΑΓΝΩΣΤΙΚΑ ΚΕΝΤΡΑ
διασύνδεσης αναλυτών VersaCell X3 της SIEMENS, αλλά και πλήρως αυτοματοποιημένοι αναλυτές για καλλιέρ γειες της BD BACTEC & PHOENIX, καλύπτοντας πρωτο ποριακά τους τομείς Βιοχημείας και Μικροβιολογίας. Το ΧΗΜΕΙΟ ΓΙΑΝΝΟΥΚΑ | ΟΜΙΛΟΣ ΒΙΟΪΑΤΡΙΚΗ είναι ένα από τα πρώτα κλινικά εργαστήρια στην Κύπρο που εφάρμοσαν το διεθνές πρότυπο
Electric, μοναδικό στο είδος του στην Ελλάδα, με και νοτόμες εφαρμογές στο πλαίσιο της πρόληψης και της σωστής διάγνωσης. Αυξάνει την ισχύ διείσδυσης στα εξεταζόμενα όργανα, βελτιώνει την ποιότητα των εικό νων και ελαττώνει σημαντικά τους χρόνους εξέτασης και λήψης των αποτελεσμάτων. Όλα τα συστήματα αξονικών τομογράφων του Ομίλου ΒΙΟΪΑΤΡΙΚΗ είναι τελευταίας γενιάς, ώστε να εξασφαλί ζουν υψηλή ποιότητα και ελεγχόμενη δόση ακτινοβολίας. Στον εξοπλισμό περιλαμβάνονται 25 αξονικοί τομογρά φοι πολλών ανιχνευτών (64 τομών), καθώς και συστή ματα εξειδικευμένα στην κάλυψη των καρδιολογικών εφαρμογών (αξονική τομογραφία καρδιάς και αξονική στεφανιογραφία), κορυφαίας τεχνολογίας. Ο αξονικός τομογράφος DISCOVERY CT 750 High Definition της General Electric έχει ως κύριο χαρακτηρι στικό τη σημαντική μείωση της δόσης της ακτινοβολίας που δέχεται ο εξεταζόμενος (έως και 83% λιγότερο), με ταυτόχρονη δυνατότητα εκτέλεσης Spectral Imaging, μείωση της δόσης ακτινοβολίας με ταυτόχρονη βελτί ωση της ποιότητας της εικόνας. Τα ακτινολογικά εργαστήρια είναι εξοπλισμένα με ακτινολογικά και ακτινοσκοπικά μηχανήματα, τα οποία υποστηρίζονται με ψηφιακά συστήματα εξασφαλίζοντας υψηλής ποιότητας και διακριτικής ικανότητας απεικόνιση. Με συνέπεια στην τεχνολογική εξέλιξη και ιδιαίτερη έμφαση στην ποιότητα της μαστογραφίας, οι ψηφιακοί και οι κλασικοί

τελευταίας
των εργαστηρίων του ομί
χαμηλής δόσης και
διακριτικής ικανότητας. Σύγχρονα συστήματα ορθοπαντομογράφων, κλα σικά και ψηφιακά, δίνουν τη δυνατότητα αξιόπιστων οδοντιατρικών απεικονίσεων (κεφαλομετρικές και πα νοραμικές λήψεις). Τα τμήματα Πυρηνικής Ιατρικής είναι εξοπλισμένα με συστήματα γ-camera, μονής ή διπλής κεφαλής, εφο διασμένα με κατευθυντήρες καταλλήλους για διαφο
ρετικές ενέργειες, ώστε να ανταποκρίνονται σε όλο το φάσμα των ραδιοϊσοτόπων, σπινθηρογραφημάτων και μελετών [στατικές, δυναμικές, ολόσωμες (whole body) και τοπογραφικές (SPECT) μελέτες]. ΕΞΕΤΑ ΣΕΙΣ Στον Όμιλο ΒΙΟΪΑΤΡΙΚΗ διενεργείται όλο το φάσμα εργα στηριακών και απεικονιστικών εξετάσεων, από τις απλές εξετάσεις ρουτίνας μέχρι τον πλήρη και εξειδικευμένο έλεγχο. Αναλυτικότερα ανά κατηγορία εξετάσεων τα Τμήματα που λειτουργούν είναι τα εξής: Τμήματα Εργαστηριακών Εξετάσεων: Αιματολογικό, Αναλυτικής Βιοχημείας, Ανοσολογίας και Ιστοσυμβατό τητας, Γενετικής και Μοριακής Βιολογίας, Εργαστηρια κής Ενδοκρινολογίας, Ηλεκτροφορήσεων, Κλινικής Χη μείας, Κυτταρολογικό, Μικροβιολογικό, Μυκητολογίας, Ορμονολογικό, Παθολογοανατομικό. Τμήματα Απεικονιστικών Εξετάσεων: PET/CT, Ακτι νολογικό, Αξονικής Τομογραφίας, Μέτρησης Οστικής Πυκνότητας, Κατευθυνόμενων Παρακεντήσεων, Μα γνητικής Τομογραφίας, Πυρηνικής Ιατρικής, Υπερήχων. Τμήματα Ειδικών Εξετάσεων: Δερματολογικό Κέντρο, Διαγνωστικό Εργαστήριο Μαστού, Διατροφολογικό και Εργομετρικό Κέντρο, Ελέγχου Νεοπλασιών, Καρδιολο γικό, Κέντρο Προληπτικής Ιατρικής και Μακροβιότητας, Παιδιατρικό Διαγνωστικό Κέντρο, Νευροακτινολογικής Απεικόνισης, Ορθοπαιδικό (Πελματογραφίας), Οφθαλ μολογικό, Προγεννητικού Ελέγχου, Προληπτικού Ελέγ χου (CHECK UP), Τοξικών Ουσιών, Φυσικής Ιατρικής και Αποκατάστασης, Ψηφιακής Μαστογραφίας, ΩΡΛ. Κ Ε ΝΤΡΟ ΠΡΟΛΗΠΤΙΚ Η Σ ΙΑΤΡΙΚ Η Σ ΚΑΙ ΜΑΚΡΟΒΙ ΟΤΗΤΑΣ Προγράμματα Προληπτικού Ελέγχου Check Up Το Κέντρο Προληπτικής Ιατρικής και Μακροβιό τητας, ανταποκρινόμενο στις απαιτήσεις της εποχής, εφαρμόζει μία καινοτόμο προσέγγιση στον τομέα της
52 |
μαστογράφοι
λου είναι
τεχνολογίας
υψηλής
πρόληψης. Οι νέες υπηρεσίες περιλαμβάνουν: α) Δομημένα προγράμματα προληπτικού ελέγχου ανά ηλικία και φύλο. β) Εξειδικευμένα προγράμματα προληπτικού ελέγχου στοχευμένα στη διαχείριση νόσων υψηλού επιπολασμού. γ) Ειδικούς ελέγχους που σχετίζονται με τη νόσο COVID-19. Ειδικότερα, πραγματοποιούνται τα εξής προγράμ ματα: Προγράμματα Προληπτικού Ελέγχου για Παιδιά Αφορά παιδιά προσχολικής και σχολικής ηλικίας

μέχρι 18 ετών. Πραγματοποιείται συνολική σε βάθος αξιολόγηση της υγείας του παιδιού, στον ίδιο χώρο, με μία μόνον επίσκεψη, ολοκληρωμένη καρδιολογική αξιολόγηση με triplex καρδιάς και ηλεκτροκαρδιογρά

φημα, εξέταση από 3 ή 4 κλινικούς ιατρούς ανάλογα με το πρόγραμμα επιλογής, χορήγηση πιστοποιητικού υγείας για άθληση, συνταγή γυαλιών οράσεως από οφθαλμίατρο (για παιδιά άνω των 12 ετών). Εξάλλου η ΒΙΟΪΑΤΡΙΚΗ έχει σχεδιάσει το πρόγραμμα προαθλητικού ελέγχου Kids’ Pre-Sports Testing με στό χο τη μεθοδική αξιολόγηση της συστηματικής υγείας, την οργανική αρτιότητα και ασφάλεια των παιδιών που πρόκειται να ασχοληθούν σε σχολικό ή αθλητικό πλαίσιο με ένα ή περισσότερα αθλήματα. Επιπλέον, τo πρόγραμμα Kids’ 360° Health αποτελεί έναν ολοκληρωμένο
• Την προσαρμογή και εξατομίκευση του πλάνου Προληπτικής Ιατρικής με βάση τη μοναδική βιολογία και τις συνθήκες ζωής του κάθε ατόμου. Δίκτυο δειγματοληψιών τεστ COVID-19 Το δίκτυο των δειγματοληψιών για τεστ COVID-19 λει τουργεί στα κέντρα του ομίλου και διευρύνεται συνεχώς. ΨΗΦΙΑΚΟΣ ΦΑ ΚΕΛΟΣ ΥΓΕ Ι ΑΣ Ο Όμιλος ΒΙΟΪΑΤΡΙΚΗ διαθέτει την πλατφόρμα «ΨΗΦΙΑ ΚΟΣ ΦΑΚΕΛΟΣ ΥΓΕΙΑΣ» με στόχο την παροχή ποιοτικών ηλεκτρονικών υπηρεσιών για όλους τους εξεταζομέ νους, αξιοποιώντας τα πιο σύγχρονα και εξελιγμένα πληροφοριακά συστήματα. Ειδικότερα οι πολίτες μπο ρούν: • να βλέπουν άμεσα, εύκολα και από οπουδήποτε και αν βρίσκονται, τα αποτελέσματα των εργαστηριακών και απεικονιστικών εξετάσεών τους, • να μπορούν να συγκρίνουν τα αποτελέσματα πα λαιότερων εξετάσεων με τα αποτελέσματα από τις πιο πρόσφατες επισκέψεις τους, • να παρακολουθούν τη διακύμανση των αποτελε σμάτων μιας συγκεκριμένης εξέτασης σε βάθος χρόνου, • να διατηρούν το ιατρικό τους αρχείο ηλεκτρονικά και να μη χρειάζεται να διατηρούν και χάρτινο αρχείο, • να έχουν τη δυνατότητα να αποστέλλουν τα αποτελέ σματά τους στον θεράποντα ιατρό τους. ΑΣΦΑΛΙΣΤΙΚ Α ΤΑΜΕ Ι Α Ο Όμιλος ΒΙΟΪΑΤΡΙΚΗ
παράγοντα μελλοντικής νόσου.
σύμβαση με τον ΕΟΠΥΥ και όλα τα δημόσια ασφαλιστικά ταμεία. Παράλληλα εξυ πηρετεί την ιδιωτική ασφάλεια συνεργαζόμενη με τις μεγαλύτερες ασφαλιστικές εταιρείες, εξυπηρετώντας ένα πλήθος ασφαλιστικών προγραμμάτων. Επίσης, προσφέρει πανελλαδική κάλυψη για τους ασφαλισμένους του Ενιαίου Δημοσιογραφικού Οργα νισμού Επικουρικής Ασφάλισης και Περίθαλψης (ΕΔΟ ΕΑΠ). ■
| 53 AΦΙΕΡΩΜΑ | ΔΙΑΓΝΩΣΤΙΚΑ ΚΕΝΤΡΑ
ετήσιο
αξιολογεί την καλή μεταβολική λειτουργία,
ξη αλλεργικής προδιάθεσης,
έλεγχο, που επιπρόσθετα
την ύπαρ
το επίπεδο θρέψης και εντερικής δυσαπορρόφησης του παιδικού οργανισμού. Υγεία Ακριβείας και Γονιδιωματική Ιατρική Το Κέντρο Προληπτικής Ιατρικής και Μακροβιότητας παρέχει υπηρεσίες που βασίζονται σε δύο κεντρικούς άξονες: • Τη διερεύνηση της γενετικής σύστασης και των γενετικών ιδιαιτεροτήτων του κάθε ανθρώπου, ως ουσι αστικού προδιαθεσικού
έχει
συνεχίζοντας, με στό χους και όραμα, τις διαρκείς επενδύσεις σε ιατρικό εξοπλισμό, προχώρησε στο σχεδιασμό του νέου Εργα στηρίου Βιοπαθολογίας, δίνοντας έμφαση στην ανάπτυ ξη αυτοματοποιημένων συστημάτων αιχμής, τα οποία βελτιώνουν την ποιότητα των εξετάσεων και μειώνουν το χρόνο διεκπεραίωσής τους. Το νέο Βιοπαθολογικό Εργαστήριο της Κλινικής Αμαρουσίου, θέτοντας ως ύψιστη προτεραιότητα τον ασθενή και την ασφάλειά του, παρέχει εργαστηριακές εξετάσεις που καλύπτουν όλο το φάσμα των υπηρε σιών υγείας που παρέχει ο Όμιλος Ιατρικού Αθηνών. Στοχεύοντας στην έγκαιρη παροχή


54 | Ο Ο ΜΙΛΟΣ ΙΑΤΡΙΚΟΥ ΑΘΗΝ Ω Ν
αξιόπιστων εργαστηριακών εξετάσεων, το Βιοπαθολογικό Ερ Ρομποτικό σύστημα προανάλυσης και αναλυτές τεχνολογίας αιχμής στο Βιοπαθολογικό Εργαστήριο! Γράφει η ΓΕΝΟΒΕΦΑ ΧΡΟΝΟΠΟΥΛΟΥ, ιατρός βιοπαθολόγος, διευθύντρια Εργαστηρίου Βιοπαθολογίας Ιατρικού Κέντρου Αθηνών.
,
γαστήριο εφαρμόζει Σύστημα Διαχείρισης κατά ISO
15189:2012 και διαπιστεύθηκε από το Εθνικό Σύστημα Διαπίστευσης (ΕΣΥΔ) με αριθμό πιστοποιητικού 1292. Το Εργαστήριο στελεχώνεται με ιατρικό, επιστημο νικό και διοικητικό προσωπικό, το οποίο διαθέτει υψη λού επιπέδου κατάρτιση και αυξημένο αίσθημα επιστη μονικής ευθύνης για την παροχή αξιόπιστων υπηρεσι ών ιατρικών εξετάσεων. Το σύνολο του προσωπικού του Εργαστηρίου ακολουθεί όλους τους κανόνες ηθι κής και δεοντολογίας που διέπουν τη λειτουργία του και υπόκειται σε συνεχή εκπαίδευση σε θέματα κα λής εργαστηριακής πρακτικής [GLP-Good Laboratory Practice] και γενικότερης θεωρητικής κατάρτισης με την παρακολούθηση εσωτερικών ενημερώσεων, ημε ρίδων, σεμιναρίων και συνεδρίων, διαδικτυακά ή διά ζώσης. Στο πλαίσιο αυτό παρέχονται συμβουλευτικές υπη ρεσίες προς τους κλινικούς ιατρούς όσον αφορά στη διαχείριση των δειγμάτων από τη λήψη έως την απο στολή τους στο Εργαστήριο, καθώς και όσον αφορά στη διερεύνηση συγκεκριμένων περιστατικών. Επισημαίνεται ότι λαμβάνεται μέριμνα για την ασφάλεια των δεδομένων που τηρούνται στο Εργα στήριο (έντυπης ή ηλεκτρονικής μορφής), ώστε να διασφαλίζεται η προστασία των ευαίσθητων προσω πικών δεδομένων των ασθενών, όπως καθορίζουν και
οι ισχύουσες νομοθετικές διατάξεις.
ΥΠΟΔΟΜΕΣ - ΥΠΗΡΕΣΙΕΣ
Το Βιοπαθολογικό Εργαστήριο της Κλινικής Αμαρου
σίου λειτουργεί σε 24ωρη βάση και καλύπτει τις ανά γκες τόσο των εσωτερικών όσο και των εξωτερικών ασθενών, σε όλους τους τομείς ενός σύγχρονου και πλήρους οργανωμένου Κέντρου Βιοπαθολογίας. Από τον Νοέμβριο του 2020 το Εργαστήριο λει

τουργεί σε νέο ειδικά διαμορφωμένο χώρο, σύμφωνα με διεθνή πρότυπα και προδιαγραφές, εφάμιλλο των καλύτερων Νοσοκομειακών Εργαστηρίων του εξωτε ρικού. Η άρτια τεχνολογική υποδομή του Βιοπαθολογικού Εργαστηρίου της Κλινικής Αμαρουσίου, σε συνδυασμό με τη στελέχωσή του με έμπειρο και άριστα καταρτι σμένο προσωπικό, σε όλα τα επίπεδα, την εφαρμογή πολλαπλών ελέγχων ποιότητας και την παρακολούθη ση σε κάθε βήμα όλης της πορείας των διαδικασιών λειτουργίας του, το κατατάσσουν στα πλέον σύγχρονα Εργαστήρια τόσο στην Ελλάδα όσο και το εξωτερικό.
Το Βιοπαθολογικό Εργαστήριο αποτελείται από τα παρακάτω τμήματα:
● Αιματολογικό Αιμόσταση.
● Ανοσοβιοχημικό.
● Ανοσολογικό.
● Μικροβιολογικό.
● Ουροχημικό.
● Μοριακής Βιολογίας. To Εργαστήριο έχει εξοπλιστεί με ανοσοβιοχημι κούς και αιματολογικούς αναλυτές τελευταίας τεχνο λογίας, υψηλής παραγωγικότητας και υψηλής αξιοπι στίας που διενεργούν τις εξετάσεις με αντιδραστήρια νέας γενιάς, τα οποία πληρούν όλες τις προδιαγραφές και πιστοποιήσεις. Για την ορθή διαχείριση των αντιδραστηρίων εγκα ταστάθηκε ειδικό λογισμικό διαχείρισης αποθεμάτων με σύστημα RFID και ηλεκτρονική 24ωρη καταγραφή θερμοκρασιών ψυγείων και περιβάλλοντος, τα οποία επιτρέπουν την απρόσκοπτη παρακολούθηση των αντι δραστηρίων, καθώς και των συνθηκών φύλαξής τους από την εισαγωγή τους στο εργαστήριο μέχρι και την τελική τους κατανάλωση, εξασφαλίζοντας πλήρη ιχνη λασιμότητα και ιδανικές συνθήκες φύλαξης. Η δε εγκατάσταση ρομποτικού συστήματος προ-α νάλυσης, σε συνδυασμό με την εγκατάσταση και λει τουργία πρωτοποριακού συστήματος μεταφοράς και παραλαβής δειγμάτων, εξασφαλίζει πλήρη ιχνηλασι μότητα και ταυτοποίηση των δειγμάτων και ελαχιστο ποίηση της πιθανότητας σφάλματος της συγκεκριμέ νης διαδικασίας.
| 55 AΦΙΕΡΩΜΑ | ΔΙΑΓΝΩΣΤΙΚΑ ΚΕΝΤΡΑ
του
Στον εξοπλισμό του Μικροβιολογικού Tμήματος
Εργαστηρίου εντάχθηκε πρόσφατα ο αναλυτής φασματομετρίας μάζας MALDI TOF /VITEK-MS Prime, o οποίος ταυτοποιεί απομονωθέντα μικρόβια από καλ λιέργειες σε βιολογικά δείγματα ασθενών σε μόλις δέκα λεπτά, έναντι των 24 ωρών της κλασικής ταυτο ποίησης, συντομεύοντας έτσι και τον συνολικό χρόνο ολοκλήρωσης της καλλιέργειας και του αντιβιογράμ ματος και προσφέροντας στους κλινικούς ιατρούς τα τεκμήρια για τη γρήγορη ορθολογική αντιμετώπιση
του ασθενούς. Επισημαίνεται
ότι το συγκεκριμένο
σε ορθικό επίχρισμα για την άμεση ανίχνευση φορέων πολυανθεκτικών μικροβίων, πολύτιμο εργαλείο για την έγκαιρη

ανθεκτικούς
Οργανισμού
56 |
απομόνωση των ασθενών σύμφωνα με τις οδηγίες της Επιτροπής Λοι μώξεων. Επίσης, υπάρχει η δυνατότητα ανίχνευσης
νοσοκομειακού περιβάλλοντος, καθώς και ασφαλών ιατρικών και νοσηλευτικών διαδικασιών και οργάνων που χρησιμοποιούνται σε επεμβατικές πράξεις, σύμ φωνα με τα προτεινόμενα και επιβεβλημένα όρια που υπαγορεύονται από διεθνείς και ελληνικούς οργανι σμούς και φορείς [CDC, ECDC, WHO, EΟΔΥ, ΕΕΕΛ]. Επίσης συμμετέχει στην επιδημιολογική διερεύνηση λοιμώξεων και την καθημερνή παρακολούθηση των αποικισμών/λοιμώξεων από σε ρινοφαρυγγικό επίχρισμα σε μόλις 20 λεπτά για τη διαχείριση των επειγόντων περιστατικών. Το Μικροβιολογικό Τμήμα συμμετέχει σε όλες τις λειτουργίες της Επιτροπής Λοιμώξεων που αφορούν στους ελέγχους για τη διατήρηση ενός ασφαλούς
μικροοργα νισμούς των ασθενών, ακολουθώντας τις οδηγίες και τα πρωτόκολλα του Εθνικού
Δημόσιας Υγείας. Επισημαίνεται ότι όλα τα συστήματα ανάλυσης, αλλά και τα αντιδραστήρια τα οποία χρησιμοποιεί το Βιοπαθολογικό Εργαστήριο είναι κατάλληλα για δια γνωστική χρήση (CE/IVD). Το εργαστήριο διαθέτει πληροφοριακό σύστημα, το οποίο διασφαλίζει την ιχνηλασιμότητα και την αρ χειοθέτηση των αποτελεσμάτων βάσει της ισχύουσας νομοθεσίας.
μο ντέλο αποτελεί την πρώτη εγκατάσταση στην Ελλάδα. Πέραν αυτού, ο βασικός εργαστηριακός εξοπλι σμός του τμήματος συμπληρώνεται με: ● Mοριακό αναλυτή συνδρομικής διάγνωσης πολ λαπλών παθογόνων κατά σύστημα, μεθοδολογίας πολυπλεκτικής PCR για τη διάγνωση λοιμώξεων ανω τέρου και κατωτέρου αναπνευστικού, αρθρώσεων, μη νιγγίτιδας/εγκεφαλίτιδας, γαστρεντερίτιδων, καθώς και ταυτοποίησης παθογόνων από αιμοκαλλιέργειες με παράλληλη ανίχνευση γονιδίων μικροβιακής αντοχής. ● Μοριακούς αναλυτές [RT-PCR] για την ανίχνευση των ιών HPV, γρίπης Α/Β, RSV, του Clostridium difficile, του μυκοβακτηριδίου φυματίωσης σε κλινικά δείγμα τα και γονιδίων αντοχής
του ιού SARS-CoV-2 σε 70 λεπτά για την πλειονότητα των δειγμάτων και ειδικός αναλυτής για τη μοριακή ανί χνευση του SARS-CoV-2
Οι τιμές αναφοράς οι οποίες έχουν υιοθετηθεί από το Εργαστήριο καλύπτουν όλο το ηλικιακό φάσμα των ασθενών της κλινικής (παιδιά, ενήλικες) και ακολου θούν τις συστάσεις των κατασκευαστών του εξοπλι σμού και τις συστάσεις της επιστημονικής βιβλιογρα φίας. Η αξιοπιστία των εργαστηριακών εξετάσεων δι ασφαλίζεται σε συνεχή βάση μέσω του καθημερινού εσωτερικού ελέγχου ποιότητας που διενεργείται σύμ φωνα με τα διεθνή πρότυπα και μέσω της συμμετοχής του Εργαστηρίου σε διεργαστηριακά
● UK NEQAS (United Kingdom).
● RANDOX International Quality Assurance Schemes (RIQAS - United Kingdom).

● ΕΛΛΗΝΙΚΗ ΕΤΑΙΡΕΙΑ ΕΡΓΑΣΤΗΡΙΑΚΗΣ ΑΙΜΑΤΟΛΟ ΓΙΑΣ - ΑΙΜΟΔΟΣΙΑΣ (Ελλάδα).
● INSTAND (Germany).
● RFB (Germany). Το Βιοπαθολογικό Εργαστήριο βρίσκεται σε συνε χή συνεργασία με διαπιστευμένα κέντρα αναφοράς και συνεργαζόμενα εργαστήρια (Κέντρο Αναφοράς Μηνιγγίτιδας-ΕΣΔΥ, Κέντρο Αναφοράς ΦυματίωσηςΝοσοκομείο Νοσημάτων Θώρακος «Σωτηρία», Κέντρο Αναφοράς Γρίπης- Ελληνικό Ινστιτούτο Παστέρ κ.ά.) για επιβεβαίωση και περαιτέρω έλεγχο των δειγμάτων, όπου αυτό απαιτείται. ■
90 περιλήψεις σε διεθνή και εθνικά συνέδρια. Επίσης, έχει περισσότερες από 100 συμμετοχές σε τοπικούς και διεθνείς κύκλους μαθημάτων και σεμινάρια.
| 57 AΦΙΕΡΩΜΑ | ΔΙΑΓΝΩΣΤΙΚΑ ΚΕΝΤΡΑ
χου ποιότητας. Τα διεργαστηριακά
συμμετέχει το Εργαστήριο διοργανώνονται από αξιό πιστους διεθνείς και ελληνικούς φορείς όπως: ● EQAS-BIORAD (USA). ΓΕΝΟΒ ΕΦΑ ΧΡΟΝΟΠΟΥΛΟΥ Η Γενοβέφα Χρονοπούλου είναι ιατρός βιοπαθολόγος, διευθύντρια του Εργαστηρίου Βιοπαθολογίας του Ιατρικού Κέντρου Αθηνών. Είναι μέλος της Ελληνικής Μικροβιολογικής Εταιρείας (2003 - έως σήμερα), μέ λος της Εταιρείας Κλινικής Μικροβιολογίας & Εργαστηριακής Διάγνωσης
Ευρωπαϊκής Εταιρείας Κλινικής Μικροβιολογίας και Λοιμωδών Νοσημάτων
σχήματα ελέγ
σχήματα στα οποία
(2003 - έως σήμερα), μέλος της
(2003 - έως σήμερα), μέλος της Εκτελεστικής Ελληνικής Επιτροπής της Εταιρείας Κλινικής Μικροβιολογίας & Εργαστηριακής Διάγνωσης (2014 - 2017). Έχει κάνει περισσότερες από 16 δημοσιεύσεις σε επιστημονικά περιοδικά, καθώς και περισ σότερες από
BY Η κ. Νέλλυ Μιχαλάκη, PhD, General Manager HealthSpot.
θεραπευτήρια Υγεία, Metropolitan Hospital, Μητέρα, Metropolitan General, Λητώ, Creta InterClinic και το Απολλώνειο Νοσοκομείο στην Κύπρο. Παρέχουν υπη ρεσίες διάγνωσης και εξατομικευμένης αντιμετώπι σης κάθε θέματος Νέα διαγνωστικά κέντρα HealthSpot με την αξιοπιστία του HHG

58 | ΤΑ ΔΙΑΓΝΩΣΤΙΚ Α Κ Ε ΝΤΡΑ HealthSpot προσφέρουν μία ολοκληρωμένη και πρωτοποριακή επιλογή για την υγεία και την ιατρική περίθαλψη στην Ελλάδα, με επίκεντρο τον άνθρωπο, συμβαδίζοντας με τις ανάγκες της σύγ χρονης ψηφιακής εποχής. Δημιουργήθηκαν από το Hellenic Healthcare Group (HHG), τον μεγαλύτερο ιδιωτικό όμιλο
πα ροχής υπηρεσιών υγείας στη χώρα που διαθέτει τα υγείας, με έμφαση στην αξία της πρόληψης. «Τα HealthSpot βρίσκονται σε ανοιχτή επικοινωνία με θεραπευτήρια του ομίλου, είναι στελεχωμένα από
εξειδικευμένους και διακεκριμένους ιατρούς, έμπειρο νοσηλευτικό και παραϊατρικό προσωπικό και πλήρως εξοπλισμένα με τεχνολογία αιχμής», μας δηλώνει η Νέλλυ Μιχαλάκη, PhD, General Manager διαγνωστικών κέντρων HealthSpot by ΗΗG, σε συνέντευξη που μας παραχώρησε. ΤΜ Η ΜΑΤΑ ΚΑΙ ΥΠΗΡΕΣ Ι ΕΣ Τα HealthSpot διαθέτουν ευρύ φάσμα διαγνωστικών τμημάτων όπως:

• Βιoπαθολογικό.
• Μοριακή Βιολογία.
• COVID-19 Τεστ (PCR, Υπερταχεία Μοριακή Ανίχνευ ση, Rapid Test και ανίχνευση εξουδετερωτικών αντισω μάτων και ειδικών αντισωμάτων νόσησης).

• Ακτινολογικό.
• Ψηφιακή Μαστογραφία.
• Μέτρηση Οστικής Πυκνότητας.
εκτίμησης στο χώρο των Κέντρων - πέραν των διαγνω στικών εξετάσεων.
• Παθολογικό.
• Διαβητολογικό.
• Ενδοκρινολογικό.
• Καρδιολογικό.
• Πνευμονολογικό.
• Ουρολογικό.
• Νευρολογικό.
• Γαστρεντερολογικό.
• Γυναικολογικό.
• Δερματολογικό.
• Οφθαλμολογικό.
• Ορθοπαιδικό.
• Ογκολογικό.
• Χειρουργικό.
• Νευροχειρουργικό.
• Θωρακοχειρουργικό.
HealthSpot Γλυφάδας.
• Τμήμα Υπερήχων.
• Δοκιμασία Κοπώσεως.
• Holter ρυθμού/πίεσης εβδομαδιαίας καταγραφής.
• Triplex καρδιάς-αγγείων.
• Stress Echo.
• Υπηρεσίες κατ’ οίκον. Παράλληλα το ευρύ, διαφόρων ειδικοτήτων δίκτυο
ιατρών των HealthSpot παρέχει τη δυνατότητα ιατρικής
• Υπηρεσίες Αισθητικής Ιατρικής. Εξειδικευμένες Υπηρεσίες: • Έλεγχος Βηματοδότη. • Τμήμα Παχυσαρκίας. • Καρδιοογκολογικό Τμήμα. • Ιατρείο Υπέρτασης. • Καρδιομεταβολικό Τμήμα. • Τμήμα Μαστού.

| 59 AΦΙΕΡΩΜΑ | ΔΙΑΓΝΩΣΤΙΚΑ ΚΕΝΤΡΑ
HealthSpot Κηφισιάς. Εσωτερικός χώρος HealthSpot Γλυφάδας.
• Τμήμα Eμβρυομητρικής Ιατρικής. • Τμήμα Check Up. ΔΗΜ ΟΣΙΟΙ ΦΟΡΕ Ι Σ ΚΑΙ ΑΣΦΑΛΙΣΤΙΚ Ε Σ ΕΤΑΙΡΕ Ι ΕΣ Τα HealthSpot είναι συμβεβλημένα με τον Εθνικό Οργα νισμό Παροχής Υπηρεσιών Υγείας (ΕΟΠΥΥ), καθώς και με τον Ενιαίο Δημοσιογραφικό Οργανισμό Επικουρικής Ασφάλισης Περίθαλψης (ΕΔΟΕΑΠ). Οι ιατροί των Healthspot έχουν τη δυνατότητα συ νταγογράφησης μετά από κάθε ιατρική εξέταση στο χώρο των HealthSpot ή απομακρυσμένα.

τις ανάγκες τους, προσφέροντάς τους τις καλύτερες λύσεις. Γι’ αυτό, στο HealthSpot υπάρχει εξειδικευμένο τμήμα ασφαλιστικών εταιρειών στο οποίο ηγείται ο κ. Βελισσάριος Παππάς, στέλεχος που προέρχεται από τον ασφαλιστικό χώρο με πολυετή εμπειρία». — Κυρία Μιχαλάκη, τι είναι η ιδέα του One Stop Clinic που πρεσβεύουν τα HealthSpot; Οne Stop Clinic σημαίνει διάγνωση με επιτόπου κλινική εξέταση από εξειδικευμένο ιατρό, σε ένα ραντεβού.
Αποφεύγονται οι πολλαπλές επανεξετάσεις, η θεραπεία ξεκινά πιο γρήγορα και μειώνεται η ταλαιπωρία για τον εξεταζόμενο. Για παράδειγμα, στο Τμήμα Μαστού πραγματοπούνται σε μία μόνο επίσκεψη, πλήρης απει κονιστικός έλεγχος και κλινική εκτίμηση από χειρουργό μαστού. — Τι ρόλο παίζει ο τεχνολογικός εξοπλισμός στα HealthSpot; Σε μια εποχή όπου η τεχνολογία διευκολύνει και εξελίσ σει την ιατρική επιστήμη, τα HealthSpot επενδύουν στον εξοπλισμό τελευταίας γενιάς, ώστε να εξασφαλίζουν το βέλτιστο διαγνωστικό αποτέλεσμα. Ο υπερσύγχρονος ψηφιακός μαστογράφος Mammomat Fusion των κέντρων προσφέρει υψηλή ευκρίνεια σε εξαιρετικά χαμηλή δόση ακτινοβολίας. Διαθέτει ισχυρό ανιχνευτή με πρωτοποριακό λογισμι κό, παρέχοντας καλύτερη ποιότητα εικόνας στη σωστή δόση και αυξάνοντας τη διαγνωστική ακρίβεια. Tο Τμήμα Ακτινολογίας είναι εξοπλισμένο με το ψη φιακό σύστημα τελευταίας τεχνολογίας Υsio X. Pree, που εξασφαλίζει τη μικρότερη δυνατή έκθεση στην ακτινοβολία Χ και εξασφαλίζει το βέλτιστο αποτέλε σμα απεικόνισης. Τα μηχανήματα μέτρησης οστικής πυκνότητας Lunar
60 |
εταιρείες και τους ασφαλιστικούς συμβούλους: «Στόχος μας είναι να είμαστε πάντα κοντά τους και να αφουγκραζόμαστε
Η κυρία Νέλλυ Μιχαλάκη εξηγεί πως δίνεται ιδιαίτερη βαρύτητα στη συνεργασία με τις ασφαλιστικές
Υπερσύγχρονο
ακτινολογικό σύστημα.
Prodigy Advance και Horizon για τη διάγνωση της οστεο πόρωσης χρησιμοποιούν τη μέθοδο DEXA. Ο μειωμένος χρόνος και η χαμηλή δόση ακτινοβολίας εξασφαλίζουν μια άνετη εμπειρία για τους εξεταζομένους. — Πώς εφαρμόζεται η ψηφιακή τεχνολογία στα Κέντρα; Αξιοποιώντας τις ψηφιακές εφαρμογές του Ομίλου HHG, τα HealthSpot στοχεύουν στην καλύτερη και πιο άμεση εξυπηρέτηση του κόσμου
Μέσα από ένα digital, φιλικό για τον χρήστη, πε ριβάλλον μπορεί να γίνει ενημέρωση σε πραγματικό χρόνο για αποτελέσματα εξετάσεων, διαχείριση και απο στολή ιατρικών εξετάσεων και δεδομένων σε ιατρό της επιλογής του ασθενούς, από σταθερή ή κινητή συσκευή που έχει πρόσβαση στο Ίντερνετ, πάντα με σεβασμό στα ευαίσθητα προσωπικά του δεδομένα.
— Τι είναι η «Homecare - Kατ’ οίκον Υπηρεσίες Υγείας»; O Όμιλος HHG με τα διαγνωστικά του κέντρα HealthSpot, έχοντας ως προτεραιότητα την άνεση και ιδιωτικότητα του πελάτη, δημιούργησε την υπηρεσία «HomeCare - Kατ’ οίκον Υπηρεσίες Υγείας», η οποία προσφέρει εξατομικευμένες ιατρικές και νοσηλευτικές υπηρεσίες σε όποιον επιθυμεί ή χρειάζεται κατ’ οίκον εξυπηρέτηση στο οικείο περιβάλλον του. Η Homecare δίνει τη δυνατότητα επίσκεψης ιατρού και διενέργειας εξετάσεων στο χώρο του ασθενούς. Μερικές από τις υπηρεσίες που παρέχονται είναι: check up, καρδιογράφημα, triplex καρδιάς, ακτινογραφία, υπερηχογράφημα, triplex αγγείων, Holter ρυθμού και πίεσης, αιμοληψία/συλλογή ούρων, διενέργεια Covid-19 test, λήψη ζωτικών σημείων/κλινική εικόνα, υποκλυσμός κ.ά. Οι υπηρεσίες της Homecare απευθύνονται σε όλους, μεταξύ άλλων και σε ασθενείς που έχουν ανάγκη για τη συνέχιση της θεραπείας τους στο χώρο τους, για υποστήριξη και παρακολούθηση μετά την έξοδό τους από το νοσοκομείο, ηλικιωμένα άτομα, ογκολογικούς ασθενείς, ασθενείς με χρόνιες παθήσεις ή αναπηρίες όπως επίσης και ασθενείς που επιθυμούν να ολοκλη ρώσουν με άνεση τον προεγχειρητικό τους έλεγχο. Τηλ. επικοινωνίας: 1051.

μαζεύει πόντους, ανεβαίνει βαθμίδα και «ανταμείβεται» για
επιλογή του. Επίσης, με τον προσωπικό φάκελο υγείας my-Ygeia μια καινοτόμο εφαρμογή, δίνεται η δυνατότητα άμεσης και εύκολης πρόσβαση στο ιατρικό αρχείο κάθε ασθε νούς/εξεταζομένου που έχει επισκεφθεί τα θεραπευ τήρια του Ομίλου HHG ή/και τα HealthSpot.
— Πού βρίσκονται τα ΗealthSpot; Τα HealthSpot βρίσκονται σε Κηφισιά, Περιστέρι, Γλυ φάδα, Πειραιά (εντός ΟΛΠ) και στη Σαντορίνη. Ωστόσο ο στόχος του HHG είναι η επέκταση της λειτουργίας τους εντός και εκτός Αττικής, δημιουργώντας ένα ολο κληρωμένο δίκτυο περίθαλψης στη χώρα με υψηλής ποιότητας υπηρεσίες υγείας, προσιτές σε όλους στην πρωτοβάθμια και δευτεροβάθμια περίθαλψη. Για πληροφορίες και επικοινωνία με τα HealthSpot Κηφισιά: Λεβίδου 16 Περιστέρι: Παναγή Τσαλδάρη & Σαρανταπόρου 1 Γλυφάδα: Λεωφ. Βουλιαγμένης & Γρηγ. Λαμπράκη 62 Πειραιάς: Ακτή Μιαούλη Σαντορίνη: Μεσαριά Tηλ. Κέντρο: 212 8086000, Website: healthspot.hhg.gr ■
| 61 AΦΙΕΡΩΜΑ | ΔΙΑΓΝΩΣΤΙΚΑ ΚΕΝΤΡΑ
ψηφιακή
με ποικιλία προνομίων. Οι χρήστες μπορούν να επω φεληθούν από ειδικές τιμές με ξεχωριστές παροχές και μοναδικές προσφορές στα Θεραπευτήρια, στα Δι αγνωστικά Κέντρα και το εργαστήριο ALab του
Με
συναλλαγή, ο κάτοχος της
που θα τα εμπιστευτεί για την υγεία του. Μέσα από την εφαρμογή Health e Bonus Card, μια
κάρτα υγείας, παρέχεται ένα premium δίκτυο
HHG.
κάθε
κάρτας
την
ΗealthSpot Περιστερίου.


Όμιλος Euromedica
Ο Ο ΜΙΛΟΣ EUROMEDICA διαχειρίζεται ένα από τα με γαλύτερα δίκτυα πρωτοβάθμιας και δευτεροβάθμιας περίθαλψης στην ελληνική επικράτεια. Παρέχει τις υπη ρεσίες του μέσω ενός εκτεταμένου δικτύου, το οποίο απαρτίζεται από διαγνωστικά κέντρα, ιδιωτικές κλινικές, μονάδα υποβοηθούμενης αναπαραγωγής και κέντρα αποκατάστασης στις μεγαλύτερες ελληνικές πόλεις. Ο Όμιλος Εuromedica κυριαρχεί στη Θεσσαλονί κη με δύο Γενικές Κλινικές, μία Μαιευτική, μία Μονάδα Υποβοηθούμενης Αναπαραγωγής, ένα Κέντρο Απο κατάστασης και έξι Διαγνωστικά Κέντρα. Η παρουσία στην ευρύτερη Βόρεια Ελλάδα είναι εξίσου ισχυρή με μια Γενική Κλινική και Διαγνωστικά Κέντρα σε Κοζάνη, Αλεξανδρούπολη και Κατερίνη. Στην Κεντρική Ελλάδα

Ρόδο. Στην Κρήτη λειτουργεί επιπλέον και δύο
Κέντρα. Όπως τονίζουν τα στελέχη της, η αποστολή της Euromedica είναι να προσφέρει καινοτόμες και υψη λού επιπέδου υπηρεσίες υγείας με γνώμονα την ασφά λεια του ασθενους και σύμφωνα με τις διεθνείς προδι αγραφές. Για το σκοπό αυτόν: • Συνεργάζεται με κορυφαίους ιατρούς στις περιο χές όπου δραστηριοποιείται. • Επανδρώνει τις μονάδες της με άρτια καταρτισμέ
νο και έμπειρο νοσηλευτικό και διοικητικό προσωπικό. • Εφαρμόζει εντατικό πρόγραμμα εκπαίδευσης του προσωπικού της, καθώς και επιστημονικές ενημερώ σεις προς τους συνεργάτες ιατρούς. • Ανανεώνει διαρκώς τον ιατροτεχνολογικό μας εξοπλισμό, επενδύοντας σε μηχανήματα τεχνολογίας αιχμής, μέσω του εκτεταμένου επενδυτικού προγράμ ματος που εφαρμόζει. Ειδικότερα στον τομέα της Πρωτοβάθμιας Φροντί δας Υγείας η Εuromedica αποτελεί έναν από τους με γαλύτερους παρόχους με ένα δίκτυο 23 διαγνωστικών κέντρων σε όλη την Ελλάδα. Τα διαγνωστικά κέντρα του ομίλου εξυπηρετούν χιλιάδες εξεταζομένους με τις πλέον σύγχρονες μεθόδους διάγνωσης και με τε χνολογικές υποδομές που εξασφαλίζουν έγκυρα και αξιόπιστα αποτελέσματα, διαθέτοντας έμπειρο και κα ταξιωμένο ιατρικό και νοσηλευτικό προσωπικό. Παράλληλα, όλα τα διαγνωστικά εργαστήρια εί ναι συνδεδεμένα με online σύστημα, έτσι ώστε ο κάθε ασθενής να έχει πρόσβαση στο φάκελό του σε όλες τις μονάδες του δικτύου. Σε κάθε ένα διαγνωστικό κέντρο του ομίλου εφαρμόζεται Σύστημα Ποιότητας, πιστοποι ημένο σύμφωνα με το πρότυπο ISO 9001:2015. Το τελευταίο χρονικό διάστημα υλοποιείται ένα ευρύ πλάνο ανανέωσης του ιατρικού εξοπλισμού των διαγνωστικών ιατρείων, σε συνεργασία με κορυφαίες εταιρείες στο χώρο της ιατρικής τεχνολογίας. Σήμερα, τα διαγνωστικά κέντρα της Euromedica καλύπτουν ένα
| 63 AΦΙΕΡΩΜΑ | ΔΙΑΓΝΩΣΤΙΚΑ ΚΕΝΤΡΑ
έχει παρουσία στη Λάρισα με δύο Διαγνωστικά Κέ ντρα. Στην Αττική λειτουργεί και εξελίσσει ένα
δέκα Διαγνωστικών Κέντρων και μίας Γενικής Κλινικής. Επίσης διαθέτει δύο υπερσύγχρονες κλινικές στην Κρή τη και τη
δίκτυο
Διαγνωστικά
ευρύ φάσμα υπηρεσιών, όπως απεικονιστικές, εργα στηριακές, καθώς και υπηρεσίες ιατρείων. Η Euromedica είναι συμβεβλημένη με τον ΕΟΠΥΥ και όλους τους δημόσιους ασφαλιστικούς φορείς, καθώς και με ιδιωτικές ασφαλιστικές εταιρείες. Πα ράλληλα διενεργεί προληπτικές εξετάσεις σε ειδικές προνομιακές τιμές, χωρίς να απαιτείται παραπεμπτικό ιατρού. Ειδικότερα οι υπηρεσίες των Κέντρων της που λει τουργούν στην Περιφέρεια της Αττικής έχουν ως εξής: • Στη Euromedica Αγίας Παρασκευής διενεργούνται όλες οι εργαστηριακές εξετάσεις, ενώ λειτουργεί πλή ρες απεικονιστικό τμήμα (αξονική & μαγνητική τομο γραφία, ακτινολογικό), καθώς και Kαρδιολογικό και Nευροφυσιολογικό Tμήμα. Στο κέντρο διενεργούνται επίσης και όλα τα τεστ έναντι του κορονοϊού Covid-19. • Στη Euromedica Γαλατσίου λειτουργεί πλήρες Aπεικονιστικό Tμήμα, ενώ διενεργούνται όλες οι ερ γαστηριακές εξετάσεις, καθώς και τα τεστ έναντι του κορoνοϊού Covid-19. Παράλληλα λειτουργούν Kαρδιο λογικό, Γαστρεντερολογικό, Οφθαλμολογικό και Ενδο κρινολογικό Τμήμα. • Η Euromedica Εγκέφαλος Χαλανδρίου είναι η ναυ αρχίδα των διαγνωστικών κέντρων του ομίλου, παρέ χοντας όλο το εύρος των διαγνωστικών μεθόδων απει
κόνισης και όχι μόνο, με συνεργασίες υψηλού επιστη μονικού επιπέδου. Πρόσφατα ανακαινίσθηκε πλήρως κτιριακά και σε ιατρικά μηχανήματα και προχώρησε στην εγκατάσταση ολοκαίνουριου ιατροτεχνολογικού εξοπλισμού τελευταίας τεχνολογίας σε συνεργασία με την General Electric Healthcare. • Η Euromedica Περιστερίου έχει πρόσφατα πλή ρως ανακαινισθεί, τόσο κτιριακά όσο και σε ιατρικά μηχανήματα. Έχουν εγκατασταθεί μαγνητικός τομογρά φος 1,5Τ της GE Healthcare με δυνατότητα πραγματο ποίησης μαγνητικής αγγειογραφίας, πολυπαραμετρι κής προστάτη, μαστογραφίας και πυελογραφίας, κα θώς και αξονικός τομογράφος 128 τομών της Siemens για την πραγματοποίηση αξονικής αγγειογραφίας και στεφανιογραφίας. Διενεργούνται επίσης οι κυριότερες απεικονιστικές εξετάσεις όπως ψηφιακή μαστογραφία, υπέρηχοι οργάνων σώματος, συμπεριλαμβανομένων καρδιάς και μαστού, ψηφιακές ακτινογραφίες, ηλε κτρομυογραφήματα, μέτρηση οστικής πυκνότητας και πανοραμικές οδόντων, ενώ λειτουργεί πλήρες Καρδιο λογικό Τμήμα με δυνατότητα ηλεκτροκαρδιογραφήμα τος, δοκιμασίας κόπωσης, triplex καρδιάς, καθώς και τοποθέτησης holter ρυθμού και πίεσης. Διενεργούνται ακόμη όλες οι εξετάσεις βιοπαθολογίας, check up και μοριακής βιολογίας, συμπεριλαμβανομένων και των

64 |
τεστ ανίχνευσης κορονοϊού. • Στο διαγνωστικό κέντρο Ιπποκράτης Νίκαιας λειτουργεί πλήρες Απεικονιστικό Τμήμα διαθέτοντας ανοιχτού τύπου μαγνήτη που εξασφαλίζει μεγαλύτερη άνεση στον εξεταζόμενο, απαλείφοντας το άγχος της κλειστοφοβίας. Παράλληλα, λειτουργούν Νευρολογι κό και Γαστρεντερολογικό Ιατρείο, ενώ διαθέτει ειδικό εξοπλισμό για τη διενέργεια διαγνωστικών εξετάσεων σε παιδιά. • Στο διαγνωστικό κέντρο Ιπποκράτης Κερατσινίου συνδυάζεται η τεχνολογική αναβάθμιση με την υψηλή εξειδίκευση του προσωπικού, ενώ τα συστήματα ποιο τικού ελέγχου που εφαρμόζονται
αξονικές και μαγνητικές τομογραφίες, καθώς επίσης και οι κυριότερες απεικονιστικές εξετάσεις όπως ψη φιακή μαστογραφία, υπέρηχοι οργάνων σώματος, συ μπεριλαμβανομένων καρδιάς και μαστού, ψηφιακές ακτινογραφίες, ηλεκτρομυογραφήματα, μέτρηση οστι κής πυκνότητας και πανοραμικές οδόντων. Στο κέντρο λειτουργεί επίσης και Τμήμα Πυρηνικής Ιατρικής (γ-κά μερα), καθώς και πλήρες Καρδιολογικό με δυνατότη τα ηλεκτροκαρδιογραφήματος, δοκιμασίας κόπωσης, triplex καρδιάς καθώς και τοποθέτησης holter ρυθμού και πίεσης. Τέλος, στη μονάδα διενεργούνται ακόμη όλες οι εξετάσεις βιοπαθολογίας, check up, και μορι ακής βιολογίας,
τομογράφο. Παράλληλα πραγματοποιούνται και όλες οι εργαστη ριακές εξετάσεις συμπεριλαμβανομένων των τεστ έναντι της Covid-19. Επιπλέον, λειτουργεί και Καρδι ολογικό Τμήμα με δυνατότητα διενέργειας τεστ κο πώσεως και triplex, καθώς και τοποθέτησης holter ρυθμού και πίεσης. • Στον Ιπποκράτη Παλαιού Φαλήρου διενεργούνται
357-359, 152 31, ΧΑΛΑΝΔΡΙ ΤΗΛ.: 210 3686800 E-mail: b2b@euromedica.gr ■

| 65 AΦΙΕΡΩΜΑ | ΔΙΑΓΝΩΣΤΙΚΑ ΚΕΝΤΡΑ
αποτελούν εγγύηση της ποιότητας των διαγνωστικών εξετάσεων. • Στη Euromedica Κηφισιάς παρέχεται όλο το εύ ρος των απεικονιστικών εξετάσεων με μηχανήματα τεχνολογίας αιχμής και είναι το μόνο στην περιοχή που διαθέτει ανοικτού τύπου μαγνητικό
και των
ανίχνευσης
Για περισσότερες πληροφορίες: ΚΕΝΤΡΙΚΑ ΓΡΑΦΕΙΑ ΔΙΟΙΚΗΣΗΣ ΜΕΣΟΓΕΙΩΝ
ΤΜΗΜΑ ΑΣΦΑΛΙΣΤΙΚΩΝ ΕΤΑΙΡΕΙΩΝ ΚΑΙ ΕΤΑΙΡΙΚΩΝ ΠΡΟΓΡΑΜΜΑΤΩΝ
συμπεριλαμβανομένων
τεστ
κορονοϊού.
357-359, 152 31, ΧΑΛΑΝΔΡΙ ΤΗΛ.: 210 3686600 FAX: 210 3686622 E-mail: hqathens@euromedica.gr
ΜΕΣΟΓΕΙΩΝ


Η ιατρική του Διαδικτύου και η αξία του προσυμπτωματικού ελέγχου! Η Κινητή Μονάδα Υγείας του «Ερρίκος Ντυνάν».
στο Διαδίκτυο πληρο φορίες για ιατρικά προβλήματα και διάφορα θέματα που άπτονται της ιατρικής επιστήμης. Οι αριθμοί που δίνουν όλες οι έρευνες είναι ξεκάθαροι: Το μεγαλύτε ρο ποσοστό των κατοίκων των ευρωπαϊκών χωρών σερφάρει πλέον στο Ίντερνετ. Για την Ελλάδα το ποσο στό αυτό αγγίζει το 65% του πληθυσμού και βρίσκεται σε διαρκή ανοδική πορεία. Οι παραπάνω αριθμοί είναι ιδιαίτερα αποκαλυπτι κοί και φανερώνουν μια νέα πραγματικότητα στη σχέ ση ιατρού - ασθενούς. Πολλά άτομα συμβουλεύονται το Ίντερνετ, με βάση τα συμπτώματά τους, χωρίς να πάνε στον γιατρό. Αυτό μπορεί να τους οδηγήσει σε λανθασμένα συμπεράσματα. Η αναζήτηση πληροφο ριών υγείας είναι πλέον πραγματικότητα και γι’ αυτόν το λόγο οι ασθενείς θα πρέπει να είναι επίσης ενήμε ροι για τους κινδύνους που ενέχει η εξεύρεση πληρο φοριών από ιστοσελίδες που δεν χαρακτηρίζονται για την εγκυρότητα, αξιοπιστία και επικαιροποίηση των πληροφοριών τους. Η διαδικτυακή πληροφορία με κριτικό στοχασμό μπορεί να βοηθήσει τους ασθενείς: · να αυξήσουν το επίπεδο γνώσεών τους σε θέματα υγείας και να ενδυναμώσουν τις δεξιότητές τους στην προάσπιση και διαχείριση της υγείας τους, · να αυξήσει την ικανότητά τους να αναζητούν τις υπηρεσίες υγείας που είναι πιο κατάλληλες για το πρό βλημα που τους απασχολεί. Αν ο ασθενής γνωρίζει ήδη κάποια πράγματα, η ιατρική του συμβουλή μπορεί να γίνει πολύ πιο εύ κολα κατανοητή. Όσο υψηλότερο είναι το επίπεδο πληροφόρησης και γνώσης που έχει ο ασθενής για την ασθένειά του τόσο καλύτερη είναι η αποδοχή της θεραπείας. Η έγκυρη πληροφόρηση από το Διαδίκτυο έχει σαν αποτέλεσμα ο ασθενής να συμμετέχει ενερ γά, να ζητάει περισσότερες πληροφορίες και να θέτει περισσότερες ερωτήσεις στη διάρκεια της ιατρικής εξέτασης. Ωστόσο, η χρήση της διαδικτυακής πληροφόρησης από τους ασθενείς ενέχει κινδύνους που μπορεί να οδηγήσουν σε λανθασμένες επιλογές υποτιμώντας ή υπερεκτιμώντας συμπτώματα και σημεία. Οι ασθενείς μπορεί να εμπιστεύονται ιστότοπους με πληροφορίες κακής ποιότητας ή ακόμα και να ερμηνεύουν λάθος τα δεδομένα. Επιπλέον, το Διαδίκτυο μπορεί να είναι επι βλαβές δημιουργώντας προσδοκίες στους ασθενείς, που όταν αντιμετωπίζουν τη γνώση ενός πραγματικού σταδίου ασθένειας-θεραπείας να απογοητεύονται. Ως


| 67 AΦΙΕΡΩΜΑ | ΔΙΑΓΝΩΣΤΙΚΑ ΚΕΝΤΡΑ ΠΟΛΛΟ Ι ΧΡ Η ΣΤΕΣ ΑΝΑΖΗΤΟΥ
λειτουργεί επικουρικά και δεν αντικαθιστά σε καμία περίπτωση τη γνώση και εμπειρία ενός γιατρού. Γράφει η ΒΑΡΒΑ ΡΑ ΚΑΛΟΓΕΡ Η, παθολόγος, διευθύντρια Τμήματος Επειγόντων Περιστατικών - Τμήματος Check Up, «Ερρίκος Ντυνάν».
Ν
εκ τούτου θα πρέπει να γίνει σαφές ότι αυτού του είδους η πληροφόρηση
UP Η σύγχρονη άποψη για την υγεία εστιάζει όλο και περισσότερο το ενδιαφέρον στον τομέα της πρόληψης και της πρώιμης διάγνωσης. Ο προληπτικός έλεγχος (check up) αποτελεί τον ακρογωνιαίο λίθο της διαφύ λαξης της υγείας. Επικεντρώνεται στην προσυμπτωματική διάγνωση ενηλίκων, ώστε να προσδιοριστούν ορισμένα νοσή ματα και παθολογικές καταστάσεις, που κατά κανόνα δεν προκαλούν συμπτώματα. Η πρόληψη έχει ιδιαί τερη σημασία σήμερα για την υγεία, την ευεξία και τη μακροζωία. Ο περιοδικός προληπτικός έλεγχος
(check up) στοχεύει στο να διαγνωσθούν έγκαιρα και να αντιμετωπισθούν νοσήματα πριν τη δημιουργία μη αναστρέψιμων επιπλοκών. Επιπλέον στοχεύει στο να δοθούν εξατομικευμένες οδηγίες-συμβουλές για να διαφυλαχτεί η καλή υγεία του εκάστοτε ασθενούς. Πρόκειται για μια στοιχειώδη υποχρέωση-επιλογή του ατόμου απέναντι στον εαυτό του. Το πρόγραμμα του περιοδικού προληπτικού ελέγ χου πρέπει να εξατομικεύεται από τον γιατρό ανάλο γα με το ιστορικό, τους παράγοντες κινδύνου και τα αποτελέσματα προηγούμενων διαγνωστικών εξετά σεων. Στόχος του είναι προαγωγή της ατομικής και οι


Η ΑΞΙΑ ΤΟΥ CHECK
κογενειακής υγείας. Επιπλέον στοχεύει στην ανίχνευση
παραγόντων κινδύνου που μπορούν να εξελιχθούν σε
νόσο και που μπορούν να αντιστραφούν με αλλαγή
του τρόπου ζωής. Τέλος, γίνεται ανίχνευση παθήσεων
που συνήθως είναι ασυμπτωματικές, καθώς επίσης η
καλή συμμόρφωση με την αγωγή των ήδη υφιστάμε
νων παθήσεων. Ανάλογα με το φύλο και την ηλικία, τα υφιστάμενα
προβλήματα υγείας, προδιαθεσικούς ή κληρονομικούς
παράγοντες, η συχνότητα του check up διαφοροποι είται. Επίσης, μπορεί να αλλάζει με βάση τα αρχικά ευρήματα. Ο προληπτικός έλεγχος περιλαμβάνει τη λήψη ιατρικού ιστορικού, κλινική εξέταση και εργαστη ριακό-απεικονιστικό έλεγχο. Στο «Ερρίκος Ντυνάν», αναγνωρίζοντας τη σημα ντικότητα του περιοδικού προληπτικού ελέγχου και ότι αποτελεί επιλογή των ασθενών να εμπιστευτούν το νοσοκομείο μας, δημιουργήθηκε ένας σύγχρονος ξεχωριστός χώρος με πιστοποιημένο ιατροτεχνολο γικό εξοπλισμό και τη συμμετοχή όλων των ιατρικών
ειδικοτήτων με στόχο την εξατομικευμένη προληπτική Ιατρική. Στόχος του νοσοκομείου μας είναι να πραγμα τοποιείται ένας ολοκληρωμένος προληπτικός έλεγχος σε σύντομο χρονικό διάστημα. Έχουμε δημιουργήσει πακέτα προληπτικού ελέγχου που καλύπτουν τις ανάγκες των ασθενών μας, αλλά είμαστε και στη διάθεσή τους να δημιουργήσουμε εξα τομικευμένα πακέτα. Επιπλέον διαχειριζόμαστε προλη πτικούς ελέγχους μεγάλων εταιρειών που έχουν δημι ουργήσει οι Ιατροί Εργασίας τους ή που έχουμε κληθεί να δημιουργήσουμε εμείς ανάλογα τις ανάγκες τους. Προβαίνουμε σε συνεχείς ενημερώσεις και καμπάνιες αφύπνισης του κοινού για τη σημαντικότητα του περι οδικού προληπτικού ελέγχου είτε μέσω διαφημιστικών καμπανιών είτε μέσω δημιουργίας μικρών ευέλικτων πακέτων για προληπτικό έλεγχο και έγκαιρη διάγνω ση ασθενειών, όπως καρκίνος του μαστού, καρκίνος προστάτη κ.ά. «Κάλλιον του θεραπεύειν το προλαµβάνειν», υπο στήριζε ο Ιπποκράτης από την αρχαιότητα. ■
παθολόγος, διευθύντρια Τμήματος Επειγόντων Περιστατικών - Τμήματος Check Up, «Ερρίκος Ντυνάν». ΕΚΠΑΙΔΕΥΣΗ • Πτυχίο Ιατρικής, University of SEMMELWEIS -Αγγλόφωνο Τμήμα- Βουδαπέστη-Ουγγαρία 23/06/2000. • Τίτλος Ειδικότητας Παθολογίας, Απρίλιος 2012. ΕΠΑΓΓΕΛΜΑΤΙΚΗ ΕΜΠΕΙΡΙΑ Οι σημαντικότεροι σταθμοί στην επαγγελματική της πορεία είναι οι εξής: • Τρίμηνο ειδικότητας ΓΝΑ Νοσο κομείο Κεφαλληνίας (Τμήματα Παθολογίας-Χειρουργικής-Καρδιολογίας) από 4/10/2002 έως 3/1/2003. • Αγροτικός Ιατρός στο Κ.Υ. Σάμης Κεφαλληνίας από 07/01/2003 μέχρι 07/01/2004. • Clinical Research Associate στην εταιρεία Zeincro Hellas από 09/03/2005 μέχρι 30/11/2006 (υπεύθυνη για την εκπαίδευση ιατρών και παρακολούθηση διενέργειας κλινικών μελετών, συμμετοχή στη δημιουργία κλινικών πρωτοκόλ λων, εκπαίδευση ιατρικών επισκεπτών στις βασικές αρχές της Ανατομίας-Παθολογίας-Παθοφυσιολογίας). • Ειδικευόμενη Ιατρός Παθολογίας στο ΓΝΑ «Γ. Γεννηματάς», στη Γ' Παθολογική Κλινική από 6/12/2006 μέχρι 23/04/2012. • Επιμελήτρια Ογκολογικού Τμήματος Ιδιωτικής κλινικής από 01/10/2012 έως 01/07/2014. • Επιμελήτρια Παθολογικού Τμήματος Ιδιωτικής κλινικής από 01/10/2014 έως και 01/11/2015. • Ιδιωτικό ιατρείο στον Βύρωνα από 01/03/2013 έως και σήμερα. • Υπεύθυνη Ιατρός στη Μονάδα Φροντίδας Ηλικι ωμένων «Ακτιος» από 01/06/15 έως και 01/09/2016. • Υπεύθυνη Ιατρός Τμήματος Check Up σε ιδιωτική κλινική από τον 01/11/2015 έως και 01/01/2019. Από 01/01/2019 έως και 01/07/2021 ανάληψη καθηκό ντων συντονισμού του Τμήματος Check Up (σχεδιασμό-επιμέλεια
| 69 AΦΙΕΡΩΜΑ | ΔΙΑΓΝΩΣΤΙΚΑ ΚΕΝΤΡΑ
πακέτων check up, εκπαίδευση ιατρού τμήματος στο νέο καθηκοντολόγιο). • Συντονίστρια ιατρός Τμήματος Επειγόντων-triage ιδιωτικής κλινικής από 01/01/2019 έως και 01/07/2021 • Υπεύθυνη ιατρός τηλεοπτικού προγράμματος ΑΝΤ1 «ΝΟΜADS 1 & 2» σε Φιλιππίνες και Μαδαγασκάρη (διενέργεια προληπτικού ελέγχου παικτών και προσωπικού αποστολής, οργάνωση απαραίτητου εμβολιασμού, παροχή Α’ βοηθειών σε όλο το διάστημα των γυρισμάτων). • Διευθύ ντρια Τμήματος Επειγόντων και Check Up σε ιδιωτική κλινική από 01/07/2021 έως και σήμερα. • Υπεύθυνη ιατρός τηλεοπτικού προγράμματος «ASIA EXPRESS» σε Λάος-Καμπότζη-Ταϊλάνδη (διενέργεια προληπτικού ελέγχου παικτών και προσωπικού αποστολής, οργάνωση απαραίτητου εμβολιασμού, παροχή Α’ βοηθειών σε όλο το διάστημα των γυρισμάτων). • Υπεύθυνη ιατρός τηλεοπτικού προγράμματος «LOVE ISLAND» (διε νέργεια προληπτικού ελέγχου παικτών).
ΒΑΡΒΑ ΡΑ ΚΑΛΟΓΕΡ Η Η Βαρβάρα Καλογερή είναι
General Health Care


και προσωποποιημένης παροχής υπη ρεσιών υγείας. Στόχος τους να κάνουν καλύτερη την υγεία και τη ζωή των εξεταζόμενων πολιτών και ασθε νών, υποστηρίζοντας επιστημονικά την αξία της προ ληπτικής Ιατρικής και της έγκαιρης διάγνωσης. Επιδί ωξη τους είναι ο εξεταζόμενος πολίτης να βιώσει μία
μοναδική, ξεχωριστή, προσωποποιημένη εμπειρία στις υπηρεσίες υγείας που του προσφέρουν. Το General Health Care είναι ιατρικές μονάδες πρω τοβάθμιας φροντίδας υγείας, σε Αθήνα (Χαλάνδρι) και Θεσσαλονίκη, και αποτελούν μια διαφοροποίηση στην καθιερωμένη και εδραιωμένη εμπορευματοποίηση της Υγείας στη χώρα μας. Οι ιατρικές μονάδες του General Health Care, πέρα από διαγνωστικά κέντρα, αποτελούνται και από όλες σχεδόν τις ειδικότητες κλινικών ιατρείων, όπως είναι το Καρδιολογικό, Παθολογικό - Γενικής Ιατρικής, Δια βητολογικό, Ενδοκρινολογικό, Ουρολογικό
70 | ΤΑ ΔΙΑΓΝΩΣΤΙΚ Α Κ Ε ΝΤΡΑ General Health Care (GHC) ιδρύθηκαν και δημιουργήθηκαν μέσα στη χρονιά που διανύουμε, το 2022, από μία ομάδα τολμηρών και ονειροπόλων ιατρών που αποφάσισαν να υλοποιή σουν ένα εγχείρημα μοναδικό στο χώρο της Yγείας. Το όραμά τους είναι να αφήσουν ιστορία στο χώρο της ποιοτικής
Νεφρολο
Ο κ. Ιωάννης Βερίγος, η κ. Ελένη Καλογερά και ο κ. Γεώργιος Βιδάκης.
γικό, Ορθοπαιδικό, Πνευμονολογικό, Ρευματολογικό, Χειρουργικό, Ωτορινολαρυγγολογικό, Αιματολογικό. Επίσης, λειτουργούν υπερσύγχρονο Ακτινολογικό Κέντρο αποτελούμενο από Υπέρηχο Triplex, Μέτρηση Οστικής Μάζας, Πανοραμική, Μαστογράφο, καθώς και ειδικά τμήματα Κλινικής Διαιτολογίας, Ιατρικό Τμήμα Πλαστικής & Αισθητικής, Κέντρο Ψυχοθεραπείας, Κέ ντρο Πόνου, Κέντρο Παχυσαρκίας και Μεταβολισμού. Τα διαγνωστικά κέντρα - πολυϊατρεία General Health Care είναι συμβεβλημένα με τον ΕΟΠΥΥ
ταυτότητά τους (ή διαβατήριο ή κάρτα ασφαλισμένου ΕΔΟΕΑΠ για όσους διαθέτουν), ώστε να πιστοποιείται η ταυτοπροσωπία. Ως προς τις διαγνωστικές εξετά σεις, θα προσκομίζουν, επιπλέον των παραπάνω, το ηλεκτρονικό παραπεμπτικό που έχουν λάβει από τον ιατρό. Τα πολυϊατρεία - διαγνωστικά κέντρα του General Health Care εφαρμόζουν Σύστημα Διαχείρισης της Ποι ότητας σύμφωνα με το πρότυπο ISO 9001:2015, πι στοποιημένο από το φορέα πιστοποίησης
διευθύντρια Ελένη Καλογερά, αφού ευχαρίστησαν τον κόσμο, είχαν την ευκαιρία να μιλήσουν για την ιστορία και το όραμα της εταιρείας, αλλά και για το μέλλον και τις προοπτικές ανάπτυξης του General Health Care. Όπως δήλωσε ο πρόεδρος Ιωάννης Βερίγος, «μο

| 71 AΦΙΕΡΩΜΑ | ΔΙΑΓΝΩΣΤΙΚΑ ΚΕΝΤΡΑ
& τον ΕΔΟΕΑΠ και δέχονται τα αντίστοιχα παραπεμπτικά. Εί ναι απαραίτητο να ελέγξετε την ημερομηνία λήξης του παραπεμπτικού σας πριν κλείσετε το ραντεβού σας με το αντίστοιχο ιατρείο! Όλοι οι ασφαλισμένοι του ΕΝΙΑΙΟΥ ΔΗΜΟΣΙΟΓΡΑ ΦΙΚΟΥ ΟΡΓΑΝΙΣΜΟΥ ΕΠΙΚΟΥΡΙΚΗΣ ΑΣΦΑΛΙΣΗΣ ΠΕΡΙ ΘΑΛΨΗΣ (ΕΔΟΕΑΠ) πανελλαδικά μπορούν να κλείνουν ραντεβού απευθείας με τα πολυϊατρεία-διαγνωστικά κέντρα GHC για τη διενέργεια των διαγνωστικών τους
εξετάσεων. Οι ασφαλισμένοι του ΕΔΟΕΑΠ θα πραγματοποιούν τις επισκέψεις τους στο ιατρείο, έχοντας μαζί τους την
A.E. με αριθμό πιστοποιητικού 3644.3/10. Η ΕΚΔ Η ΛΩΣΗ ΤΩΝ ΕΓΚΑΙΝ Ι ΩΝ Τα εγκαίνια του General Health Care στο Χαλάνδρι πραγ ματοποιήθηκαν στα μέσα του Σεπτεμβρίου. Κατά τη δι άρκεια της εκδήλωσης ο πρόεδρος Ιωάννης Βερίγος, ο διευθύνων σύμβουλος Γεώργιος Βιδάκης και η γενική
EQA HELLAS
της ευγένειας και της φροντίδας προς τον άνθρωπο.

3) Οι κτιριακές υποδομές και εγκαταστάσεις είναι διαμορφωμένες πλήρως από την αρχή και προσεγμέ νες μέχρι και την τελευταία λεπτομέρεια. Εξαιρετικοί χώροι φιλοξενίας εξεταζομένων, ειδικός φωτισμός και εξαερισμός στους χώρους αναμονής και εξετάσεων.
4) Σύγχρονα ιατρικά μηχανήματα είναι εγκατεστη μένα και στα 3 υπερσύγχρονα κέντρα με εξοπλισμό τεχνολογίας αιχμής.
5) Ιατροτεχνολογικός εξοπλισμός τελευταίας τεχνο λογίας σε συνεργασία με την General Electric Health Care, κορυφαία εταιρεία στο χώρο της ιατρικής τεχνο λογίας και σε ό,τι αφορά όλους τους υπερήχους των κέντρων.
6) Ο ακτινοδιαγνωστικός εξοπλισμός είναι νέας ψηφιακής τεχνολογίας, σχεδιασμένος για να παρέχει την καλύτερη δυνατή διαγνωστική ακρίβεια για όλους τους ασθενείς με τη χαμηλότερη δυνατή δόση ακτι νοβολίας.
7) Τα υπερσύγχρονα αναλυτικά συστήματα αιματο λογικών - βιοχημικών - ορμονολογικών και ανοσολο γικών αναλυτών είναι της εταιρείας Roche Diagnostics Hellas, της πλέον εξειδικευμένης -σε αυτόν τον τομέαεταιρείας του ιατρικού χώρου. Προσφέρουν τη δυνα τότητα εκτέλεσης ιδιαίτερα εξειδικευμένων εξετάσεων διαγνωστικού και ερευνητικού επιπέδου. 8) Στα υπερσύγχρονα τμήματα Κλινικής Διαιτολογί ας και Αισθητικής Ιατρικής παρέχονται πρωτοποριακές υπηρεσίες υγείας και ευεξίας βασισμένες σε εξοπλι σμό τελευταίας τεχνολογίας. Το πλήρως καταρτισμέ νο επιστημονικό προσωπικό διαθέτει τόσο τις γνώσεις όσο και την εμπειρία για να προτείνει την κατάλληλη προσωποποιημένη θεραπεία.
9) Σύναψη συνεργασίας με κορυφαίους ιατρούς ακτινοδιαγνώστες, με εξαιρετική εμπειρία και ακαδη μαϊκή κατάρτιση. Σκοπός αυτής της συνεργασίας είναι η αξιοποίηση στο έπακρο των δυνατοτήτων του σύγ χρονου εξοπλισμού.
10) Τα Κλινικά Ιατρεία είναι υψηλού επιστημονικού ιατρικού επιπέδου και πλαισιώνονται από κλινικούς ια τρούς όλων σχεδόν των ειδικοτήτων. Ολοκληρώνουν την προσπάθεια των ιατρών να παρακάμψουν νόμους της αγοράς και να υλοποιήσουν ένα όραμα ετών. 11) Όλα τα κέντρα είναι συμβεβλημένα με τον ΕΟ ΠΥΥ και λοιπούς δημόσιους ασφαλιστικούς φορείς. Για περισσότερες πληροφορίες: General Health Care - Αθήνα Δρυάδων 4 & Λ. Πεντέλης 49, Χαλάνδρι 15233 +30 210 689 0089 info@ghc.gr www.ghc.gr ■
72 | ναδική
υγείας. Όχι μόνο εξελιγμένο διαγνωστικό κέντρο, όχι μόνο ποιοτικό πο λυϊατρείο με διαφορετικά ειδικά τμήματα, όπως το κέντρο πόνου ή το κέντρο κεφαλαλγίας ή μετά Covid έλεγχος και παρακολούθηση, όχι μόνο σύγχρονο ια τρικό τμήμα πλαστικής και αισθητικής, όχι απλά τμήμα Kλινικής Διαιτολογίας, αλλά ΟΛΑ ΑΥΤΑ ΜΑΖΙ! Με παροχή ολοκληρωμένων ιατρικών υπηρεσιών στον ίδιο χώρο, με μία εξέχουσα ιατρική επιστημονική ομάδα, με χρήση εξοπλισμού τελευταίας τεχνολογίας και πάντα με επίκεντρο τον κάθε άνθρωπο ξεχωριστά και την άριστη ψυχική και σωματική ευημερία του». ΓΙΑΤ Ι ΝΑ ΕΠΙΛ Ε ΞΕΤΕ ΤΟ GHC 1) Τα ιδρυτικά του μέλη είναι ιατροί με πολύχρονη εμπειρία και εξειδίκευση στην ειδικότητά τους. 2) Το διοικητικό προσωπικό είναι άριστα
με πρωταρχικές αξίες και αρχές
μας δέσμευση είναι η παροχή άριστων ιατρι κών υπηρεσιών με απόλυτο σεβασμό προς τον κάθε άνθρωπο ξεχωριστά». Παράλληλα ο διευθύνων σύμβουλος των ιατρικών μονάδων, Γεώργιος Βιδάκης, δήλωσε χαρακτηριστικά τα εξής: «Το General Health Care είναι ακριβώς αυτό που λένε οι λέξεις: γενική φροντίδα
εκπαιδευ μένο
του σεβασμού,





Μάθετε περισσότερα στο www.juvederm.gr Juvéderm Greece © 2022 AbbVie. All rights reserved. All trademarks are the property of their respective owners. • GR-JUV-220095 Τα μοντέλα μας έλαβαν θεραπεία με JUVÉDERM®. Τα αποτελέσματα της θεραπείας ενδέχεται να ποικίλλουν. ΧΕΙΛΗ ΑΝΩ ΤΜΗΜΑ ΠΡΟΣΩΠΟΥ ΜΕΣΟ ΤΜΗΜΑ ΠΡΟΣΩΠΟΥ ΚΑΤΩ ΤΜΗΜΑ ΠΡΟΣΩΠΟΥ ΠΟΙΟΤΗΤΑ ΔΕΡΜΑΤΟΣ ΔΗΜΙΟΥΡΓΗΣΤΕ ΤΑ ΑΠΟΤΕΛΕΣΜΑΤΑ ΠΟΥ ΕΠΙΘΥΜΟΥΝ Aναγνωρίζουμε τα μοναδικά χαρακτηριστικά των θεραπευόμενων που τους κάνουν ξεχωριστούς Κάθε filler στη συλλογή JUVÉDERM® έχει σχεδιαστεί προσεκτικά, με συγκεκριμένες ιδιότητες, για τη βελτίωση των ιδιαίτερων χαρακτηριστικών κάθε περιοχής του προσώπου.
ΤΗΝ ΠΙΛΟΤΙΚ Η ΕΦΑΡΜΟΓ Η λογισμικού για την απο μακρυσμένη παρακολούθηση και εξατομικευμένη δι αχείριση ασθενών με νεοπλασματικές ασθένειες της Β’ Παιδιατρικής Κλινικής του ΠΓΝΘ ΑΧΕΠΑ ενέκρινε η Περιφέρεια Κεντρικής Μακεδονίας. Το έργο συνολι κού ποσού 148.676 ευρώ αφορά στη δημιουργία μιας ολοκληρωμένης ψηφιακής λύσης, που θα συμβάλει στην ενδυνάμωση της απομακρυσμένης επικοινωνί ας και συνεργασίας των στελεχών του τμήματος με τους ασθενείς/γονείς και εξωτερικούς επαγγελματίες υγείας, επιτυγχάνοντας τη βελτίωση της ποιότητας των προσφερόμενων υπηρεσιών, καθώς και της ποιότητας ζωής των ασθενών. Σύμφωνα με τους ειδικούς, το έργο κρίνεται απα ραίτητο και επιτακτικό, διότι θα συμβάλει στη σημα ντική ελάττωση των εισαγωγών στα επείγοντα. Κάθε χρόνο περίπου 300.000 παιδιά διαγιγνώσκονται με καρκίνο παγκοσμίως. Η πρόοδος των θεραπειών για καρκίνους παιδικής ηλικίας έχει βελτιώσει το ποσοστό επιβίωσης, το οποίο ανέρχεται στο 75%. Για πολλούς ασθενείς
τρόπο ζωτικές πληροφορίες από τους ίδιους τους ασθενείς και επεμβαίνει έγκαιρα για να αναπροσαρμόσει το θεραπευτικό πλάνο. Επίσης οι ασθενείς αποκτούν ισχυρότερη αίσθηση ασφάλειας και συνδεσιμότητας με την ιατρική ομάδα. Αποκτούν πρόσβαση σε ασφαλή φροντίδα χωρίς να μετακινη θούν στο νοσοκομείο και χωρίς

74 |
το μοντέλο της μακρόχρονης παρακολούθη σής τους στην Παιδοαιματολογική - Ογκολογική Μο νάδα από τους θεράποντες ιατρούς φαντάζει ιδανική. Στη Μονάδα Παιδικής και Εφηβικής Αιματολογίας-Ο γκολογίας της Β’ Παιδιατρικής Κλινικής ΑΠΘ στο ΠΓΝΘ ΑΧΕΠΑ θεραπεύονται περί τα 30-40 νέα περιστατικά καρκίνου ετησίως. Ενώ στα εξωτερικά ιατρεία της Μο νάδας παρακολουθούνται για 5-10 χρόνια μετά τη θε ραπεία τους 200 παιδιά και έφηβοι. Η πιλοτική εφαρμογή λογισμικού για την απομα κρυσμένη παρακολούθηση και εξατομικευμένη δια χείριση ασθενών με νεοπλασματικές ασθένειες θα συμβάλει στη βελτίωση της ποιότητας προσφερόμε νων υπηρεσιών, καθώς και της ποιότητας ζωής των ασθενών. Τα
της εφαρμογής είναι
διεπιστημονική ομάδα που παρακολουθεί τους ασθε νείς αποκτά με
τον
πιθανότητες λοιμώξεων. ■ ΤΕΧΝΟΛΟΓΙΚ Ε Σ ΕΞΕΛ Ι ΞΕΙΣ ΣΤΗΝ ΥΠΗΡΕΣ Ι Α ΤΩΝ ΑΣΘΕΝ Ω Ν ! Της ΑΝΘ Η Σ ΑΓΓΕΛΟΠΟΥΛΟΥ Η ΠΑΝΔΗΜ Ι Α Μ Α Σ Ε ΔΩΣΕ Ε ΝΑ ΜΕΓΑ ΛΟ Μ ΑΘΗΜΑ σε όλους τους τομείς της ζωής μας και ειδικότερα στον τομέα της Υγείας. Με αφορμή τα τρία σκληρά χρόνια, καθώς και τις ραγδαίες εξελίξεις του τομέα
κάνουν «αγώνα δρόμου»
να ανακαλύψουν με τη
της τεχνολογίας
θα πρέπει να βρουν ασφαλείς διαδικασίες έτσι ώστε αυτή η τεχνολογική εκτόξευση στην υγειονομική περίθαλψη να βρει την απαραίτητη ανταπόκριση και συγχρόνως να είναι προσβάσιμη για όλους. Με λίγα λόγια, το μέλλον είναι εδώ και καλούμαστε όλοι να το ακολουθήσουμε! Πρόγραμμα παρακολούθησης παιδιατρικών ασθενών από μακριά από το ΑΧΕΠΑ
οφέλη
πολλαπλά. Η
αυτόν
να εκτεθούν σε περι βάλλον με αυξημένες
Υγείας, οι επιστήμονες
καθημερινά για
βοήθεια
νέες πιο αποτελεσματικές και ασφαλείς υπηρεσίες υγείας για τους ασθενείς. Ενώ την ίδια στιγμή, οι ηγεσίες των κρατών
θα μπορούν να κάνουν χη μειοθεραπείες στο σπίτι τους, ενώ, παράλληλα, παιδιά και ενήλικοι με σοβαρά νευρολογικά ή άλλα νοσήματα, που απαιτούν την υποστήριξη ενός ή περισσότερων οργάνων με τη βοήθεια της ιατρικής τεχνολογίας, θα έχουν ασφαλή νοσοκομειακή φροντίδα στο δωμάτιο του σπιτιού τους, χωρίς να χρειάζεται να μπαινοβγαί νουν και να ταλαιπωρούνται στα νοσοκομεία. Αυτό είναι το νέο καινοτόμο μοντέλο υπηρεσιών υγείας που περιλαμβάνεται στο Εθνικό Πρόγραμμα της Κατ’ οίκον Νοσηλείας, το οποίο παρουσίασε ο γενικός γραμματέας Υπηρεσιών Υγείας του υπουργείου Υγείας, Ιωάννης Κωτσιόπουλος. Σύμφωνα με τον κ. Κωτσιόπουλο, το πρόγραμμα έχει εγκριθεί από το Ταμείο Ανάκαμψης και επιχορη γείται με 14 εκατομμύρια ευρώ. Προβλέπεται ότι εντός των επόμενων μηνών σε οκτώ νοσοκομεία της χώρας θα δημιουργηθούν αντίστοιχα κέντρα που ουσιαστι κά θα υποστηρίζουν τη νοσηλεία του ασθενούς στο σπίτι. Η αρχή θα γίνει από το Ογκολογικό Νοσοκομείο «Άγιος Σάββας», το οποίο ήδη «τρέχει» το καινοτόμο







πρόγραμμα ΟΙΚΟΘΕΝ, όπου ασθενείς με καρκίνο, που πληρούν συγκεκριμένα κριτήρια και προϋποθέσεις, θα έχουν τη δυνατότητα να κάνουν τις χημειοθεραπείες τους στο σπίτι τους, με την υποστήριξη γιατρού και νοσηλευτή. Το ίδιο μοντέλο φροντίδας διευρύνθηκε και θα εφαρμοστεί και σε άλλα νοσήματα. Συγκεκριμένα σε χρόνιους πάσχοντες, που έχουν πολλές επαναεισαγω γές στα νοσοκομεία με μακρά νοσηλεία και κινδυνεύ ουν από ενδονοσοκομειακές λοιμώξεις και ταλαιπω ρούνται οι ίδιοι και οι οικογένειές τους. Να σημειωθεί ότι οι χρόνιοι πάσχοντες με μακρά νοσηλεία έχουν ένα έμμεσο κόστος για την οικογένεια και ένα άμεσο κόστος για το κράτος, που πρέπει να τους φροντίζει σε ένα νοσοκομειακό περιβάλλον. Σήμερα το Εθνικό Πρόγραμμα της Κατ’ Οίκον Νοσηλείας δημιουργεί ένα νέο μοντέλο, όπου ο ασθενής θα μένει σπίτι, θα τον φροντίζει μια διεπιστημονική ομάδα νοσηλευτών, για τρών και των φροντιστών του, με λιγότερο κόστος, μεγαλύτερη ασφάλεια και σε καλύτερο περιβάλλον για τους ασθενείς. ■
του λειτουργίας σε πραγματικό χρόνο. Σύμφωνα με τους επι στήμονες, η εφαρμογή αυτή μπορεί να εντοπίσει καρδιακές αρρυθμίες και κολπική μαρμαρυγή. ■
| 75 Εφαρμογή που μετατρέπει το κινητό τηλέφωνο σε στηθοσκόπιο ΜΕ ΤΗ ΒΟ Η ΘΕΙΑ της Τεχνητής Νοημοσύνης, οι επιστήμονες του King’s College London κατάφεραν να μετατρέψουν τα smartphones σε στηθοσκόπια. Συγκεκρι μένα, δημιούργησαν μια εφαρμογή με την ονομασία Echoes app που μπορεί να καταγράψει όχι μόνο τον καρδιακό ρυθμό, αλλά και μια σειρά από δεδομένων, όπως είναι οι ήχοι που δημιουργούνται ανάμεσα στο άνοιγμα και κλείσιμο των βαλβίδων. Οι καταγραφές αυτές αποστέλλονται στον γιατρό που παρακολουθεί τον ασθενή ώστε να έχει εικόνα της καρδιακής
ΟΓΚΟΛΟΓΙΚΟ Ι ΑΣΘΕΝΕ Ι Σ
Hospital@home για ασθενείς με καρκίνο και νευρολογικά προβλήματα
Η
ντής της Μονάδας, πυρηνικός ιατρός και εκλεγμένος ερευνητής στο ΙΤΕ Γιώργος Ζ. Παπαδάκης, η ένταση του μαγνητικού πεδίου που παράγει ο μαγνητικός το μογράφος είναι της τάξης των 4.7 Tesla και το κόστος προμήθειάς του, έπειτα από διεθνή διαγωνισμό, άγ γιξε τα 2 εκατομμύρια ευρώ, ενώ το σύνολο σχεδόν της επένδυσης, ύψους 3 εκατομμυρίων ευρώ, προήλθε από ίδιους πόρους του Ινστιτούτου Πληροφορικής του ΙΤΕ, με τη συνεισφορά της Περιφέρειας Κρήτης για την προμήθεια του συνοδού εξοπλισμού. Όπως είπε, «η μονάδα υλοποιεί ήδη ερευνητικά έργα ύψους περίπου 250 χιλιάδων ευρώ στα πεδία των καρδιαγγειακών και των νευρο-εκφυλιστικών νοσημάτων, ενώ συμμετέχει στο εθνικό δίκτυο για τα νευρο-εκφυλιστικά νοσήματα, έχοντας αναλάβει την ανάπτυξη και αξιολόγηση ενός καινοτόμου παράγοντα επισημασμένου με ισότοπο εκ πομπής ποζιτρονίου για την ταυτόχρονη απεικόνιση και θεραπεία της νόσου του Αλτσχάιμερ». ■

76 | Διαγνωστικά τεστ για όλους τους ιούς COVID-19, ΓΡ Ι ΠΗ ΚΑΙ RSV είναι στο επίκεντρο του ενδιαφέροντος της επιστημονικής κοινότητας σε παγκόσμιο επίπεδο. Η αυξημένη ανησυχία οφείλεται στο ότι λόγω των περιοριστικών μέτρων της πανδημίας τα τελευταία 2 χρόνια έχει εξασθενίσει η φυσική ανοσία έναντι του ιού της γρίπης και του RSV. Τα συμπτώματα των τριών αναπνευστικών ιών είναι παρόμοια, με τον RSV να αποτελεί μεγαλύτερο κίνδυνο για παιδιά κάτω των 5 ετών και ενήλικες άνω των 65, κυρίως λόγω της απουσίας εμβολίου. Ουσιαστική συμβολή
ΜΙΑ ΙΔΙΑ Ι ΤΕΡΗ ΕΡΕΥΝΗΤΙΚ Η ΥΠΟΔΟΜ
στην έγκαιρη και με απλό τρό πο διάγνωση έρχεται να δώσει μια εταιρεία βιοτεχνολογίας με έδρα τη Λάρισα, προσφέροντας απλά εργαλεία στα χέρια των επαγγελματιών υγείας. Η ProGnosis-Biotech αποτελεί τη μοναδική ελληνική εταιρεία που παράγει διαγνωστικά τεστ για όλους αυτούς τους ιούς. Βραβευμένη πολλάκις για την καινοτομία της ως η εταιρείας κατασκευής των πρώτων και μοναδικών ελληνικών rapid και self-test για την COVID-19, η ProGnosis Biotech συνεχίζει να εξελίσσει τον κατάλογο των κλινικών διαγνωστικών της, προσθέτοντας σε αυτά λύσεις, τόσο για τη γρίπη τύπου Α και Β όσο και για τον αναπνευστικό συγκυτιακό ιό RSV και τον αδενοϊό. ■ Ο πιο ισχυρός μαγνητικός τομογράφος στην Ελλάδα
δημιουργή θηκε στο Ινστιτούτο Πληροφορικής του Ιδρύματος Τε χνολογίας και Έρευνας στην Κρήτη και συγκεκριμένα στη Μονάδα Υβριδικών Τεχνικών Μοριακής Απεικόνι σης, η οποία φιλοξενεί έναν ερευνητικό τομογράφο, τον τέταρτο παγκοσμίως, που ενσωματώνει τις τελευ ταίες τεχνολογικές εξελίξεις στο πεδίο των τεχνικών μοριακής απεικόνισης. Πρόκειται για έναν προ-κλινικό υβριδικό τομογρά φο Ποζιτρονικής/Μαγνητικής Τομογραφίας που πα ρέχει τη δυνατότητα ταυτόχρονης λήψης δεδομένων από τους δύο τομογράφους. Η νέα υποδομή παρέχει βάσιμες υποσχέσεις για σημαντική συνεισφορά στην εξατομικευμένη και αποτελεσματική διαχείριση νοση μάτων, όπως είναι τα καρδιαγγειακά, οι κακοήθειες, νευροεκφυλιστικά, ρευματολογικά και άλλα πολυ-συ στηματικά νοσήματα. Όπως ανέφερε στο ΑΠΕ ο επιστημονικός διευθυ
παρακολούθησης της θέσης του ασθε νούς πριν και κατά τη διάρκεια της ακτινοθεραπείας, AlignRT®Advance. Το σύστημα αυτό καθιστά τη θερα πεία ασφαλέστερη χρησιμοποιώντας μια ειδική τεχνι κή (στο εγγύς μέλλον και χωρίς σημάδια - tattoo) για την παρακολούθηση της επιφάνειας του δέρματος ενός ασθενούς σε πραγματικό χρόνο με ακρίβεια υπο διαίρεσης του χιλιοστού, με αποτέλεσμα να διασφαλί ζει ότι η ακτινοβολία παρέχεται μόνο όταν ο ασθενής είναι σωστά τοποθετημένος. Το AlignRT®Advance εί ναι εγκατεστημένο σε περισσότερα από 1.500 κέντρα παγκοσμίως και τουλάχιστον 70 δημοσιευμένες μελέ τες αποδεικνύουν την κλινική ακρίβειά του σε διάφο ρες εφαρμογές. ■
Emergency Medical Teams
2030 από τον ΠΟΥ
από το εσωτε ρικό του ιστού με πρωτοφανή ταχύτητα. Σύμφωνα με το Indipendet, το ενδομικροσκόπιο θα βοηθήσει τους χειρούργους να εντοπίζουν καρκινικά κύτταρα μεγέθους ενός εκατοστού του χιλιοστού με πολύ ταχύτερο ρυθμό από τις παραδοσιακές μεθό δους, αλλά και στη χειρουργική επέμβαση διατήρησης του μαστού, όπου ο χειρουργός αφαιρεί τον καρκίνο αφήνοντας
Ο ΠΟΥ ΕΓΚΑΙΝ Ι ΑΣΕ ΤΗ ΣΤΡΑΤΗΓΙΚ Η Emergency Medical Teams 2030 (Δίκτυο Επείγουσας Ιατρικής Ομά δας - EMT) στην 5η Παγκόσμια Συνάντηση EMT που έγινε στο Γερεβάν της Αρμενίας, παρουσιάζοντας τις νέες προσεγγίσεις για την ταχύτερη και αποτελεσματι κότερη απόκριση σε κρίσεις, όπως φυσικές καταστρο φές, εστίες ασθενειών και συγκρούσεις. Η στρατηγική EMT 2030 είναι επένδυση υψηλού αντίκτυπου στην ετοιμότητα για καταστάσεις έκτακτης ανάγκης και για τα επόμενα οκτώ χρόνια θα συνεχιστεί η ανάπτυξη ενός δικτύου αποτελεσματικών και υψηλής απόδοσης εθνικών, υποεθνικών και περιφερειακών προτύπων. «Καθώς χτίζουμε μια νέα και ισχυρότερη αρχιτεκτονική για την ετοιμότητα και την ανταπό κριση σε καταστάσεις έκτακτης ανάγκης υγείας, ένα ταχέως αναπτυσσόμενο παγκόσμιο σώμα έκτακτης ανάγκης υγείας θα είναι ζωτικής σημασίας, με βάση την εμπειρία και τις ικανότητες των ιατρικών ομάδων έκτακτης ανάγκης», δήλωσε ο Δρ Tedros Adhanom Ghebreyesus, γενικός διευθυντής του Παγκόσμιου Οργανισμού Υγείας, συμπληρώνοντας: «Η στρατηγική EMT 2030 οραματίζεται έναν κόσμο στον οποίο κάθε χώρα έχει τη δυνατότητα να ανταποκρίνεται γρήγορα και αποτελεσματικά σε εθνικές καταστάσεις έκτακτης ανάγκης, αξιοποιώντας τις περιφερειακές και υποπε ριφερειακές ικανότητες για την υποστήριξη ευάλωτων κοινοτήτων και άλλων που έχουν ανάγκη». Σύμφωνα με τους ειδικούς, η συνεχιζόμενη πανδημία COVID-19, που διανύει τώρα το τρίτο έτος της, έχει δημιουργήσει ένα ιδιαίτερα απαιτητικό πλαίσιο για την αντιμετώπιση έκτακτων περιστατικών σε πολλές χώρες, αυξάνοντας τη ζήτηση για εξειδικευμένες δεξιότητες για την πρό ληψη και τον έλεγχο των λοιμώξεων και τη διαχείριση κρουσμάτων σοβαρών λοιμώξεων του αναπνευστικού. Σε απάντηση σε αυτό, το δίκτυο EMT ανέπτυξε σχεδόν 200 διεθνείς EMT για να υποστηρίξει την ανταπόκρι ση σε 67 χώρες, υπογραμμίζοντας το ρόλο των εξειδι κευμένων ομάδων φροντίδας που υποστηρίζουν την ανταπόκριση μιας χώρας ενώ αναπτύσσουν τις εθνι κές τους ικανότητες. ■
| 77 | ΤΕΧΝΟΛΟΓΙΚΕΣ ΕΞΕΛΙΞΕΙΣ Ενδομικροσκόπιο 1 χιλιοστού για την αντιμετώπιση του καρκίνου του μαστού ΕΡΕΥΝΗΤ Ε Σ ΤΟΥ IMPERIAL COLLEGE στο Λονδίνου ανέπτυξαν ένα ενδομικροσκόπιο διαμέτρου μικρότε ρης του 1 χιλιοστού, το οποίο εισέρχεται στο ανθρώ πινο σώμα και μπορεί να δώσει εικόνες
όσο το δυνατόν περισσότερο φυσιολογικό μαστό. Οι ερευνητές θα ξεκινήσουν σύντομα κλινικές δοκιμές ώστε το ενδομικροσκόπιο να είναι διαθέσιμο τα επόμενα 5 έτη. ■ Νέα εποχή στην Ακτινοθεραπεία και τη Στερεοτακτική Ακτινοχειρουργική ΤΟ Κ Ε ΝΤΡΟ ΑΚΤΙΝΟΘΕΡΑΠΕΥΤΙΚ Η Σ Ογκολογίας & Στερεοτακτικής Ακτινοχειρουργικής του Mediterraneo Hospital είναι το πρώτο και μοναδικό στην Ελλάδα που εφαρμόζει την τεχνολογία Surface Guided Radiation Therapy (SGRT) με την εγκατάσταση του συστήμα τος οπτικής
ΤΟ ΚΕΝΤΡΟ ΕΦΑΡΜΟΓΩΝ και Υπηρεσιών Ηλεκτρονι κής Υγείας του Ινστιτούτου Πληροφορικής του Ιδρύμα τος Τεχνολογίας και Έρευνας έχει επιλεγεί από τέσσερις αγοραστές, που εκπροσωπούν παρόχους υγειονομικής περίθαλψης από την Ιταλία, τη Γερμανία και την Ισπα νία, για την ανάπτυξη της ψηφιακής λύσης BONVITA, που κινείται πέρα κι από τις πιο πρόσφατες τεχνολογι κές εξελίξεις, προσφέροντας μια ολιστική πλατφόρμα, η οποία ενσωματώνει όλα τα βασικά στοιχεία που απαι τούνται για τον αποτελεσματικό έλεγχο, την πρόληψη και τη διαχείριση της ευπάθειας στους ηλικιωμένους. Η έξυπνη ψηφιακή πλατφόρμα BONVITA υποστη ρίζει τη διεπιστημονική φροντίδα των ευάλωτων και ευπαθών ηλικιωμένων αξιοποιώντας υπηρεσίες ειδικά σχεδιασμένες για επαγγελματίες παροχής υπηρεσιών υγείας, περιθάλποντες και ηλικιωμένους. Οι υπηρεσίες της BONVITA είναι προσβάσιμες μέσω Διαδικτύου, τη λεοράσεων, φορητών συσκευών και υπολογιστών, και επιτρέπουν τη διασύνδεση με αισθητήρες και φορητές συσκευές που διατίθενται στην αγορά. Η BONVITA ενσωματώνει υπηρεσίες για την υπο στήριξη της ενεργούς και υγιούς γήρανσης συμβάλ λοντας στην ενδυνάμωση των ηλικιωμένων και στην ενίσχυση της ανεξάρτητης διαβίωσής τους. Επίσης υποστηρίζει υπηρεσίες διαχείρισης φαρμάκων, εκπαί δευσης και κατάρτισης, έξυπνου σχεδιασμού στόχων,

παροχής συστάσεων με βάση τις εξατομικευμένες ανάγκες, παροχής ειδοποιήσεων βοήθειας, επιλογής εξατομικευμένων παιχνιδιών για τη βελτίωση της φυ σικής και ψυχολογικής κατάστασης, έξυπνου ημερο λογίου, έξυπνου πίνακα ελέγχου και προβολής αναφο ρών και αναλύσεων. Οι αλγόριθμοι επιτρέπουν τη δι αστρωμάτωση των ασθενών, την πρόβλεψη κινδύνου και την ανίχνευση της ευπάθειας. Η BONVITA προσφέ ρει λειτουργικότητες μέσω φωνής, χρησιμοποιώντας έναν έξυπνο εικονικό φροντιστή. Να σημειωθεί ότι η ψηφιακή πλατφόρμα BONVITA υλοποιείται στο πλαίσιο προεμπορικής σύμβασης για το έργο eCare. ■
ση σωματικών κολιφάγων ιών και άλλων παθογόνων μικροοργανισμών που δύναται να εμφανιστούν σε επιφανειακά ύδατα. Το καινοτόμο πιλοτικό έργο ευθυ γραμμίζεται με τις νέες απαιτήσεις για την ασφάλεια υδάτων, όπως ορίζονται από την αναθεωρημένη Οδη γία της Ε.Ε. (Ε.Ε. 2020/2184) για το πόσιμο νερό. ■
επίκουρο καθηγητή Γκίκα Μαγιορκίνη. Του έργου ηγείται η καθηγήτρια Αναστασία Κοτανίδου. Για ακόμη μία φορά Έλληνες επιστήμονες πρωτοπορούν με την τεχνολογία αιχμής που διαθέτει η Dna sequence στη χαρτογράφηση του μικροβιώματος και πιθανόν να θέσει υπό επανεξέταση τα πρωτόκολλα ανίχνευσης επιδημιών, ιδιαίτερα σε ιδρύματα υγειονομικής περίθαλψης. ■
78 | Ανίχνευση κολιφάγων ιών για πρώτη φορά στην Ελλάδα ΓΙΑ ΠΡ ΩΤΗ ΦΟΡΑ ΣΤΗΝ ΕΛΛ Α ΔΑ, η νεοφυής εταιρεία Βιοτεχνολογίας DNA SEQUENCE ανακοινώνει καινοτό μο πιλοτική εφαρμογή ελέγχου βιοπαρακολούθησης υδάτων με χρήση τεχνολογιών αλληλούχησης νέας γενιάς, σε συνεργασία με την ΕΥΔΑΠ.
τη βιοπαρακολούθηση
με ιδιαίτερη εστίαση
Συγκεκριμένα, το έργο αφορά
μη επεξεργα σμένων υδάτων,
στην ανίχνευ
Μεταγονιδιωματική για την αντιμετώπιση των ενδονοσοκομειακών λοιμώξεων Η DNA SEQUENCE ΑΝΑΚΟΙΝΩΣΕ τη συνεργασία της με τη ΜΕΘ του Νοσοκομείου «Ευαγγελισμός». Για πρώ τη φορά στην Ελλάδα θα γίνει εφαρμογή της μεταγο νιδιωματικής τεχνολογίας για τη χαρτογράφηση των ενδονοσοκομειακών λοιμώξεων. Η εφαρμογή θα γίνει σε συνεργασία με την Ιατρική σχολή Αθηνών και συγκε
με το
της καθηγήτριας
και με τον
κριμένα
εργαστήριο
Παγώνας Λά γιου
Ψηφιακές λύσεις για τη διαχείριση της ευπάθειας σε ηλικιωμένους
το πρόγραμ μα ADD-freeTraining (Preventing Smoking, Alcohol and Internet addictions among children and adolescents: a family oriented training approach for adult learners and educators), το οποίο χρηματοδοτείται από το Πρό γραμμα ERASMUS+ της Ευρωπαϊκής Ένωσης και διεξά γεται με τη συμμετοχή οργανισμών από 5 χώρες. Από την Ελλάδα συμμετέχουν το Ίδρυμα Ορμύλια (συντονι στής) και το Ινστιτούτο Prolepsis. Συμμετέχουν επίσης οι οργανισμοί: Bulgaria Youth Prevention (Βουλγαρία), Institut društvenih znanosti «Ivo Pilar» (Κροατία), CSICenter for Social Innovation LTD (Κύπρος), University of

Belgrade - Faculty of Medicine (Σερβία). Σύμφωνα με τα στοιχεία της καθηγήτριας Αθηνάς Λινού, οι διεθνείς μελέτες δείχνουν ότι το 6-7% του πληθυσμού είναι ήδη εθισμένο στη χρήση του Δια δικτύου, ποσοστό που αναμφίβολα θα αυξηθεί μετά τις επιπτώσεις που έχει προκαλέσει η πανδημία στην καθημερινότητα των παιδιών. Ο συγκεκριμένος εθι σμός έχει αποδειχθεί ότι μπορεί να προκαλέσει ποικί λα προβλήματα στη σωματική και ψυχική υγεία, όπως μυοσκελετικά προβλήματα, παχυσαρκία, προβλήματα όρασης, καθιστική ζωή και άγχος. Την ίδια στιγμή, γονείς και δάσκαλοι δηλώνουν απροετοίμαστοι και εκφράζουν αδυναμία για την πρό ληψη και την αντιμετώπιση του προβλήματος. Παράλ ληλα, σε παγκόσμια κλίμακα, 8 εκατομμύρια θάνατοι ετησίως φαίνεται να αποδίδονται στο κάπνισμα, ενώ 3 εκατομμύρια θανάτους κάθε χρόνο προκαλεί και ο εθισμός στο αλκοόλ. Το πρόγραμμα ADD-freeTraining διδάσκει πώς να ενδυναμώνουμε τα παιδιά και τους εφήβους να παραμείνουν απαλλαγμένοι από κάθε εί δους εθισμό. ■
και προπονητών ως διευκολυντών για την υποστήριξη και περαιτέρω ανάπτυξη του δικτύου και γ) η παροχή της εφαρμογής
νέων.
καθηγητής Τμήματος Ιατρικής Πανεπιστημίου Πατρών, θεωρεί ότι είναι μια εξαι ρετική ευκαιρία να αναπτυχθούν κατευθυντήριες γραμμές και καλές πρακτικές υγιεινού τρόπου ζωής με έμφαση στη σωματική δραστηριότητα και τη διατροφή για άτομα που έχουν επιβιώσει από τον καρκίνο. ■
| 79 Ευρωπαϊκό πρόγραμμα ADDfreeΤraining για την πρόληψη των εθισμών στους νέους ΠΡΙΝ ΑΠ Ο Λ Ι ΓΕΣ ΗΜ Ε ΡΕΣ ανακοινώθηκε
Πρόγραμμα πρόληψης της υγείας στο Πανεπιστήμιο Πατρών Η ΕΛΛ Α ΔΑ Μ Ε ΣΩ ΤΟΥ ΠΑΝΕΠΙΣΤΗΜ Ι ΟΥ Πατρών συμμετέχει στο πρωτοποριακό ευρωπαϊκό πρόγραμμα EU4Health που έρχεται να δώσει απαντήσεις και να ανοίξει δρόμους για την ποιότητα ζωής των νέων που επι βιώνουν από τον καρκίνο. Σε αυτό το πλαίσιο, το έργο OACCUs [OAC Sees (C) Us και OAC Connects Us] αφορά τους νέους επιζώντες από καρκίνο και το σύνθημα του έργου είναι: «ΔΙΑΛΕΞΤΕ τον ΥΓΙΕΙΝΟ τρόπο!» προωθώ ντας 4 βασικά σημεία: α) υπαίθρια αθλήματα και άσκηση, β) ψυχοεκπαίδευση, γ) υγιεινή διατροφή και δ) υγιεινό περιβάλλον (ή βιώσιμος τρόπος ζωής). Το OACCUs επιδιώκει την ιδέα της εκπαίδευσης νεαρών επιζώντων από καρκίνο, των οικογενειών και των φίλων τους ως πρεσβευτές και προπονητές σε κάθε συμμετέχουσα χώρα και την ανάπτυξη και διατήρηση ενός δικτύου νέων επιζώντων από καρκίνο. Και οι 14 εταίροι που λαμβάνουν μέρος στο πρόγραμμα αυτό ασχολούνται ήδη με το θέμα των νεαρών επιζώντων από καρκίνο ή/και έχουν αναπτύξει ιδέες για πρωτογενή, δευτερογενή και τριτογενή πρόληψη του καρκίνου μαζί με συνεργάτες τα τελευταία χρόνια. Τα κύρια αποτελέσματα των OACCUs θα είναι: α) ένα ζωντανό και βιώσιμο δίκτυο νέων, β) η εκπαίδευση πολλών πρεσβευτών
OACCUs για τη συμμετοχή και τη σύνδεση συμμετεχόντων
Ο Απόστολος Βανταράκης,
ανακατασκευής του Κέντρου Μελανώματος και Καρκί νου Δέρματος, η οποία ολοκληρώθηκε το 2018 με την υποστήριξη του Ιδρύματος Ωνάση.
Στο Νοσοκομείο «Ανδρέας Συγγρός» δημιουρ γήθηκε ένας σύγχρονος και λειτουργικός χώρος, ο οποίος υποδέχεται καθημερινά περισσότερους από 40 ασθενείς με δερματο-ογκολογικές παθήσεις, επιτε λώντας ένα σημαντικό έργο απέναντι σε μια ταχύτατα αναπτυσσόμενη νόσο, που εξελίσσεται σε σύγχρονη μάστιγα: από το Nοσοκομείο «Ανδρέας Συγγρός» και μόνο, κάθε χρόνο διαγιγνώσκονται περίπου 1.000 νέα κρούσματα μελανώματος και

80 | ΤΟ ΝΟΣΟΚΟΜΕ Ι Ο «ΑΝΔΡ Ε ΑΣ ΣΥΓΓΡ ΟΣ» εξοπλίστηκε πριν λίγες μέρες με το τελευταίας τεχνολογίας μηχάνη μα VECTRA WB360, που αποτελεί αποκλειστική δωρεά του Ιδρύματος Ωνάση, με σκοπό την έγκαιρη διάγνωση του καρκίνου του δέρματος. Η δωρεά του μηχανήμα τος VECTRA WB360 έρχεται σε συνέχεια της συνολικής
του δέρματος, ΝΟΣΟΚΟΜΕ Ι Ο ΑΦΡΟΔ Ι ΣΙΩΝ & ΔΕΡΜΑΤΙΚ Ω Ν Ν ΟΣΩΝ «ΑΝΔΡ Ε ΑΣ ΣΥΓΓΡ ΟΣ» Μηχάνημα με ΤΕΧΝΗΤ Η ΝΟΗΜΟΣ Υ ΝΗ για έγκαιρη διάγνωση του καρκίνου του δέρματος! Από αριστερά: Ο πρύτανης του Εθνικού και Καποδιστριακού Πανεπιστημίου Αθηνών κ. Μελέτιος-Αθανάσιος Δημόπουλος, ο πρόεδρος του Ιδρύματος Ωνάση κ. Αντώνης Σ. Παπαδημητρίου, η αναπληρώτρια υπουργός Υγείας κ. Μίνα Γκάγκα, ο βουλευτής Ρεθύμνης και Τομεάρχης Υγείας του ΣΥΡΙΖΑ-Π.Σ. κ. Ανδρέας Ξανθός, ο καθηγητής Δερματολογίας και Αφροδισιολογίας και διευθυντής του Νοσοκομείου «Ανδρέας Συγγρός» κ. Αλέξανδρος Στρατηγός.
καρκίνου
γεγονός που μεταφράζεται σε επείγουσα κατάσταση δημόσιας υγείας. Το νέο κέντρο, με εμβαδόν 250 τετραγωνικά μέτρα (τριπλάσιο από εκείνο του προηγούμενου χώρου), δια θέτει τέσσερα εξεταστήρια, χώρο μικροεπεμβάσεων, χώρο προσωπικού, καθώς και αίθουσα βιβλιοθήκης, διασκέψεων και συνεντεύξεων ασθενών. Το σπουδαίο αυτό έργο του κέντρου έρχεται από σήμερα να θωρα κίσει το VECTRA WB360, το οποίο αποτελεί συνώνυμο της ιατρικής καινοτομίας και έρευνας στον τομέα της Δερματολογίας. Τα πλεονεκτήματα


όπως και οι μεταβολές τους στο χρόνο. • Μια 3D καταγραφή καλύπτει σχεδόν όλο το δέρμα του ασθενούς, εξοικονομώντας χρόνο στη φωτογρά φιση και βελτιώνοντας την άνεση του ασθενούς. • Οι 3D εικόνες υψηλής ευκρίνειας μειώνουν την απαιτούμενη ποσότητα κοντινών εικόνων. • Οι ενσωματωμένοι αλγόριθμοι Τεχνητής Νοημο σύνης που περιέχει το VECTRA WB360 επιτρέπουν την
αυτοματοποιημένη συγκέντρωση όλων των βλαβών του δέρματος ενός ασθενούς, ενώ παρέχουν και το πλεονέκτημα της σύγκρισης σε εξακολουθητικές φω τογραφίσεις. • Πρακτικά, η τρισδιάστατη εικόνα, οι φωτογραφί ες από κοντά, τα χαρακτηριστικά αναζήτησης και οι σημειώσεις του γιατρού παρέχουν το κλινικό ιστορικό. Στην αρχική του εφαρμογή, το μηχάνημα θα χρη σιμοποιείται για ασθενείς με ιστορικό μελανώματος ή με αυξημένο κίνδυνο για εμφάνιση καρκίνου του δέρ ματος (ιστορικό προηγούμενου καρκίνου δέρματος, οικογενειακό ιστορικό μελανώματος, ιστορικό έντο νης έκθεσης στον ήλιο με πολλαπλά εγκαύματα κ.ά.). Στην πορεία, η χρήση του δύναται να επεκταθεί σε υγιή άτομα για την πρόληψη του καρκίνου του δέρματος, καθώς και σε άλλους δερματολογικούς ασθενείς, για την παρακολούθηση ενός μεγάλου εύρους δερματο λογικών νοσημάτων, όπως της ψωρίασης, της λεύκης, των πομφολυγωδών νοσημάτων, για τη διαχείριση εγκαυμάτων κ.ά. Στο πλαίσιο της εκδήλωσης παρουσίασης του νέου μηχανήματος, ο πρόεδρος του Ιδρύματος Ωνάση Αντώνης Παπαδημητρίου δήλωσε: «Η σημερινή πρω τοβουλία υπογραμμίζει τη συνέπεια και την προσήλω ση των ανθρώπων του Ιδρύματος στην καινοτομία, στην αριστεία
| ΚΑΙΝΟΤΟΜΙΕΣ ΥΓΕΙΑΣ | 81
του
είναι αναλυτικά τα
• Η τρισδιάστατη απεικόνιση που μπορεί και προ σφέρει το συγκεκριμένο μηχάνημα μέσα από 92 κά μερες, οι οποίες τραβούν μια στιγμιαία φωτογραφία, αποτελεί το μέλλον της Δερματολογίας και της Δερμα τολογικής Ογκολογίας, αφού παρέχει τη δυνατότητα να παρακολουθούνται όλες οι βλάβες ενός ασθενούς ταυτόχρονα,
νέου μηχανήματος
εξής:
κάτω από την ομπρέλα της ψηφιακής Υγείας: του επόμενου Ο κ. Αντώνης Σ. Παπαδημητρίου. Ο κ. Αλέξανδρος Στρατηγός.
και την έρευνα, που συναντώνται
Στρατηγός, διευθυντής του Νοσοκομείου «Ανδρέας Συγγρός», ανέφερε: «Η σημαντική δωρεά του Ιδρύμα τος Ωνάση μάς επιτρέπει να αναβαθμίσουμε με κα ταλυτικό Το νέο υπερσύγχρονο μηχάνημα VECTRA WB360, αποκλειστική δωρεά του Ιδρύματος Ωνάση προς το Νοσοκομείο «Ανδρέας Συγγρός».

82 | δηλαδή κεφαλαίου στην παροχή ιατρικής περίθαλψης προς τον ασθενή. Δεν θα μπορούσε να συμβεί δια φορετικά σε μια διαδρομή που έχει ξεκινήσει από το ιδρυτικό όραμα του Αριστοτέλη Ωνάση, μας ενώνει όλους στο παρόν και θέτει τις βάσεις για να ξανασυ ναντηθούμε στο μέλλον και να συνεχίσουμε
τη συνερ γασία μας». Από την πλευρά του, ο καθηγητής Αλέξανδρος τρόπο τις παρεχόμενες υπηρεσίες στο πεδίο της αντιμετώπισης των δερματικών όγκων και να προ σθέσουμε ένα κορυφαίας τεχνολογίας όπλο για την πρόληψη και έγκαιρη διάγνωση του μελανώματος και του καρκίνου του δέρματος». ■
Κάθε εξέταση Αξονικής Τομογραφίας που πραγματοποιείται στα διαγνωστικά κέντρα Affidea γίνεται με τη χαμηλότερη δυνατή δόση ακτινοβολίας, για να σας προσφέρουμε ασφαλή και ποιοτική διάγνωση. Ενημερωθείτε για το πρόγραμμα βελτιστοποίησης της δόσης ακτινοβολίας



Dose Excellence που εφαρμόζει ο Όμιλος Affidea

αποκλειστικότητα
περισσότερα για τα μέτρα που λαμβάνουμε για την προστασία σας στο affidea.gr. Είστε ασφαλείς, όταν κάνετε ασφαλείς εξετάσεις. affidea.gr Το Dose Excellence έχει λάβει πολλαπλές βραβεύσεις και διακρίσεις από την ιατρική κοινότητα πανευρωπαϊκά.
κατ’
και μάθετε
Η
iGEM MetaThess αποτελείται από επτά μετα πτυχιακούς φοιτητές από το Αριστοτέλειο Πανεπιστήμιο Θεσσαλονίκης, που δημιουργήθηκε τον Νοέμβριο του 2021 με σκοπό να συμμετάσχει στον Παγκόσμιο Διαγωνι σμό Συνθετικής Βιολογίας iGEM, που πραγματοποιήθηκε στο Παρίσι στις 26-28 Οκτωβρίου 2022. Στο διαγωνισμό συμμετείχαν συνολικά πάνω 350 ομάδες από 45 χώρες ανά τον κόσμο και κριτές στους οποίους παρουσιάστηκε το πρότζεκτ της ομάδας για την τελική αξιολόγηση. Η ομάδα iGEM MetaThess κατάφερε να κατακτήσει το πρώτο βραβείο στην κατηγορία της, δηλαδή έλαβε τη διάκριση του Best Diagnostics Project στην κατηγο ρία των Διαγνωστικών για τα Project των μεταπτυχια κών φοιτητών. Επιπλέον, στο σύνολο των διαγωνιζόμε νων μεταπτυχιακών ομάδων από όλες τις κατηγορίες βρέθηκε ανάμεσα στους 10 καλύτερους του διαγωνι σμού. Επίσης βρέθηκε υποψήφια για 6 ειδικά βραβεία που αφορούσαν το σχεδιασμό και την ανάπτυξη καινο τόμων μεθόδων κλωνοποίησης DNA αλληλουχιών, τη μοντελοποίηση βιολογικών συστημάτων, την ανάπτυξη και υλοποίηση πρωτότυπων αναλυτικών μεθόδων και την επιχειρηματική ανάλυση του project. Τέλος, στην κατηγοριοποίηση των μεταλλίων η ομάδα
των περιπτώσεων καρκίνου του πνεύμονα. Πρόκειται για τον καρκίνο με τα μεγαλύτερα ποσοστά θνησιμότη τας παγκοσμίως για άνδρες και γυναίκες λόγω, μεταξύ άλλων, της μη έγκαιρης διάγνωσης. Το διαγνωστικό εργαλείο DIAS είναι ένα φθηνό και ακριβές διαγνωστι κό εργαλείο, το οποίο με την ανίχνευση ειδικών βιοδει κτών στο αίμα ασθενών θα μπορεί να πραγματοποιή σει διάγνωση στα αρχικά στάδια της νόσου. Η έγκαιρη διάγνωση μπορεί να οδηγήσει στην άμεση χειρουργική επέμβαση, ώστε να αυξηθούν τα ποσοστά επιβίωσης των ασθενών. Επιπλέον, με αυτόν τον τρόπο θα μπο ρούν να αποφευχθούν οι ενδεχόμενες μεταστάσεις. Το DIAS χρησιμοποιεί απλό μηχανισμό και δεν απαιτεί ακριβό εργαστηριακό εξοπλισμό, με αποτέλεσμα να μπορεί να χρησιμοποιηθεί με ευκολία από όλα τα δι αγνωστικά κέντρα. Βασίζεται σε μια συσκευή η οποία συνοδεύεται από μια μικροπλακέτα (microfluidic chip), στην οποία εισάγεται το δείγμα αίματος, αφού υποστεί κατάλληλη επεξεργασία. Στο εσωτερικό της συσκευής το προ- επεξεργασμένο δείγμα αίματος αναμιγνύεται με τα κατάλληλα αντιδραστήρια φανερώνοντας τελι κά ένα διαγνωστικό σκορ με την πιθανότητα ύπαρξης καρκίνου. Η συγκεκριμένη μικροπλακέτα μπορεί να κατασκευαστεί με τεχνικές τρισδιάστατης εκτύπωσης (3D-printing), διευκολύνοντας μελλοντικά την ευρεία παραγωγή τους από τις βιομηχανίες.
84 |
σό
ΟΜ Α ΔΑ
έλαβε χρυ
μετάλλιο. Συνολικά στο διαγωνισμό 173 ομάδες έλαβαν χρυσό μετάλλιο, 94 ομάδες έλαβαν ασημένιο μετάλλιο και 57 ομάδες έλαβαν αργυρό μετάλλιο. ΤΟ ΔΙΑΓΝΩΣΤΙΚΟ ΕΡΓΑΛΕ Ι Ο DIAS Το project της ομάδας αφορά στην ανάπτυξη του και νοτόμου διαγνωστικού εργαλείου DIAS (Diagnostic Investigation Accurate System) για τον μη μικροκυττα ρικό καρκίνο του πνεύμονα, ο οποίος αποτελεί το 84%
ΛΗ ΤΗΣ
Α ΔΑΣ
υπεύθυνο τον Ιωάννη Βιζιριανάκη, αναπληρωτή κα θηγητή Μοριακής Φαρμακολογίας & Φαρμακογονιδι Διεθνής διάκριση σε μεταπτυχιακούς φοιτητές του ΑΠΘ για ΑΝ Α ΠΤΥΞΗ ΔΙΑΓΝΩΣΤΙΚΟΥ ΕΡΓΑΛΕ Ι ΟΥ στον καρκίνο του πνεύμονα! Του Α ΡΗ ΜΠΕΡΖΟΒ Ι ΤΗ
ΤΑ Μ Ε
ΟΜ
Η ομάδα iGEM MetaThess 2022 αποτελεί μία διεπιστη μονική, φοιτητική, ερευνητική ομάδα με επιστημονικό
φαρμακοποιός και μεταπτυχιακή φοιτήτρια του τμήμα τος Ιατρικής ΑΠΘ, και Τρυγωνιάρης Δημήτριος, φυσι κός και μεταπτυχιακός φοιτητής του τμήματος Ιατρικής του ΑΠΘ.
Επιπλέον, η ομάδα απαρτίζεται και από τέσσερις συμβούλους των οποίων η βοήθεια κρίθηκε καθορι στική για την επιτυχημένη ανάπτυξη του Project DIAS. Συγκεκριμένα, τον Δαμαλά Σταμάτιο (βιολόγο και υπο ψήφιο διδάκτορα στο Wageningen UR στην Ολλανδία), ο οποίος συνέβαλε σημαντικά στον εργαστηριακό σχε διασμό του project DIAS, τον Δασκαλάκη Ελευθέριο (Software Engineer με μεταπτυχιακό στην Υπολογιστική Φυσική και στη Μηχανική Μάθηση ΑΠΘ), για την ανά πτυξη της επίσημης ιστοσελίδας της ομάδας, την Χα τζητάκη Αικατερίνη-Θεοδώρα (υποψήφια διδάκτορα στο τμήμα Φαρμακευτικής ΑΠΘ) και τη Μόνου Παρασκευή-Κυριακή (υποψήφια διδάκτορα στο τμήμα Φαρ μακευτικής ΑΠΘ). ΔΡΑ ΣΕΙΣ ΤΗΣ ΟΜ Α ΔΑΣ Εκτός από το σχεδιασμό και την εργαστηριακή υλοποί ηση του project DIAS, η ομάδα ανέλαβε τη μοντελο ποίηση του διαγνωστικού εργαλείου, τη διοργάνωση δράσεων και σεμιναρίων για την ενημέρωση του κοι νού για τον καρκίνο του πνεύμονα και τα οφέλη της συνθετικής βιολογίας, καθώς και την επικοινωνία με το κοινό μέσω της παρουσίας της ομάδας στη Διεθνή Έκθεση Θεσσαλονίκης. Επιπλέον, η ομάδα, θέλοντας να διευρύνει την εκπαίδευση των μαθητών σχετικά με τη Συνθετική Βιολογία, ήρθε σε επαφή με σχολεία της Ελλάδας και της Κύπρου, όπου εκπαίδευσε τους μα θητές στα βασικά εργαλεία της Συνθετικής Βιολογίας. Επιπλέον, η δουλειά της ομάδας παρουσιάστηκε σε ποικίλα συνέδρια, ενώ η ομάδα ήρθε σε επαφή και συ νεργάστηκε με παρόμοιες ομάδες iGEM τόσο στην Ελ λάδα όσο και στο εξωτερικό. Φυσικά, πραγματοποιή θηκαν συναντήσεις με ογκολόγους, ογκοχειρουργούς, διαγνωστικά κέντρα, καθηγητές, και φαρμακοβιομη χανίες που αξιολόγησαν το διαγνωστικό εργαλείο και συμβούλευσαν τους φοιτητές για τα επόμενα βήματα ανάπτυξης του πρότζεκτ. Τέλος, για την επιτυχημένη πορεία της ομάδας κα θοριστική ήταν η συμβολή των χορηγών και συγκεκρι μένα του Κέντρου Έρευνας και Γενετικής του Καρκίνου (RGCC Group) της DEMO ΑΒΕΕ, της ELPEN Pharmaceu tical A.E., της Uni-Pharma Pharmaceutical Laboratories S.A., της αλυσίδας διαγνωστικών εργαστηρίων LabNET και, τέλος, του Πανελληνίου Φαρμακευτικού Συλλόγου. Όλο το έργο και οι δραστηριότητες της ομάδας iGEM MetaThess παρουσιάζονται αναλυτικά στην επί σημη ιστοσελίδα της ομάδας: https://2022.igem.wiki/ thessaloniki-meta/ ■

| KAINOTOMIA
φοιτητής του τμήματος Ιατρικής ΑΠΘ, Γουλιού Ιωάννα, φαρμακοποιός και μεταπτυχιακή φοιτήτρια του τμήματος Ιατρικής ΑΠΘ, Κοσμίδου Μαρία, φαρμακοποιός και μεταπτυχιακή φοιτήτρια του τμήματος Οικονομικών του ΑΠΘ, Κωνσταντινίδου Μαρία, φαρμακοποιός και μεταπτυχιακή φοιτήτρια του τμήματος Φαρμακευτικής ΑΠΘ, Παπα δημητρίου Αλίκη, βιολόγος
ωματικής του Τμήματος Φαρμακευτικής του Αριστο τελείου Πανεπιστημίου Θεσσαλονίκης. Στην ομάδα συμμετέχουν επτά μεταπτυχιακοί φοιτητές του Αρι στοτελείου Πανεπιστημίου οι οποίοι αλφαβητικά είναι οι εξής: Γιαννόπουλος - Δημητρίου Αλέξανδρος, φαρμα κοποιός και μεταπτυχιακός
και υποψήφια διδάκτωρ στο τμήμα Φαρμακευτικής του ΑΠΘ, Σαΐτη Αικατερίνη,

86 |
ση, των αντιβιοτικών επιταχύνει την ανάπτυξη και εξάπλω ση βακτηρίων ανθεκτικών σε αυτά. Αντιμικροβιακή αντοχή είναι η ικανότητα ενός μικροοργανισμού να αντιστέκεται στη δράση ενός ή περισσότερων αντιμικροβιακών πα ραγόντων. Οι πιο συνηθισμένοι λόγοι για την εξάπλωση της αντιμικροβιακής αντοχής είναι η υπερβολική χρήση και η κατάχρηση αντιβιοτικών, η μετάδοση ανθεκτικών μικροοργανισμών μεταξύ ανθρώπων, μεταξύ ζώων και ανθρώπων, μεταξύ ζώων και περιβάλλοντος. Οι ερευνητές υπολόγισαν ότι η μικροβιακή αντοχή στα βακτήρια προ κάλεσε 1,27 εκατομμύρια θανάτους το 2019 και 35.000 θανάτους στην Ε.Ε. το 2021, ενώ ο Παγκόσμιος Οργανι σμός Υγείας έχει δηλώσει ότι η μικροβιακή αντίσταση είναι μία από τις 10 κορυφαίες παγκόσμιες απειλές. — Ποιες αρνητικές συνέπειες έχει στον οργανισμό μας -και κατ’ επέκταση στην αντιμετώπιση κάποιας λοίμωξης- η υπερχρήση αντιβιοτικών; Η αλόγιστη χρήση αντιβιοτικών χωρίς τη σύσταση ια τρού μοιραία θα οδηγήσει στην ανάπτυξη μικροβιακής αντίστασης. Σε περίπτωση, δε, νέας λοίμωξης, είναι δυ νατόν να μην μπορεί να αντιμετωπιστεί με τα υπάρχοντα αντιβιοτικά της κοινότητας και να χρειαστεί νοσηλεία, που μπορεί τελικά να μην επιφέρει και την ίαση. Η συνο λική λήψη αντιβιοτικών σε έναν πληθυσμό, καθώς και ο τρόπος κατανάλωσης των αντιβιοτικών έχουν αντίκτυπο στην αντοχή των βακτηρίων στα αντιβιοτικά. Επιπλέον, πρέπει να επισημανθεί ότι η πιθανή εξά πλωση ανθεκτικών οργανισμών έχει επίσης αρνητικό αντίκτυπο στην υγεία των ατόμων που δεν εκτίθενται

| 87 | ΣΥΝΕΝΤΕΥΞΗ Συνέντευξη στην ΑΝΘΗ ΑΓΓΕΛΟΠΟΥΛΟΥ ΓΙΑ ΤΟ ΣΟΒΑΡ Ο ΠΡ Ο ΒΛΗΜΑ της μικροβιακής αντοχής και της υπερχρήσης αντιβιοτικών μάς μιλά ο Ευστάθιος Σκληρός, MD, PhD, διδάκτωρ του Πανεπιστημίου Κρήτης, γενικός ιατρός, δ/ντής του Κ.Υ. Νεμέας και πρόεδρος της
Ελληνικής Εταιρείας Έρευνας και Εκπαίδευσης στην ΠΦΥ. Σύμφωνα με τον ίδιο, η σωστή ενημέρωση των ιατρών, αλλά και του κοινού θα βοηθήσει στο να γίνεται η κατάλληλη χρήση αντιβιοτικών. — Γιατρέ μου, σε τι οφείλεται η μη αποτελεσματι κότητα των αντιβιοτικών τα τελευταία χρόνια στη χώρα μας; Η εσφαλμένη χρήση, μερικές φορές πραγματική κατάχρη
ΕΥΣΤΑΘΙΟΣ ΣΚΛΗΡ ΟΣ Γενικός ιατρός, δ/ντής Κ.Υ. Νεμέας, πρόεδρος Ελληνικής Εταιρείας Έρευνας και Εκπαίδευσης στην ΠΦΥ. H ΔΙΑΤ Η ΡΗΣΗ ΤΗΣ ΑΠΟΤΕΛΕΣΜΑΤΙΚΟ ΤΗΤΑΣ ΤΩΝ ΑΝΤΙΒΙΟΤΙΚ Ω Ν Ε Ι ΝΑΙ ΕΥΘΥ ΝΗ ΟΛΩΝ!
άμεσα σε ορισμένα αντιβιοτικά. Μπροστά σε αυτό το σενάριο, υπάρχει επείγουσα ανάγκη για νέα αντιβιοτικά προκειμένου να εξασφαλιστούν αποτελεσματικές θερα πείες έναντι λοιμώξεων ανθεκτικών στα παραδοσιακά αντιβιοτικά. — Πώς ξεκίνησε η χρήση αντιβιοτικών ιστορικά; Τα αντιβιοτικά αποτελούν αναμφίβολα ορόσημο στην ιστορία της ανθρωπότητας και της σύγχρονης Ιατρι κής. Είναι ένα απαραίτητο και σωτήριο όπλο ενάντια σε πολυάριθμες μολυσματικές ασθένειες, συμπεριλαμ βανομένων αυτών που σχετίζονται με μεταμοσχεύσεις οργάνων, χημειοθεραπείες καρκίνου και εντατικές θε ραπείες. H πενικιλίνη είναι το πρώτο αντιβιοτικό που ανακαλύφθηκε το 1928 από τον Sir Alexander Fleming, o οποίος απομόνωσε κατά λάθος την ουσία από ένα μύκητα, τον Penicillium notatum. Η ανακάλυψή του όμως αναφέρθηκε για πρώτη φορά το 1929 και οι πρώτες δοκιμές στον άνθρωπο διεξήχθησαν το 1940. Τον τελευταίο αιώνα, η έρευνα δημιούργησε πολλά νέα αντιβιοτικά. Ωστόσο, από τη δεκαετία του 1990, ο αριθμός των αντιμικροβιακών παραγόντων που ανα καλύφθηκαν μειώθηκε απότομα, με ταυτόχρονη και ανησυχητική αύξηση του φαινομένου της αντοχής στα αντιβιοτικά. Ενώ ο αριθμός των λοιμώξεων που οφεί λονται σε βακτήρια ανθεκτικά στα αντιβιοτικά αυξάνε ται, ο τομέας των νέων αντιβιοτικών δεν είναι πολλά υποσχόμενος, με αποτέλεσμα οι προοπτικές για τη δια θεσιμότητα αποτελεσματικών αντιβιοτικών θεραπειών στο μέλλον να είναι δυσοίωνες. — Ποιες είναι οι συνέπειες της υπερχρήσης αντιβι οτικών στην κτηνοτροφία και στο περιβάλλον; Τα αντιβιοτικά στην κτηνοτροφία χρησιμοποιούνται: για τη θεραπεία των ασθενειών των παραγωγικών ζώων, για προφύλαξη και πρόληψη νοσημάτων και, τέλος, ως παράγοντες αύξησης του σωματικού βάρους των ζώων. Η χορήγηση των αντιβιοτικών στα παραγωγικά ζώα ως παράγοντας αύξησης του βάρους είναι μια συνήθης τακτική, που χρησιμοποιήθηκε και χρησιμο ποιείται ευρύτατα. Στην Ευρωπαϊκή Ένωση, ήδη από το 2006, απαγο ρεύτηκε η χρήση τους στην κτηνοτροφία για το σκοπό αυτόν. Υπάρχουν σήμερα ρυθμιστικά συστήματα και κανόνες για τα φαρμακούχα τρόφιμα και ζωοτροφές, που χρησιμοποιούνται κυρίως στην εντατική γεωργία, προκειμένου να αποφευχθεί η εμφάνιση λοιμώξεων. Οι πωλήσεις αντιβιοτικών για χρήση σε ζώα στην Ευρώπη μειώθηκαν κατά περισσότερο από 34% μεταξύ 2011 και 2018. Η Ελλάδα κατά την περίοδο 2015-2018 πα ρουσίασε αύξηση στις πωλήσεις των αντιμικροβιακών φαρμάκων για χρήση σε ζώα κατά 59%. Ωστόσο, από
το 2017 έως το 2018, οι πωλήσεις μειώθηκαν κατά 3%. Η μαζική ή ακατάλληλη χρήση αντιβιοτικών σε ζώα έχει ως αποτέλεσμα την εμφάνιση ανθεκτικών στα φάρ μακα μικροοργανισμών και τη διασπορά τους στο πε ριβάλλον, στους ανθρώπους και σε άλλα ζώα. Πέρα από τα προβλήματα μικροβιακής αντίστασης, οι επιπτώσεις της χρήσης αντιβιοτικών στην κτηνοτρο φία για την ανθρώπινη υγεία είναι ότι τα κατάλοιπα των αντιβιοτικών στα τρόφιμα μπορεί να προκαλέσουν αλλεργικές αντιδράσεις και πεπτικά προβλήματα. Τα χορηγούμενα αντιβιοτικά στους ανθρώπους όσο και στα ζώα αποβάλλονται κατά μεγάλο ποσοστό αυ τούσιο χωρίς να μεταβολίζεται από τον οργανισμό. Τα λύματα, επομένως, αστικά και κτηνοτροφικά, προκαλούν επιβάρυνση του περιβάλλοντος με αντιβιοτικά και μεγά λα προβλήματα δημόσιας υγείας, όταν μπαίνουν στον κύκλο νερού και τροφής, ενισχύοντας το φαινόμενο της μικροβιακής αντίστασης. — Σε πολλά συνέδρια έχουμε ακούσει κατά καιρούς ότι δεν έχουμε νέα αντιβιοτικά. Τι σημαίνει ακριβώς αυτό; Όπως είπαμε, ο τομέας έρευνας των νέων αντιβιοτικών δεν είναι πολλά υποσχόμενος, με αποτέλεσμα οι προοπτι κές για την ανακάλυψη νέων αποτελεσματικών μορίων στο μέλλον να είναι δυσοίωνες. Πολλά από τα μόρια που επιλέγονται στο εργαστήριο καταλήγουν γρήγορα να αναπτύσσουν αντίσταση στα παθογόνα που εξετάζονται. Από την άλλη μεριά, ορισμένα μόρια που ανακαλύφθη καν πρόσφατα, δραστικά έναντι των πολυανθεκτικών βακτηρίων, δεν είναι ασφαλή και μπορούν κατά συνέπεια να προκαλέσουν σημαντικές παρενέργειες. Μάλιστα, η απόδοση της επένδυσης για τα αντι βιοτικά που κυκλοφορούν στην αγορά τις τελευταίες δεκαετίες ήταν μάλλον αρνητική με χρηματοοικονομι κούς όρους, γεγονός που κάνει το πεδίο αυτό έρευνας μη ελκυστικό για τις φαρμακευτικές εταιρείες. Ευτυχώς όμως η έρευνα που περιλαμβάνει δημόσιες επενδύσεις με στόχο την ανάπτυξη νέων αντιβιοτικών έχει αυξηθεί τα τελευταία χρόνια και αναμένεται να αποδώσει. Μέσα στην επόμενη πενταετία αναμένεται να κυκλοφορήσουν 11 καινούργια μόρια αντιμικροβιακών. — Πώς μπορεί να εκπαιδευτεί το κοινό, αλλά και οι επαγγελματίες υγείας έτσι ώστε να μειώσουμε τη χρήση των αντιβιοτικών; Παλαιότερες έρευνες υπογράμμισαν την άγνοια ως βασικό μοχλό της ακατάλληλης χρήσης αντιβιοτικών στην Ελλάδα και συνέστησαν την ενημέρωση των για τρών και του κοινού ως απάντηση. Άρα η ενημέρωση και η ευαισθητοποίηση κοινού και ιατρικού κόσμου εί ναι πρωτεύων στόχος και, κατά τη γνώμη μου, έχουν
88 |
γίνει μεγάλα βήματα προς την κατεύθυνση αυτή με τη συνεισφορά του κράτους, των Μέσων Μαζικής Ενημέ ρωσης, των επιστημονικών εταιρειών και του ιατρικού κόσμου γενικότερα. Το κοινό θα πρέπει να καταλάβει ότι αποτελεί ατομική και συλλογική ευθύνη όλων μας η αντιμετώπιση της αντιμικροβιακής αντοχής και να του ενισχυθεί η εμπιστοσύνη στα ιδρύματα υγειονομικής




περίθαλψης και στους ιατρούς. Οι ιατροί, από την άλλη πλευρά, θα πρέπει να ακο λουθούν τις κατευθυντήριες οδηγίες και να ενημερώνο νται για τις τελευταίες εξελίξεις μέσω προγραμμάτων συνεχιζόμενης εκπαίδευσης και να εκπαιδευτούν στην επικοινωνία με τους ασθενείς, βελτιώνοντας τη σχέση ιατρού - ασθενούς. ■

| 89 | ΣΥΝΕΝΤΕΥΞΗ
ΕΥΣΤΑΘΙΟΣ ΣΚΛΗΡ ΟΣ Ο Ευστάθιος Σκληρός είναι γενικός ιατρός, δ/ντής του Κ.Υ. Νεμέας από 22ετίας. Είναι απόφοιτος και διδά κτωρ του Πανεπιστημίου Κρήτης, πρόεδρος της Ελληνικής Εταιρείας Έρευνας και Εκπαίδευσης στην ΠΦΥ και γενικός γραμματέας του Ελληνικού Κολεγίου Γενικής Ιατρικής. Έχει διατελέσει μέλος του Δ.Σ. της Ελληνικής Εταιρείας Γενικής Ιατρικής. Έχει αποτελέσει και αποτελεί μέλος της εξεταστικής επιτροπής της ειδικότητας της Γενικής Ιατρικής (2020-2023). Το 2017 αποτέλεσε έμμισθος σύμβουλος της Παγκόσμιας Οργάνωσης Υγείας (WHO) για την εκπαίδευση στη Γενική Ιατρική. Έχει παρακολουθήσει σημαντικό αριθμό συνεδρίων, στρογγυλών τραπεζιών, μετεκπαιδευτικών σεμιναρίων στο πλαίσιο συνεχούς επιμόρφωσης, ενώ έχει αποτελέσει μέλος διεθνών και ελληνικών οργανωτικών και επιστημονικών επιτροπών σεμιναρίων/συνεδρίων και έχει μετεκπαιδευθεί στη Λοιμωξιολογία και στον σακχαρώδη διαβήτη. Έχει συμμετοχή σαν εισηγητής ή/και συντονιστής σε περισσότερες από 150 εκπαιδευτικές δραστηριό τητες. Συμμετείχε ως εκπαιδευτής σε μεταπτυχιακά προγράμματα σπουδών του ΕΚΠΑ και σε μεταπτυχιακό πρόγραμμα σπουδών του Πανεπιστημίου Θεσσαλίας. Έχει συγγράψει 3 επιστημονικά συγγράμματα που αναφέρονται στην ΠΦΥ (αντιμετώπιση συνήθων παθήσεων στην ΠΦΥ), ενώ έχει δημοσιεύσει περισσότερες από 60 ερευνητικές εργασίες σε ελληνικά περιοδικά και 35 μελέτες σε διεθνή περιοδικά και έχει περισσότερα από 900 citation, ενώ έχει βραβευθεί 8 φορές για το ερευνητικό έργο του. Οι άνθρωποι χρειάζεται ορισµένες φορές να πάρουν αντιβιοτικά για την αντιµετώπιση λοιµώξεων Τα βακτήρια όµως, ως φυσική αντίδραση, προσαρµόζονται και αναπτύσσουν αντοχή στα αντιβιοτικά. Τα ανθεκτικά αυτά βακτήρια µπορούν στη συνέχεια να µεταδοθούν και σε άλλους. Οι άνθρωποι που λαµβάνουν αντιβιοτικά σε νοσοκοµεία είναι ενίοτε φορείς ανθεκτικών βακτηρίων. Αυτά µπορούν να µεταδοθούν σε άλλους ασθενείς λόγω κακής υγιεινής των χεριών ή µολυσµένων αντικειµένων, ή και σε άλλους ανθρώπους όταν οι ασθενείς που είναι φορείς επιστρέψουν σπίτι Πώς εξαπλώνεται η αντοχή στα αντιβιοτικά; Αντοχή στα αντιβιοτικά είναι η ικανότητα των βακτηρίων να αντιστέκονται στη δράση ενός ή πολλών αντιβιοτικών. Αντοχή στα αντιβιοτικά δεν αναπτύσσουν οι άνθρωποι και τα ζώα, αλλά τα βακτήρια που µεταφέρουν οι άνθρωποι και τα ζώα. Οι ταξιδιώτες που έχουν νοσηλευθεί σε χώρες µε υψηλά επίπεδα αντοχής των µικροβίων στα αντιβιοτικά είναι πιθανοί φορείς ανθεκτικών βακτηρίων όταν επιστρέφουν Ακόµη και εάν δεν νοσηλευθούν, οι ταξιδιώτες είναι πιθανοί φορείς λόγω επαφής µε ανθεκτικά βακτήρια µέσω της τροφής ή του περιβάλλοντος. Σεχώρους υγειονοµικής περ ίθ α λ ψ ςη Στην κοινότητα Στην κτηνοτροφία Τα ζώα που λαµβάνουν θεραπεία µε αντιβιοτικά µπορούν να µεταφέρουν ανθεκτικά βακτήρια. Τα φυτά µπορούν να µολυνθούν µε ανθεκτικά βακτήρια µέσω της κοπριάς που χρησιµοποιείται ως λίπασµα. Οι άνθρωποι µπορούν να προσβληθούν από ανθεκτικά βακτήρια µέσω των τροφίµων και της άµεσης επαφής µε τα ζώα. Κατά τηνεπιστροφήαπό τ α ξ ί δ αι
σβολή στην Ουκρανία, αλλά και γενικότερα η επικαι ρότητα φαίνεται ότι έχουν αρνητική επίδραση στην ερωτική επιθυμία, με αποτέλεσμα ένα 37% των νέων
ανδρών στη χώρα μας, ηλικίας 18-25 ετών, να δηλώ νει ότι απέχει εβδομαδιαίως από τη σεξουαλική πρά ξη, ενώ στους μεγαλύτερους τα πράγματα δείχνουν σημαντικά καλύτερα, με τους άνδρες 50-70 ετών να απέχουν σε ποσοστό μόλις 15%! Τα ποσοστά αυτά προ έρχονται από πρόσφατη έρευνα του Ανδρολογικού Ιν στιτούτου και αφορούν δείγμα 2.000 ανδρών

90 | ΑΝ ΚΑΙ ΖΟΥ ΜΕ ΣΕ ΜΙΑ ΑΠ Ο ΤΙΣ ΠΙΟ ΣΕΞΟΥΑΛΙΚ Α απελευθερωμένες περιόδους της ανθρώπινης ιστορί ας, είναι γεγονός η κατακόρυφη πτώση των ερωτικών επαφών στις δυτικές κοινωνίες, ιδιαίτερα στους νέους άνδρες. Τι συμβαίνει; Οικονομική κρίση,
πανδημία, κίνημα #metoo, ει
δεκαετίες δείχνουν την πτω τική πορεία της σεξουαλικής ζωής των νέων αντρών. ΑΝΔΡΟΛΟΓΙΚΟ ΙΝΣΤΙΤΟΥ ΤΟ Γιατί μειώνεται η ερωτική επιθυμία στις δυτικές κοινωνίες; Του Α ΡΗ ΜΠΕΡΖΟΒ Ι ΤΗ ΕΡΕΥΝΑ
και σε σύγκριση με περασμένες
Το πρόβλημα όμως φαίνεται να αφορά γενικότερα τις δυτικές κοινωνίες, καθώς σχεδόν 1 στους 3 άνδρες ηλικίας 18 έως 24 ετών αναφέρει μηδενική σεξουαλική

δραστηριότητα κατά το προηγούμενο έτος, σύμφω να με πρόσφατη μελέτη που δημοσιεύτηκε στο JAMA Network Open. Μεταξύ των ετών 2000-2002 και 2016-2018, η σε ξουαλική αδράνεια κατά το τελευταίο έτος αυξήθηκε
από 19% σχεδόν στο 31% στους άνδρες από 18 έως 24 ετών, σύμφωνα με την ερευνητική ομάδα του Δρος Pete Ueda, μεταδιδακτορικού ερευνητή στο Ινστιτούτο Karolinska της Στοκχόλμης. Για τις γυναίκες ίδιας ηλικί ας, η σεξουαλική αδράνεια έμεινε σε γενικές γραμμές σταθερή, παρουσιάζοντας μικρή αύξηση από 15% σε 19% κατά την ίδια χρονική περίοδο. Οι άγαμοι, άνεργοι και χαμηλού εισοδήματος άν δρες φάνηκε ότι ήταν πιο πιθανό να μην έχουν κάνει σεξ τους τελευταίους 12 μήνες σε σχέση με τους έγ γαμους, εργαζόμενους και υψηλότερου εισοδήματος. «Η πρόσβαση στις νέες τεχνολογίες κατά τα τε λευταία 40 χρόνια, είτε αυτές είναι τα αντισυλληπτικά χάπια είτε οι εφαρμογές όπως το Tinder και το Grindr, έχει ανοίξει νέες προοπτικές και δυνατότητες. Καθώς η σεξουαλική επανάσταση της δεκαετίας του 1970 ωρί μασε, οι κοινωνικές συμβάσεις άλλαξαν, οδηγώντας στην αυξημένη αποδοχή της ομοφυλοφιλίας, των δι αζυγίων, του προγαμιαίου σεξ και των εναλλακτικών μορφών ερωτικών σχέσεων όπως ο πολυερωτισμός
και η ανταλλαγή συντρόφων. Οι άνθρωποι κάνουν λιγότερο σεξ και η μείωση
αυτή είναι περισσότερο ορατή μεταξύ των νεότερων και κυρίως των ανδρών. Η τάση αυτή φαίνεται να σχετίζεται περισσότερο με το Διαδίκτυο και τις εφαρμογές γνωριμιών, παρά με την ηθική, το φόβο εγκυμοσύνης ή την εύκολη πρό σβαση στην πορνογραφία», επισημαίνει ο χειρουργός ουρολόγος-ανδρολόγος και πρόεδρος του Ανδρολο γικού Ινστιτούτου δρ Κωνσταντίνος Κωνσταντινίδης. «Φαίνεται ότι στις ΗΠΑ αλλά και αλλού στον δυτικό κόσμο είναι δυσκολότερο για ένα τμήμα του πληθυ σμού να καθιερώσει τον εαυτό του μέσα στην κοινω νία, στην αγορά εργασίας και ίσως και στην ερωτική “αγορά”», αναφέρει ο Ueda στο Healthline. Η μελέτη επίσης ανέδειξε ότι ακόμα και όσοι είχαν σεξουαλικές επαφές, είχαν σπανιότερα από ό,τι παλιά. «Αν και η μέση σεξουαλική συχνότητα των σεξου αλικά δραστήριων μπορεί να αντικατοπτρίζει τις προ τεραιότητες και τις προτιμήσεις τους, η σεξουαλική
αδράνεια μπορεί να μας δείχνει την απουσία ερωτι κών σχέσεων με πολύ διαφορετικές και ουσιαστικές συνέπειες για τα άτομα και την κοινωνία», συνεχίζει ο Ueda.
Τα αποτελέσματα αντλήθηκαν από τις απαντήσεις 4.291 ανδρών και 5.213 γυναικών που έλαβαν μέρος στην έρευνα «U.S. General Social Survey» μεταξύ των ετών 2000 και 2018. ΠΑΡΑ ΓΟΝΤΑΣ Η ΚΑΘΥΣΤΕΡΗΜ Ε ΝΗ ΕΝΗΛΙΚ Ι ΩΣΗ Σε σχολιασμό που συνόδευε τα αποτελέσματα της έρευνας, η Jean M. Twenge, PhD, καθηγήτρια Ψυχο λογίας στο Πανεπιστήμιο San Diego State University, ανέφερε ότι παρόμοιες τάσεις έχουν ανιχνευθεί σε έρευνες που έχουν γίνει στη Μεγάλη Βρετανία, δείχνο ντας ότι το φαινόμενο δεν συναντάται μόνο στις ΗΠΑ. Η Twenge λέει πως το ότι οι νέοι κάνουν λιγότερο σεξ μπορεί να δείχνει ότι χρειάζονται περισσότερο χρόνο πλέον για να περάσουν στην ενηλικίωση. «Αυτό περιλαμβάνει την αναβολή όχι μόνο της σε ξουαλικής δραστηριότητας, αλλά και του φλερτ, της συγκατοίκησης, της εγκυμοσύνης και του τοκετού. Παρ’ όλα αυτά, αυτές οι αναπαραγωγικές τάσεις δεν συμ βαίνουν απομονωμένα, καθώς αποτελούν τμήμα μιας ευρύτερης πολιτισμικής τάσης προς την καθυστερημέ νη ανάπτυξη. Για παράδειγμα, οι έφηβοι στη δεκαετία του 2010 ήταν επίσης λιγότερο πιθανό να οδηγούν, να πίνουν αλκοόλ, να βγαίνουν χωρίς τους γονείς τους και να δουλεύουν σε σχέση με τους εφήβους περασμένων δεκαετιών», σημειώνει η Twenge. «Δεν είναι μόνο οι νέοι άνδρες που κάνουν λιγό τερο σεξ, αλλά και οι νέες γυναίκες σε σχέση με την προηγούμενη γενιά», λέει ο Jeffrey Jensen Arnett, PhD,
O δρ Κωνσταντίνος Κωνσταντινίδης, χειρουργός ουρολόγος-ανδρολόγος, πρόεδρος του Ανδρολογικού Ινστιτούτου.
| 91 | ΕΡΕΥΝΑ
ερευνητής καθηγητής στο Clark University της Μασα χουσέτης και εισηγητής της θεωρίας της «αναδυό μενης ενηλικίωσης» (emerging adulthood) - η οποία ορίζεται από το τέλος της εφηβείας μέχρι την έναρξη ανάληψης ενήλικων υποχρεώσεων, όπως σταθερή ερ γασία, γάμος και τεκνογονία. «Το φαινόμενο αποτελεί συνέχεια μιας γενικότερης τάσης προς λιγότερο ριψοκίνδυνες συμπεριφορές, ήδη από τη δεκαετία του 1990, και περιλαμβάνει όχι μόνο το σεξ, αλλά και την κατανάλωση αλκοόλ, την επικίνδυνη οδήγηση και την εγκληματική δραστηριό τητα», επισημαίνει ο Dr. Arnett. ΨΗΦΙΑΚΟ Ι ΠΕΡΙΣΠΑΣΜΟ Ι Η Twenge προσθέτει ότι το πορνό μάλλον δεν είναι το πρόβλημα, καθώς η βιβλιογραφία δείχνει πως οι «κα ταναλωτές» πορνό είναι για την ακρίβεια περισσότερο σεξουαλικά ενεργοί. Είναι πιθανότερο οι ατελείωτες επιλογές διασκέδα σης που προσφέρονται από το Διαδίκτυο και γενικά τα ψηφιακά μέσα να αποσπούν τους νέους από τη δημι ουργία αληθινών σχέσεων. «Αν και οι ιστοσελίδες και τα social media υποτί θεται έπρεπε να κάνουν ευκολότερη την εύρεση σε ξουαλικών συντρόφων, είναι αλήθεια πως ο χρόνος που σπαταλιέται online έχει πάρει τη θέση του χρόνου που αφιερωνόταν στη διαπροσωπική αλληλεπίδραση», σημειώνει η Twenge. «Μεταξύ της 24ωρης διαθεσιμό τητας της διασκέδασης και του πειρασμού των social media, η σεξουαλική δραστηριότητα μπορεί πλέον να μην είναι τόσο ελκυστική όσο ήταν κάποτε. Για να το πούμε απλά, τώρα υπάρχουν αναρίθμητες επιλογές για να περάσει κανείς το βράδυ του και λιγότερες ευ καιρίες για την έναρξη σεξουαλικής δραστηριότητας, αν και οι δύο σύντροφοι είναι κολλημένοι στα social
media, τα video games ή την παρακολούθηση
92 |
παρατηρείται εδώ και δεκαετίες οφείλε ται στην αποχή από το σεξ και πως το κίνημα #metoo έχει παίξει κι αυτό το ρόλο του. «Οι γυναίκες πλέον είναι πιο δυναμικές, πιο σίγου ρες και στο ναι και στο όχι τους και δεν ανέχονται το εξαναγκασμένο σεξ», λέει η Pierce και καταλήγει ότι >5 επαφές 3–4 επαφές 1–2 επαφές 0 επαφές >5 επαφές 3–4 επαφές 1–2 επαφές 0 επαφές 15% 32% 36% 57% 33% 44% 41% 52% 17% 37% 33% 22% 8% 0 10 20 30 40 50 60 Επικαιρότητα Πόλεµος στην Ουκρανία Κίνηµα #metoo Πανδηµία Οικονοµική κατάσταση >5 επαφές 3–4 επαφές 1–2 επαφές 0 επαφές 15% 32% 36% 57% 33% 44% 41% 52% 17% 22% 8% 0 10 20 30 40 50 60 Επικαιρότητα Πόλεµος στην Ουκρανία Κίνηµα #metoo Πανδηµία Οικονοµική κατάσταση Εβδομαδιαία συχνότητα σεξουαλικών επαφών (Σεπτέμβριος - Οκτώβριος 2022) Δείγμα 1.000 ανδρών ηλικίας 50-70 ετών Δείγμα 1.000 ανδρών ηλικίας 18-25 ετών Τι επηρεάζει αρνητικά την ερωτική σας διάθεση; (Σεπτέμβριος - Οκτώβριος 2022) Δείγμα 2.000 ανδρών ΠΗΓ Η Ανδρολογικό Ινστιτούτο. ΠΗΓ Η Ανδρολογικό Ινστιτούτο.
σειρών». Η Nancy Sutton Pierce, κλινική σεξολόγος, αναφέ ρει ότι η πτώση στα επίπεδα της τεστοστερόνης των ανδρών που
στα θετικά αυτής της μειωμένης σεξουαλικής δραστη ριότητας συγκαταλέγονται οι λιγότερες ανεπιθύμητες εγκυμοσύνες και η μείωση των σεξουαλικά μεταδιδό μενων νοσημάτων. Η COVID-19 ΔΕΝ ΒΟΗΘΑ ΕΙ ΙΔΙΑ Ι ΤΕΡΑ Οι καραντίνες και οι φυσικές αποστάσεις που αναγκα στικά υιοθετήθηκαν λόγω της πανδημίας είναι πολύ πιθανό να κάνουν τη σεξουαλική απραξία ακόμα συ χνότερη, έστω και βραχυχρόνια. Σύμφωνα με τον Ueda, «αν η σεξουαλική αδράνεια εν μέρει τροφοδοτείται από την ανεργία και το χαμηλό εισόδημα, είναι βέβαιο ότι η παρούσα οικονομική κρί ση θα την επιδεινώσει ακόμα περαιτέρω». «Ο εγκλεισμός και η ανησυχία για τη μετάδοση της ασθένειας δεν αποτελούν ιδανικές συνθήκες για την εύρεση σεξουαλικών συντρόφων. Νομίζω ολόκληρος ο κόσμος είναι λιγότερο σεξουαλικός λόγω της πανδη μίας», καταλήγει η Pierce. Η ΕΥΕΞ Ι Α ΣΕ Κ Ι ΝΔΥΝΟ Τα ευρήματα μπορεί να έχουν διαστάσεις πέρα από τη σεξουαλικότητα καθαυτή. «Η ερώτηση-κλειδί είναι σε ποιο βαθμό η σεξουα
απραξία
για κάποιους άλλους να αποτελεί πηγή μεγάλης δυσφορίας», λέει ο Ueda. «Η σεξουαλική απραξία και η πιθανή δυσφορία που επιφέρει φαίνεται να είναι ευαίσθητα ζητήματα, ίσως πιο ευαίσθητα και από το ίδιο το σεξ. Εχει γίνει πολλή δουλειά για την προώθηση ειλικρινούς και ανοιχτής επικοινωνίας γύρω από το σεξ, ίσως θα πρέπει να γίνει κάτι παρόμοιο και για την έλλειψη σεξ. Πρέπει να βελ τιώσουμε τον δημόσιο διάλογο γύρω από το θέμα»,
καταλήγει ο Ueda. «Οι δυτικές κοινωνίες βιώνουν μια πανδημία δι αρκείας στην ψυχική υγεία τις τελευταίες δεκαετίες, με κύριες εκφράσεις της την κλινική κατάθλιψη και τις αγχώδεις διαταραχές. Όπως γίνεται εύκολα αντιληπτό, υπάρχει ισχυρός συσχετισμός μεταξύ καταθλιπτικών συμπτωμάτων και μείωσης των σεξουαλικών επαφών. Σε μια ανασκόπη ση μελετών που έχει δημοσιευτεί στο «Journal of Sexual Medicine», οι Evan Atlantis και Thomas Sullivan του Πανε πιστημίου της Αδελαΐδας βρήκαν σημαντικές ενδείξεις ότι η κατάθλιψη οδηγεί σε σεξουαλική δυσλειτουργία και μείωση της επιθυμίας. Αυτές οι ενδείξεις, μαζί τον αδιαμφισβήτητα αυξημένο επιπολασμό των ψυχικών νοσημάτων, όπως συμπεραίνουν οι Twenge, Sherman και Wells, αποδεικνύουν ότι υπάρχει αιτιώδης συνάφεια μεταξύ της λιγότερης χαράς και της πτώσης στη σεξου αλική δραστηριότητα», τονίζει ο χειρουργός ουρολό γος-ανδρολόγος δρ Χρήστος Φλιάτουρας, επιστημονι κός διευθυντής του Ανδρολογικού Ινστιτούτου Αθηνών. Προσθέτει ότι «το 2013 η έρευνα “National Survey of Sexual Attitudes and Lifestyles” (Natsal) βρήκε ότι οι Βρετανοί μεταξύ 16 και 44 ετών έκαναν σεξ λίγο λιγότερο από 5 φορές το μήνα. Αυτό αποτελεί μείωση σε σχέση με τα αποτελέσματα προηγούμενης έρευνας που έλαβε χώρα το 2000 και βρήκε ότι οι άνδρες έκα ναν σεξ 6,2 φορές το μήνα και οι γυναίκες 6,3 φορές. Παράλληλα, το 2014 η έρευνα “Australian National Survey of Sexual Activity” έδειξε ότι οι ετεροφυλόφιλοι έκαναν σεξ κατά μέσο όρο 1,4 φορές την εβδομάδα, ενώ πριν 10 χρόνια ο μέσος όρος ήταν 1,8. Η κατάστα ση φαίνεται μάλλον σοβαρότερη στην Ιαπωνία, όπου τα τελευταία δεδομένα έδειξαν ότι το 46% των γυναι κών και το 25% των ανδρών μεταξύ 16 και 25 ετών “απεχθάνονται” τη σεξουαλική επαφή». ■

| 93
λική απραξία συνδέεται με μη ικανοποίηση. Η
αυτή μπορεί να είναι συνειδητή επιλογή για κάποιους, αλλά
(δύναμη) που εξασκεί το αίμα πάνω στα τοιχώματα των αρτηριών καθώς κυκλοφορεί. Όταν η καρδιά στέλνει το αίμα στις αρτηρίες κατά ώσεις, η πίεση αυξάνεται και μειώνεται με κάθε κτύπο της καρδιάς. Όταν η καρδιά συσπάται, αυξάνεται η πίεση μέχρι ένα μέγιστο σημείο που το λέμε συστολική πίεση (μεγάλη) και μειώνεται, όταν χα λαρώνει μέχρι ένα ελάχιστο που το λέμε διαστολική πίεση (μικρή). Μετράμε την πίεση σε χιλιοστά στήλης υδραργύρου (mmHg). ΥΠ Ε ΡΤΑΣΗ Υπέρταση ονομάζεται η αυξημένη αρτηριακή πίεση του αίματος (συστολική ≥ 140mmHg, διαστολική ≥ 85mmHg). Διαβαθμίζεται σε ήπια, μέτρια και σοβα ρή. Πρόκειται για μία πάθηση που επηρεάζει κυρίως τους ενήλικες, αλλά σε ορισμένες περιπτώσεις είναι δυνατό να διαγνωσθούν με υπέρταση ακόμη και μικρά παιδιά. Σύμφωνα με στατιστικά στοιχεία, σε παγκόσμιο επίπεδο ένας στους τρεις ενήλικες πάσχει από αυξημέ νη αρτηριακή πίεση. Στην Ελλάδα η υπέρταση αφορά περίπου στο 20% του συνολικού πληθυσμού.

94 | Η ΑΡΤΗΡΙΑΚ Η Π Ι ΕΣΗ Ε Ι ΝΑΙ Η Π Ι ΕΣΗ
Π Ω Σ ΠΡΟΚ Υ ΠΤΕΙ Η ΥΠ Ε ΡΤΑΣΗ
ως ιδιοπαθής,
δηλαδή σε: • κληρονομικούς παράγοντες • αυξημένο
βάρος • καθιστική ζωή • υπερβολική πρόσληψη αλατιού • αυξημένο άγχος Γράφει ο ΣΤ Ε ΛΙΟΣ ΚΩΝΣΤΑΝΤΙΝ Ι ΔΗΣ, καρδιολόγος, διευθυντής Β′ Καρδιολογικής Κλινικής Νοσοκομείου ΥΓΕΙΑ. Όλα όσα πρέπει να γνωρίζετε για να προλάβετε και να αντιμετωπίσετε την ΥΠ Ε ΡΤΑΣΗ !
Σε ποσοστό 90-95% των περιπτώσεων η υπέρταση χαρακτηρίζεται
οφείλεται
σωματικό
• αρτηριοσκλήρυνση Στις υπόλοιπες περιπτώσεις, η υπέρταση χαρα κτηρίζεται ως δευτεροπαθής, οφείλεται δηλαδή σε κάποια άλλη πάθηση και εμφανίζεται λόγω αυτής. Οι παθήσεις που ενοχοποιούνται για την εκδήλωση δευ τεροπαθούς υπέρτασης είναι:
• αρτηριοσκλήρυνση
• παθήσεις των νεφρών
• στένωση των νεφρικών αρτηριών
• υπνική άπνοια
• δυσλειτουργίες του θυρεοειδούς αδένα
• προεκλαμψία (κατά την εγκυμοσύνη) ΜΕ ΠΟΙΑ ΣΥΜΠΤΩ ΜΑΤΑ ΕΚΔΗΛ Ω ΝΕΤΑΙ Η υπέρταση έχει χαρακτηρισθεί και ως «ύπουλη νό σος», γιατί συνήθως δεν προκαλεί κανένα απολύτως σύμπτωμα. Ίσως ο υπερτασικός ασθενής να αναφέ ρει κάποια συμπτώματα (όπως ρινορραγία, ναυτία, κεφαλαλγία), αλλά ισχύουν κυρίως για ασθενείς με βαριάς μορφής υπέρταση. Άλλα συμπτώματα που ενδεχομένως σχετίζονται με την αύξηση της αρτηρι ακής πίεσης είναι η εύκολη κόπωση,
των ηλεκτρολυτών και έλεγχο της νεφρικής λειτουρ γίας, εξετάσεις αίματος και ούρων ως και απεικονι στικές εξετάσεις, προκειμένου να διαπιστωθεί εάν πρόκειται για πρωτοπαθή ή δευτεροπαθή υπέρταση. Συνήθως η διάγνωση γίνεται μέσω μετρήσεων της αρτηριακής πίεσης από τον ιατρό με τον ασθενή σε καθιστή θέση. Ως υπερτασικός ορίζεται κάποιος όταν η συστο λική πίεση, γνωστή και ως «μεγάλη», είναι πάνω από 140mmHg και η διαστολική, ή αλλιώς «μικρή», είναι από 85mmHg και πάνω. Γενικότερα η πίεση του αί ματος θεωρείται ιδανική, όταν η συστολική είναι 120 mmHg και η διαστολική 70mmHg.

αυξάνεται
να προκύψουν καρδιαγ γειακά νοσήματα όπως: • στεφανιαία νόσος • έμφραγμα του μυοκαρδίου • συμφορητική καρδιακή ανεπάρκεια Επιπλέον υπερδιπλασιάζει τον κίνδυνο να προκύ ψουν:
| 95
ΥΠ Ε ΡΤΑΣΗ ΚΑΙ
Ε
Η
να αντιμετωπίζεται, διότι
εξαιρετικά επιβλαβής για
ΠΙΘΑΝ
Σ ΕΠΙΠΛΟΚ Ε Σ
υπέρταση πρέπει
είναι
τον οργανισμό. Εάν δεν ρυθ μιστεί,
ο κίνδυνος
η ζάλη, το αίσθη μα παλμών. ΔΙ Α ΓΝΩΣΗ ΚΑΙ ΕΞΕΤΑ ΣΕΙΣ Η επίσκεψη στο ιατρείο περιλαμβάνει την κλινική εξέ ταση και την καταγραφή του πλήρους ιστορικού του ασθενούς, καθώς επίσης και τη διερεύνηση
παθήσεων που τυχόν υπάρχουν μέσω εργαστηριακού ελέγχου. Ο
έλεγχος περιλαμβάνει
άλλων
εργαστηριακός
μέτρηση
Πότε πρέπει να πάρω φάρμακα για την υπέρταση; Ο ιατρός θα βασίσει την απόφασή του στο ύψος της αρτηριακής πίεσης, στο αν τυχόν υπάρχουν ήδη αλλοι ώσεις στον οργανισμό από την υπέρταση και αν συνυπάρχουν άλλοι βλαπτικοί για τα αγγεία παράγοντες (παράγοντες καρδιαγγειακού κινδύνου).
Θα αισθανθώ καλύτερα παίρνοντας φάρμακα; Συνήθως ναι. Πάντως η θεραπεία στοχεύει στη μακροχρόνια προστασία από τις απώτερες επιπλοκές της πίεσης και όχι για υποκειμενική βελτίωση.
Τα διουρητικά βλάπτουν τα νεφρά; Όχι μόνο δεν βλάπτουν τα νεφρά, αλλά μειώνοντας την πίεση προστατεύουν τα νεφρά από τις συνέπειες της υπέρτασης. Είναι κακό που ορισμένα φάρμακα μειώνουν τους σφυγμούς; Αντίθετα, είναι συχνά επιθυμητό, γιατί έτσι προστατεύεται η καρδιά ακόμα περισσότερο. Η βραδυκαρδία που προκαλούν ορισμένα φάρμακα δεν είναι παρενέργεια, αλλά μέρος της θεραπευτικής τους δράσης. Εάν αρχίσω θεραπεία με φάρμακα, δεν θα μπορώ να τα σταματήσω; Αφού δεν υπάρχει οριστική ίαση, αλλά διά βίου διαρκής έλεγχος της υπέρτασης η θεραπεία μπορεί μεν, αλλά δεν πρέπει να σταματήσει. Δεν υπάρχει εθισμός στα φάρμακα, ώστε να μην μπορούν να διακοπούν. Πρέπει να διακόπτω πού και πού τη λήψη των

96 | Συνήθεις ερωτήσεις των
ασθενών
Η
δεν
και
θεραπεία μειώνει
ονέκτημα της
Τίποτα
Καλό είναι
Γιατί ο
μού αλλάζει
Ο
της θεραπείας
ακόμα και μήνες. Έτσι ο ιατρός αρχίζει με μικρή δόση φαρμάκου που προοδευτικά αυξάνεται και μπορεί να χρειαστεί να προσθέσει και δεύτερο φάρμακο. Εάν το πρώτο φάρμακο δεν φέρει κανένα αποτέλεσμα τότε ο ιατρός το αντικαθιστά με άλλο διαφορετικής κατηγορίας. Μερικές φορές μπορεί να χορηγηθεί χάπι συν δυασμού δύο ή τριών φαρμάκων. Πώς θα λύσω και τις άλλες απορίες που έχω; Ρώτησε τον ιατρό σου!
φαρμάκων για να ξεκουράζεται ο οργανισμός;
διαρκής θεραπεία
δημιουργεί κινδύνους, αντίθετα η ανεπαρκής
ατελής
το πλε
προστασίας από καρδιαγγειακές παθήσεις. Τι θα συμβεί, εάν κάποια φορά ξεχάσω το φάρμακό μου;
σοβαρό.
όμως αυτό να μη συμβαίνει συχνά.
ιατρός
θεραπεία;
σκοπός
είναι να επιτευχθεί μια τιμή στόχος της αρτηριακής πίεσης μέσα σε εβδομάδες ή
Δεν υπάρχει θεραπεία που να απαλλάσσει τον ασθενή οριστικά από την υπέρταση. Θα πρέπει να μάθει να ζει με αυτήν και να ακολουθεί πιστά τις οδηγίες του ιατρού. Εφόσον ο ιατρός το κρίνει σκόπιμο, θα συστήσει φαρμακευτική αγωγή με αντιυπερτασικά δισκία.
• ισχαιμικά και αγγειακά εγκεφαλικά επεισόδια
• ανεύρυσμα αορτής
• χρόνια νεφρική ανεπάρκεια
• βλάβες στον αμφιβληστροειδή
• εμφάνιση άνοιας
ΘΕΡΑΠΕ Ι Α Δεν υπάρχει θεραπεία που να απαλλάσσει τον ασθενή οριστικά από την υπέρταση. Θα πρέπει να μάθει να ζει με αυτήν και να ακολουθεί πιστά τις οδηγίες του ια τρού. Εφόσον ο ιατρός το κρίνει σκόπιμο, θα συστήσει φαρμακευτική αγωγή με αντιυπερτασικά δισκία. Έχουμε καταγράψει ότι λιγότεροι από τους μι σούς υπερτασικούς κάνουν σωστή θεραπεία, ενώ πολλοί από αυτούς που κατά καιρούς παίρνουν φάρ μακα για να μειώσουν την πίεσή τους δεν είναι υπερ τασικοί και δεν τα έχουν ανάγκη. Η σύγχυση αυτή που επικρατεί στην αντιμετώπιση της υπέρτασης οφείλεται σε μεγάλο βαθμό στην παραπληροφόρη ση γύρω από αυτή. Η επιλογή της αγωγής διαφέρει από ασθενή σε ασθενή, γίνεται με γνώμονα την ηλικία, τα συνοδά νο
σήματα, τη βαρύτητα της πάθησης και τυχόν αλλεργίες που έχει ο εκάστοτε ασθενής. Στην περίπτωση των ασθενών με ελαφριάς μορ φής υπέρταση, δεν δίδεται θεραπεία αλλά συνιστάται η αλλαγή του τρόπου ζωής και των διατροφικών συ νηθειών. ΥΠ Ε ΡΤΑΣΗ ΚΑΙ ΠΡ ΟΛΗΨΗ Η αλλαγή του τρόπου ζωής μπορεί να μειώσει την υψη λή αρτηριακή πίεση όσο ένα αντιυπερτασικό φάρμακο. Ο κίνδυνος να εμφανιστεί υπέρταση είναι πολύ μικρό τερος, όταν υιοθετούμε τις παρακάτω συμπεριφορές:
• Ακολουθούμε μια ισορροπημένη διατροφή, πλού σια σε φρούτα και λαχανικά.
• Διατηρούμε φυσιολογικό σωματικό βάρος.
• Ασκούμαστε τουλάχιστον δύο-τρεις φορές την εβδομάδα.
• Μειώνουμε την πρόσληψη αλατιού. • Διακόπτουμε το κάπνισμα. • Αποφεύγουμε την κατάχρηση αλκοόλ. • Περιορίζουμε την κατανάλωση τσαγιού και καφέ. • Αποβάλλουμε όσο μπορούμε το άγχος. ■
Σύνδρομα. Καρδιακή Ανεπάρκεια. Υπέρταση. ΔΙΑΚΡ
European Boards of Cardiology. Αντιπρόεδρος του Επιστημονικού Συμβουλίου ΔΘΚΑ «Υγεία». Συντονιστής Παθολογικού Τομέα ΔΘΚΑ «Υγεία».
| 97 | ΥΠΕΡΤΑΣΗ
ΣΤ Ε ΛΙΟΣ Κ Ώ ΝΣΤΑΝΤΙΝ Ι ΔΗΣ Ο Στέλιος Κωνσταντινίδης είναι καρδιολόγος, διευθυντής Β′ Καρδιολογικής Κλινικής ΥΓΕΙΑ, αντιπρόεδρος Επιστημονικού Συμβουλίου Νοσοκομείου Υγεία. ΕΚΠΑ Ι ΔΕΥΣΗ & ΑΚΑΔΗΜΑΪΚΟ Ι Τ Ι ΤΛΟΙ Πτυχιούχος της Ιατρικής Σχολής του Ελληνικού Καποδιστριακού Πανεπιστημίου Αθηνών, 1981. Τίτλος ιατρικής ειδικότητας Καρδιολογίας της Ιατρικής Σχολής Αθηνών, 1989. Πιστοποίηση εκτέλεσης υπερήχων καρδιάς (υπουργείο Υγείας). Πτυχιούχος μετά από εξετάσεις σε Μετεκπαιδευτικά Σεμινάρια της Ελληνικής Αγγειοχειρουργικής Εταιρείας. ΚΛΙΝΙΚΟ & ΕΡΕΥΝΗΤΙΚΟ ΕΝΔΙΑΦ Ε ΡΟΝ Οξέα Στεφανιαία
Ι ΣΕΙΣ

98 |
διευθύντρια της Αιματολογι κής-Λεμφωμάτων Κλινικής και ΜΜΜΟ του Νοσοκο
μείου «Ο Ευαγγελισμός» και πρόεδρος της Ελληνικής Αιματολογικής Εταιρείας, Μαρία Παγώνη. — Στο φετινό Συνέδριο φιλοξενήσατε την 3rd EHA - Balkan Hematology Day, με θέμα «Novel therapies of Lymphoma», με ένα πολύ επίκαιρο επιστημονικό πρόγραμμα σχετικά με τις εξελίξεις στη θεραπευ τική αντιμετώπιση των λεμφωμάτων. Πείτε μας τι προβλέπει το πρόγραμμα αυτό και ποιοι συμβάλ λουν; Η Ελληνική Αιματολογική Εταιρεία διαχρονικά συνερ γάζεται με τις εθνικές αιματολογικές εταιρείες των χωρών της ευρύτερης περιοχής μας, τη European Hematology Association (EHA), την American Society of Hematology (ASH) και άλλες επιστημονικές εταιρεί ες, σε μια προσπάθεια βέλτιστης αντιμετώπισης των ασθενών μας, εκπόνησης κοινών ερευνητικών δράσε ων και θεραπευτικών πρωτοκόλλων. Στο φετινό Συνέδριό μας είχαμε τη χαρά να φιλο ξενήσουμε την 3rd EHA -Balkan Hematology Day, με θέμα «Novel therapies of Lymphoma». Συμμετείχαν δι ακεκριμένοι επιστήμονες από την Ελλάδα και από Ρου μανία, Κύπρο, Βουλγαρία, Σερβία, Αλβανία, Σλοβενία, Κροατία, Τουρκία, Κόσοβο και Μολδαβία. Σημαντική

| 99 | ΣΥΝΕΝΤΕΥΞΗ ΓΙΑ ΤΗΝ ΕΠΙΤΑΚΤΙΚ Η ΑΝ Α ΓΚΗ της θεσμοθέτησης της αποζημίωσης των εργαστηριακών ελέγχων βιο δεικτών, τις θεραπευτικές εξελίξεις στον τομέα της Αιματολογίας και της Μοριακής Γενετικής, καθώς και τον σημαντικό ρόλο των CAR-Τ-λεμφοκυττάρων μάς μίλησε η αιματολόγος,
Συνέντευξη στην ΑΝΘΗ ΑΓΓΕΛΟΠΟΥΛΟΥ ΓΝΑ «Ο ΕΥΑΓΓΕΛΙΣΜ ΟΣ» ΜΑΡ Ι Α ΠΑΓΩ ΝΗ Αιματολόγος, διευθύντρια Αιματολογικής-Λεμφωμάτων Κλινική, ΜΜΜΟ, ΓΝΑ «Ο Ευαγγελισμός», πρόεδρος Ελληνικής Αιματολογικής Εταιρείας. ΤΑ ΝΕΟ ΤΕΡΑ ΦΑ ΡΜΑΚΑ ΕΠΙΜΗΚ Υ ΝΟΥΝ ΤΗ ΣΥΝΟΛΙΚ Η ΕΠΙΒ Ι ΩΣΗ ΚΑΙ ΒΕΛΤΙ Ω ΝΟΥΝ ΣΗΜΑΝΤΙΚ Α ΤΗΝ ΠΟΙ Ο ΤΗΤΑ ΖΩ Η Σ !
εξέλιξη στην αντιμετώπιση των μη Hodgkin λεμφωμά των αποτελεί η πρόσφατη ανακάλυψη των αμφι-ειδι κών αντισωμάτων, τα οποία είτε φέρνουν σε επαφή τα νεοπλασματικά κύτταρα με τα φυσιολογικά κύτταρα της άμυνας του οργανισμού ή εισάγουν χημειοθερα πευτικά μόρια στοχευμένα εντός αυτών. Επιπλέον, η χορήγηση των CAR-T λεμφοκυττάρων δίνει εντυπωσι ακά αποτελέσματα, ακόμα και ίαση, σε ένα σημαντικό ποσοστό ασθενών με επιθετικό μη Hodgkin λέμφωμα, στους οποίους είχαν αποτύχει αρκετές προηγούμενες θεραπείες. Η τάση πλέον είναι αυτή η θεραπεία να δί νεται νωρίτερα σε επιλεγμένους ασθενείς. Όσον αφορά στο λέμφωμα Hodgkin, οι νεότερες θεραπείες περιλαμβάνουν κυρίως φάρμακα-αντισώ ματα, τα οποία εμποδίζουν την απενεργοποίηση των φυσιολογικών κυττάρων της άμυνας του οργανισμού που συμβαίνει από τον όγκο, με αποτέλεσμα αυτά να στρέφονται εναντίον του λεμφώματος. Οι θεραπευ τικές εξελίξεις αποτελούν πλέον μια πρόκληση δεδο μένου ότι, εκτός των εντυπωσιακών αποτελεσμάτων, καταγράφονται και καινοφανείς τοξικότητες. Η εφαρ μογή τους προϋποθέτει Κέντρα με άρτια οργάνωση και δυνατότητα παροχής υψηλού επιπέδου ιατρικών υπηρεσιών από ομάδες ιατρών πολλών ειδικοτήτων. Ταυτόχρονα, η υψηλή αποτελεσματικότητα των θερα πειών αυτών επαναπροσδιορίζει τον αλγόριθμο αντι μετώπισης των ασθενών, γεγονός που ασκεί πίεση στα συστήματα υγείας της Ευρώπης δεδομένου του υψη λού κόστους τους. Εκτός από την ανταλλαγή επιστημονικών απόψεων, είχαμε την ευκαιρία να συζητήσουμε θέματα σχετικά με την οικοδόμηση και την ενίσχυση της συνεργασίας μεταξύ της ΕΑΕ, των εθνικών επιστημονικών εταιρει ών και της ΕΗΑ, ενώ ιδιαίτερη έμφαση δόθηκε στην προσπάθεια εναρμόνισης της εκπαίδευσης των νέων αιματολόγων στην Ευρώπη. Η συνεργασία της ΕΑΕ με την ΕΗΑ και οι προσπά θειες εναρμόνισης στην εκπαίδευση έχουν αρχίσει από το 2002-2004. Έχουμε υιοθετήσει το logbook της EHA για την εκπαίδευση των νέων αιματολόγων και προ σπαθούμε να θεσμοτεθεί από το ΚΕΣΥ, συμμετέχου με στις παράλληλες εξετάσεις, που διεξάγονται κάθε
δεδομένα αναφορικά με
τη Μοριακή Γενετική, καθώς και οι θεραπευτικές εξελί ξεις στις αιματολογικές κακοήθειες. Θα ήθελα να ανα φερθώ ιδιαίτερα στη σημαντική πρόοδο, που έχει γίνει τα τελευταία χρόνια, στην κατανόηση της βιολογίας των οξειών λευχαιμιών και των μυελοδυσπλαστικών νεοπλασμάτων, με την ταυτοποίηση γενετικών δια ταραχών, που έχουν ιδιαίτερη σημασία για την προ γνωστική ταξινόμηση και τη θεραπευτική αντιμετώπι ση των νοσημάτων αυτών. Η διακεκριμένη Ελληνίδα Έλλη Παπαεμμανουήλ, καθηγήτρια στο Μemorial Sloan Kettering Cancer Center, New York, USA, προσκεκλημέ νη μου στο φετινό Συνέδριο, στην ομιλία της με τίτλο «Unifying Disease Classification and Risk Stratification in AML: From Research to Clinical Guidelines», αναφέρ θηκε στις νεότερες εξελίξεις που αφορούν στο γενετι κό υπόβαθρο της Οξείας Μυελογενούς Λευχαιμίας και τις θεραπευτικές προεκτάσεις τους. Η συστηματική με λέτη των μοριακών βλαβών στις μυελικές κακοήθειες με τα σύγχρονα τεχνολογικά εργαλεία οδήγησε στην αναθεώρηση των προηγούμενων διαγνωστικών και προγνωστικών ταξινομήσεων. Πλέον, οι μυελικές κα κοήθειες ταξινομούνται με πιο αντικειμενικό τρόπο με βάση τις κυτταρογενετικές και μοριακές βλάβες. Η πρόοδος αυτή συνοδεύτηκε, μετά από ένα με γάλο διάστημα που διήρκεσε περισσότερο από τρεις δεκαετίες και χαρακτηρίστηκε από στασιμότητα όσον αφορά στις θεραπευτικές εξελίξεις στην οξεία λευχαι μία, από την έγκριση αρκετών νέων φαρμάκων, που έλαβαν έγκριση από τις ρυθμιστικές αρχές την τελευ ταία πενταετία. Τα νεότερα φάρμακα όχι μόνο επιμηκύνουν τη συ νολική επιβίωση, αλλά και βελτιώνουν σημαντικά την ποιότητα ζωής, ιδιαίτερα των ασθενών μεγαλύτερης ηλικίας, οι οποίοι λόγω σημαντικών συννοσηροτήτων δεν δύνανται να λάβουν επιθετική χημειοθεραπεία. Οι εξελίξεις τρέχουν και τα επόμενα χρόνια αναμένεται να τροποποιείται ο θεραπευτικός σχεδιασμός. Πλέον, θα λαμβάνεται υπόψη η βιολογική συμπεριφορά του νοσήματος από τη φάση τη διάγνωσης με στόχο την ενσωμάτωση των νεότερων παραγόντων στη θερα πεία, την επίτευξη βαθύτερων υφέσεων και τη διενέρ γεια αλλογενούς μεταμόσχευσης αιμοποιητικών κυττά ρων στις καλύτερες δυνατές συνθήκες. Στην εποχή της ιατρικής ακριβείας ένα ακόμα ερ γαλείο προστίθεται στη φαρέτρα μας. Η δυνατότητα ανίχνευσης της νόσου σε πολύ χαμηλό επίπεδο χρησι μοποιώντας ευαίσθητες μοριακές τεχνικές. Σε αυτές τις μεθόδους και το πώς ενσωματώνονται στην κλινική πρακτική αναφέρθηκε ο Michael Heuser, Professor of Medicine, Chair for Molecular Therapies in Hematology, Hannover Medical School, Hannover, Germany, στην ομιλία του με τίτλο «Clinical use of MRD in the treatment
100 |
χρόνο τον Ιούνιο στο πλαίσιο του ετήσιου συνεδρίου της ΕΗΑ, ενώ το 2021 υπεγράφη το Joint membership Memorandum μεταξύ ΕΑΕ και ΕΗΑ, που δίνει σημαντι κές ευκαιρίες και πρόσβαση στην εκπαίδευση και τις συνεργασίες στους Έλληνες αιματολόγους και ιδιαίτε ρα στους νέους. — Ποιες είναι οι εξελίξεις στον τομέα της Μοριακής Γενετικής; Είναι σημαντικά τα νεότερα
Οι θεραπευτικές εξελίξεις
αποτελούν πλέον μια πρόκληση δεδομένου ότι, εκτός των εντυπωσιακών αποτελεσμάτων, καταγράφονται και καινοφανείς τοξικότητες.
θεραπείες για τις αιματολογικές κακοήθει ες, συμπεριλαμβανομένων των εξελίξεων στην ανοσοθεραπεία με CAR-T λεμφοκύτταρα. Θα μας εξηγήσετε; Οι θεραπείες με γενετικά τροποποιημένα Τ-λεμφοκύτ ταρα (CAR-T λεμφοκύτταρα) αποτελούν εγκεκριμένες θεραπείες από τον Ευρωπαϊκό Οργανισμό Φαρμάκου
(ΕΜΑ) για τη θεραπεία αρκετών πλέον αιματολογι κών νεοπλασιών που είναι ανθεκτικές στη συμβατική θεραπεία, δηλαδή στη χημειοθεραπεία, στην ακτινο θεραπεία και τη μεταμόσχευση μυελού των οστών. Πρόκειται για θεραπείες, που βασίζονται στη χορή γηση Τ-λεμφοκυττάρων του ίδιου του ασθενούς, τα οποία, αφού πρώτα απομονωθούν από το αίμα του, στη συνέχεια επεξεργάζονται γενετικά σε ειδικά ερ γαστήρια. Η γενετική επεξεργασία των Τ-λεμφοκυττάρων αφορά την κατάλληλη τροποποίησή τους, μέσω της εισαγωγής ενός γονιδίου, ώστε να αναγνωρίζουν και να εξοντώνουν τα κύτταρα της νόσου, που δια φεύγουν της συμβατικής θεραπείας. Η συγκεκριμένη ανοσοθεραπεία βασίζεται στη μετατροπή Τ-λεμφο κυττάρων του αίματος σε ειδικά για την αναγνώριση συγκεκριμένων κυττάρων-στόχων. Η μετατροπή αυτή γίνεται με την εισαγωγή στα Τ-λεμφοκύτταρα ενός γο νιδίου ειδικού για την έκφραση χιμαιρικού υποδοχέα (chimeric antigen receptor-CAR) εναντίον συγκεκριμέ νου αντιγόνου των λευχαιμικών κυττάρων. Ο υποδοχέ ας είναι μία χιμαιρική πρωτεΐνη, που αποτελείται από τρεις τουλάχιστον διαφορετικές περιοχές, εξ ου και ο όρος χιμαιρική, ήτοι την περιοχή αναγνώρισης και σύνδεσης του αντιγόνου-στόχου και τις δύο περιοχές που είναι ειδικές για την ενεργοποίηση και τον πολλα πλασιασμό των Τ-λεμφοκυττάρων. Όταν χορηγηθούν στον ασθενή, τα CAR-Τ λεμφοκύτταρα αναγνωρίζουν το αντιγόνο-στόχο στην επιφάνεια των λευχαιμικών κυττάρων, μέσω του χιμαιρικού υποδοχέα, και συν δέονται μαζί του. Η σύνδεση αυτή είναι το σήμα για την ενεργοποίηση και τον πολλαπλασιασμό των CAR-Τ λεμφοκυττάρων, με αποτέλεσμα τη θανάτωση των λευχαιμικών κυττάρων. Τα νοσήματα για τα οποία έχει ένδειξη η ανωτέρω θεραπεία είναι η οξεία λεμφοβλαστική λευχαιμία σε παιδιά και ενήλικες, τα λεμφώματα από μεγάλα Β-κύτ ταρα, το λέμφωμα από κύτταρο του μανδύα, τα οζώδη λεμφώματα και το πολλαπλούν μυέλωμα. Η παρασκευή των CAR-Τ-λεμφοκυττάρων είναι μία πολύπλοκη διεργασία και γίνεται σε συγκεκριμένα δια πιστευμένα εργαστήρια με ειδικά διαμορφωμένους και εξοπλισμένους χώρους. Στη διαδικασία της παρασκευ ής συμμετέχει και το κέντρο θεραπείας, όπου γίνεται η λήψη-συλλογή των Τ-κυττάρων από τον ασθενή. Στη συνέχεια, τα κύτταρα στέλνονται στο διαπιστευμένο εργαστήριο, ακολουθεί η επεξεργασία και το τελικό κυτταρικό προϊόν γυρίζει πίσω στο κέντρο νοσηλείας για να χορηγηθεί στον ασθενή. Την οργάνωση και τον έλεγχο της παραγωγής των κυτταρικών προϊόντων έχει η φαρμακευτική εταιρεία, η οποία είναι αυτή που δι απιστεύει την επάρκεια των κέντρων. Προς το παρόν

| 101 | ΣΥΝΕΝΤΕΥΞΗ of AML patients». Η συνεχώς αυξανόμενη ενσωμάτωση των μεθόδων αυτών στην παρακολούθηση των ασθε νών συμβάλλει στην αναγνώριση της επαπειλούμενης υποτροπής και τη λήψη θεραπευτικών αποφάσεων, όταν το φορτίο νόσου είναι χαμηλό. — Έχουμε όμως νεότερα και όσον αφορά στις νε ότερες
στην Ελλάδα, διαπιστευμένα για τη θεραπεία με CAR-Τ λεμφοκύτταρα είναι τα νοσοκομεία ενηλίκων, ΓΝΑ «Ο Ευαγγελισμός», ΓΝΘ «Γ. Παπανικολάου», ΓΝΑ ΛΑΪΚΟ, ΓΝΑ ΑΤΤΙΚΟΝ, ΠΓΠ ΡΙΟ, ΠΑΓΝΗ και ένα παιδιατρικό, η Ογκολογική Μονάδα Παίδων «Μαριάννα Β. Βαρδινο γιάννη-ΕΛΠΙΔΑ», Γ.Ν. Παίδων «Η Αγία Σοφία». Η χορήγηση των θεραπειών αυτών γίνεται υπό στενή παρακολούθηση και συγκεκριμένες συνθήκες, που πληρούνται μόνο από τις αδειοδοτημένες μονά δες μεταμόσχευσης αρχέγονων αιμοποιητικών κυττά ρων. Παράλληλα, πρέπει να υπάρχει κάλυψη από τη Μονάδα Εντατικής Θεραπείας, για την αντιμετώπιση των άμεσων επιπλοκών από τη θεραπεία που μπορεί να εμφανιστούν στους ασθενείς αυτούς, όπως το σύν δρομο απελευθέρωσης κυτταροκινών και οι νευρολο γικές επιπλοκές. Η εφαρμογή προηγμένων κυτταρικών θεραπειών, όπως είναι τα CAR-T-λεμφοκύτταρα, σηματοδοτεί την αρχή μιας καινούργιας εποχής στη θεραπεία του καρ κίνου, την εποχή της εξατομικευμένης θεραπείας. Στο εγγύς μέλλον αναμένεται σχεδίαση και παρασκευή νέων χιμαιρικών υποδοχέων με στόχο την αντιμετώπι ση και άλλων μορφών καρκίνου χρησιμοποιώντας την CAR-T τεχνολογία. Στη διάρκεια του 33ου Πανελλήνιου Αιματολογικού Συνεδρίου, που διεξήχθη με μεγάλη επιτυχία από 9 έως 12 Νοεμβρίου στη Θεσσαλονίκη, παρουσιάστηκε για πρώτη φορά η παρασκευή CAR-T κυττάρων στην Ελλάδα. Συγκεκριμένα, στο Κέντρο Κυτταρικής και Γο νιδιακής Θεραπείας της Ογκολογικής Μονάδας Παί δων «Μαριάννα Β. Βαρδινογιάννη» παρασκευάσθη καν CAR-T κύτταρα από τρεις υγιείς δότες, στο πλαίσιο κλινικής μελέτης για ασθενείς, παιδιά και ενήλικες, με υποτροπή Οξείας Λεμφοβλαστικής Λευχαιμίας μετά από μεταμόσχευση αιμοποιητικών κυττάρων. Τα απο τελέσματα της κλινικής μελέτης, που αναμένονται σε τρία χρόνια, θα ανοίξουν το δρόμο για την ευρεία χρησιμοποίηση τέτοιων προηγμένων θεραπειών πα ρασκευασμένων σε τριτοβάθμιες δομές του ΕΣΥ. — Στην τελευταία συνέντευξη Τύπου αναφερθήκατε στην επιτακτική ανάγκη να θεσμοθετηθεί η απο ζημίωση του εργαστηριακού ελέγχου βιοδεικτών. Ποιος είναι ο λόγος; Είμαστε στην εποχή της Ιατρικής Ακριβείας και των θεραπειών στόχευσης. Σε μια εποχή που η ακριβής διάγνωση, η πρόγνωση, ο θεραπευτικός σχεδιασμός και η παρακολούθηση για πολλά αιματολογικά νοσή ματα βασίζονται στην ανίχνευση μοριακών δεικτών. Ο εργαστηριακός έλεγχος των δεικτών τόσο στη διά γνωση όσο και στην παρακολούθηση είναι αναγκαίος, προκειμένου να τύχουν οι ασθενείς της ενδεδειγμένης
θεραπείας, και συμπεριλαμβάνεται στις κατευθυντή ριες οδηγίες των επιστημονικών μας φορέων, όπως ELN (European Leukemia Net) και NCCN (National Comprehensive Cancer Network). Από το 2014 δεν έχει γίνει επικαιροποίηση του κα ταλόγου των αποζημιούμενων βιοδεικτών για τα αι ματολογικά νεοπλάσματα. Έτσι, οι περισσότεροι από τους βιοδείκτες, που είναι απαραίτητοι για τη διερεύ νηση, τη θεραπεία και την παρακολούθηση των ασθε νών με αιματολογικά κακοήθη νοσήματα, σύμφωνα με την τρέχουσα επιστημονική γνώση δεν αποζημιώ νονται από τα ασφαλιστικά ταμεία και οι ασθενείς κα λούνται να καλύψουν το κόστος, που για ορισμένους είναι πραγματικά δυσβάστακτο. Επιπλέον, σήμερα με τη μέθοδο της αλληλούχισης επόμενης γενιάς (Next Generation Sequencing, NGS), υπάρχει η δυνατότητα της παράλληλης διερεύνησης πολλών γονιδίων και «hot spots» και της ταυτόχρο νης ανίχνευσης μεταλλάξεων σε αυτά. Η αναζήτηση πολλαπλών μεταλλάξεων σε ένα έκαστο αιματολογι κό νόσημα με σκοπό την αντιμετώπιση του ασθενούς σύμφωνα με τις αρχές της Ιατρικής Ακριβείας καθιστά αναγκαία την αποζημίωσή τους από τους ασφαλιστι κούς φορείς. Με την τεχνολογία NGS υπάρχει η δυνατότητα κα θορισμού μοριακών θεραπευτικών στόχων που οδη γούν σε εξατομικευμένη θεραπεία. Αυτό, εκτός από ωφέλεια για τον ίδιο τον ασθενή, αναμένεται να συμ βάλει στην εξοικονόμηση πόρων για το ασφαλιστικό σύστημα. Στην Ελληνική Αιματολογική Εταιρεία έχουμε καταγράψει όλους τους βιοδείκτες, που είναι απαραί τητοι για τη διερεύνηση, τη θεραπεία και την παρα κολούθηση των ασθενών με αιματολογικά κακοήθη νοσήματα, σύμφωνα με την τρέχουσα επιστημονική γνώση. — Επίσης μιλήσατε για αύξηση των κλινών μεταμό σχευσης αρχέγονων αιμοποιητικών κυττάρων και κυτταρικών θεραπειών. Παρά τη σημαντική πρόοδο και τις καινοτόμες θερα πείες για πολλά αιματολογικά νοσήματα, η αλλογενής μεταμόσχευση αιμοποιητικών κυττάρων παραμένει μο ναδική θεραπευτική επιλογή που μπορεί να προσφέρει την προοπτική της ίασης για το μεγαλύτερο ποσοστό των ασθενών με οξεία λευχαιμία, αλλά και άλλα κακο ήθη ή μη αιματολογικά νοσήματα. Αυτό είναι εφικτό για το 40-60% των επιλέξιμων ασθενών με ένδειξη να υποβληθούν σε μεταμόσχευση. Σύμφωνα με τα στοι χεία που δημοσιεύτηκαν από τον European Association for Blood and Marrow Transplantation το 2021, τόσο οι αλλογενείς όσο και οι αυτόλογες μεταμοσχεύσεις αι μοποιητικών κυττάρων διπλασιάστηκαν σε αριθμό την
102 |
τελευταία δεκαετία σε πανευρωπαϊκό επίπεδο. Αυτό ως εξέλιξη ήταν αναμενόμενο δεδομένου ότι τόσο οι θεραπείες επαγωγής ύφεσης όσο και η μεταμόσχευση αυτή καθαυτή βελτιώθηκαν σε τέτοιο βαθμό που εκ των πραγμάτων οι ανάγκες αυξήθηκαν σημαντικά. Εν δεικτικά, ασθενείς έως και 75 ετών, εφόσον δεν έχουν σοβαρά προβλήματα υγείας, μπορούν με ασφάλεια να υποβληθούν σε αλλογενή μεταμόσχευση. Στην Ελ λάδα πραγματοποιούνται σε ετήσια βάση πάνω από 200 αλλογενείς μεταμοσχεύσεις. Όμως, σύμφωνα με τις ανάγκες των ασθενών μας και τα δεδομένα από τις υπόλοιπες ευρωπαϊκές χώρες με ανεπτυγμένα συστή
ματα υγείας, απαιτείται αύξηση της μεταμοσχευτικής δραστηριότητας τουλάχιστον κατά 50%. Από την άλλη, οι θεραπείες με γενετικά τροποποι ημένα Τ-λεμφοκύτταρα (CAR-T λεμφοκύτταρα), όπως ήδη ανέφερα, αποτελούν εγκεκριμένες θεραπείες από τον Ευρωπαϊκό Οργανισμό Φαρμάκου (ΕΜΑ) για την αντιμετώπιση αρκετών πλέον αιματολογικών νεοπλα σιών, που είναι ανθεκτικές στη συμβατική θεραπεία. Η χορήγηση των θεραπειών αυτών γίνεται υπό στενή παρακολούθηση και συγκεκριμένες συνθήκες, που πλη ρούνται μόνο από τις αδειοδοτημένες μονάδες μετα μόσχευσης αρχέγονων αιμοποιητικών κυττάρων. Στην Ελλάδα έχει ήδη πραγματοποιηθεί θεραπεία με CAR-T λεμφοκύτταρα σε περισσότερους από 50 ασθενείς. Με τη διεύρυνση των ενδείξεων, οι ασθενείς που έχουν ανάγκη αυτών των θεραπειών θα είναι πολλαπλάσιοι στο άμεσο μέλλον. Με βάση όσα αναφέρθηκαν παραπάνω και για να
μπορέσουν όλοι οι ασθενείς μας να λάβουν την καλύ
τερη δυνατή θεραπεία για το νόσημά τους, είναι προ φανές ότι απαιτείται αύξηση των κλινών στις μονάδες μεταμόσχευσης και μάλιστα άμεσα. Παράλληλα είναι αναγκαία η αύξηση των κλινών αποθεραπείας μετά τη μεταμόσχευση, ώστε να διευκολύνεται η διακίνηση
των ασθενών. Όλα αυτά διότι είναι τουλάχιστον παράδοξο στη χώρα μας να είναι διαθέσιμες όλες οι καινούργιες θε ραπείες και κατά συνέπεια να αυξάνεται ο πληθυσμός των υποψήφιων για μεταμόσχευση ασθενών χωρίς ωστόσο να αυξάνονται οι κλίνες, με αποτέλεσμα οι λίστες αναμονής να φτάνουν τους έξι μήνες και κά ποιοι ασθενείς να χάνουν την ύφεση, ενώ περιμένουν να υποβληθούν σε μεταμόσχευση. — Και τέλος για το μεγάλο αγκάθι του ΕΣΥ, που είναι η ενίσχυση των υποδομών και της στελέχω σης των αιματολογικών τμημάτων και των μονά δων μεταμόσχευσης της χώρας και η βελτίωση των συνθηκών νοσηλείας των αιματολογικών ασθενών; Τα προηγούμενα χρόνια, μεσούσης της κρίσης, οι υπο δομές του ΕΣΥ, αλλά και η στελέχωσή του μάλλον εγκα ταλείφθηκαν. Με αφορμή την πανδημία έγιναν κάποια έργα και υπήρξε ουσιαστική βελτίωση σε ορισμένα τμήματα των νοσοκομείων. Ωστόσο, τα Αιματολογικά Τμήματα, αν και διαχειρίστηκαν σημαντικό όγκο ασθε νών με COVID-19 λοίμωξη και αιματολογικά νοσήματα, δεν αποτέλεσαν προτεραιότητα. Οι ήδη ακατάλληλες συνθήκες νοσηλείας επιβαρύνθηκαν κατά την παν δημία. Οι ασθενείς με επιθετικά νοσήματα, όπως οι οξείες λευχαιμίες και τα επιθετικά λεμφώματα, έχουν μακρόχρονες και πολύπλοκες νοσηλείες, οι οποίες απαιτούν κλειστά τμήματα με περιορισμένο επισκε πτήριο και επαρκές νοσηλευτικό προσωπικό που να μπορεί να φροντίζει κατάλληλα αυτούς τους ασθενείς. Είναι ο μόνος τρόπος για να εξασφαλιστεί η βέλτιστη έκβασή τους και να περιοριστεί η πανδημία των πο λυανθεκτικών μικροβίων, που κοστίζει πόρους για το ασφαλιστικό σύστημα αλλά κυρίως ζωές. Απαιτούνται, λοιπόν, άμεσες δράσεις και η υποστήριξη του έργου των αιματολόγων από την Πολιτεία. ■
αναπτύξει ιδιαίτερη δραστηριότητα στον τομέα του εθελοντισμού από τα φοιτητικά της χρόνια με έμφαση στην ενημέρωση για τη δωρεά αίματος και αιμοποιητικών κυττάρων.
| ΣΥΝΕΝΤΕΥΞΗ | 103
Παγώνη είναι αιματολόγος, διευθύντρια της Αιματολογικής-Λεμφωμάτων Κλινικής και
του ΓΝΑ «Ο Ευαγγελισμός», πρόεδρος της Ελληνικής Αιματολογικής Εταιρείας. Γεννήθηκε στην Υπάτη της Φθιώτιδος και σπούδασε στην Ιατρική Σχολή Ιωαννίνων. Εργάστηκε ως ειδικευόμενη παθολογίας στη Β’ Παθολογική Κλινική του ΓΝΑ Βόλου και ακολούθως εκπαιδεύτηκε στην Αιματολογία στην Αιματολογική-Λεμφωμάτων Κλινική του ΓΝΑ «Ο Ευαγγελισμός». Μετά την ολοκλήρωση της ειδικότητας παρέμεινε στο ΓΝΑ «Ο Ευαγγελισμός», αποκτώντας εμπειρία στη μεταμόσχευση αιμοποιητικών κυττάρων. Στη συνέχεια, κατόπιν κρίσης, διορίστηκε στην ίδια Κλινική, όπου παραμένει μέχρι σήμερα. Ασχολείται με τις μυελικές κακοήθειες και ιδιαίτερα με την Οξεία και Χρόνια Μυελογενή Λευχαιμία, αλλά και σπανιότερα μυελικά νεοπλάσματα, όπως η Συστηματική Μαστοκυττάρωση. Από το 2006, εκλέγεται στο Διοικητικό Συμβούλιο της Ελληνικής Αιματολογικής Εταιρείας, που έχει υπηρετήσει από διάφορες θέσεις, ενώ το 2021 εξελέγη πρόεδρος του Δ.Σ. Έχει
ΜΑΡ Ι Α ΠΑΓΏΝΗ Η Μαρία
ΜΜΜΟ
Οργανισμό για το Εγκεφαλικό, ετησίως 17 εκατομμύρια άνθρωποι υφί στανται εγκεφαλικό και από αυτούς 6 εκατομμύρια πε θαίνουν. Είναι η δεύτερη αιτία θανάτου και η πρώτη αι

τία αναπηρίας παγκοσμίως και γι’ αυτό το αποτύπωμά του είναι σοβαρό πάνω σε όλες τις πτυχές της ζωής. Το εγκεφαλικό δεν επηρεάζει μόνο τον ίδιο τον ασθε νή, αλλά έχει επιπτώσεις στον κοινωνικό του περίγυρο, την οικογένεια και τον εργασιακό του τομέα. Επίσης, αντίθετα με την κοινή πεποίθηση, μπορεί να συμβεί σε οποιονδήποτε, σε οποιαδήποτε ηλικία, ανεξαρτήτως φύλου και φυσικής κατάστασης. Το εγκεφαλικό είναι ένα πολυσύνθετο ιατρικό πρό βλημα και είναι ζωτικής σημασίας να γίνει ευρύτερα γνωστό ότι θεραπεύεται. Η έγκαιρη αναγνώριση των συμπτωμάτων και η ορθή διαχείρισή του ως υπερε πείγουσα κατάσταση, με αντιμετώπιση σε Μονάδα Εγκεφαλικών, μπορούν να βελτιώσουν εξαιρετικά την έκβαση του ασθενούς. ΠΟΙΑ Ε Ι ΝΑΙ ΤΑ ΣΥΜΠΤΩ ΜΑΤΑ Ανάλογα με το τμήμα του εγκεφάλου που προσβάλλε ται προκύπτουν τα αντίστοιχα συμπτώματα, με το κύ ριο χαρακτηριστικό ότι εγκαθίστανται απότομα, αιφνί δια. Τα πιο συνηθισμένα συμπτώματα είναι η αδυναμία ή το μούδιασμα σε πρόσωπο, χέρι ή πόδι, δυσκολία στην επικοινωνία, διαταραχή της όρασης, διαταραχή της ισορροπίας ή ξαφνικός πολύ δυνατός πονοκέφα λος. Πολλοί άνθρωποι όμως δυσκολεύονται να θυμη θούν όλα τα παραπάνω και τη στιγμή του εγκεφαλικού είναι ακόμη πιο δύσκολο. Γι’ αυτό υπάρχουν διάφοροι μνημονικοί κανόνες των κυριότερων συμπτωμάτων. Ένας εύκολος τρόπος να θυμάται κανείς τα συ μπτώματα του εγκεφαλικού είναι να σκεφτεί ΑΠΛΑ: Άκρο: Αδυναμία ή μούδιασμα σε ένα άκρο (στο

104 | ΤΟ ΕΓΚΕΦΑΛΙΚΟ ΠΡΟΚΑΛΕ Ι ΤΑΙ όταν διακόπτεται απότομα η κυκλοφορία του αίματος προς ένα τμήμα του εγκεφάλου. Χωρίς την παροχή αίματος τα
σταδιακά νεκρώνονται και εμφανίζεται
με την περιοχή
εγκεφα λικά κύτταρα
αναπηρία ανάλογα
του εγκεφάλου που προσβάλλεται. Σύμφωνα με τον Παγκόσμιο
πλευρά του προσώ που. Το ΕΓΚΕΦΑΛΙΚΟ ΕΠΕΙΣΟΔΙΟ απαιτεί έγκαιρη και σωστή αντιμετώπιση! Γράφει η ΒΑ ΣΩ ΖΗΣΙΜΟΠΟΥΛΟΥ, νευρολόγος, επικεφαλής της Πρότυπης Μονάδας Αντιμετώπισης Εγκεφαλικών της Ευρωκλινικής Αθηνών.
χέρι ή/και στο πόδι). Πρόσωπο: Αδυναμία στη μισή
Λόγος: Δυσκολία στο λόγο, ακατανόητες λέξεις ή καθόλου λόγος.
Άμεσα: Αν κάποιο από τα συμπτώματα έχει εμφα νιστεί ξαφνικά, πρέπει άμεσα να πάμε στο νοσοκομείο
που ιδανικά διαθέτει Μονάδα Εγκεφαλικών. Είναι σημαντικό να τονιστεί πως ένας στους τέσ σερις που έχουν υποστεί εγκεφαλικό υφίστανται και δεύτερο. Οι ασθενείς αυτοί και το περιβάλλον τους θα πρέπει να είναι επαρκώς ενημερωμένοι και προε τοιμασμένοι, ώστε αν προκύψει ανάγκη να κινηθούν γρήγορα. Ο ΧΡ Ο ΝΟΣ Ε Ι ΝΑΙ ΠΟΛΥ ΣΗΜΑΝΤΙΚΟΣ ΓΙΑ ΤΟ ΕΓΚΕΦΑΛΙΚΟ Κάθε λεπτό που περνά 2 εκατομμύρια κύτταρα νεκρώ νονται, που σημαίνει ότι η αναπηρία που καταλείπεται στον ασθενή αυξάνεται κάθε λεπτό. Γι’ αυτό είναι ζωτι κής σημασίας η άμεση αναζήτηση ιατρικής φροντίδας. Σε ασθενείς με ισχαιμικό εγκεφαλικό, έως 4,5 ώρες από την εγκατάσταση, που πληρούν συγκεκριμένα κριτήρια, χορηγείται θρομβολυτική αγωγή. Η θρομ βόλυση αποκαθιστά την κυκλοφορία του αίματος και επαναφέρει τη λειτουργία του εγκεφάλου. Όσο νωρί τερα χορηγείται τόσο καλύτερα είναι τα αποτελέσματα της θεραπείας και τόσο μικρότερη η αναπηρία που μένει στον ασθενή. Η θεραπευτική προσέγγιση μπορεί να περιλαμβάνει και μηχανική θρομ βεκτομή έως και 24 ώρες μετά το επεισόδιο με τη χρήση κατάλληλου απεικονιστικού
λογισμικού.
ΜΟΝ Α ΔΑ ΕΓΚΕΦΑΛΙΚ Ω Ν
Ιδανικά όλοι οι ασθενείς με εγκεφαλικό θα πρέπει να νοσηλεύονται σε Μονά δα Εγκεφαλικών. Τα πλεονεκτήματα της ύπαρξης Μονάδας Εγκεφαλικών και της νοσηλείας σε αυτή, έναντι της παρα κολούθησης σε όροφο, είναι πολ λαπλά. Εξειδίκευση: Οι ασθενείς αντιμετωπίζονται από εξειδι κευμένους νευρολόγους με συγκεκριμένα πρωτόκολλα ενεργειών. Έτσι διασφαλίζε ται η ομοιογενής προσέγγι ση των ασθενών βάσει των παγκοσμίως κατοχυρωμέ νων κατευθυντήριων οδη γιών. Χρόνος: Η οργανωμέ νη προσέγγιση με εξειδι κευμένο προσωπικό, μέσα
και τυποποιημένες διαδικασίες εξασφαλίζει ταχύτερη εκτίμηση, ταχύτερη διάγνωση και ταχύτερη θεραπεία. Ποιότητα: Τα στατιστικά αποδεικνύουν πως η ορ γάνωση Μονάδας Εγκεφαλικών οδηγεί σε αύξηση χο ρήγησης θρομβολυτικής θεραπείας, μειώνει τη θνητό τητα και τις ενδονοσοκομειακές επιπλοκές και αυξάνει τις πιθανότητες πλήρους επανένταξης του ασθενούς στην κοινωνία. Τέλος, αξίζει να σημειωθεί το οικονομικό όφε λος της νοσηλείας σε Μονάδα Εγκεφαλικών για το σύστημα υγείας. Ασθενείς που λαμβάνουν θεραπεία μειώνουν την ενδονοσοκομειακή παραμονή τους στο 1/3, απαιτείται μικρότερος ή καθόλου χρόνος αποκα τάστασης και αποθεραπείας και ταυτόχρονα η υπο λειπόμενη αναπηρία ελαχιστοποιείται. Έτσι, μπορούν να επιστρέψουν γρηγορότερα στο πρότερο επίπεδο λειτουργικότητας και παραμένουν ενεργοί στο κοι νωνικό σύνολο. Η ΧΡ Η ΣΗ ΤΕΧΝΗΤ Η Σ ΝΟΗΜΟΣ Υ ΝΗΣ Η διαχείριση των ασθενών με εγκεφαλικό εξαρτάται σημαντικά από τις πληροφο

| ΕΓΚΕΦΑΛΙΚΟ
οξεία φάση και μάλιστα από την ταχύτητα με την οποία οι πληροφορίες αυτές φτάνουν στον ειδικό νευρολόγο, καθώς όσο γρηγορότερα πραγματοποιη θεί η απεικονιστική διερεύνηση τόσο γρηγορότερα θα δοθεί θεραπεία στον ασθενή. Τη λύση στο παραπάνω πρόβλημα φέρνει η χρήση της Τεχνητής Νοημοσύνης (Artificial Intelligence). Η Μονάδα Εγκεφαλικών της Ευρωκλινικής, επεν δύοντας στις καινοτόμες τεχνολογίες, είναι η μόνη στην Ελλάδα που διαθέτει το πρωτοποριακό λογισμι κό Τεχνητής Νοημοσύνης «e-Stroke» της εταιρείας Brainomix, για την καλύτερη
γνωστικό λογισμικό Τεχνητής Νοημοσύνης (Artificial Intelligence), το οποίο παρέχει μεγαλύτερη αξιοπι στία και ταχύτητα στη διαγνωστική προσπέλαση των απεικονιστικών εξετάσεων του εγκεφάλου, προσδιο ρίζοντας με ακρίβεια το μέγεθος και την περιοχή του εγκεφάλου που πάσχει από εγκεφαλικό. Με αυτόν τον τρόπο, ο ασθενής λαμβάνει τη βέλτιστη απεικονιστική προσέγγιση με ελαχιστοποίηση των παρενεργειών από ακτινοβολία και σε συνδυασμό με την εξειδικευμένη ιατρική προσέγγιση, επιταχύνεται η διαδικασία λήψης αποφάσεων και αυξάνεται κατά 70% το ποσοστό των ασθενών που μπορούν να δεχθούν θεραπεία. Το εγκεφαλικό είναι ΕΠΕΙΓΟΝ. Αν έχετε συμπτώματα ή υποψία εγκεφαλικού, επισκεφτείτε άμεσα μία εξειδι κευμένη Μονάδα Εγκεφαλικών ή καλέστε 1011. ■

106 |
και πιο αποτελεσματική διάγνωση και θεραπεία των ασθενών με εγκεφαλικό επεισόδιο. Το «e-Stroke» αποτελεί ένα υπερσύγχρονο δια ΒΑ Σ Ώ ΖΗΣΙΜΟΠΟΥΛΟΥ Η Βάσω Ζησιμοπούλου είναι νευρολόγος, επικεφαλής της Πρότυπης Μονάδας Αντιμετώπισης Εγκεφαλικών της Ευρωκλινικής Αθηνών, η οποία έχει λάβει την πιστοποίηση «ESO Stroke Unit» από τον Ευρωπαϊκό Οργα νισμό Εγκεφαλικών (European Stroke Organization). Η αναγνώριση αυτή εντάσσει την Ευρωκλινική και την Ελλάδα στο επιλεγμένο δίκτυο των
νοσοκομείων της Ευρώπης, που διαθέτουν τα υψηλά ποιοτικά κριτήρια παροχής εξειδικευμένης υποστήριξης και θεραπείας σε ασθενείς με εγκεφαλικό.

Γράφει ο ΕΛΕΥΘ Ε ΡΙΟΣ Ζ Ε ΡΒΑΣ, πνευμονολόγος, διευθυντής ΕΣΥ (7η Πνευμονολογική Κλινική «ΣΩΤΗΡΙΑ»), γεν. γραμμ. Ελληνικής Πνευμονολογικής Εταιρείας

ενώ ο Ιπποκράτης ήταν αυτός που εισήγαγε πρώτος το «άσθμα» ως νοσολογική οντότητα στην Ιατρική, αν και το πιθανότερο είναι να περιλάμβανε τότε σε αυτό και άλλα αίτια δύσπνοιας. Από τότε βέβαια πολύ νερό κύλησε στο αυλάκι της γνώσης της ιατρικής επιστήμης, για να φτάσουμε στον σύγχρονο ορισμό του άσθματος ως μια χρόνια φλεγμονώδη νόσο των αεραγωγών.
Το άσθμα αποτελεί σήμερα μια από τις συχνότε ρες νοσολογικές οντότητες που απασχολεί γιατρούς και ασθενείς στην καθημερινή πράξη. Με κύρια χαρα κτηριστικά τη συνεχώς αυξανόμενη επιδημιολογική του διάσταση, τη χρονιότητα, την πολυπαραγοντική αιτι ολογία του και την αδιευκρίνιστη παθογένειά του, το άσθμα επηρεάζει χιλιάδες ανθρώπους στη χώρα μας και ωθεί την ιατρική κοινότητα σε πρωτοβουλίες για την έγκαιρη διάγνωση και σωστή αντιμετώπιση της νόσου. ΤΙ Ε Ι ΝΑΙ ΤΟ Α ΣΘΜΑ Στο άσθμα προσβάλλονται οι βρόγχοι, τα «σωληνάκια» δηλαδή που μεταφέρουν τον αέρα στους πνεύμονες. Συγκεκριμένα οι βρόγχοι φλεγμαίνουν, γίνονται δηλαδή ευαίσθητοι και οιδηματώδεις (πρησμένοι), και επομένως ο αυλός τους στενεύει. Επιπλέον οι μύες που περιβάλ λουν τους βρόγχους σαν δακτυλίδια ερεθίζονται και κάνουν σπασμό (βρογχόσπασμος), γεγονός που οδηγεί σε επιπλέον στένωση. Τέλος, έχουμε και αυξημένη παρα γωγή βλέννης (πτύελα), η οποία φράζει παραπάνω τους βρόγχους. Υπολογίζεται ότι 300 εκατομμύρια άνθρωποι έχουν άσθμα παγκοσμίως και ότι το άσθμα εμφανίζε ται στο 3-18% του πληθυσμού, ανάλογα με τη χώρα. Η πανελλαδική επιδημιολογική μελέτη για το άσθμα που έγινε από την Ομάδα Άσθματος της Ελληνικής Πνευ μονολογικής Εταιρείας έδειξε ότι το 9% περίπου του γενικού πληθυσμού στην Ελλάδα έχει άσθμα. ΠΑΡΑ ΓΟΝΤΕΣ ΠΟΥ ΠΡΟΚΑΛΟΥ Ν ΤΗΝ ΕΜΦΑ ΝΙΣΗ Α ΣΘΜΑΤΟΣ Πιθανολογείται ότι το άσθμα αναπτύσσεται από συν δυασμό κληρονομικών και περιβαλλοντικών
να αναπτύξουν και αυτά τη νόσο. Η ατοπία είναι ένας άλλος παράγοντας κινδύνου για την ανάπτυξη άσθματος και αρκετοί από τους πάσχοντες από άσθμα έχουν κάποια μορφή αλλεργίας. Στα αλλερ
108 | ΤΟ Α ΣΘΜΑ Ε Ι ΝΑΙ ΜΙΑ Ν ΟΣΟΣ γνωστή από την αρχαι ότητα, τα πρώτα δε καταγεγραμμένα συμπτώματα που μοιάζουν με αυτά του άσθματος υπάρχουν σε αιγυ πτιακό πάπυρο χρονολογούμενο από το 1550 π.Χ. Ο όρος «ασθμαίνω» αναφέρεται από τον Όμηρο στην «Ιλιάδα» ως το κόψιμο της ανάσας ή το λαχάνιασμα,
παραγό
Περισσότερα από
και τα
με
ντων.
100 γονίδια συνδέονται με το άσθμα
παιδιά γονιών
άσθμα έχουν μεγαλύ τερη πιθανότητα
ΓΝΝΘΑ «Η ΣΩΤΗΡΙΑ» Συμπτώματα, διάγνωση και θεραπεία για το ΒΡΟΓΧΙΚΟ Α ΣΘΜΑ !
γιογόνα περιλαμβάνονται ζωικές πρωτεΐνες (κυρίως το τρίχωμα της γάτας και του σκύλου), τα ακάρεα της σκόνης, διάφορες γύρεις λουλουδιών, αλλά και μύκη τες. Ο καπνός του τσιγάρου έχει συνδεθεί επίσης με αυξημένο κίνδυνο εμφάνισης άσθματος και υψηλότερο κίνδυνο θανάτου από άσθμα, συριγμό και λοιμώξεις του αναπνευστικού. Τέλος, η μόλυνση του περιβάλλοντος, η ατμοσφαιρική ρύπανση και ο «δυτικός» τρόπος ζωής, η απομάκρυνσή μας δηλαδή από το περιβάλλον και η ζωή σε μεγαλουπόλεις, έχουν ενοχοποιηθεί για την αύξηση της συχνότητας του άσθματος τις τελευταίες δεκαετίες.
ΤΑ ΣΥΜΠΤΩ ΜΑΤΑ Τα συχνότερα συμπτώματα που βιώνει ο ασθματικός ασθενής είναι δύσπνοια, βάρος ή σφίξιμο στο στήθος, συρίττουσα αναπνοή (γατάκια), ενώ συχνά υπάρχει και βήχας. Η αναπνοή τότε γίνεται δύσκολη. Είναι σαν να προσπαθεί κανείς να πάρει αναπνοή μέσα από ένα καλαμάκι. Χαρακτηριστικό του άσθματος είναι ότι τα συμπτώματα αυτά μεταβάλλονται στο χρόνο. Έτσι μπο ρεί να είναι εντονότερα αργά το βράδυ (ξυπνούν τον ασθενή στον ύπνο του) ή νωρίς το πρωί, ενώ παρου σιάζουν διακυμάνσεις από μέρα σε μέρα και ανάλογα με τις εποχές του χρόνου. Τα συμπτώματα αυτά μπορεί να βελτιώνονται αυτόματα ή μετά από θεραπεία. Τα συμπτώματα του άσθματος επιδεινώνονται μετά
από επαφή με ποικιλία περιβαλλοντικών παραγόντων, οπότε μπορεί να εμφανιστεί μια ασθματική κρίση-πα ροξυσμός. Τέτοιοι παράγοντες μπορεί να είναι αλλερ γιογόνα (οικιακή σκόνη, γύρη, μούχλα), λοιμώξεις κυ ρίως ιογενείς, συναισθηματικό stress, υγρασία, καπνός τσιγάρου. Η ΔΙ Α ΓΝΩΣΗ Η διάγνωση του άσθματος γίνεται κυρίως από την περι γραφή των συμπτωμάτων (ιστορικό), την εξέταση από τον ιατρό και τη χρήση συγκεκριμένων διαγνωστικών μεθόδων. Η σπιρομέτρηση είναι μια 5λεπτη εξέταση που μπο ρούν
της αλλεργίας είναι: οι δερματικές δοκιμασίες νυγμού (δερματικά test) και η εξέταση αίματος για ειδικά IgE αντισώματα (RAST test).
ΦΑΡΜΑΚΕΥΤΙΚ Η ΑΝΤΙΜΕΤΩ ΠΙΣΗ Μέχρι και σήμερα δεν υπάρχει οριστική θεραπεία του άσθματος, δεν υπάρχει δηλαδή κάποιο φάρμακο που θα το πάρει κάποιος και η νόσος θα εξαφανιστεί. Αυτό που χρειάζεται είναι συνεχής παρακολούθηση και σω στή αντιμετώπιση των συμπτωμάτων και αποφυγή των παροξύνσεων της νόσου. Ο στόχος της αντιμετώπισης του άσθματος είναι λοιπόν, σύμφωνα και με όλες τις διεθνείς οδηγίες, ο ΕΛΕΓΧΟΣ ΤΗΣ ΝΟΣΟΥ. Ο έλεγχος του άσθματος

ο γιατρός σας θα εκτιμήσει κυρίως στοιχεία από το ιστορικό σας για να θέσει τη διάγνωση της νόσου. Είναι λοιπόν σημαντικό να γνωρίζουμε ότι όλοι οι ασθματικοί δεν έχουν πα θολογική σπιρομέτρηση και ότι μια φυσιολογική σπι ρομέτρηση δεν αποκλείει τη διάγνωση του άσθματος. Χρήσιμες είναι επίσης εξετάσεις για τη διάγνωση της αλλεργίας σε συγκεκριμένες ουσίες. Οι δύο δοκιμασί ες που χρησιμοποιούνται πιο συχνά για την ανίχνευση
Στις πιο σο βαρές μορφές του άσθματος αυτό είναι πολύ δύσκολο να επιτευχθεί και ο στόχος εκεί είναι να επιτύχουμε το καλύτερο δυνατό αποτέλεσμα. Σε όλες τις περιπτώ σεις, πάντως, η αντιμετώπιση του άσθματος πρέπει να στοχεύει στην πρόληψη και την ανακούφιση των συμπτωμάτων. Το άσθμα όμως δεν είναι μια ομοιογενής και σταθε ρή νόσος, αλλά μια μεταβαλλόμενη στο χρόνο πάθηση
| 109 | ΒΡΟΓΧΙΚΟ ΑΣΘΜΑ
να κάνουν οι πνευμονολόγοι για τη διάγνωση διά φορων πνευμονοπαθειών. Η εξέταση αυτή μπορεί να βοηθήσει στη διάγνωση του άσθματος, πολλές φορές όμως -ειδικά στο ήπιο άσθμα- είναι απολύτως φυσι ολογική. Σε αυτές τις περιπτώσεις
επιτυγχάνεται όταν ο ασθε νής δεν έχει συμπτώματα, δεν έχει παροξυσμούς και είναι ικανός να έχει μια απολύτως φυσιολογική ζωή, συμπεριλαμβανομένων της άσκησης, της άθλησης και της πλήρους κοινωνικής δραστηριότητας.
και κάθε ασθενής μπορεί να έχει περιόδους απολύτου ελέγχου του άσθματός του, καθώς και περιόδους παρο ξύνσεων. Για το λόγο αυτόν, η αντιμετώπιση και η θερα πεία δεν μπορεί να είναι η ίδια για όλους τους ασθενείς, ούτε καν η ίδια για έναν συγκεκριμένο ασθενή στην πορεία του χρόνου. Η αγωγή πρέπει να μεταβάλλεται και να προσαρμόζεται στις ανάγκες του συγκεκριμένου ασθενούς, τη συγκεκριμένη περίοδο της ζωής του και της νόσου του. Ο καθορισμός της βαρύτητας της νόσου πρέπει να γίνεται κατά την αρχική επίσκεψη του ασθενούς στον γιατρό, κατά τη διάγνωση δηλαδή της νόσου. Βασίζε ται στο ιστορικό του ασθενούς, στα συμπτώματα και τη σπιρομέτρηση. Παρ’ όλα αυτά, επειδή όπως είπαμε το άσθμα είναι μια μεταβαλλόμενη νόσος και οι χαρα κτήρες του αλλάζουν με τη θεραπεία, η εκτίμηση του ελέγχου της νόσου και της ανταπόκρισης στην αγωγή πρέπει να επανεξετάζεται ανά τακτά χρονικά διαστήμα τα. Ο τακτικός αυτός έλεγχος πρέπει να περιλαμβάνει παρακολούθηση της διακύμανσης της αναπνευστικής λειτουργίας (σπιρομέτρηση), εκτίμηση του ελέγχου του άσθματος μέσω προτυποποιημένων ερωτηματολογίων (π.χ. ACT) και όπου είναι δυνατόν μέτρηση άλλων δει κτών βαρύτητας (π.χ. εκπνεόμενο ΝΟ). Η φαρμακευτική λοιπόν αγωγή, σύμφωνα με τις διεθνείς οδηγίες, πρέπει να προσαρμόζεται ανάλογα με τον έλεγχο της νόσου. Τα φάρμακα του άσθματος χωρίζονται σε αυτά που ανακουφίζουν τα συμπτώματα κάνοντας βρογχοδιαστο λή (ΑΝΑΚΟΥΦΙΣΤΙΚΑ) και σε αυτά που ελέγχουν τη νόσο και προλαμβάνουν τους παροξυσμούς καταπολεμώντας τη φλεγμονή (ΡΥΘΜΙΣΤΙΚΑ). Ανακουφιστικά φάρμακα είναι κατά κύριο λόγω οι β2 διεγέρτες ταχείας δράσης
και δευτερευόντως τα αντιχολινεργικά, καθώς και τα από του στόματος στεροειδή όταν χρησιμοποιούνται για τη θεραπεία των κρίσεων. Ρυθμιστικά φάρμακα είναι κατά κύριο λόγο τα στε ροειδή (εισπνεόμενα και από του στόματος) και οι β2 διεγέρτες μακράς δράσης και δευτερευόντως οι ανα στολείς των λευκοτριενίων. Στην κατηγορία των ρυθμι στικών φαρμάκων έχουν προστεθεί τα τελευταία χρόνια και τα μονοκλωνικά αντισώματα (anti-IgE, anti-IL5/5Ra, antiIL4/13) που χρησιμοποιούνται στις πιο σοβαρές μορ φές του άσθματος. Τα εισπνεόμενα στεροειδή είναι η βασική θεραπεία του άσθματος και είναι τα φάρμακα που άλλαξαν πορεία της νόσου και βοήθησαν στη βελτίωση της ζωής των ασθματικών ασθενών. Είναι η βάση της φαρμακοθερα πείας του άσθματος και η χρήση τους επιβάλλεται σε όλες τις κατηγορίες επίμονου άσθματος, σε δοσολογία αυξανόμενη ανάλογα με τη βαρύτητα της νόσου. Οι β2 διεγέρτες μακράς δράσης ήταν η επόμενη μεγάλη εξέλιξη στη θεραπεία του άσθματος και είναι πια η βα σική θεραπεία (πάντα σε συνδυασμό με εισπνεόμενα στεροειδή) του επίμονου άσθματος. Οι αναστολείς των λευκοτριενίων έρχονται να προσθέσουν ένα επιπλέον όπλο στη φαρμακευτική μας φαρέτρα, έχοντας θέση στο ήπιο - μέτριο άσθμα ιδιαίτερα όταν συνυπάρχει ρινίτιδα. Τέλος, τα μονοκλωνικά αντισώματα (υποδό ρια ενέσιμη θεραπεία) ήρθαν τα τελευταία χρόνια να προσφέρουν μια επιπλέον βοήθεια στη θεραπεία του σοβαρού άσθματος που δεν ρυθμίζεται με τη μέγιστη δοσολογία των εισπνεομένων φαρμάκων, με εντυπω σιακά αποτελέσματα στον έλεγχο της νόσου στην πολύ δύσκολη αυτή ομάδα των ασθματικών ασθενών. ■
110 |
ΕΛΕΥΘ Ε ΡΙΟΣ Ζ Ε ΡΒΑΣ Ο Ελευθέριος Ζέρβας είναι πνευμονολόγος, διευθυντής 7ης Πνευμονολογικής Κλινικής Νοσοκομείο ΓΝΝΘΑ «Η ΣΩΤΗΡΙΑ», γενικός γραμματέας Ελληνικής Πνευμονολογικής Εταιρείας. Γεννήθηκε στην Αθήνα το 1970. Αποφοίτησε το 1993 από την Ιατρική Σχολή του Πανεπιστημίου Κρήτης και ειδικεύτηκε στην Πνευμονολογία, αρχικά στο 401 ΓΣΝΑ και στη συνέχεια στο Νοσοκομείο «Η ΣΩΤΗΡΙΑ». Το 2003 απέκτησε τον τίτλο ειδικό
Πνευμονολογίας-Φυματιολογίας. Για
«Η ΣΩΤΗΡΙΑ», όπου και εργάζεται μέχρι σήμερα. Από τον Σεπτέμβριο του 2021 είναι διευθυντής της 7ης Πνευμονολογικής Κλινικής, ενώ από τον Φεβρουάριο 2022 και διευθυντής Ιατρικής Υπηρεσίας του Νοσοκομείου «Η ΣΩΤΗΡΙΑ» Το 2010 μετεκπαιδεύτηκε στην επεμβατική βρογχοσκόπηση στην Ιταλία, στο κέντρο Azienda Ospedali Riuniti. Το κλινικό και ερευνητικό του έργο επικεντρώνεται στα αποφρακτικά νοσήματα - άσθμα και ΧΑΠ, στον καρκίνο του πνεύμονα και την επεμβατική βρογχοσκόπηση. Είναι υπεύθυνος του Ιατρείου Ασθματος και του Κεντρικού Βρογχολογικού Εργαστηρίου «Χρίστος Γκάγκας» - ένα από τα μεγαλύτερα της Ελλάδος με πάνω από 2000 βρογχοσκοπήσεις το έτος. Είναι μέλος της ΕΠΕ και της ERS από το 2003, ενώ από τον Οκτώβριο 2020 είναι γενικός γραμματέας της ΕΠΕ. Έχει 60 δημοσιεύσεις σε διεθνή περιοδικά και περισσό τερες από 150 παρουσιάσεις σε ελληνικά και διεθνή συνέδρια.
τητας
4 χρόνια (από το 2004 έως το 2007) εργάστηκε ως επικουρικός επιμελητής πνευμονολόγος στο Νοσοκομείο Κορίνθου. Τον Μάρτιο του 2008 διορίστηκε ως επιμελητής Β' στην 7η Πνευμονολογική Κλινική του ΝΝΘΑ




#zoimprosta
για σύμπτωμα και επιβάλλει τη διαγνωστι κή αξιολόγηση από αρκετές ειδικότητες, με πιο συχνές εκείνες του παθολόγου, του ωτορινολαρυγγολόγου, του νευρολόγου, του οφθαλμιάτρου και του καρδιολόγου. «Ουσιαστικά πρόκειται για μια διαταραχή της ισορροπίας, η οποία σχετίζεται με την ικανότητα του εγκεφάλου μας να αντιλαμβάνεται τη θέση μας στο
περιβάλλον. Συνοδεύεται από την αίσθηση ότι περιστρε φόμαστε ή ότι όλα γυρίζουν γύρω από εμάς», εξηγεί η ωτορινολαρυγγολόγος-χειρουργός Κεφαλής Τραχήλου, ΠαιδοΩΡΛ, επιστημονική συνεργάτις του Νοσοκομείου ΥΓΕΙΑ-ΜΗΤΕΡΑ, Ανατολή Παταρίδου. Οι περισσότεροι μπερδεύουν τον ίλιγγο με την απλή ζάλη, την αστάθεια, τη «θολούρα», την τάση για λιπο θυμία ή το «βαρύ» κεφάλι (αυτό που νιώθει κανείς μετά από μεγάλη κατανάλωση αλκοόλ). Ιλιγγος μπορεί να εμφανιστεί είτε από προβλήματα του λαβυρίνθου (το όργανο της ισορροπίας) -κάτι που συμβαίνει στο 90% των περιπτώσεων- είτε από νευρολογικά προβλήματα, που είναι πολύ πιο σπάνια (10%). «Τα μηνύματα, που λαμβάνει ο εγκέφαλός μας από τα διάφορα όργανα (λαβύρινθο, μάτια, αρθρώσεις κ.τ.λ.), όσον αφορά στη θέση μας στο χώρο, μπορεί να είναι αντικρουόμενα, εάν κάποιο σύστημα ή όργανό μας υφίσταται μια διαταραχή. Τότε μπορεί να νιώσουμε ίλιγγο. Όμως, παρόλο που ο ίλιγγος έχει «εκρηκτικό» χαρακτήρα και συμπτώματα που τρομάζουν, σπάνια σχετίζεται με κάτι σοβαρό για την υγεία. Με άλλα λόγια, ένας ίλιγγος είναι πάντοτε επείγον ζήτημα, αλλά ευτυ χώς σπάνια είναι σοβαρό», επισημαίνει η κ. Παταρίδου. Ο Ρ ΟΛΟΣ ΤΟΥ ΕΙΔΙΚΟΥ ΙΑΤΡΟΥ Είναι σημαντικό ο πάσχων να απευθυνθεί στην κατάλλη λη ιατρική ειδικότητα, που είναι η Ωτορινολαρυγγολο γία. Ο ειδικός ιατρός θα λάβει λεπτομερές ιατρικό ιστο ρικό και θα υποβάλει τον πάσχοντα σε νευροωτολογικό - ακοολογικό έλεγχο [ακοόγραμμα, τυμπανόγραμμα, ωτοακουστικές εκπομπές, ακουστικά προκλητά δυναμικά εγκεφαλικού στελέχους, πρόκληση ιλίγγου θέσεως (δο κιμασία Dix Hallpike), ηλεκτρονυσταγμογραφία]. Συχνά

112 | ΟΣΟΙ Ε ΧΟΥΝ ΝΙ Ω ΣΕΙ Ι ΛΙΓΓΟ ή vertigo δύσκολα το ξε χνούν. Αυτή η αίσθηση ότι όλα γύρω γυρίζουν τρομο κρατεί τον πάσχοντα, που εκείνη τη στιγμή αδυνατεί να καταλάβει τι του συμβαίνει και γιατί. Ο ίλιγγος, ωστόσο, δεν είναι ένα παιχνίδι του μυαλού. Ούτε είναι
Πρόκειται
πάθηση.
μπορεί να χρειαστεί να γίνει και αξονική ή μαγνητική Ο Ι ΛΙΓΓΟΣ αφορά όλες τις ηλικίες και μπορεί να αντιμετωπιστεί! ΑΝΑΤΟΛ Η ΠΑΤΑΡ Ι ΔΟΥ Χειρουργός ωτορινολαρυγγολόγος Κεφαλής & Τραχήλου, παιδοΩΡΛ, επιστημονική συνεργάτις του Νοσοκομείου ΥΓΕΙΑ-ΜΗΤΕΡΑ.
εμέτους, που επιδεινώ
του κεφαλιού. Διαρκεί
από λίγες μέρες έως τρεις εβδομάδες. Καλοήθης παροξυσμικός ίλιγγος θέσεως: Χαρακτη ριστικό της πάθησης είναι η πρόκληση των συμπτωμά των του ιλίγγου όταν ο ασθενής ξαπλώσει ύπτια, με το κεφάλι του στραμμένο προς τα πλάγια, από την πλευρά του πάσχοντος λαβυρίνθου. Νόσος του Meniere: Η νόσος χαρακτηρίζεται από σημαντικές ακουστικές διαταραχές, που διαρκούν από 30 λεπτά έως 24 ώρες. Εκτός από τον ίλιγγο, ο ασθενής παρουσιάζει βαρηκοΐα, εμβοές και αίσθημα πληρότητας ώτων. Η βαρηκοΐα δεν είναι μόνιμη, αλλά βελτιώνεται μετά την πάροδο μιας υποτροπής. Ακουστικό νευρίνωμα: Είναι ένας καλοήθης όγκος, που αυξάνεται με βραδύ ρυθμό, προκαλώντας μονό πλευρη βαρηκοΐα, εμβοές και ίλιγγο. Ο ίλιγγος είναι παροδικός και διαρκεί από 30 λεπτά έως μερικές εβδο μάδες. Η βαρηκοΐα, όμως, είναι μόνιμη και προοδευτικά επιδεινώνεται. Διάσειση του λαβυρίνθου: Οφείλεται σε τραυματι σμούς και σε κακώσεις του κεφαλιού. Εκτός από τον ίλιγγο, ο τραυματίας πιθανόν να παρουσιάζει βαρηκοΐα και εμβοές. Ίλιγγος σχετιζόμενος με ημικρανία: Στο πλαίσιο ενός επεισοδίου ημικρανίας, μπορεί ο ασθενής να εμφανίσει και ίλιγγο, βαρηκοΐα και εμβοές. Χαρακτηριστικά της ημικρανίας είναι η ευαισθησία του πάσχοντος στους ήχους και στο φως. Π Ω Σ ΑΝΤΙΜΕΤΩΠ Ι ΖΕΤΑΙ Δεδομένου ότι οι αιτίες του ιλίγγου είναι πολλές και διαφορετικές, η αντιμετώπιση είναι ανάλογη της εκά στοτε αιτίας. «Η θεραπεία στις περιπτώσεις ιλίγγου λαβυρινθικής αιτιολογίας μπορεί να περιλαμβάνει είτε φάρμακα είτε

| ΙΛΙΓΓΟΣ | 113 τομογραφία. Γενικότερα, το ποιες από τις παραπάνω εξετάσεις είναι απαραίτητες, προκειμένου να αποκλεισθούν πα θήσεις με παρόμοια κλινική εικόνα και να καταλήξει ο ιατρός στην αιτία του ιλίγγου, εξατομικεύεται ανά ασθενή. ΔΕΣΜ ΩΤΕΣ ΤΟΥ ΙΛ Ι ΓΓΟΥ Ας δούμε ποιες είναι οι πιο συχνές αιτίες του ιλίγγου: Αιθουσαία νευρωνίτιδα: Χαρακτηρίζεται από
δια έναρξη με έντονο ίλιγγο και
αιφνί
νονται με οποιοσδήποτε κίνηση
ασκήσεις αιθουσαίας αντιρρόπησης, όπως λέγεται, είτε σε κάποιες περιπτώσεις και χειρουργική επέμβαση. Η φαρμακευτική αγωγή ουσιαστικά προσφέρει ανακού φιση από συμπτώματα όπως η ναυτία και η έντονη ζα λάδα, που σχετίζονται με τον ίλιγγο. Αν, όμως, από τον διαγνωστικό έλεγχο διαπιστωθεί λοίμωξη στα αυτιά ή στις παραρρίνιες κοιλότητες, τότε επιβάλλεται και η χρήση αντιβιοτικών», εξηγεί η ειδικός. Αξίζει να αναφερθεί ότι στον καλοήθη παροξυσμικό ίλιγγο θέσης, η θεραπεία επιτυγχάνεται με ειδικές ασκή σεις, που ονομάζονται χειρισμοί Epley. Πρόκειται για κινήσεις της κεφαλής, που γίνονται υπό την καθοδήγηση του ωτορινολαρυγγολόγου στο χώρο του ιατρείου και ανακουφίζουν άμεσα τον ασθενή. Π Ω Σ ΕΜΦΑΝ Ι ΖΕΤΑΙ ΣΤΑ ΠΑΙΔΙ Α Ίλιγγο, όμως, παθαίνουν ενίοτε και τα παιδιά. Σε αυτές τις περιπτώσεις τα βασικά συμπτώματα είναι η αστά θεια, δηλαδή η τάση του παιδιού να πέσει προς τη μια πλευρά, όταν στέκεται ή όταν βαδίζει, που γίνεται ακόμη πιο έντονη όταν κινείται πάνω σε κρεβάτι ή σε μαξι λάρια. Πολύ συχνό σύμπτωμα είναι επίσης ο εμετός ή η ναυτία και ο πόνος στην κοιλιά. Επιπλέον μπορεί να συνοδεύεται και από διαταραχές στην όραση. «Η πιο συχνή αιτία του παιδιατρικού ιλίγγου είναι η ημικρανία, που είναι πολύ συχνό πρόβλημα της παιδικής ηλικίας και συχνά συνοδεύεται από ίλιγγο. Η δεύτερη κατά σειρά συχνότητας αιτία είναι ο ιδιοπαθής καλο
ήθης παροξυσμικός ίλιγγος θέσεως της παιδικής ηλι κίας. Πρόκειται για μια άγνωστης αιτιολογίας πάθηση, που χαρακτηρίζεται από ίλιγγο μικρής διάρκειας ≤10 λεπτών, ο οποίος μετά την κρίση υποχωρεί εντελώς. Οι κρίσεις ιλίγγου συνήθως έρχονται με μια απρόβλεπτη συχνότητα και περνούν από μόνες τους μετά από 6-12 μήνες», αναφέρει η κ. Παταρίδου. Τα οφθαλμολογικά προβλήματα είναι υπεύθυνα για το 15-20% των επεισοδίων παιδιατρικού ιλίγγου. Τα πιο συχνά είναι η μυωπία, η υπερμετρωπία και ο αστιγμα τισμός και μπορούν να οδηγήσουν σε κρίση ιλίγγου, ναυτία και εμετό. Χαρακτηριστικά παρατηρούνται κατά το τέλος της ημέρας μετά από ανάγνωση, παρακολού θηση τηλεόρασης ή χρήση ηλεκτρονικού υπολογιστή. Πιο συχνά τη μορφή αυτή ιλίγγου τη βρίσκουμε σε παιδιά ηλικίας 4-5 ετών, που κάθονται πολλές ώρες μπροστά σε οθόνη. Μια γενική κλινική εξέταση από τον παιδίατρο μπορεί να οδηγήσει στη διάγνωση. Όμως και εδώ η συμβολή του έμπειρου ωτορινολαρυγγολόγου είναι καθοριστική. Απαραίτητες είναι η νευρολογική και η οφθαλμολογική εξέταση. Η θεραπεία και εδώ ορίζεται ανάλογα με την αιτία που προκάλεσε το σύμπτωμα. ■
Σκωτία, Τμήμα ΩΡΛ. Διετέλεσε υπεύθυνη στο ΩΡΛ Τμήμα της Θεραπευτικής Κλινικής Αθηνών, υπεύθυνη στο Κέντρο Αποκατάστασης «ΦΙΛΟΚΤΗΤΗΣ», Τμήμα ΩΡΛ-Δυσφαγίας-Κατάποσης, επιστημονική συνεργάτις, ΔΘΚΑ «Υγεία», ΩΡΛ.

114 |
ΑΝΑΤΟΛ Η ΠΑΤΑΡ Ι ΔΟΥ Η Ανατολή Παταρίδου είναι χειρουργός ωτορινολαρυγγολόγος Κεφαλής & Τραχήλου, παιδοΩΡΛ, επιστημονική συνεργάτις του Νοσοκομείου ΥΓΕΙΑ-ΜΗΤΕΡΑ. Είναι πτυχιούχος της Ιατρικής Σχολής του Αριστοτελείου Πανεπιστημίου Θεσσαλονίκης. ΕΠΑΓΓΕΛΜΑΤΙΚΗ ΠΡΟΫΠΗΡΕΣΙΑ Αγροτικός ιατρός, Κ.Υ. Περάματος Ν. Ρεθύμνου, Κρήτη, συνεργάτις Νοσοκομείο Παίδων «Π. & Α. Κυριακού», Β′ Παιδοχειρουργικό Τμήμα ΩΡΛ, ΓΠΝ «Ευαγγελισμός», Τμήμα ΩΡΛ, Μετεκπαίδευση, Πανεπιστημιακή Κλινική Εδιμβούργου,

Η
ΣΑΡΚΟΠΕΝ Ι Α μεγάλη απειλή


για τους καρκινοπαθείς!
Γράφει ο ΙΩ Α ΝΝΗΣ Γ. ΚΑΡΑΪΤΙΑΝ ΟΣ, αμ. επίκ. καθηγητής Χειρουργικής Πανεπιστημίου Αθηνών, διευθυντής Χειρουργικής Κλινικής Νοσοκομείου «Ερρίκος Ντυνάν», τ. συντονιστής διευθυντής Ογκολογικής Χειρουργικής Κλινικής Αντικαρκινικού Νοσοκομείου «Αγ. Σάββας», πρόεδρος Ελληνικής Εταιρείας Χειρουργικής Ογκολογίας, πρόεδρος Ελληνικής Γεροντολογικής & Γηριατρικής Εταιρείας, πρόεδρος Εταιρείας Ιατρικών Σπουδών.
στις πρώτες θέσεις μεταξύ των κρατών-μελών της Ευρωπαϊκής Ένωσης σε γηρά σκοντα πληθυσμό, με τα άτομα ηλικίας άνω των 65 ετών να αντιπροσωπεύουν σήμερα στη χώρα μας πο σοστό πάνω από το 21,3% του πληθυσμού. Σύμφωνα με τις προβλέψεις, το 2030 θα είναι περίπου το 30% του πληθυσμού, ενώ το 2050 θα πλησιάσουν το 1/3 του πληθυσμού! Αυτή η δημογραφική γήρανση -κοινή σε όλες τις δυτικού τύπου χώρες- προκαλεί πολλά προ βλήματα, ιατρικά, κοινωνικά, οικογενειακά, οικονομι κά, ασφαλιστικά κ.ά., που θα προσλάβουν εκρηκτικές διαστάσεις στις προσεχείς δεκαετίες. Ο καρκίνος αποτελεί νόσο κατεξοχήν της τρίτης ηλικίας. Οι περισσότερες μορφές καρκίνου διαγιγνώ σκονται σε ηλικιωμένα άτομα: Πάνω από το 50% των κακοήθων όγκων στις ΗΠΑ και στην Ε.Ε. αφορά σε άτο μα άνω των 65 ετών. Πάνω από το 66% των θανάτων από καρκίνο συμβαίνει σε ασθενείς ηλικίας άνω των 65 ετών. Οι καρκίνοι είναι υπεύθυνοι σαν πρώτη αιτία θανάτου στο φάσμα ηλικίας μεταξύ 65 και 74 ετών και η δεύτερη αιτία θανάτου μετά τα 75 χρόνια. Με τον όρο δυσθρεψία, δηλαδή τις διαταραχές της θρέψης, χαρακτηρίζουμε είτε τη σαρκοπενία είτε την παχυσαρκία. Και οι δύο αυτές μορφές της δυσθρεψίας απαντώνται πολύ συχνά στις προχωρημένες ηλικίες, αλλά και στους ασθενείς με καρκίνο. Η δυσθρεψία είναι από τις πιο συχνές και σοβαρές επιπλοκές του καρκίνου, αλλά και των θεραπειών αντιμετώπισής του. Ο επιπολασμός της δυσθρεψίας και της απώλειας βά ρους στους ογκολογικούς ασθενείς κυμαίνεται από 20% έως 70%, αναλόγως του είδους καρκίνου και του σταδίου της νόσου. Τα μεγαλύτερα ποσοστά δυσθρεψίας παρατηρού νται σε ασθενείς με καρκίνο του ανώτερου γαστρε ντερικού συστήματος, δηλαδή του οισοφάγου και του στομάχου, καθώς και με καρκίνο πνεύμονα και παγκρέ ατος. Χαρακτηριστικά αναφέρεται πως το 60 85 % των ασθενών με καρκίνο ανώτερου γαστρεντερικού συστή
116 | Η ΕΛΛ Α ΔΑ ΚΑΤΑΤΑ
ΣΣΕΤΑΙ
ματος θα αντιμετωπίσει τουλάχιστον ένα διατροφικό πρόβλημα από τη διάγνωση της νόσου μέχρι και την ολοκλήρωση των θεραπειών. Πολύ σημαντικό είναι το γεγονός πως σε πολλούς ασθενείς παρατηρούνται δι ατροφικές ελλείψεις, ήδη από τη φάση της διάγνωσης της νόσου, με το 51% των ασθενών να αναφέρει δια ταραγμένη διατροφική πρόσληψη, το 40% ανορεξία, ενώ το 65% αναφέρει ακούσια απώλεια βάρους κατά τη διάρκεια των τελευταίων 6 μηνών. Όσον αφορά στις αιτίες για τα υψηλά αυτά ποσο στά δυσθρεψίας και σαρκοπενίας, πρέπει να αναφέ ρουμε πως τα αίτια είναι πολυπαραγοντικά. Κύριες αιτίες είναι η δυσφαγία, η ξηροστομία, η εντερική απόφραξη, η δυσαπορρόφηση, διαταραχές στην κι νητικότητα του εντέρου, ναυτία/έμετοι,
φάση διάγνωσης της νόσου. Η σαρκοπενία αποτελεί αρνητικό προγνωστικό παράγοντα για τις μετεγχειρη τικές επιπλοκές, αλλά και τη συνολική επιβίωση για τους ασθενείς με καρκίνο πεπτικού. Μάλιστα, η σαρκο πενία έχει συνδεθεί με την καρκινική καχεξία, η οποία ορίζεται ως «ένα πολυπαραγοντικό σύνδρομο, που χα ρακτηρίζεται από προοδευτική απώλεια μυϊκής μάζας, με ή χωρίς απώλεια λιπώδους μάζας, και δεν μπορεί να αντιστραφεί πλήρως από τη συνήθη διατροφική υποστήριξη, οδηγώντας προοδευτικά σε λειτουργικές διαταραχές». Σε μία μελέτη μας σε 233 ασθενείς με καρκίνο πε πτικού που προσήλθαν για χειρουργική
επιστημονικοί φορείς τη χαρακτηρίζουν ως το χαμηλό επίπεδο σκελετικής μυϊκής μάζας με συνυπάρχουσα μειωμένη
έγινε με τον υπο λογισμό της μυϊκής επιφάνειας στο επίπεδο του 3ου οσφυϊκού σπονδύλου από τις διαθέσιμες αξονικές τομογραφίες κοιλίας με το λογισμικό Tomovision. Τα ευρήματα συσχετίστηκαν με αιματολογικές και βιοχη μικές παραμέτρους. Από τους 233 ασθενείς, οι 106 ήταν άνδρες και οι 127 γυναίκες. Άνω των 65 ετών ήταν οι 58 από τους 106 άνδρες (55%) και οι 68 από τις 127 γυναίκες (53%). Οι 91 στους 106 άνδρες (85%) και οι 76 στις 127 γυ ναίκες (60%) ήταν σαρκοπενικοί. Όσον αφορά στον

| 117 | ΣΑΡΚΟΠΕΝΙΑ
Χειρουργική Ογκολογική Κλινική του Νοσοκομείου «Άγιος Σάββας» από τον Ιανουάριο του 2012 ως και τον Οκτώβριο του 2019, εκτιμήθηκε η επίπτωση της σαρκοπενίας κατά την αρχική διάγνωση της κακοήθει ας. Η αξιολόγηση της σαρκοπενίας
επέμβαση στη
ο πόνος, με ταβολές στην όρεξη, γεύση και όσφρηση. Ακόμη, ο νεοπλασματικός όγκος ανταγωνίζεται τα υπόλοιπα όργανα
ιστούς σε επίπεδο
και
που επιδεινώνει
σότερο την πρόσληψη τροφής. Αν και δεν υπάρχει ένας καθολικά παραδεκτός ορι σμός για τη σαρκοπενία, οι περισσότεροι ευρωπαϊκοί
μυϊκή λειτουργία με ή χωρίς συνοδό αύξηση της λιπώδους μάζας. Οι ασθενείς με καρκίνο πεπτικού εμφανίζουν υψη λά ποσοστά δυσθρεψίας και σαρκοπενίας ήδη από τη
και
πρόσληψης ενέργειας
προκαλεί ανορεξία
ακόμη περισ
Δείκτη Μάζας Σώματος (ΔΜΣ), όλοι οι υποθρεπτικοί ασθενείς με ΔΜΣ <20 ήταν σαρκοπενικοί, ενώ από τους παχύσαρκους μόνο 18 από τους 31 άνδρες (58%) και 10 από τις 27 γυναίκες (37%) ήταν σαρκοπενικοί. Επιβαρυντικοί παράγοντες εμφάνισης σαρκοπενίας ήταν η μεγαλύτερη ηλικία, το ανδρικό φύλο και ο ΔΜΣ <20. Όλοι οι σαρκοπενικοί ασθενείς έλαβαν διατροφι κή υποστήριξη. Ιδιαίτερο ενδιαφέρον παρουσιάζουν οι επαναξιολογήσεις 47 ασθενών. Οι 16 από αυτούς εμφάνισαν αύξηση της μυϊκής τους μάζας μετά τη χο ρήγηση διατροφικής υποστήριξης και έναρξη ήπιας σωματικής άσκησης. Ιδιαίτερη αναφορά πρέπει να γίνει στη σαρκο πενική παχυσαρκία, η οποία ορίζεται ως ο συνδυα σμός χαμηλών επιπέδων μυϊκής μάζας και αυξημένων επιπέδων λιπώδους ιστού. Συγκεκριμένα, 1 στους 10 ασθενείς σε προχωρημένα στάδια καρκίνου είναι σαρ κοπενικά παχύσαρκος, ενώ 1 στους 4 ασθενείς που εί ναι παχύσαρκοι είναι ταυτοχρόνως σαρκοπενικός. Οι σαρκοπενικά παχύσαρκοι ασθενείς έχουν ιδιαίτερα αυξημένο
διατροφικής φροντίδας στους ασθενείς με καρκίνο πεπτικού. Αξίζει να σημειωθεί, ωστόσο, πως μόνο το 30-60% των ογκολογικών ασθενών που ανιχνεύονται με κίνδυνο εμφάνισης δυσθρεψίας στα νοσοκομεία
λαμβάνει την κατάλληλη διατροφική υποστήριξη. Είναι απαραίτητη, επομένως, τόσο η ευαισθητοποίηση όσο και η συνεργασία μεταξύ των επαγγελματιών υγείας σε όλα τα στάδια ανίχνευσης και αντιμετώπισης της δυσθρεψίας. Ωστόσο, σημαντική είναι η παράλληλη με τη δι ατροφική υποστήριξη σύσταση στους ασθενείς για αύξηση της σωματικής δραστηριότητας και άσκησης. Φαίνεται ότι η σωματική άσκηση, έστω και για το βρα χύ χρονικό διάστημα της προεγχειρητικής περιόδου και ιδιαίτερα μετά από τη χειρουργική επέμβαση, βελ τιώνει τη μυϊκή μάζα των ασθενών. Τέλος, η καρκινική καχεξία αποτελεί ένα από τα ση μαντικότερα προβλήματα που καλείται να αντιμετωπί σει ο ογκολογικός ασθενής στα προχωρημένα στάδια της νόσου, ως αποτέλεσμα της προόδου της νόσου αλλά και των συμπληρωματικών θεραπειών, δηλαδή χειρουργικών επεμβάσεων, ακτινοθεραπείας, χημειο θεραπείας κ.λπ. Οι μισοί περίπου θάνατοι από καρκίνο παγκοσμίως (~8,2 εκατομμύρια άνθρωποι ανά έτος) αποδίδονται κυρίως σε επιπλοκές που σχετίζονται με την καχεξία, ιδιαίτερα στον καρκίνο του παγκρέατος (0,33 εκατ. θάνατοι), του οισοφάγου (0,40 εκατ. θάνα τοι), του στομάχου (0,72 εκατ. θάνατοι), του πνεύμονος (1,59 εκατ. θάνατοι), του ήπατος (0,75 εκατ. θάνατοι) και στον καρκίνο του παχέος εντέρου-ορθού (0,69 εκατ. θάνατοι). Ωστόσο, μόνο ένας στους τρεις νοσηλευόμενους ογκολογικούς ασθενείς που βρίσκονται σε διατροφικό κίνδυνο και δυσθρεψία λαμβάνει διατροφική υποστή ριξη, γεγονός που καταδεικνύει την επιτακτική ανάγκη έγκαιρης αξιολόγησης των ασθενών αυτών και την ορ γάνωση διεπιστημονικών ομάδων που θα εστιάσουν

118 |
κίνδυνο θνητότητας και εμφάνισης σοβα ρών επιπλοκών από τις θεραπείες αντιμετώπισης του καρκίνου. Π Ω Σ ΜΠΟΡΕ Ι ΝΑ ΑΝΤΙΜΕΤΩΠΙΣΤΕ Ι Η χορήγηση μετεγχειρητικής διατροφικής υποστή ριξης σχετίσθηκε με βελτίωση της
της
τη σημασία της
μυϊκότητας και με μερική αποκατάσταση
σαρκοπενίας, γεγονός που αναδεικνύει
έγκαιρης και στοχευμένης
Με τον όρο δυσθρεψία, δηλαδή τις διαταραχές της θρέψης, χαρακτηρίζουμε είτε τη σαρκοπενία είτε την παχυσαρκία. Και οι δύο αυτές μορφές της δυσθρεψίας απαντώνται πολύ συχνά στις προχωρημένες ηλικίες, αλλά και στους ασθενείς με καρκίνο.
στην αποτελεσματική διατροφική ενίσχυσή τους. Σήμερα έχουμε στη διάθεσή μας πολλά επιστημονι κά εργαλεία για την έγκαιρη διάγνωση της σαρκοπενί ας στους καρκινοπαθείς ασθενείς, ιδιαίτερα σε αυτούς
που έχουν και άλλα χρόνια νοσήματα, όπως σακχα ρώδη διαβήτη, καρδιοπάθειες, χρόνια αποφρακτική πνευμονοπάθεια, ηπατικές παθήσεις, χρόνια νεφρική ανεπάρκεια, οστεοπόρωση κ.λπ. Η ευαισθητοποίηση του ιατρικού και νοσηλευτικού προσωπικού εν προκειμένω είναι απαραίτητη για την έγκαιρη ανίχνευση των διαταραχών θρέψης των ασθε νών με τη χρήση απλών ερωτηματολογίων για τις δια τροφικές τους συνήθειες, την επιμελή φυσική εξέταση και αξιολόγηση της πρόσληψης τροφής στη σωστή πο σότητα και θρεπτική αξία, την εκτίμηση της απώλειας
βάρους στο τελευταίο χρονικό διάστημα, αλλά και τις διαταραχές όρεξης, γεύσης, μάσησης και κατάποσης. Συμπερασματικά, η σαρκοπενία επιβαρύνει κατά πολύ την επιβίωση των ασθενών με καρκίνο, αυξά νει τους κινδύνους επιπλοκών μετά από χειρουργικές επεμβάσεις, αλλά και ακτινοθεραπεία και χημειοθερα πεία και επιδεινώνει σημαντικά την ποιότητα ζωής των ασθενών, δυσχεραίνοντας την αποθεραπεία τους. Η σωστή διατροφή, πλούσια σε πρωτεΐνες, βιταμίνες και ιχνοστοιχεία, με τη χρήση συμπληρωματικά και ειδικών διατροφικών σκευασμάτων, εάν αυτό απαιτείται, και η ήπια σωματική δραστηριότητα μπορούν να βελτιώ σουν το επίπεδο της μυϊκής μάζας και της λειτουργι κότητας των ασθενών με καρκίνο, συντελώντας στην κατά το δυνατόν θετικότερη εξέλιξη της νόσου. ■
Συμβουλίου και διευθυντής
Τομέα ΓΑΟΝΑ «Άγιος Σάββας». 2017-2019: Συντονιστής διευθυντής Χειρουργικής Ογκολογικής Κλινικής ΓΑΟΝΑ «Άγιος Σάββας». 20052017: Διευθυντής Χειρουργικής Ογκολογικής Κλινικής ΓΑΟΝΑ «Άγιος Σάββας». 1995: Αναπληρωτής διευθυντής Χειρουργικής Κλινικής ΓΑΟΝΑ «Άγιος Σάββας». 1990: Υφηγητής - αμ. επίκ. καθηγητής Χειρουργικής Πανεπιστημίου Αθηνών. 1990-1991: Αναπληρωτής καθηγητής Χειρουργικής Πανεπιστημίου
Saint Antoine Πανεπιστημίου Παρισίων. 1986: Ανάθεση διδασκαλίας μαθήματος Ανατομικής Πανεπιστημίου Κρήτης. 1984-1986: Επιμελητής Χειρουργικής Κλινικής Αντικαρκινικού Νοσοκομείου Πειραιώς «Μεταξά». 1982-1983: Επιμελητής Χειρουργικής Κλινικής Νοσοκομείου «Αγία Όλγα» Νέας Ιωνίας. 1981: Επίκουρος καθηγητής ΤΕΙ Αθηνών-Σχολή Επαγγ. Υγείας. 198081: Επιμελητής Χειρουργικής Κλινικής Ναυτικού Νοσοκομείου Σαλαμίνας (Κελευστής Π.Ν.). 1980: Ανάθεση διδασκαλίας μαθήματος Ανατομικής Πανεπιστημίου Πατρών.
| 119 | ΣΑΡΚΟΠΕΝΙΑ
Ι ΏΑ ΝΝΗΣ Γ.
πρόεδρος Ελληνικής Γεροντολογικής & Γηριατρικής Εταιρείας, πρόεδρος Εταιρείας Ιατρικών
ΕΠΑΓΓΕΛΜΑΤΙΚ Η ΠΡΟΫΠΗΡΕΣ Ι Α: 2020-σήμερα: Διευθυντής H′ Χειρουργικής Κλινικής Νοσοκομείου Ερρίκος Ντυνάν Hospital Center. 1990-σή μερα: Αμ. επίκ. καθηγητής Χειρουργικής Πανεπιστημίου Αθηνών - Μαθήματα σε φοιτητές Ιατρικής και Νοσηλευτικής Σχολής ΕΚΠΑ και συμμετοχή στην εκπαίδευση ειδικευομένων στη Χειρουργική ιατρών. 20182019: Πρόεδρος Επιστημονικού
Saint Antoine Παρισίων. 1989: Επιμελητής Α’ ΓΑΟΝΑ «Άγιος Σάββας». 1986-1989: Chef de Clinique Assistant Αντικαρκινι κού Νοσοκομείου Institut Curie Παρισίων και Νοσοκομείου
ΚΑΡΑΪΤΙΑΝ ΟΣ Ο Ιωάννης Γ. Καραϊτιανός είναι αμ. επίκ. καθηγητής Χειρουργικής Πανεπιστημίου Αθηνών, διευθυντής Χει ρουργικής Κλινικής Νοσοκομείου «Ερρίκος Ντυνάν», τ. συντονιστής διευθυντής Ογκολογικής Χειρουργικής Κλινικής Αντικαρκινικού Νοσοκομείου «Αγ. Σάββας», πρόεδρος Ελληνικής Εταιρείας Χειρουργικής Ογκολο γίας,
Σπουδών.
Χειρουργικού
ΠΑΝΕΠΙΣΤΗΜΙΑΚΟ ΓΕΝΙΚΟ ΝΟΣΟΚΟΜΕΙΟ «ΑΤΤΙΚΟΝ»
Γράφει ο ΓΙ Ω ΡΓΟΣ ΔΗΜΗΤΡΙ Α ΔΗΣ, ομότιμος καθηγητής ΠαθολογίαςΜεταβολικών Παθήσεων ΕΚΠΑ, αντιπρόεδρος Ινστιτούτου Εφαρμοσμένης Φυσιολογίας & Άσκησης στην Ιατρική.

1. ΣΔ τύπου 1 (ΣΔτ1): αφορά το 5-10% και οφείλεται σε αυτοάνοση καταστροφή των β-κυττάρων, η οποία οδηγεί συνήθως σε απόλυτη έλλειψη ινσουλίνης.
2. ΣΔ τύπου 2 (ΣΔτ2): αφορά το ~90% και οφείλε ται κυρίως στην παχυσαρκία και την αντίσταση στην ινσουλίνη, η οποία προκαλεί προοδευτική ανεπάρκεια έκκρισης ινσουλίνης από τα β-κύτταρα. 3. ΣΔ κύησης: εμφανίζεται στο 2ο ή στο 3ο τρίμηνο της κύησης. Η εμφάνιση ΣΔ στο 1ο τρίμηνο της κύησης αφορά εκδήλωση ΣΔτ2 (σπανιότερα ΣΔτ1), ο οποίος προϋπήρχε σε λανθάνουσα μορφή. 4. Ειδικοί τύποι ΣΔ οφειλόμενοι σε άλλα αίτια όπως γενετικές διαταραχές των β-κυττάρων που οδη γούν σε μειωμένη έκκριση ινσουλίνης (μονογονιδιακός ΣΔ ο οποίος περιλαμβάνει τον νεογνικό ΣΔ και τον ΣΔ
120 |
Ο ΣΑΚΧΑΡ Ω ΔΗΣ ΔΙΑΒ Η ΤΗΣ (ΣΔ) ταξινομείται στις εξής κατηγορίες:
τύπου MODY), νοσήματα της εξωκρινούς μοίρας του παγκρέατος (κυστική ίνωση, παγκρεατίτις) και ΣΔ προ καλούμενος από φάρμακα, κυρίως γλυκοκορτικοειδή και αντιψυχωσικά. Σύμφωνα με τη Διεθνή Ομοσπονδία Διαβήτη, όσον αφορά τους ενήλικες, 463 εκατομμύρια άτομα εμφα νίζουν ΣΔ (~10% του παγκόσμιου πληθυσμού), με τα 2/3 να αφορούν παραγωγικές ηλικίες και το 40,7% να παραμένει αδιάγνωστο. Ο αριθμός αυτός υπολογίζεται ότι θα ξεπεράσει τα 578,4 εκατομμύρια το 2030 και η μεγαλύτερη αύξηση αναμένεται να συμβεί σε χώρες και περιοχές χαμηλού ή μέσου εισοδήματος. Ο αριθμός των θανάτων στον ΣΔ υπολογίζεται στα 4,2 εκατομμύρια παγκοσμίως με κύρια αιτία τα καρδιαγγειακά επεισό δια. Το ετήσιο συνολικό κόστος υγείας για τα άτομα αυτά υπολογίζεται στα 763 δισεκατομμύρια δολάρια (το κόστος είναι ~2πλάσιο από το αντίστοιχο σε άτομα χωρίς ΣΔ), με το μεγαλύτερο τμήμα αυτού του ποσού να αφορά τη διαχείριση των χρόνιων επιπλοκών της νόσου. Ο αριθμός των ατόμων με διαταραχή ανοχής στη γλυκόζη (προδιαβήτης) υπολογίζεται στα 373,9 εκα τομμύρια, με το 48,1% να αφορά ηλικίες κάτω των 50 ετών. Στην Ευρώπη, το ποσοστό του ΣΔ είναι ~9%. Στην Ελλάδα, η επίπτωση του ΣΔτ2 είναι ~10% χω ρίς διαφορές μεταξύ των δύο φύλων. Η πιθανότητα εμφάνισης προδιαβήτη ή έκδηλου ΣΔτ2 αυξάνεται με το βάρος και την ηλικία, ενώ μειώνεται με τη σωματική δραστηριότητα/άσκηση και την αποφυγή παχυσαρκί ας. Το συνολικό κόστος/ασθενή/έτος για τη διαχείριση του ΣΔ στην Ελλάδα έχει υπολογισθεί στις 6.366 ευρώ για τα ρυθμισμένα (HbA1c<7%) και 7.783 ευρώ για τα αρρύθμιστα άτομα (HbA1c>7%), με τη διαφορά του κόστους να οφείλεται κατά 48% στη διαχείριση των καρδιαγγειακών επιπλοκών. Όσον αφορά τον ΣΔ σε παιδιά και εφήβους, ο ΣΔτ1 παρουσιάζει ανοδική πορεία με αύξηση ~3% κάθε χρόνο (ιδιαίτερα σε ηλικίες <15 ετών). Διεθνώς, ο συνολικός Πώς να προλάβετε και να αντιμετωπίσετε τον ΣΑΚΧΑΡ Ω ΔΗ ΔΙΑΒ Η ΤΗ !
αριθμός των περιστατικών με ΣΔτ1 σε αυτές τις ηλικί ες υπολογίζεται σε 1.110.100, με 128.900 καινούργια περιστατικά να προστίθενται/έτος. Η Ευρώπη (κυρίως
Φινλανδία-Σουηδία) εμφανίζει το υψηλότερο ποσοστό
ΣΔτ1 στον κόσμο με 25.000 καινούργια περιστατικά/ έτος. Ανοδική τάση σε παιδιά και εφήβους παρουσιάζει και ο ΣΔτ2, αλλά δεν υπάρχουν ακόμα έγκυρες διεθνείς στατιστικές. Οι κυριότερες αιτίες για την εμφάνιση του ΣΔτ2 στις μικρές ηλικίες είναι η παχυσαρκία και η καθι στική ζωή, με την Ελλάδα να έχει τα πρωτεία. Ο κίνδυνος είναι μεγάλος διότι οι χρόνιες επιπλοκές του ΣΔτ2 θα εμφανίζονται πλέον πολύ νωρίτερα, με

τον κίνδυνο εμφάνισης ΣΔτ2 κατά 58%. Η διάγνωση του προδιαβήτη γίνεται εύκολα αν τα άτομα που ανήκουν σε ομάδες υψηλού κινδύνου υποβληθούν έγκαιρα σε «καμπύλη γλυκόζης». Η παραδοσιακή άποψη ότι ο ΣΔτ2 εμφανίζεται μόνο σε ενήλικες και ο ΣΔτ1 μόνο σε παιδιά δεν ισχύει πλέον, καθόσον και οι δύο τύποι ΣΔ μπορούν να εμφανισθούν σε όλες τις ηλικίες. Επιπλέον, η παχυσαρκία, χαρακτη ριστικό γνώρισμα του ΣΔτ2, εμφανίζεται και στον ΣΔτ1 τόσο στα παιδιά/εφήβους όσο και στους ενήλικες. ΤΑ ΣΥΜΠΤΩ ΜΑΤΑ ΚΑΙ Η ΔΙ Α ΓΝΩΣΗ Ο ΣΔτ2 αναπτύσσεται σταδιακά για πολλά χρόνια (πάνω από 10) χωρίς να προειδοποιεί. Τα συμπτώματα είναι
αλλα
τρόπο ζωής, όπως μείωση της παχυσαρκίας (τουλάχιστον 10-15%) και αύξηση της σωματικής δρα στηριότητας. Είναι εντυπωσιακό ότι 30 λεπτά μέτριας φυσικής δραστηριότητας κάθε μέρα (ζωηρό περπάτημα, ήπιο τρέξιμο ή άλλης μορφής αερόβια άσκηση) μειώνει
ασαφή και μικρής έντασης όπως δίψα, ξηροστομία, πολυουρία/νυκτουρία, έντονο αίσθημα κόπωσης/εξά ντληση, υπερφαγία/προτίμηση σε γλυκές τροφές, ανε ξήγητη απώλεια βάρους, θόλωση όρασης, λοιμώξεις γεννητικών οργάνων (κνησμός αιδοίου, βαλανοποσθί τις), κεφαλαλγία, ζάλη, αλλαγή διάθεσης, ευερεθιστό τητα, δυσκολία συγκέντρωσης. Μπορεί όμως να μην υπάρχουν καθόλου συμπτώματα και ο ΣΔτ2 να βρεθεί τυχαία σε γενικές εξετάσεις αίματος που γίνονται για άλλη αιτία ή για έλεγχο ρουτίνας. Τέλος, πολλές φο ρές ο ΣΔτ2 ανακαλύπτεται από τις επιπλοκές του, όπως νεφρική ανεπάρκεια, καρδιαγγειακή νόσος, αμφιβλη στροειδοπάθεια, νευροπάθεια. Τα κριτήρια για την εργαστηριακή διάγνωση στηρί ζονται στις μετρήσεις γλυκόζης νηστείας και επί αμφι βολίας για τη διάγνωση γίνεται «καμπύλη γλυκόζης». H εξέταση αυτή είναι ιδιαίτερα χρήσιμη σε ομάδες
| 121 | ΔΙΑΒΗΤΗΣ
καταστροφικά αποτελέσματα. Όσον αφορά την πρόληψη του ΣΔτ1, είναι προς το παρόν τουλάχιστον δύσκολη, διότι δεν έχουν διευκρι νισθεί οι παθογενετικοί μηχανισμοί που προκαλούν την καταστροφή των β-κυττάρων. Η έλλειψη θηλασμού και η χορήγηση αγελαδινού γάλακτος στα νεογνά είχαν ενοχοποιηθεί για τη δημιουργία αντισωμάτων και πυ ροδότηση του ανοσοποιητικού μηχανισμού, αλλά κάτι τέτοιο πλέον δεν ισχύει. Σε αντίθεση με τον ΣΔτ1, η πρόληψη του ΣΔτ2 είναι εφικτή. Οι παθογενετικοί μηχανισμοί που τον προκα λούν έχουν διευκρινισθεί και ο ΣΔτ2 στους ενήλικες
ή στα παιδιά μπορεί να προληφθεί, αν μπει έγκαιρα η διάγνωση στο στάδιο του προδιαβήτη και γίνουν
γές στον
υψηλού κινδύνου για την έγκαιρη διάγνωση του ΣΔτ2 όταν αυτός βρίσκεται ακόμα στο στάδιο του προδια βήτη, παρέχοντας ένα άριστο εργαλείο για την πρόλη ψη της νόσου. Η Αμερικανική Διαβητολογική Εταιρεία προτείνει ως κριτήριο διάγνωσης και τις τιμές γλυκο ζυλιωμένης αιμοσφαιρίνης >6,5, με την προϋπόθεση ότι δεν υπάρχουν στον ασθενή αιμοσφαιρινοπάθειες, χρόνια νεφρική νόσος ή πρόσφατη μετάγγιση και η μέτρηση έχει γίνει σύμφωνα με τα διεθνώς πιστοποι ημένα πρότυπα. Στα παιδιά, ο ΣΔτ1 εμφανίζεται τυπικά με πολυου ρία-πολυδιψία-πολυφαγία-απώλεια βάρους και περί που στο 1/3 των περιπτώσεων με κετοξέωση. Στους ενήλικες, όμως, η εμφάνιση του ΣΔτ1 ποικίλλει και τα κλασικά συμπτώματα που αναφέρθηκαν στα παιδιά μπορεί να είναι ασαφή ή να μην υπάρχουν, με απο τέλεσμα τη δυσκολία της ορθής διάγνωσης. Ο λόγος είναι ότι οι ενήλικες με ΣΔτ1, παρά την αυτοάνοση καταστροφή, συνήθως διατηρούν κάποιο ποσοστό ενεργών β-κυττάρων για πολλά χρόνια, με αποτέ λεσμα να μην παρατηρούνται η ραγδαία πορεία της έλλειψης ινσουλίνης και τα θορυβώδη συμπτώματα που παρατηρούνται στα παιδιά. Κατά την κλινική διάγνωση του ΣΔτ1 ανιχνεύονται ένα ή περισσότερα αυτοαντισώματα. Η επιθετικότητα του ανοσοποιητικού μηχανισμού και η ταχύτητα κατα στροφής των β-κυττάρων στη φυσική πορεία εξέλιξης της νόσου είναι ανάλογες του αριθμού των αυτοαντι σωμάτων τα οποία βρίσκονται θετικά στις εργαστηρια κές εξετάσεις. Τα αυτοαντισώματα μπορούν επίσης να βοηθήσουν στην ταυτοποίηση ατόμων υψηλού κινδύνου
για την ανάπτυξη ΣΔτ1 (συγγενείς 1ου βαθμού). Η διάγνωση του ΣΔ κύησης τίθεται με την «καμπύλη γλυκόζης» στις 26-28 εβδομάδες της κύησης. Η σύγχρονη προσέγγιση της θεραπευτικής αντιμετώ πισης του ΣΔτ2 βασίζεται στην εξατομίκευση με επιλογή στοχευμένων φαρμακευτικών συνδυασμών ανάλογα με τις παθογενετικές διαταραχές που ευθύνονται για την υπεργλυκαιμία, τη μεταβολική απορρύθμιση, τις συν νοσηρότητες που υπάρχουν, την παχυσαρκία και την τάση για υπογλυκαιμίες. Σήμερα, υπάρχουν πολλά καινούργια φάρμακα για τον ΣΔ, όπως πρωτοποριακά ανάλογα ινσουλίνης μα κράς και ταχείας δράσης, ινσουλίνη μακράς δράσης που χορηγείται 1 φορά την εβδομάδα, μιμητικά ινκρετινών (από του στόματος χορηγούμενοι αναστολείς DPP4 και ενέσιμοι αγωνιστές υποδοχέων GLP-1) και αναστολείς SGLT2 μεταφορέων. Τα σκευάσματα αυτά έχουν βο ηθήσει στην καλύτερη ρύθμιση του ΣΔ και πρέπει να χορηγούνται αυστηρά με τις συστάσεις και την τακτική παρακολούθηση από τους θεράποντες ιατρούς. Οι εξελίξεις στην τεχνολογία έχουν δώσει εξελιγ μένους αισθητήρες συνεχούς μέτρησης της γλυκόζης στον υποδόριο ιστό σε πραγματικό χρόνο ή αναδρομι κά, νέους μετρητές γλυκόζης τριχοειδικού αίματος από το δάκτυλο, πρωτοποριακές αντλίες συνεχούς χορή γησης ινσουλίνης και το πρώτο τεχνητό πάγκρεας. Οι επιλογές για τη θεραπεία περιγράφονται λεπτομερώς υπό μορφή πρακτικών πινάκων στις «Κατευθυντήριες Οδηγίες για τη Διαχείριση του Σακχαρώδους Διαβήτη 2022» της «Ελληνικής Διαβητολογικής Εταιρείας», με ελεύθερη πρόσβαση στο Διαδίκτυο. ■
Πανεπιστήμιο Οξφόρδης (1986-1988). Ήταν μέλος της Εκτελεστικής Επιτροπής του «European Association for the Study of Diabetes» (EASD, 2002-2005) και γενικός γραμματέας της Οργανωτικής Επιτροπής του 41ου Ετήσιου Συνεδρίου του EASD στην Αθήνα το 2005. Από το 2010-2019 ήταν διευθυντής της Β’ Προπαιδευτικής Παθολογικής Κλινικής, Μονάδας Έρευνας και Διαβητολογικού Κέντρου ΕΚΠΑ στο ΠΓΝΑ «Αττικόν». Το
122 |
ΓΕΏΡΓΙΟΣ Δ. ΔΗΜΗΤΡΙ Α ΔΗΣ Ο Γεώργιος Δ. Δημητριάδης, MD, DPhil (Oxford), είναι ομ. καθηγητής Παθολογίας και Μεταβολικών Παθήσεων ΕΚΠΑ, αντιπρόεδρος Ινστιτούτου Εφαρμοσμένης Φυσιολογίας & Άσκησης στην Ιατρική, τ. πρόεδρος
Διαβητολογικής Εταιρείας. Γεννήθηκε στην Αθήνα και πήρε το πτυχίο Ιατρικής από το Πανεπιστήμιο Αθηνών και το PhD στο Μεταβολισμό από το Πανεπιστήμιο της Οξφόρδης. Ήταν Research Fellow στο Τμήμα Ενδοκρινολογίας και Σακχαρώδους Διαβήτη στη Mayo Clinic (Πανεπι στήμιο Μινεαπόλεως, Μινεσότα, ΗΠΑ 1980-83) και στο Τμήμα Βιοχημείας και Κυτταρικού Μεταβολισμού,
2015-2017 ήταν διευθυντής του Τομέα Παθολογίας της Ιατρικής Σχολής του ΕΚΠΑ. Από το 2016-2019 ήταν μέλος της Επιτροπής Εκπαίδευσης-Μετεκπαίδευσης του ΚΕΣΥ, από το 2017-2020 αναπληρωτής συντονιστής της Επιτροπής Σακχαρώδους Διαβήτη του ΚΕΣΥ και από το 2017-σήμερα συντονιστής της Επιστημονικής Ομάδας Εργασίας Σακχαρώδους Διαβήτη της Γενικής Γραμματείας του υπουργείου Υγείας. Είναι κριτής εργασιών σε πάνω από 30 ξενόγλωσσα ιατρικά περιοδικά. Έχει πάνω από 200 δημοσιεύσεις σε ξενόγλωσσα ιατρικά περιοδικά μετά από κρίση (peer review) και βιβλία, και 9.664 αναφορές στη διεθνή βιβλιογραφία.
Ελλη νικής
ΡΕΤΑΙ στο Γ.Ν. Ασκληπιείο Βούλας, το οποίο θα στεγάσει 6 Νοσηλευτικές Μονάδες δυναμι κότητας 115 κλινών, οι οποίες κατά την παρούσα χρονική περίοδο είναι διάσπαρτες στο νοσοκομείο. Ειδικότερα το έργο προϋπολογισμού 10.000.000 ευρώ αφορά την κατασκευή και τον εξοπλισμό ενός τετραώροφου κτιρίου (περιλαμβανομένου του ισογεί ου), με συνολική επιφάνεια 5.500 m². Στη νέα δομή οι νοσηλευτικές κλίνες θα είναι συνδεδεμένες με το κεντρικό κτίριο στο οποίο στεγάζονται όλοι οι κρίσιμοι χώροι του νοσοκομείου: Επείγοντα Περιστατικά (ΤΕΠ), Χειρουργεία, Μονάδα Εντατικής Θεραπείας (ΜΕΘ/Χ), Ακτινολογικό, Αιμοδυναμικό, αξονικός, εργαστήρια. Η σύνδεση του υφιστάμενου κεντρικού κτιρίου με το νέο κτίριο θα πραγματοποιηθεί με γέφυρες σύνδε σης ανά όροφο. Ως εκ τούτου, θα επιτευχθεί η ασφα λέστερη, ταχύτερη και οικονομικά συμφερότερη παρο
ο
Πλεύρης δήλωσε: «Θεωρούμε ότι σε συνεργασία και με τις δωρεές θα μπορούμε να έχουμε μέχρι το 2025 μία πολύ καλύτερη εικόνα στην κτιριακή υποδομή των νοσοκομείων». Παράλληλα, ο πρόεδρος του ΕΕΣ Αντώνης Αυγερι νός δήλωσε: «Η δωρεά αυτή μας τιμά ιδιαίτερα διότι αφορά το εμβληματικό Νοσοκομείο Ασκληπιείο Βού λας, ένα νοσοκομείο με λαμπρή φήμη και αίγλη. Ειδικά από το 1923 (έτος απόκτησης του νοσοκομείου από τον ΕΕΣ) και μετέπειτα, με αποκορύφωμα το Έπος του

’40-41, στο νοσοκομείο αυτό νοσηλεύτηκαν, με αδιά πτωτη φροντίδα και με μοναδική στοργή και αγάπη, εκατοντάδες χιλιάδες ασθενείς και τραυματίες, με την ιδιαίτερη περιποίηση της Νοσηλευτικής Υπηρεσίας του ΕΕΣ. Το έργο αυτό, μετά την ολοκλήρωσή του, θα με ταλαμπαδεύσει σε όλους μας τα ευγενή αισθήματα, τη μεγαλοψυχία, τη μεγαλοκαρδία και τη φιλοπατρία των ευγενών και σεμνών δωρητών που συνεχίζουν επαξί ως το έργο των μεγάλων ευεργετών του Έθνους». Από την πλευρά των δωρητών, η Ιωάννα Μαρτίνου τόνισε: Σήμερα θεμελιώνουμε ένα υπερσύγχρονο νο σοκομείο που θα πληροί όλες τις προδιαγραφές και όλα τα διεθνή πρότυπα λειτουργίας. Θεμελιώνουμε ένα νοσοκομείο για το οποίο δεσμευόμαστε πως θα δουλέψουμε σκληρά για να παραδοθεί στην κοινωνία το συντομότερο δυνατό. Θεμελιώνουμε ένα στολίδι που θα προσφέρει

| 123 Ν ΕΟ ΚΤ Ι ΡΙΟ
μετακινήσεις
περιφερειακά
ΑΝΑΓΕ Ι
χή υπηρεσιών υγείας και θα αποφευχθούν οι άσκοπες
ασθενών και προσωπικού από και προς διάσπαρτα
κτίρια. Κατά τη διάρκεια της τελετής θεμελίωσης του κτι ρίου,
υπουργός Υγείας Θάνος
ισότιμη πρόσβαση σε ποιοτικές υπηρεσίες ιατρικής φροντίδας και περίθαλψης σε όλους τους κατοίκους». ■ Γ.Ν. ΑΣΚΛΗΠΙΕ Ι Ο ΒΟΥΛΑΣ Ανέγερση νέου κτιρίου δωρεά της οικογένειας Κων/νου Μαρτίνου
σύγκριση με τα άτομα χωρίς σακχαρώδη διαβήτη, η νέα εκστρατεία με τίτλο #EinaiStoDikoSouΧeri φιλοδοξεί, με


όχημά

«Ο σακχαρώδης διαβήτης μπορεί να μπει στη ζωή του καθενός μας, το έχει ήδη κάνει στις ζωές περίπου 1 εκατ. συμπολιτών μας. Υπάρχουν ωστόσο τρόποι να το αποτρέψουμε αυτό, αλλά και να το διαχειριστού με αποτελεσματικά, εφόσον μας συμβεί. Η σωματική άσκηση, η σωστή διατροφή και η διαχείριση του σω ματικού
βάρους, ώστε
124 | ΜΙΑ Ν Ε Α
να
ΕΚΣΤΡΑΤΕ Ι Α ΕΝΗΜ Ε ΡΩΣΗΣ τη νόσο της πα χυσαρκίας, είναι τα εργαλεία που θα μας βοηθήσουν #EinaiStoDikoSouXeri να προλάβεις τις επιπλοκές του σακχαρώδους διαβήτη! Η κ. Μαίρη Καραγεώργου.
και ευαισθητο ποίησης του γενικού κοινού για τον σακχαρώδη διαβή τη και τις επιπτώσεις του στο καρδιαγγειακό σύστημα παρουσίασαν η Νοvo Nordisk Hellas και η ΑΜΚΕ «Με Οδηγό τον Διαβήτη». Με δεδομένο ότι τα άτομα με σακχαρώδη διαβήτη τύπου 2 έχουν 2 έως 4 φορές περισσότερες πιθανότη τες να εμφανίσουν έμφραγμα του μυοκαρδίου ή αγγει ακό εγκεφαλικό επεισόδιο, σε
κύριο
της τα social media, να ενημερώσει κοινό και ασθενείς για την πρόληψη των επικίνδυνων επιπλοκών του σακχα ρώδoυς διαβήτη, όπως εκείνων στο καρδιαγγειακό σύστημα, αλλά και τη νόσο της παχυσαρκίας. Άλλωστε, μόλις το 50% των ατόμων με σακχαρώδη διαβήτη τύπου 2 αναγνωρίζει ότι έχει αυξημένο κίνδυ νο εμφάνισης καρδιαγγειακής νόσου. Σε εκδήλωση που πραγματοποιήθηκε ανήμερα της Παγκόσμιας Ημέρας Διαβήτη στις 14 Νοεμβρίου 2022, ο Ολύμπιος Παπαδημητρίου, γενικός διευθυντής της Novo Nordisk Hellas και πρόεδρος του ΣΦΕΕ, τόνισε:
αποφύγουμε
Aπό αριστερά, ο κ. Ολύμπιος Παπαδημητρίου, ο κ. Αντώνιος Λέπουρας, η κ. Αναστασία Καφούση, η κ. Μαίρη Καραγεώργου και η κ. Αθηνά Ζώτου.
να αποτρέψουμε την εμφάνιση του διαβήτη. Αλλά ακό μη και αν μας συναντήσει ο διαβήτης, χρησιμοποιώ ντας τα ίδια εργαλεία καθώς και αποκτώντας γνώση
και εκπαίδευση για το πώς επηρεάζει το καρδιαγγεια κό μας σύστημα και το πώς μπορούμε να αποφύγουμε τις επιπλοκές που προκαλεί, θα καταφέρουμε να τον διαχειριστούμε αποτελεσματικά. Τελικά, σε πολύ μεγά λο βαθμό, “Είναι στο Δικό μας Χέρι!”». «Τα άτομα με σακχαρώδη διαβήτη εμφανίζουν σοβαρές συννοσηρότητες για τις οποίες απαιτούνται γνώσεις και συνεργασία μεταξύ πολλών ειδικοτήτων για να υπάρξει σφαιρική και αποτελεσματική αντιμε τώπιση. Ας μην ξεχνάμε ότι η πανδημία, για λόγους μη γνωστούς, αυξάνει την επίπτωση του σακχαρώδους διαβήτη και ενώ φαίνεται να υποχωρεί, τα άτομα με σακχαρώδη διαβήτη εξακολουθούν να χρειάζονται να διατηρούν ευγλυκαιμία, να αντιμετωπίζουν καρδιαγ γειακούς κινδύνους, κακοήθειες, νεφρικά, αγγειακά, οφθαλμολογικά και νευρολογικά προβλήματα», σημεί ωσε ο Αντώνιος Λέπουρας, παθολόγος - διαβητολό γος, διευθυντής Παθολογικής-Διαβητολογικής Κλινι κής, υπεύθυνος Διαβητολογικού Κέντρου και εξωτερι κών ιατρείων σακχαρώδους διαβήτη του Metropolitan General. Ο Σπύρος Σαπουνάς, ενδοκρινολόγος διαβητολό γος, αντιπρόεδρος Μη Μεταδοτικών Νοσημάτων του ΕΟΔΥ, ανέφερε στην τοποθέτησή του: «Τα άτομα με σακχαρώδη διαβήτη έχουν αυξημένο κίνδυνο να κα ταλήξουν από τη νόσο της Covid-19 και χρειάζεται να παραμείνουν πολύ μεγαλύτερο χρονικό διάστημα

ότι «η πανδημία δεν έχει τελειώσει και οι νοσήσεις είναι πολλές ακόμη», συστή νοντας στα άτομα με σακχαρώδη διαβήτη «να προ στατεύονται από την μόλυνση από τον ιό, να εμβολιά
ζονται με όλες τις αναμνηστικές δόσεις, να ελέγχονται για έγκαιρη ανίχνευση της λοίμωξης και να φροντίζουν για την καλή ρύθμιση του σακχάρου τους». Την εκστρατεία «#EinaiStoDikoSouXeri» παρουσί ασε η διευθύντρια Εταιρικών Υποθέσεων της Novo Nordisk Hellas, Μαίρη Καραγεώργου, σημειώνοντας: «Θέλουμε οι ασθενείς με σακχαρώδη διαβήτη τύπου 2 και οι οικείοι τους να καταλάβουν ότι αν αφήσουν τον σακχαρώδη διαβήτη ανεξέλεγκτο θα αντιμετωπίσουν μεγαλύτερα προβλήματα στο μέλλον και ότι η έγκαιρη διάγνωση ισοδυναμεί με καλύτερη ποιότητα ζωής». Κεντρικό πρόσωπο της καμπάνιας είναι η γνωστή ηθοποιός Αθηνά Ζώτου, η οποία θα αναλάβει να «πε ράσει» τα βασικά μηνύματα της εκστρατείας στο ευρύ κοινό. Στην εκδήλωση παρουσίασης της εκστρατείας παραβρέθηκαν και απηύθυναν χαιρετισμό ο περιφε ρειάρχης Αττικής Γιώργος Πατούλης και ο εκπρόσω πος του υπουργείου Υγείας Παναγιώτης Τσίγγανος, δι ευθυντής του Γραφείου της υφυπουργού Υγείας Ζωής Ράπτη. Επίσης, η Αναστασία Μαυρογιαννάκη, πρόεδρος της Ελληνικής Διαβητολογικής Εταιρείας, ο Γεράσιμος Σιάσος, πρόεδρος Ιατρικής Σχολής Αθηνών & πρόε δρος Ομάδας Εργασίας Καρδιά και Διαβήτης της Ελ ληνικής Καρδιολογικής Εταιρείας, και ο Ευθύμιος Κα πάνταης, γενικός γραμματέας της Ελληνικής Ιατρικής Εταιρείας Παχυσαρκίας. Η εκστρατεία τελεί υπό την αιγίδα της Περιφέρειας Αττικής, του Δήμου Αθηναίων, της Ελληνικής Διαβητο λογικής Εταιρείας (ΕΔΕ), της Ελληνικής Ενδοκρινολογι κής Εταιρείας, της Ελληνικής Καρδιολογικής Εταιρείας (ΕΚΕ) και της Ελληνικής Ιατρικής Εταιρείας Παχυσαρ κίας (ΕΙΕΠ). ■
| 125
νοσηλευόμενοι. Πρόσθεσε
ΟΛΟΚΛΗΡ Ω ΘΗΚΕ ΠΡ ΟΣΦΑΤΑ στο Ηράκλειο Κρήτης η πρώτη φάση του εκπαιδευτικού προγράμματος «Εν συναίσθηση, Ενδυνάμωση, Επικοινωνία» με στόχο την ενδυνάμωση του πνευμονολόγου και τη βελτίωση της επικοινωνίας του με τον ασθενή μέσω της ενσυναί σθησης. Πρόκειται για μια πρωτοβουλία της Ελληνικής Πνευμονολογικής Εταιρείας (ΕΠΕ) που πραγματοποι είται με την ευγενική χορηγία της βιοφαρμακευτικής εταιρείας Chiesi Hellas. Το εν λόγω εκπαιδευτικό πρόγραμμα ξεκίνησε στις αρχές του 2022 με δύο workshops στην Αθήνα και στη


όπως η ανα κοίνωση δυσάρεστων νέων σε ασθενείς. Εκπαιδεύθη καν συνολικά περισσότεροι από 80 πνευμονολόγοι και η
πολλούς επαγγελματίες υγείας, η επαγγελματική εξουθένωση, αλλά και οι δύσκολες συνθήκες εργασί ας, ειδικά κατά την πανδημία, έχουν επηρεάσει την ψυ χική τους κατάσταση και κατ’ επέκταση
126 |
σε Θεσσαλονίκη
ήταν να εκπαιδευθούν οι
τόσο σε τεχνικές διαχείρισης του καθημερινού στρες και της έλλειψης χρόνου όσο και σε τεχνικές που τους βοηθούν να επιτύχουν μια αποτελεσματική επικοινω νία με διαφορετικές περιπτώσεις ασθενών, επιδεικνύ οντας ενσυναίσθηση. Στη συνέχεια και λαμβάνοντας υπόψη τις ανάγκες των συμμετεχόντων, το πρόγραμμα εμπλουτίστηκε με επιπλέον θεματολογία,
ανταπόκριση ήταν εξαιρετική. ΓΙΑΤ Ι ΑΥΤΟ ΤΟ ΠΡ Ο ΓΡΑΜΜΑ Ε Ι ΝΑΙ ΑΠΑΡΑ Ι ΤΗΤΟ
ο
Μπακάκος, ειδικός γραμμα τέας
τους με τον ασθενή. Η ΕΠΕ, αντιλαμβανόμενη αυτή την επιβάρυνση ΕΛΛΗΝΙΚΗ ΠΝΕΥΜΟΝΟΛΟΓΙΚΗ ΕΤΑΙΡΕΙΑ Εκπαιδευτικό πρόγραμμα για τη βελτίωση της επικοινωνίας πνευμονολόγου - ασθενούς! Ο κ. Πέτρος Μπακάκος, ειδικός γραμματέας ΕΠΕ, καθηγητής Πνευμονολογίας, η κ. Ελισάβετ Κάλμπαρη, Neuropsychologist-Healthcare Professional & Leadership Trainer - Founder of Self Balance, και η κ. Νικολέτα Ροβίνα, μέλος Δ.Σ. ΕΠΕ, αναπληρώτρια καθηγήτρια Πνευμονολογίας - Εντατικής Θεραπείας, Ιατρική Σχολή ΕΚΠΑ.
συνέχεια επεκτάθηκε
και Κρήτη. Ο αρ χικός στόχος
πνευμονολόγοι
Όπως δήλωσε
Πέτρος
ΕΠΕ, καθηγητής Πνευμονολογίας, Α’ Πανεπιστη μιακή Πνευμονολογική Κλινική, Ιατρική Σχολή ΕΚΠΑ, «για
την επικοινωνία
και πηγαίνοντας ένα βήμα παρακάτω, πέρα από τους βασικούς σκοπούς μας, που είναι η εκπαίδευση των γιατρών στα νεότερα δεδομένα για την αντιμετώπιση των παθήσεων του αναπνευστικού συστήματος, δη μιούργησε αυτό το πρόγραμμα. Ένα πρόγραμμα που απευθύνεται σε όλους τους πνευμονολόγους, ανεξαρ τήτως του αν εργάζονται στον δημόσιο ή στον ιδιωτικό τομέα, καθώς όλοι πρέπει να κατανοήσουμε ότι ο ειλι κρινής διάλογος μεταξύ ενός ψυχικά ισορροπημένου γιατρού και ασθενούς μπορεί να
— «Μας βοήθησε να κατανοήσουμε και τον ασθενή μας και την επικοινωνία μαζί του» Α.Κ.
— «Έμαθα ότι δεν είμαι μόνο γιατρός, είμαι και άν θρωπος» Σ.Μ. — «Είναι σημαντικό να εφαρμόσουμε αυτές τις γνώ σεις στην καθημερινότητά μας» Ι.Τ. — «Να επεκταθεί σε όλους τους επαγγελματίες υγεί ας, μας κάνει καλύτερους» Ε.Μ. Για τη δράση αυτή η Παναγιώτα Γιαννοπούλου, Customer Experience Manager της Chiesi Hellas, δήλω σε τα εξής: «Ως επαναπιστοποιημένη BCorp εταιρεία, είμαστε ιδιαίτερα χαρούμενοι και υπερήφανοι στην Chiesi Hellas που επιχορηγούμε το εκπαιδευτικό πρό γραμμα “Ενσυναίσθηση, Ενδυνάμωση, Επικοινωνία”, συμβάλλοντας
αφού
της εταιρείας μας να θέτουμε στο επίκεντρο τον ασθενή και τον επαγγελ ματία υγείας και να δημιουργούμε αξία για τον οργα νισμό και την κοινωνία». Για να λάβετε περισσότερες πληροφορίες για το πρόγραμμα και να δείτε τα πρώτα σχόλια
για την ενδυνάμωση του επαγγελματία υγείας και για τη βελτίωση της επικοινωνίας του με τον ασθενή» Γ.Χ.

| 127 | ΕΚΠΑΙΔΕΥΤΙΚΟ ΠΡΟΓΡΑΜΜΑ
μας οδηγήσει στον τελικό στόχο, που δεν είναι άλλος από την αποτελε σματική διαχείριση των νοσημάτων και τη βελτίωση της ποιότητας ζωής των ασθενών». ΤΙ Ε Ι ΠΑΝ ΟΙ ΣΥΜΜΕΤ Ε ΧΟΝΤΕΣ ΓΙΑ ΤΟ ΠΡ Ο ΓΡΑΜΜΑ Τόσο οι νοσοκομειακοί όσο και οι ιδιώτες πνευμονο λόγοι σε όλη την Ελλάδα αγκάλιασαν με ενθουσιασμό την πρωτοβουλία αυτή και τα σχόλια ήταν ενθαρρυ ντικά τόσο για το ίδιο το πρόγραμμα και τον τρόπο που υλοποιήθηκε όσο και για την ανάγκη μελλοντικών αντίστοιχων δράσεων. — «Πρόκειται για μια εξαιρετική πρωτοβουλία» Ζ.Μ. — «Αυτές οι δράσεις είναι πάρα πολύ σημαντικές
και
των
τεχόντων, μπορείτε να επισκεφθείτε την ιστοσελίδα της ΕΠΕ, στη διεύθυνση www.hts.org.gr/empathy ■ Η κ. Παναγιώτα Γιαννοπούλου, Customer Experience Manager, Chiesi Hellas, η κ. Παρασκευή Κατσαούνου, μέλος Δ.Σ. ΕΠΕ, αναπληρώτρια καθηγήτρια Πνευμονολογίας, Ιατρική Σχολή ΕΚΠΑ, η κ. Ελισάβετ Κάλμπαρη, Neuropsychologist- Healthcare Professional & Leadership Trainer Founder of Self Balance, και ο κ. Ηλίας Πυρνοκόκης, Head of Value, Access & External Affairs Chiesi Hellas.
με όλες μας τις δυνάμεις στην επιτυχή διοργάνωση
υλοποίηση της δράσης αυτής,
συνάδει απόλυτα με το όραμα
συμμε
Γράφει η ΟΛΓΑ ΛΥΜΠΕΡΟΠΟΥΛΟΥ, γνωστική
νευροψυχολόγος, M.Sc., ειδίκευση στην 3η Ηλικία και τις Άνοιες, υπεύθυνη Κέντρου Διαταραχών Μνήμης
δεν έχουν εφαρμογή μόνο στην περίοδο των Χριστουγέννων, αλλά και σε άλλες καταστάσεις που συνεπάγονται μεγάλες αλλαγές στο περιβάλλον και τη ρουτίνα του ανθρώπου που ξε χνά (Πάσχα, γενέθλια, γάμους συγγενικών προσώπων κ.λπ.).


128 | ΓΙΑ ΤΟΥΣ ΠΕΡΙΣΣΟΤΕΡΟΥΣ ΑΠ Ο ΕΜ Α Σ, τα Χριστού γεννα σημαίνουν γιορτινή ατμόσφαιρα, διασκέδαση, απολαυστικό φαγητό, δώρα και συναντήσεις με την οικογένεια και τους φίλους. Δεν ισχύει όμως το ίδιο και για τους ανθρώπους με άνοια και τις οικογένειές τους, οι οποίοι συχνά βιώνουν τα Χριστούγεννα ως τη δυσκολότερη και απαιτητικότερη εποχή του
Αν φροντίζετε έναν άνθρωπο με νόσο Αλτσχάιμερ ή κάποια άλλη μορφή άνοιας, οι παρακάτω συμβου λές θα βοηθήσουν και εσάς, αλλά και εκείνον να απο λαύσετε
την
των
λιγότερο άγχος.
χρόνου.
πραγματικά
περίοδο
γιορτών με όσο το δυνατόν
Μάλιστα, πολλές από τις συμβουλές που ακολουθούν
1 Δώστε μεγάλη προσοχή στο στολισμό του σπιτιού Ξεκινήστε να στολίζετε νωρίς και σταδιακά (π.χ. το ποθετήστε αρχικά το δέντρο, μετά από λίγες ημέρες προσθέστε μερικά στολίδια κ.ο.κ.), ώστε ο άνθρωπός σας να προσαρμοστεί ομαλά στον καινούργιο διάκο σμο. Οι μεγάλες αλλαγές στο χώρο όπου ζει και κινεί ται ένας άνθρωπος με νόσο Αλτσχάιμερ ή άλλη μορφή άνοιας προκαλούν σύγχυση. Επιλέξτε προσεκτικά τα διακοσμητικά στοιχεία. Ενώ οι περισσότεροι απολαμ βάνουμε τα φωτάκια που αναβοσβήνουν στο δέντρο, σε έναν άνθρωπο με άνοια ενδέχεται να προκαλέσουν σύγχυση και εκνευρισμό. Μη χρησιμοποιείτε διακοσμη τικά που μοιάζουν με τρόφιμα (π.χ. στολίδια σε σχήμα 16 συμβουλές για να απολαύσετε τα Χριστούγεννα με έναν άνθρωπο που ξεχνά!
μπισκότων), γιατί δεν αποκλείεται να μπερδέψουν τον άνθρωπο που ξεχνά. 2 Η συνεχής υπενθύμιση του γιορτινού προγράμματος δεν βοηθά Αποφύγετε να λέτε ξανά και ξανά στο αγαπημένο σας πρόσωπο ότι έρχονται τα Χριστούγεννα και να επανα λαμβάνετε τις δραστηριότητες που έχετε προγραμμα τίσει με την ελπίδα ότι έτσι θα το προετοιμάσετε για τις γιορτινές ημέρες. Αν θυμάται ότι του λέτε διαρκώς τα ίδια πράγματα θα εκνευριστεί, ενώ αν συνειδητο ποιήσει ότι είναι σαν να τα ακούει για πρώτη φορά θα αισθανθεί ντροπή και απογοήτευση. Ούτως ή άλλως, οι σχετικές συζητήσεις δεν θα βοηθήσουν στο να δια χειριστεί ο άνθρωπός σας καλύτερα την περίοδο των γιορτών.

3 Φτιάξτε ένα πλάνο Μην περιμένετε απλά να δείτε «πώς θα πάνε τα πράγ ματα», ελπίζοντας ότι στο τέλος όλα θα εξελιχθούν ομαλά. Το πώς ακριβώς θα διαμορφώσετε το πρό γραμμα των γιορτών εξαρτάται από τις ιδιαίτερες ανάγκες του αγαπημένου σας προσώπου. Δεν υπάρ χουν λύσεις που να ταιριάζουν σε όλους. Μία ερώτηση που μπορείτε να κάνετε στον εαυτό σας και που θα σας βοηθήσει να πάρετε τις σωστές αποφάσεις είναι
η εξής: «Αυτό που θέλω να προγραμματίσω είναι σε θέση να το απολαύσει ο άνθρωπός μου; Ή το επιδιώκω απλά, γιατί θα ήθελα όσο τίποτα να μπορούσε να το απολαύσει;».
4 Φτιάξτε ένα δεύτερο ή και ένα τρίτο εναλλακτικό πλάνο Είναι προτιμότερο να είστε προετοιμασμένοι ακόμα και για το χειρότερο σενάριο. Δεν είναι απαραίτητο να πάνε όλα στραβά, θα πρέπει όμως να είστε έτοιμοι -πρακτικά και ψυχικά- να αναπροσαρμόσετε τα σχέδιά σας, αν παραστεί ανάγκη. Για παράδειγμα, υπάρχει η πιθανότητα ο βομβαρδισμός ηχητικών και οπτικών ερεθισμάτων να προκαλέσει στον άνθρωπο που ξεχνά επιθετική συμπεριφορά. Να είστε προετοιμασμένοι να αποχωρήσετε εκτάκτως από το γιορτινό τραπέζι στο οποίο είστε καλεσμένοι ή να ζητήσετε από τους καλε σμένους σας να φύγουν νωρίτερα, αν οι οικοδεσπότες είστε εσείς.
5 Όσο πιο απλά τόσο το καλύτερο για όλους Αποδεχτείτε τις δυσκολίες και τους περιορισμούς της νόσου και διαμορφώστε το πρόγραμμά σας ανάλογα. Μπορεί π.χ. να συνηθίζατε να καλείτε στο σπίτι σας για το χριστουγεννιάτικο γεύμα τα μέλη της ευρύτερης οικογένειας. Δεν έχει καμία σημασία το πώς γιορτά ζατε τα Χριστούγεννα τα προηγούμενα χρόνια. Τώρα η κατάσταση είναι εντελώς διαφορετική. Φέτος ίσως θα ήταν προτιμότερο να περιοριστείτε σε ένα γεύμα με τους πολύ κοντινούς σας ανθρώπους. Αδιαφορή στε για τις προσδοκίες των υπολοίπων. Αυτό που έχει σημασία είναι να περάσετε ήρεμα και ευχάριστα τις γιορτές εσείς και ο άνθρωπος που φροντίζετε. 6 Ζητήστε τη βοήθεια των δικών σας ανθρώπων Πιθανότατα υπάρχουν στενοί φίλοι και συγγενείς που θα ήθελαν να σας βοηθήσουν, αλλά δεν μπορούν να διαβάσουν τη σκέψη σας και να μαντέψουν τι θα θέ λατε από αυτούς. Κάντε τα πράγματα πιο απλά για όλους, λέγοντάς τους ακριβώς το είδος της βοήθειας που χρειάζεστε. Η βοήθεια θα μπορούσε π.χ. να με ταφραστεί στο να κανονίσετε να είναι πάντα κάποιος δίπλα στο αγαπημένο σας πρόσωπο στο γιορτινό τρα πέζι ή θα μπορούσε να είναι καθαρά πρακτική (να σας βοηθήσουν στα ψώνια, στην προετοιμασία του σπι τιού, στο μαγείρεμα).
| 129 | ΑΝΟΙΑ
7 Εμπιστευτείτε το ένστικτό σας Θα έχετε ίσως παρατηρήσει ότι συχνά έχετε ένα προ αίσθημα σχετικά με το πώς πρόκειται να εξελιχθεί μια
κατάσταση, το οποίο πηγάζει από τη βαθιά γνώση των αναγκών του αγαπημένου σας προσώπου που ξεχνά. Αν, για παράδειγμα, αποδεχθήκατε με χαρά μια πρόσκλη ση για το ρεβεγιόν της Πρωτοχρονιάς, αλλά μια φωνή μέσα σας λέει ότι ο άνθρωπός σας δεν θα μπορέσει να διαχειριστεί ικανοποιητικά την επαφή με τόσο πολύ κό σμο, ακούστε τη και αλλάξτε εγκαίρως τα σχέδιά σας. 8 Ενημερώστε συγγενείς και φίλους για το πώς έχουν τα πράγματα Πολλές φορές στις χριστουγεννιάτικες συγκεντρώσεις συναντάμε αγαπημένους ανθρώπους με τους οποί ους δεν βρισκόμαστε συχνά. Γι’ αυτό είναι σημαντικό να τους μιλήσετε από πριν ανοιχτά για τις δυσκολίες που αντιμετωπίζει σε αυτή τη φάση ο άνθρωπος που ξεχνά, τις «παράξενες» συμπεριφορές που μπορεί να εκδηλώσει, αλλά και για τον κατάλληλο τρόπο να επι κοινωνήσουν μαζί του όταν συναντηθούν, ανάλογα με το στάδιο της νόσου.
9 Ενθαρρύνετε τον άνθρωπό σας να συμμετέχει στις προετοιμασίες Ο βαθμός συμμετοχής του εξαρτάται κυρίως από το στάδιο της νόσου στο οποίο βρίσκεται. Δώστε του την ευκαιρία να νιώσει χρήσιμος: προτείνετέ του να σας βοηθήσει να στολίσετε το δέντρο, να μαγειρέψετε για το γιορτινό τραπέζι, να διαλέξετε δώρα για τα αγα πημένα σας πρόσωπα. Αν δυσκολεύεται, δώστε του μια πιο απλή αρμοδιότητα, π.χ. να διπλώσει τις χαρτο πετσέτες ή να μετρήσει τα μαχαιροπίρουνα. Σε καμία περίπτωση μην τον αγνοήσετε ή μην τον αναγκάσετε να ασχοληθεί με κάτι, αν δεν το θέλει. Προσπεράστε ευγενικά λάθη και αστοχίες. 10 Δημιουργήστε νέες παραδόσεις με γνώμονα τις ικανότητες του ανθρώπου που ξεχνά Αν το αγαπημένο σας πρόσωπο δεν είναι πια σε θέση να στολίσει το δέντρο ή να φτιάξει μελομακάρονα και κουραμπιέδες, όπως έκανε τα προηγούμενα χρόνια, δεν πειράζει. Δημιουργήστε νέες οικογενειακές παρα δόσεις με βάση τα πράγματα που μπορεί ακόμα να κάνει καλά. Τραγουδήστε τα Κάλαντα. Δείτε φωτογρα φίες από Χριστούγεννα περασμένων ετών. Φτιάξτε χριστουγεννιάτικα στολίδια από χαρτί. Ενθαρρύνετε τα μικρότερα σε ηλικία μέλη της οικογένειας να συμμε τέχουν στις παραπάνω δραστηριότητες. Είναι βέβαιο πως θα το κάνουν με μεγάλη χαρά! 11
ξεφεύγετε από τη ρουτίνα φαγητού και ύπνου του αγα πημένου σας προσώπου. Οι αλλαγές στο πρόγραμμα που έχει συνηθίσει ενδέχεται να δημιουργήσουν συ ναισθήματα άγχους και ανασφάλειας, τα οποία με τη σειρά τους μπορεί να οδηγήσουν στην εκδήλωση δύ σκολων συμπεριφορών. Θυμηθείτε πως πάντα υπάρχει κι άλλος τρόπος για να γίνουν τα πράγματα. Αν π.χ. ο άνθρωπός σας έχει συνηθίσει να τρώει μεσημεριανό στη 1 το μεσημέρι, αλλά το χριστουγεννιάτικο γεύμα έχει προγραμματιστεί για τις 2:30, δώστε του ένα σνακ στη 1 και μια μικρή ποσότητα φαγητού στις 2:30. 12 Αποφύγετε τις διαμάχες σχετικά με τη φροντίδα του αγαπημένου σας προσώπου Ας το παραδεχτούμε: σχεδόν πάντα υπάρχει ένα μέλος της οικογένειας που παρά τη διάγνωση που έχει δώσει ο γιατρός επιμένει ότι ο άνθρωπός σας είναι μια χαρά ή που έχει διαφορετική άποψη για το είδος της φρο ντίδας που χρειάζεται. Όσο κι αν αισθάνεστε την ανά γκη να αντικρούσετε τα λεγόμενά του με συγκεκριμένα επιχειρήματα, μην το κάνετε στο γιορτινό τραπέζι. Όχι μόνο θα χαλάσει η ευχάριστη ατμόσφαιρα, αλλά επι πλέον θα προσκληθεί σύγχυση και αναστάτωση στο άτομο που φροντίζετε.
13 Εντοπίστε εγκαίρως τα σημάδια της κόπωσης Ειδικά στην περίπτωση που το αγαπημένο σας πρόσω πο βρίσκεται στα μεσαία ή προχωρημένα στάδια της νόσου και δεν είναι σε θέση να σας πει με σαφήνεια πότε και γιατί αισθάνεται δυσάρεστα, να είστε σε ετοι μότητα ώστε να αναγνωρίσετε τα «καμουφλαρισμένα» σημάδια της κόπωσης. Μια τέτοια ένδειξη θα μπορού σε να είναι οποιαδήποτε μη αναμενόμενη συμπεριφο ρά. Προβληματιστείτε αν ο άνθρωπός σας εκφράζει αδικαιολόγητο θυμό, ζητά επίμονα να πάει στο σπίτι του ή είναι ασυνήθιστα σιωπηλός. 14 Βοηθήστε τον άνθρωπο που ξεχνά να παραμείνει ήρεμος Ο πολύς κόσμος, η γιορτινή μουσική, οι ζωηρές συ ζητήσεις, τα γέλια, όσα για εμάς θεωρούνται κα λοδεχούμενη «αναστάτωση», για τον άνθρωπο που ξεχνά είναι ένας πραγματικός εφιάλτης. Αν νιώσετε ότι ο άνθρωπός σας έχει κουραστεί από τα τόσα ερε θίσματα, προτείνετέ του να αποσυρθεί για λίγο σε ένα ήσυχο δωμάτιο του σπιτιού. Ενθαρρύνετέ τον να ασχοληθεί με μία χαλαρωτική δραστηριότητα: να ξε φυλλίσει ένα άλμπουμ με φωτογραφίες, να ακούσει την αγαπημένη του μουσική, να ζωγραφίσει ή ακόμα και να κοιμηθεί.
130 |
Διατηρήστε τη ρουτίνα του ανθρώπου που ξεχνά Παρότι δεν είναι πάντα εύκολο, προσπαθήστε να μην
15 Προσπαθήστε να βλέπετε το ποτήρι μισογεμάτο
Ακόμα και αν έχετε προετοιμαστεί κατάλληλα και έχετε
προβλέψει κάθε πιθανό σενάριο, δεν αποκλείεται να πάει κάτι στραβά. Μπορεί ο άνθρωπος που φροντίζετε να έχει ένα ξέσπασμα θυμού μπροστά στους καλεσμέ νους σας. Ή την ώρα του δείπνου να πάρει από την πιατέλα ένα κομμάτι κρέας και να το φάει με το χέρι. Διαχειριστείτε το περιστατικό με ψυχραιμία, όπως θα κάνατε αν ήσασταν στο σπίτι οι δυο σας. Δεν πειράζει αν δεν είναι όλα τέλεια. Μια άβολη στιγμή δεν αρκεί για να χαλάσει την ευχάριστη, γιορτινή ατμόσφαιραεκτός κι αν εσείς το επιτρέψετε.
τό σας και να φορτίσετε τις μπαταρίες σας. Ζητήστε από ένα άτομο εμπιστοσύνης να μείνει για λίγες ώρες με τον άνθρωπό σας ώστε να κάνετε μια βόλτα στους χριστουγεννιάτικα στολισμένους δρόμους, να πάτε στο κομμωτήριο ή απλά για να χαλαρώσετε στον καναπέ σας διαβάζοντας το αγαπημένο σας βιβλίο. Λίγος χρό νος αποκλειστικά για εσάς είναι το καλύτερο χριστου γεννιάτικο δώρο που μπορείτε να κάνετε στον εαυτό σας. Το αξίζετε. Αποδεχθείτε το «καινούργιο φυσιολογικό», υποδε χθείτε τα Χριστούγεννα με χαμηλές προσδοκίες, αλλά και ταυτόχρονα με θετική διάθεση και ίσως αυτές οι γιορτές να διαψεύσουν τους φόβους σας και να απο δειχθούν πραγματικά υπέροχες τόσο για εσάς όσο για τον άνθρωπό σας που ξεχνά. Καλά Χριστούγεννα με Υγεία και Αγάπη! ■
και της Ελληνικής Νευροψυχολογικής Εταιρείας.

| 131
Ακόμα
πρόγραμμα των Χρι στουγέννων, βρείτε χρόνο για να φροντίσετε τον εαυ ΟΛΓΑ ΛΥΜΠΕΡΟΠΟΥΛΟΥ Η Όλγα Λυμπεροπούλου είναι γνωστική νευροψυχολόγος με ειδίκευση στην Τρίτη Ηλικία και τις Άνοιες. Έχει πτυχίο Ψυχολογίας από τη Φιλοσοφική Σχολή Αθηνών και μεταπτυχιακό στη Γνωστική Νευροψυχολογία από το Πανεπιστήμιο Essex του Ηνωμένου Βασιλείου. Από το 2002 εργάζεται καθημερινά με άτομα μέσης και τρίτης ηλικίας που αντιμετωπίζουν διαταραχές των νοητικών τους λειτουργιών και τις οικογένειές τους. Είναι υπεύθυνη του Κέντρου Διαταραχών Μνήμης και διαχειρίστρια της ιστοσελίδας trainyourbrain.gr. Μέσα από τα άρθρα, τα βιβλία και τις ομιλίες της επιδι ώκει να μεταδώσει στο ευρύ κοινό με απλό και κατανοητό τρόπο επιστημονικά τεκμηριωμένες πληροφορίες σχετικά με τις άνοιες και τη φροντίδα της υγείας του εγκεφάλου. Είναι ιδρυτικό μέλος της Εταιρείας Alzheimer Αθηνών και επί μία δεκαετία υπήρξε μέλος της διεπιστημο νικής ομάδας του Ιατρείου Μνήμης του Νοσοκομείου
Είναι μέλος της Διεθνούς
16 Φροντίστε τον εαυτό σας
και μέσα στο φορτωμένο
ΥΓΕΙΑ.
Εταιρείας Γνωστικής Αποκατάστασης
συμβάλει σημα
στην αποτελεσματικότε ρη εξυπηρέτηση των ασθενών και των συνοδών τους, καθώς και στη βελτίωση των συνθηκών εργασίας του υγειονομικού προσωπικού. Το ΤΕΠ του ΓΝΑ «Γ. Γεννηματάς» λειτούργησε ως το πρώτο συντονιστικό κέντρο επειγόντων περιστατικών στα τέλη της δεκαετίας του 1960 με σκοπό την αντι μετώπιση όλων των επειγόντων περιστατικών εντός του Λεκανοπεδίου Αττικής, αλλά και του συνόλου της Ελληνικής Επικράτειας σε 24ωρη καθημερινή βάση. Περισσότερα από 80.000 άτομα επισκέφθηκαν το ΤΕΠ του ΓΝΑ «Γ. Γεννηματάς» κατά τη διάρκεια της γενικής εφημερίας του για το 2021, καθιστώντας το πρώτο στο Λεκανοπέδιο Αττικής, ενώ η επισκεψιμότητα του ανήλ θε σε περίπου 55.000 άτομα για το πρώτο εξάμηνο του 2022. Η δωρεά του Κοινωφελούς Ιδρύματος Ιωάννη Σ. Λάτση αφορούσε στη μελέτη και υλοποίηση της πλή ρους οικοδομικής και Η/Μ ανακατασκευής του συνολι κού κτιριακού συγκροτήματος (1.192 m2) του ΤΕΠ, του περιβάλλοντος αυτού χώρου (1.600 m2) και του νέου στεγάστρου (350 m2), καθώς και στην προμήθεια και εγκατάσταση σύγχρονου ιατροτεχνολογικού και λοιπού εξοπλισμού. Αναλυτικά η νέα χωροταξία του ΤΕΠ έχει ως ακο λούθως: 1. ΚΕΝΤΡΙΚΗ ΕΙΣΟΔΟΣ


Από αριστερά ο Δρ. Πέτρος Καλαντζής, Προέδρος του Εκτελεστικού Συμβουλίου του Κοινωφελούς Ιδρύματος Ιωάννη Σ. Λάτση, κ. Θάνος Πλεύρης, Υπουργός Υγείας, κ. Κώστας Τασούλας, Πρόεδρος της Βουλής των Ελλήνων, κ. Μαριάννα Λάτση, κ. Μίνα Γκάγκα, Αναπληρώτρια Υπουργός Υγείας, κ. Ζωή Ράπτη, Υφυπουργός Υγείας.
κ. Θάνος Πλεύρης, υπουργός Υγείας.
132 | ΜΕ ΔΩΡΕ Α ΤΟΥ ΚΟΙΝΩΦΕΛΟΥ Σ Ιδρύματος Ιωάννη Σ. Λάτση ανακαινίστηκε και αναβαθμίστηκε
του Γενικού
Χώρος Υποδοχής Ασθενών με λειτουργία χώρου Πλη ροφοριών • Χώρος Λογιστηρίου Ταμείων Γραμμα τείας Εξυπηρέτησης Ασθενών • Χώρος Αναμονής Πε ριπατητικών Ασθενών και Συνοδών με χώρους W.C. (ανδρών-γυναικών) • Γραφείο Κοινωνικού Λειτουργού Ενημέρωσης Συγγενών • Χώρος Διαλογής Ασθενών Triage 5 κλινών. 2. ΧΩΡΟΙ ΕΞΕΤΑΣΗΣ – ΥΠΟΣΤΗΡΙΚΤΙΚΟΙ
Χώροι Αναμονής Περιπατητικών Ασθενών •
• Λουτρό Ασθενών • Χώροι Προσωπικού (Γραφεία, Αποδυτήρια W.C., ανά παυση προσωπικού) • Χώρος Ειδών Καθαριότητας
Μικροεπεμβάσεων • Χώρος Scrub up (πλύσης Ιατρών - Νοσηλευτών) • Χώρος Αποστειρω μένου Υλικού • Χώρος Αποστείρωσης Πλύσης Εργα
• Χώρος συγκέντρωσης Ακαθάρτων. ■ ΓΝΑ «Γ. ΓΕΝΝΗΜΑΤΑΣ» Αναβαθμίστηκε το Τμήμα Επειγόντων Περιστατικών! Από αριστερά ο Επίσκοπος Ρωγών κ. Φιλόθεος, κ. Μίνα Γκάγκα, αναπληρώτρια υπουργός Υγείας, Δρ Πέτρος Καλαντζής, προέδρος του Εκτελεστικού Συμβουλίου του Κοινωφελούς Ιδρύματος Ιωάννη Σ. Λάτση, κ. Μαριάννα Λάτση,
το Τμήμα Επει γόντων Περιστατικών
Νοσοκομείου Αθηνών «Γ. Γεννηματάς». Το έργο αναμένεται να
ντικά στον εκσυγχρονισμό των υπηρεσιών επείγουσας φροντίδας του νοσοκομείου,
ΧΩΡΟΙ Καρδιολογικό Τμήμα Αναζωογόνηση: 5 κλίνες • Πα θολογικό Τμήμα: 12 κλίνες • Μόνωση: 1 κλίνη • Χει ρουργικό Τμήμα: 9 κλίνες • Αίθουσα Γύψου • Χώρος Ηλεκτροκαρδιογράφου με W.C. • Χώρος αναμονής κατακεκλιμένων ασθενών χωρητικότητας 10 κλινών •
W.C. Ασθε νών (ανδρών-γυναικών και ΑμεΑ)
• Χώροι Ακαθάρτων Σκωραμίδων • Χώροι Αποθηκών • Χώροι Η/Μ Εγκαταστάσεων 3. ΤΜΗΜΑ ΕΠΕΜΒΑΣΕΩΝ 3 Αίθουσες
λείων
αποτελεί, λοι πόν, έκπληξη
η περίοδος που διανύουμε συνοδεύεται από μια χαρακτηριστική αύξηση της πρόσβασης των πολιτών σε πληροφορίες υγείας, ενισχύοντας την εγρήγορση για θέματα ατομικής υγείας και τη μέριμνα για αυτοπροστασία. Σήμερα, η αξία της υιοθέτησης υπεύθυνων συμπεριφορών Αυτοφροντίδας γίνεται περισσότερο εμφανής από ποτέ. Πράγματι, η υιοθέτηση ορθών πρακτικών Αυτοφροντίδας στην καθημερινότητά μας έχει πολλαπλά και με τρήσιμα οφέλη τόσο για εμάς τους ίδιους όσο και για το σύστημα υγείας και την εθνική οικονομία. Αποτελώντας ένα μέσο ελέγχου και προστασίας της υγείας του ατόμου, οι πρακτικές αυτές συμβάλλουν στην πρόληψη ορι σμένων παθήσεων, αλλά και στη γρηγορότερη και αποτελεσματικότερη αντιμετώπιση των ήπιων συμπτωμάτων τους (όπως για παράδειγμα τα συμπτώματα του κρυολογήματος ή των γαστρεντερικών διαταραχών), οδηγώ ντας κατ’ επέκταση στη μείωση των δαπανών υγείας. Ενδεικτικά, πρόσφατη έρευνα καταγράφει σε παγκόσμιο επίπεδο ετήσια εξοικονόμηση 119 δισ. δολαρίων όσον αφορά στη συγκράτηση δαπανών στον τομέα της Υγείας, ως απόρροια της Αυτοφροντίδας1 Με άλλα λόγια, η υιοθέτηση μιας κουλτούρας Αυτοφροντίδας μάς βοηθά να έχουμε μια ποιοτική, ισορρο πημένη και παραγωγική ζωή. Για να το επιτύχουμε όμως, πρέπει να είμαστε εφοδιασμένοι με τα αναγκαία μέσα. Στο σημείο αυτό, η συμβολή των καταναλωτικών προϊόντων υγείας είναι αποφασιστικής σημασίας. Αυτός είναι ο λόγος που για τη Sanofi, μία από τις μεγαλύτερες φαρμακευτικές εταιρείες παγκοσμίως, τα καταναλωτικά προϊόντα υγείας αποτελούν στρατηγικής σημασίας τομέα δραστηριοποίησης. Αναγνωρίζοντας την αξία τους για την προαγωγή της υγείας και ευεξίας των ανθρώπων, η εταιρεία διατηρεί μια ξεχωριστή Επι χειρησιακή Μονάδα αφιερωμένη εξ ολοκλήρου στον τομέα ανάπτυξης, παραγωγής και διάθεσης ασφαλών και ποιοτικών μη συνταγογραφούμενων φαρμάκων. Η Παγκόσμια Επιχειρησιακή Μονάδα Καταναλωτικών Προϊόντων Υγείας της Sanofi σχεδιάζει τις επιχειρη σιακές της δράσεις με άξονα την πεποίθηση ότι εμείς οι ίδιοι είμαστε υπεύθυνοι για την υγεία μας. Στο πλαίσιο αυτό, αξιοποιεί την τεχνολογική καινοτομία και τεχνογνωσία της, προκειμένου να μας προσφέρει λύσεις και προϊόντα υγείας για την καλύτερη διαχείριση όλων των σταδίων προστασίας της υγείας μας – από την πρόληψη έως την ανάρρωση. Προσαρμοσμένα στις σύγχρονες ανάγκες των ανθρώπων, τα καταναλωτικά προϊόντα υγείας της Sanofi παγκοσμίως χαρακτηρίζονται από υψηλότατες προδιαγραφές ποιότητας, ενσωματώνουν τις πιο πρόσφατες επι στημονικές εξελίξεις και καλύπτουν ένα μεγάλο εύρος παθήσεων και συμπτωμάτων: το βήχα και το κρυολόγημα, για την αντιμετώπιση των οποίων οι καταναλωτές εμπιστεύονται τη Sanofi για περισσότερα από 50 χρόνια, τον πόνο (οσφυαλγία, χρόνιος πόνος), τις εντερικές διαταραχές (δυσκοιλιότητα, διάρροια, δυσπεψία), το στρες και την αϋπνία (η επίπτωση των οποίων εντάθηκε αισθητά εν μέσω πανδημίας), την κόπωση, αλλά και τις αλλεργίες. Ειδικά ως προς την τελευταία κατηγορία, η εταιρεία διαθέτει στην αγορά ένα φάσμα καινοτόμων προϊόντων, ειδικά σχεδιασμένων
1 Bauer C, May U, Giulini-Limbach C, Schneider-Ziebe A (2022) The Global Social and Economic Value of Self-Care 2022 Report Global Self-Care Federation. Accessed 17 July 2022.

| 133 | ADVERTORIAL Αυτοφροντίδα: Πυλώνας Υγείας και Κοινωνικής Ανάπτυξης! Ένα από τα θεμελιώδη διδάγματα της
και προγράμματα σε διεθνές επίπεδο. Μπορείτε να μάθετε περισσότερα για την Υγεία και Αυτοφροντίδα στην Ελλάδα στο
πανδημίας της νόσου COVID-19 είναι ότι η διασφάλιση της υγείας μας είναι άρρηκτα συνδεδεμένη με την υγεία της ευρύτερης κοινότητας στην οποία ανήκουμε. Δεν
ότι
για να ανταποκρίνονται στις εξατομικευμένες ανάγκες των αλλεργικών ατόμων. Τέλος, δραστηριοποιείται έντονα στον τομέα εκπαίδευσης και ενημέρωσης του κοινού για θέματα υπεύθυνης διαχείρισης της ατομικής υγείας, υιοθέτησης ορθών διατροφικών συνηθειών και προαγωγής της υγείας και ευεξίας, εκπονώντας δράσεις
https://www.sanofi.gr/ el/gnoriste-mas/therapeftikes-katigories/ugeia-kai-aftofrontida
«ΧΡΥΣ Η» ΑΝΑΔΕ Ι ΧΘΗΚΕ η Allergan Aesthetics, μία εταιρεία της AbbVie, στην απονομή των βραβείων Medical Beauty Awards 2022. Η Allergan Aesthetics, πρωτοπόρος στην Αισθητική Ιατρική, με 25 χρόνια έρευνας και ανάπτυξης κορυφαίων brands τα οποία αναγνωρίζονται από επαγγελματίες υγείας και θεραπευ ομένους, τιμήθηκε συνολικά με πέντε βραβεία, τέσσερα χρυσά και ένα ασημένιο, για τις καινοτόμες ενέσιμες θεραπείες προσώπου. Τρία χρυσά απονεμήθηκαν στην κορυφαία σειρά
JUVÉDERM®, #1 brand, παγκοσμίως, στα fillers προσώ που με υαλουρονικό οξύ: Ένα για την κατηγορία «Best Face Filler» για τη βελτίωση του περιγράμματος, τη λεί ανση των ρυτίδων και την αποκατάσταση του όγκου του προσώπου, ένα για την κατηγορία «Best Lips Filler» για την ανάδειξη της περιοχής των χειλιών και ένα για την κατηγορία «Best Eyes Filler» για την περιοχή των ματιών.
To JUVÉDERM® είναι το brand που στόχο έχει την ανά δειξη των μοναδικών, φυσικών χαρακτηριστικών κάθε ανθρώπου, που τον κάνουν ξεχωριστό, αναδεικνύοντας τα χαρακτηριστικά αυτά με τον σωστό τρόπο ώστε να γίνουν ακόμη πιο εντυπωσιακά. Με χρυσό βραβείο τιμήθηκε, επίσης, στην κατηγορία «Best Botulinum Toxin Product», η βοτουλινική τοξίνη τύπου Α της Allergan Aesthetics, για κοσμητική χρήση. Σημαντική ασημένια διάκριση έλαβε η νέα καινο τόμος θεραπεία HArmonyCa™ με λιδοκαΐνη, ως «Best Innovation Injectable Product», μόλις δυο μήνες μετά το λανσάρισμά της! Είναι το πρώτο υβριδικό ενέσιμο τζελ διπλής δράσης της Allergan Aesthetics, το οποίο συνδυάζει στην ίδια σύριγγα δύο ενεργά συστατικά, το υαλουρονικό
Ο κ. Γιάννης Μπεσσής, Country Manager Allergan Aesthetics, για Ελλάδα και Κύπρο, και η κ. Ρούλα Σχίζα, Head of Marketing / Europe Region PR & Communications Lead Allergan Aesthetics.
της Allergan Aesthetics να εξελίσσεται και να προσφέρει τις πιο καινοτόμες θεραπείες με αποδεδειγμένα βέλτι στα αποτελέσματα για τους θεραπευομένους. Για τις διακρίσεις αυτές ο Γιάννης Μπεσσής, Country Manager της Allergan Aesthetics, για Ελλάδα και Κύπρο,
δήλωσε τα εξής: «Η διαχρονική αναγνώρισή μας από την ευρύτερη αγορά, όπως στα Medical Beauty Awards, μας τιμά ιδιαίτερα και μας ενεργοποιεί περαιτέρω να προσπαθούμε να γίνουμε καλύτεροι. Βρισκόμαστε στην αιχμή της επιστήμης, όμως δεν επαναπαυόμαστε. Αφου γκραζόμαστε τις νέες τάσεις στην Αισθητική Ιατρική οι οποίες επιβάλλουν να μετεξελιχθούμε σε ό,τι πιο σύγχρο νο και επίκαιρο, ώστε να προσφέρουμε στους θεραπευ ομένους μας τις θεραπείες που θα τους βοηθήσουν να καθυστερήσουν τα σημάδια της γήρανσης, να νιώθουν αυτοπεποίθηση και να πετύχουν την καλύτερη εκδοχή του εαυτού τους. Είναι μία συναρπαστική νέα εποχή για εμάς, γιατί θέλουμε οι άνθρωποι που αναζητούν αισθητική περιποίηση να εκπροσωπούνται και να ταυτίζονται με τα brands και τις υπηρεσίες μας. Το κοινό μας είναι άνδρες και γυναίκες όλων των ηλικιών και όλων των εθνικοτή των, είναι αυτοί που ορίζουν το νέο πλαίσιο ομορφιάς το οποίο καταργεί τα στερεότυπα. Χάρη στην εμπειρία μας και στους ταλαντούχους συνεργάτες μας, αλλά και χάρη στη συμβολή των επαγγελματιών υγείας, είμαστε έτοιμοι να ανταποκριθούμε στις νέες προκλήσεις, με επαναστατικές νέες θεραπείες που αποτελούν σημείο αναφοράς για το χώρο της Αισθητικής Ιατρικής». ■

134 |
πολυδιάστατες ανάγκες του δέρματος που προκύπτουν με την πάροδο της ηλικίας. Το HArmonyCa™ αντικατοπτρίζει τη σταθερή δέσμευση
οξύ και τον υδροξυαπατίτη ασβεστίου. Η θεραπεία προσφέρει άμεση ανόρθωση, χάρη στο υαλουρονικό οξύ και τη διαρκή διέγερση κολλαγόνου που σχετίζεται με τον υδροξυαπατίτη ασβεστίου και καλύπτει κάποιες από τις
ALLERGAN AESTHETICS Χρυσές διακρίσεις στα Medical Beauty Awards 2022 για τις καινοτόμες θεραπείες της!
βάθος από τους ασθενείς, αλλά και τη συνδια μόρφωσή του από γιατρό και ασθενή, ώστε η θεραπεία να είναι προσαρμοσμένη στα ατομικά χαρακτηριστικά
και ανάγκες κάθε ασθε νούς. Μάλιστα, σύμφωνα με έρευνες, η καλή επι κοινωνία διαδραματίζει

τον ίδιο σημαντικό ρόλο με τη λήψη της σωστής φαρμακευτικής αγω γής. Εξίσου σημαντικός, όμως, είναι και ο ρόλος των φροντιστών των ασθενών με καρδιαγγει ακές παθήσεις. Αυτή τη νέα προσέγγιση υλοποιεί το «Σχολείο Ασθενών με Καρδιαγγειακές Παθή σεις» της Γ’ Καρδιολογικής Κλινικής του ΑΠΘ, με τη διοργάνωση διαδραστικής ημερίδας που πραγματο ποιήθηκε πρόσφατα. «Ο ασθενής δεν είναι και δεν μπορεί να αποτελεί στατιστικό αποτέλεσμα μέσου όρου. Η εξατομικευμέ νη θεραπεία, που είναι το ζητούμενο της σύγχρονης ιατρικής πρακτικής, μπορεί να φέρει τα καλύτερα απο
Όπως εξηγεί, «τα βιώματα που είχα ως ασθενής COVID-19 για μεγάλο χρονικό διάστημα με βοήθησαν να αντιληφθώ τα κενά στην επικοινωνία μεταξύ ασθε νών και ιατρικού προσωπικού. Αυτό ήταν το έναυσμα για τη δημιουργία σχολείου καρδιολογικών ασθενών. Πολλές φορές, γιατροί και νοσηλευτές, παρά την καλή διάθεσή μας, επειδή δεν έχουμε τον απαιτούμενο χρόνο για ενημέρωση σε βάθος, δεν γινόμα στε αντιληπτοί από τους ασθενείς, με συνέπεια να μην κατανοούν αυτό που τους λέμε και κατ’ επέκταση να μη συμ μορφώνονται με την προτεινόμενη θεραπεία. Επειδή πιστεύουμε ότι συμμορφωμένοι ασθε νείς είναι μόνο οι καλά ενημερωμένοι ασθενείς, ξεκινήσαμε το σχολείο πιλοτικά με έναν μικρό αριθμό καρδιολογικών ασθενών. Στις συναντήσεις που προηγή θηκαν, εξηγήσαμε τις βασικές καρδιολογικές παθήσεις και ακούσαμε τις απορίες και τους προβληματισμούς τους. Ταυτόχρονα εκπαιδευτήκαμε από τους ασθενείς μας, γιατί μας έδειξαν τι είναι σημαντικό γι’ αυτούς. Θέ λουν να γνωρίζουν ποια είναι η πάθησή τους, τι πρέπει να κάνουν, τι επιλογές έχουν, ζητούν απαντήσεις σε όλα τα ερωτήματά τους». ΑΝΑΝΤΙΚΑΤΑ

και δείχνουν αν μία θεραπεία είναι αποδο τική ή όχι», δηλώνει ο καθηγητής Καρδιολογίας και διευθυντής της Γ’ Καρδιολογικής Κλινικής, Βασίλειος Βασιλικός.
αυτά. Η πιο συχνή αιτία εισαγωγής στο νοσοκομείο για ασθε νείς με καρδιακή ανεπάρκεια είναι η πλημμελής λήψη της φαρμακευτικής αγωγής. Αυτό μπορεί να αλλάξει με εφαρμογή απλών πρακτικών συμβουλών προς όφελος του ασθενούς
| 135 | ΕΙΔΗΣΕΙΣ H ΟΡΘ Η ΕΠΙΚΟΙΝΩΝ Ι Α ΙΑΤΡΟΥ και ασθενoύς αποτελεί τη βασική προϋπόθεση για την έγκαιρη διάγνωση και αποτελεσματικότερη θεραπευτική αντιμετώπιση. Για να μπορέσει το θεραπευτικό πλάνο διαχείρισης να αποδώ σει τα μέγιστα, προϋποθέτει όχι μόνο την κατανόησή του σε
στη συμμόρφωσή του. Το σχο λείο ασθενών έρχεται να καλύψει αυτό το κενό της ενημέρωσης και της καλύτερης κατανόησης. Η δυτική Ιατρική έχει κατηγορηθεί ότι παραβλέπει ατομικά χα ρακτηριστικά που θα έπρεπε να λαμβάνει υπόψη της,
στην τεκμηρίωση,
των
που προκύπτουν για
τελέσματα όταν βρούμε κοινή γλώσσα με τον ασθενή. Η λήψη αποφάσεων για τη θεραπεία από κοινού με τον ασθενή συμβάλλει
βασισμένη
δηλαδή στην εφαρμογή
στατιστικών
μεγάλες ομάδες ασθενών
και
της υγείας, όταν
και
οικογενειακό περιβάλλον του είναι καλά ενημερωμένοι». ■ ΙΠΠΟΚΡΑΤΕΙΟ NΟΣΟΚΟΜΕ Ι Ο ΘΕΣΣΑΛΟΝ Ι ΚΗΣ «Σχολείο Ασθενών με Καρδιαγγειακές Παθήσεις» από την Γ’ Καρδιολογική Κλινική του ΑΠΘ Ο κ. Βασίλειος Βασιλικός. Ο κ. Κώστας Μπακογιάννης.
ΣΤΑΤΗ Η ΔΙ Α Ζ Ω ΣΗΣ ΠΛΗΡΟΦ Ο ΡΗΣΗ Από την πλευρά του, ο υπεύθυνος του σχολείου ασθε νών, καρδιολόγος Κώστας Μπακογιάννης επισημαίνει ότι «είναι πολύ εύκολο ένας ηλικιωμένος ασθενής που παίρνει 15 χάπια την ημέρα να ξεχάσει κάποιο από
των οικονομικών
ο ασθενής
το


136 | ΤΟ Ρ ΟΛΟ ΤΗΣ ΚΑΙΝΟΤΟΜ Ι ΑΣ στην αειφόρο ανάπτυξη της Ελλάδας τόνισε σε ομιλία του στο 3ο Φόρουμ Καινο τομίας o Δημήτρης Αναγνωστάκης, γενικός δ/ντής της φαρμακευτικής εταιρείας Boehringer Ingelheim Ελλάς και μέλος του Ελληνογερμανικού Επιμελητηρίου. Ο κ. Αναγνωστάκης αναφέρθηκε στη στρατηγι κή αειφόρου ανάπτυξης της Boehringer Ingelheim, η οποία ανακοινώθηκε αμέσως μετά τη Διάσκεψη των Ηνωμένων Εθνών για την Κλιματική Αλλαγή το 2021 (COP26). Το πλαίσιο «Αειφόρος Ανάπτυξη - Για Γενεές» έχει τρεις πυλώνες: «More Health» (καλή υγεία για τους ανθρώπους και τα ζώα), «More Green» (φροντίδα για το περιβάλλον) και «More Potential» (συνδημιουργία υγιών ενσωματωμένων και βιώσιμων κοινοτήτων). Από την καινοτομία στην αειφόρο ανάπτυξη και την ενιαία Υγεία! Η στρατηγική καινοτομίας και αειφορίας της Boehringer Ingelheim Στιγμιότυπο από την ομιλία του κ. Δημήτρη Αναγνωστάκη στο φόρουμ.
Μέσω των τριών αυτών πυλώνων, η Boehringer Ingelheim εφαρμόζει 20 πρωτοβουλίες σε ολόκληρο τον κόσμο που καθοδηγούν τη συνεισφορά και την επίδραση της εταιρείας. Αυτές οι πρωτοβουλίες είναι σε συμφω νία με τους Στόχους Βιώσιμης Ανάπτυξης των Ηνωμένων Εθνών. Προκειμένου να επιτύχει τους στόχους αυτούς, η εταιρεία έχει ανανεώσει τη δέσμευσή της για συμ μετοχή σε μεγάλο εύρος συνεργασιών που απαιτείται για την αντιμετώπιση των πολύπλοκων προκλήσεων παγκοσμίως. Παράλληλα, σε διεθνές επίπεδο ακολουθεί τη φιλοσοφία One Health στο σχεδιασμό και διάθεση τόσο των φαρμάκων για ανθρώπινη χρήση όσο και των φαρμάκων για κτηνιατρική χρήση. Στο πλαίσιο αυτό, η εταιρεία μέσω του πυλώνα More Health επενδύει το ποσό των 250 εκατομμυρίων ευρώ


γή. Η επένδυση αυτή αποδεικνύει ότι η καινοτομία σε αυτή τη χώρα μπορεί να παραχθεί, να φέρει σημαντικό συνάλλαγμα, να συγκρατήσει επιστημονικό δυναμικό (brain drain) και να μας βοηθήσει να κρατήσουμε την παραγωγή στο ευρωπαϊκό έδαφος. Ένα στα τρία φάρ μακα που εξάγονται από την Ελλάδα προέρχονται από το εργοστάσιο της Boehringer Ingelheim στο Κορωπί. Σύμφωνα με την έκθεση του ινστιτούτου Wifor, η άμεση συνεισφορά της Boehringer Ingelheim στο ΑΕΠ της Ελλάδας ανέρχεται σε περίπου 8% της ελληνικής φαρμακευτικής βιομηχανίας. Συμπεριλαμβανομένων των δευτερογενών επιπτώσεων, η Boehringer Ingelheim συνεισέφερε σχεδόν 310 εκατ. ευρώ στο ΑΕΠ. Με πο σοστό 11%, η Boehringer Ingelheim στην Ελλάδα πέτυχε αξιοσημείωτη συνολική ένταση R&D (εσωτερικές και εξωτερικές δαπάνες R&D ανά GVA), η οποία υπερβαίνει κατά πολύ το στόχο του 3% για τη χώρα. Η δραστηρι ότητα της Boehringer στην Ελλάδα δημιούργησε 5.764 έμμεσες και 1.573 άμεσες θέσεις εργασίας
για το διάστημα 2019-2025 έχει ήδη τεθεί σε εφαρμο
παρουσιάσει ιστορίες επιτυχίας από διάφορους τομείς με επίκεντρο την καινοτομία, και να δρομολογή σει διαδραστικές μορφές ανταλλαγής ιδεών και νέες συνεργασίες. Σε αυτό το πλαίσιο, η ελληνογερμανική ανταλλαγή απόψεων γύρω από το θέμα της καινοτομί ας ως μοχλού οικονομικής ανάπτυξης είναι ιδιαιτέρως σημαντική.
| 137 | ΦΟΡΟΥΜ ΚΑΙΝΟΤΟΜΙΑΣ
τα οποία οφείλονται
Απόρροια της στρατηγικής
στην Ελλάδα αποτελεί η συνεχής επένδυση της εται ρείας με προδιαγραφές industry 4.0. στο εργοστάσιό της στο Κορωπί, το οποίο έχει μετατραπεί σε κέντρο (HUB) παραγωγής και εξαγωγών των καινοτόμων αντι διαβητικών φαρμάκων της εταιρείας σε
Η νέα επένδυση της εταιρείας ύψους
σε συμμαχία για την καταπολέμηση αναδυόμενων λοιμωδών νοσημάτων, τα 2/3 από
σε ζωοανθρωπονόσους.
αειφόρου ανάπτυξης
80 χώρες.
100 εκατομμυρίων
στην ελληνική αγορά εργασίας, στηρίζοντας έτσι σχεδόν 7.700 ελληνι κές θέσεις εργασίας. Τα παραπάνω στοιχεία δείχνουν το πολύ σημαντικό αποτύπωμα της Boehringer Ingelheim στην Ελλάδα. TO FORUM ΚΑΙΝΟΤΟΜ Ι ΑΣ ΤΟΥ ΕΛΛΗΝΟΓΕΡΜΑΝΙΚΟΥ ΕΠΙΜΕΛΗΤΗΡ Ι ΟΥ To forum καινοτομίας διοργανώνεται από το Ελληνο γερμανικό Εμπορικό και Βιομηχανικό Επιμελητήριο και την Πρεσβεία της Ομοσπονδιακής Δημοκρατίας της Γερμανίας στην Αθήνα. Στόχος του forum καινοτομίας είναι να
Ο κ. Δημήτρης Αναγνωστάκης.
■


Πώς θα ΠΡΟΣΤΑΤΕ Υ ΣΟΥΜΕ ΤΑ ΠΑΙΔΙ Α από σεξουαλική κακοποίηση!
με ένα ρυθμό πλέον που ξεπερνάει κάθε προηγούμενο. Η περίπτωση της 12χρονης στον Κολωνό, αλλά και άλλα περιστατικά τα οποία δημοσιοποιούνται, αποτελούν μόνο την κορυφή ενός παγόβουνου, που συντηρείται στα θεμέλια της σύγχρονης κοινωνίας. Σύμφωνα με στοιχεία, στη χώρα μας μόνον 1 στα 100 περιστατικά σεξουαλικής κακοποίησης παιδιών αναφέ ρεται, γεγονός που καθιστά την ανάληψη δράσης από τους γονείς, αλλά και τα σχολεία και τους αρμόδιους φορείς κάτι παραπάνω από αναγκαία. «Η βία και η κακοποίηση είναι πλέον πάρα πολύ έντονα φαινόμενα. Κατά συνέπεια, τα περιστατικά σεξουαλικής κακοποίησης, τα οποία αποτελούν μία μορφή βίας, είναι επίσης πολύ έντονα στις μέρες μας. Το πρόβλημα προφανώς προϋπήρχε, αλλά η πανδη μία και ο εγκλεισμός φαίνεται ότι το έχουν εντείνει και έχουν συμβάλει στην εκδήλωση και ανάδειξή του. Από τα περιστατικά που βλέπουμε στα ιατρεία μας καθη μερινά προκύπτει ότι η βία έχει ενταθεί την τελευταία τριετία, επιβεβαιώνοντας το ρόλο που έχει διαδραμα τίσει η υγειονομική κρίση», επισημαίνει η Φρίντα Κων σταντοπούλου, παιδοψυχίατρος-οικογενειακή ψυχοθε ραπεύτρια, επιστημονική συνεργάτις Παίδων ΜΗΤΕΡΑ. Μέσα σε αυτό το ζοφερό σκηνικό, στο… κόκκινο βρίσκεται η αγωνία των γονέων για τη μεταχείριση των παιδιών τους εκτός σπιτιού, ενώ συχνά δεν γνω
ρίζουν πώς να τα εκπαιδεύσουν στο να αποφεύγουν τέτοιες εμπειρίες, αλλά και να τις διαχειρίζονται όταν συμβαίνουν. «Όλα τα θέματα ξεκινούν από το ίδιο σημείο και καταλήγουν στο ίδιο σημείο: την επικοινωνία. Τα παι διά πρέπει να ενημερώνονται από τους γονείς τους για το σεξ χωρίς ταμπού, τα οποία φαίνεται ότι εξακο λουθούν να υπάρχουν ακόμα και σήμερα. Την κατάλ ληλη στιγμή για μία τέτοια κουβέντα σηματοδοτούν οι ερωτήσεις του ίδιου του παιδιού, σχετικά με το πώς έρχονται τα μωρά στον κόσμο, με την ανατομία των γεννητικών οργάνων και γενικότερα με ό,τι έχει να κά νει με τη σεξουαλικότητα και την αναπαραγωγή. Την ώρα που θα γεννηθεί η απορία πρέπει αμέσως να απαντηθεί. Διαφορετικά μετατρέπεται σε ένα μυστικό, το οποίο θα μπορέσει ο οποιοσδήποτε να εκμεταλ λευτεί κάποια στιγμή στο μέλλον. Ωστόσο, βλέπουμε ότι υπάρχουν γονείς που δεν έχουν μιλήσει στα παιδιά τους ακόμα και στην εφηβεία. Δεν μιλούν, παρά μόνο όταν συμβεί κάτι. Όταν, δηλαδή, είναι πλέον αργά», τονίζει η κ. Κωνσταντοπούλου.


ΟΔΡΟΜΟΣ
ΘΕΙΑ Οι ειδικοί συνιστούν στους γονείς να απαντούν στα παιδιά λέγοντας μόνο την αλήθεια, αλλά με έναν τρό πο προσαρμοσμένο στην ηλικία τους. Το ζητούμενο είναι να δημιουργηθεί ένα ασφαλές περιβάλλον στο σπίτι, ούτως ώστε να οχυρωθούν τα παιδιά απέναντι σε περιστατικά σεξουαλικής κακοποίησης και να τα εκμυστηρευτούν στην απευκταία περίπτωση που αυτά συμβούν. «Είναι αναγκαίο οι γονείς να μιλήσουν στα παιδιά σχετικά με το σώμα τους και το σεξ. Υπάρχουν και ειδι κά βιβλία που απευθύνονται σε παιδιά, ανάλογα με την ηλικία τους. Εξηγούν πώς είναι το σώμα των αγοριών και των κοριτσιών, πώς εξελίσσεται στην εφηβεία και πώς γίνεται το σεξ υπό φυσιολογικές συνθήκες, μιλούν για την ομοφυλοφιλία κ.ά. Αυτά τα βιβλία αποτελούν εξαιρετικό εργαλείο για την ενημέρωση των παιδιών. Έτσι θα αποκτήσουν εξοικείωση και θα μπορούν να κάνουν ερωτήσεις. Για ένα θέμα που δεν είναι ταμπού μέσα στο σπίτι, τα παιδιά μπορούν να ρωτήσουν τα πάντα, αλλά και να εκμυστηρευτούν τα πάντα», ανα φέρει η ειδικός. Ωστόσο, πρωταρχικής σημασίας είναι η ανάπτυ ξη του αισθήματος της αυτοπροστασίας. Θα πρέπει να γνωρίζουν ότι το σώμα τους είναι δικό τους, δεν επιτρέπεται να το αγγίζει κανείς, θα το αγγίξουν όταν έρθει η ώρα και πάντα με τη συγκατάθεσή τους. «Έτσι, τίθενται όρια σε αυτόν που θα επιχειρήσει να τα εκμεταλλευτεί
| 139
ΠΑΙΔΙ
|
με οποιονδήποτε τρόπο. “Χρυσό κανόνα” αποτελεί η εκπαίδευσή τους στο να προστα ΦΡ Ι ΝΤΑ ΚΩΝΣΤΑΝΤΟΠΟΥΛΟΥ Παιδοψυχίατρος-οικογενειακή ψυχοθεραπεύτρια, επιστημονική συνεργάτις Παίδων ΜΗΤΕΡΑ. ΑΠΟΤΡΟΠΙΑΣΜ Ο ΠΡΟΚΑΛΟΥ Ν ΤΑ ΠΕΡΙΣΤΑΤΙΚ Α σε ξουαλικής
της
ΜΟΝ
Η ΑΛ Η
κακοποίησης παιδιών που βλέπουν το φως
δημοσιότητας,
τεύουν το σώμα τους και την ψυχή τους από οτιδήποτε τα κάνει να νιώθουν άβολα. Σε μεγαλύτερες ηλικίες, να ξέρουν να λένε “όχι”, χωρίς ενοχές και φόβο μη αποδοχής, και να γνωρίζουν ότι δεν είναι αναγκασμέ να να κάνουν αυτό που τους ζητούν οι άλλοι, εάν δεν το επιθυμούν», εξηγεί. ΤΑ ΣΗΜ Α ΔΙΑ ΠΟΥ ΥΠΟΔΗΛ Ω ΝΟΥΝ ΠΙΘΑΝ Η ΣΕΞΟΥΑΛΙΚ Η ΚΑΚΟΠΟ Ι ΗΣΗ «Καμπανάκι» ότι ένα παιδί μπορεί να έχει πέσει θύμα σεξουαλικής παρενόχλησης ή κακοποίησης αποτελεί μία αισθητή αλλαγή στη συμπεριφορά

περιβάλλον.
μπορεί να πα
• Αρνείται να βγει από το σπίτι. • Εμφανίζει διαταραχές διατροφής και ύπνου. • Γνωρίζει πράγματα για το σεξ που δεν συνάδουν με την ηλικία του. • Επιδιώκει να φορά ρούχα που καλύπτουν το σώμα του. «Οποιαδήποτε αλλαγή στη συμπεριφορά του παι διού πρέπει να μας υποψιάσει και να το ενθαρρύνουμε να μας μιλήσει, διαβεβαιώνοντάς το πως ούτε θα το κρίνουμε ούτε θα δημιουργήσουμε μία κατάσταση που θα το κάνει να νιώσει άβολα. Τα παιδιά πολλές φορές φοβούνται ότι το θέμα θα πάρει μεγάλες διαστάσεις και θα βρεθούν στο επίκεντρο, κάτι το οποίο δεν το θέλουν. Γι’ αυτό και οι γονείς θα πρέπει να τα κάνουν να νιώσουν ασφαλή, με τη δέσμευση ότι το ζήτημα θα αντιμετωπιστεί με τον καλύτερο δυνατό τρόπο, ούτως ώστε
140 |
ΦΡ Ι ΝΤΑ Κ Ώ ΝΣΤΑΝΤΟΠΟΥΛΟΥ Η Φρίντα Κωνσταντοπούλου είναι παιδοψυχίατρος-οικογενειακή ψυχοθεραπεύτρια, επιστημονική συνερ γάτις Παίδων ΜΗΤΕΡΑ. Σπούδασε Ιατρική στην Ιατρική Σχολή του Δημοκρίτειου Πανεπιστημίου Θράκης. Κατά τη διάρκεια της ειδικότητας άσκησε την Ιατρική στο Ψυχιατρικό Νοσοκομείο Αττικής, στο Νοσοκομείο Παίδων Πεντέλης, στο Κέντρο Ψυχικής Υγιεινής της Αθήνας και στο Παιδοψυχιατρικό Νοσοκομείο Αττικής. Εκπαιδεύτηκε στη Συστημική και Οικογενειακή Θεραπεία στη Μονάδα Οικογενειακής Θεραπείας του ΨΝΑ (Κ. Χαραλαμπάκη-Κοτσίδας). Εργάστηκε στο ΚΕΔΔΥ Πειραιά, καθώς και στην Παιδοψυχιατρική Κλινική του Τζάνειου Νοσοκομείου.
του, που χαρα κτηρίζεται από τις εξής εκδηλώσεις: • Γίνεται πολύ εσωστρεφές και ευερέθιστο στο οι κογενειακό
• Αρνείται να πάει στο σχολείο και
ρουσιάζει και πτώση των ακαδημαϊκών του επιδόσε ων.
να αισθάνονται και τα ίδια καλά», καταλήγει η κ. Κωνσταντοπούλου. ■

































































142 |
σορών πτολεμαϊκής
(μία γυναίκας, τρεις ανδρών και μία μικρού αγοριού), οι σαρκοφάγοι των οποίων είχαν μελετηθεί ήδη αιγυπτιολογικώς από τη Δρα Αλίκη Μαραβέλια, αιγυπτιολόγο και πρόεδρο του Ελληνικού Ινστιτούτου Αιγυπτιολογίας, εξετάσθηκαν με μη επεμβατική σάρωση, διά μέσου αξονικού τομογρά φου τελευταίας τεχνολογίας, ώστε να απεικονισθούν
και να μελετηθούν με ιατρικό, ανθρωπολογικό και ια τροδικαστικό τρόπο. Η Δρ Αλίκη Μαραβέλια είναι επίσης επικεφαλής της έρευνας που γίνεται για το αιγυπτιακό θυμίαμα κυφί και με αφορμή μια επιστημονική εργασία που διεξάγεται από την ομάδα της, τόσο για τις ιδιότητες του κυφίου όσο και για τις διαφορές του με το δικό μας Άγιον Μύρον, μας μίλησε για την πορεία των μελετών της. — Κυρία Μαραβέλια, πώς ακριβώς διεξήχθησαν οι εξετάσεις; Χρησιμοποιήθηκε αξονικός τομογράφος τελευταίας τεχνολογίας (Somatom Sensation 64 της Siemens) με το πλέον σύγχρονο λογισμικό επεξεργασίας εικόνων. Οι εξετάσεις που έγιναν με διακριτική ικανότητα μεγαλύτε ρη αυτής των περισσοτέρων έως τώρα δημοσιευμένων εργασιών πραγματοποιήθηκαν από το ειδικευμένο ια τρικό και τεχνικό προσωπικό του Ιατρικού Κέντρου Αθη νών, υπό τη διεύθυνση του εκλεκτού ιατρού-ραδιολόγου και διευθυντή της Μονάδας Αξονικής και Μαγνητικής Τομογραφίας Δρος Νικολάου Μποντόζογλου και της Ομάδας του (ιατροί-ραδιολόγοι: Ιωάννης Πανταζής, Σταυρούλα Κυριαζή, Γεώργιος Μιχαηλίδης, Κλεάνθη Καλογεράκου, Κυριάκος Καλαμπούκας). Η μελέτη των αποτελεσμάτων πραγματοποιήθηκε σε στενή συνερ γασία με την αιγυπτιολόγο Δρα Αλίκη Μαραβέλια, την πρ. υπεύθυνη της

| 143 ΤΟ ΕΛΛΗΝΙΚΟ ΙΝΣΤΙΤΟΥ ΤΟ ΑΙΓΥΠΤΙΟΛΟΓ Ι ΑΣ, σε στενή συνεργασία με το Εθνικό Αρχαιολογικό Μουσείο Αθηνών και τον Όμιλο του Ιατρικού Κέντρου Αθηνών, προέβη στη διεξαγωγή Ερευνητικού Προγράμματος πρωτοτύπου και μοναδικού μέχρι στιγμής για τα ελλη νικά δεδομένα.
Πέντε εκ των δέκα
περιόδου της Αιγυπτιακής Συλλογής
Συλλογής του Μουσείου, Συνέντευξη στην ΑΝΘΗ ΑΓΓΕΛΟΠΟΥΛΟΥ Δ ρ ΑΛ Ι ΚΗ ΜΑΡΑΒ Ε ΛΙΑ Αιγυπτιολόγος, πρόεδρος του Ελληνικού Ινστιτούτου Αιγυπτιολογίας ΤΙ ΜΑΣ ΜΑΘΑ Ι ΝΟΥΝ ΟΙ ΑΙΓΥΠΤΙΑΚ Ε Σ ΣΑΡΚΟΦΑ ΓΟΙ ΜΕ ΤΗ ΒΟ Η ΘΕΙΑ ΤΟΥ ΙΑΤΡΙΚΟΥ ΑΘΗΝ Ω Ν Απεικόνιση και μελέτη με αξονικό τομογράφο αιγυπτιακών σαρκοφάγων! | ΣΥΝΕΝΤΕΥΞΗ
Αιγυπτιακής
αρχαιολόγο Ελένη Τουρνά, τον ιστορικό της Ιατρικής και διακεκριμένο καρδιοχειρουργό, καθηγητή Δρα Στέφανο Γερουλάνο, τον ιατροδικαστή και ανθρωπολόγο Κων σταντίνο Κούβαρη και τον συντηρητή της Αιγυπτιακής Συλλογής Παναγιώτη Λάζαρη. — Ποια ήταν τα αποτελέσματα της μελέτης; Τα αποτελέσματα αυτής της μελέτης είναι όχι μόνον ενθαρρυντικά, αλλά πολύ ενδιαφέροντα και μερικά εξ αυτών μοναδικά. Ήδη η Επιστημονική Ομάδα του Athens Mummy Project προέβη σε πέντε πρωτότυπες δημοσι εύσεις των πρώτων αποτελεσμάτων σε έγκριτα διεθνή περιοδικά με κριτές (Annals of Otology, Rhinology & Laryngology, International Journal of Osteoarchaeology, The Oriental Studies, The Anatomical Record, Journal of the Hellenic Institute of Egyptology), συνοδευόμενες από δισδιάστατες και εντυπωσιακές τρισδιάστατες πανοραμικές εικόνες. Ειδικότερα, μελετήθηκαν η ηλικία και το φύλο των νεκρών εν συγκρίσει προς τα αναγραφόμενα στις σαρ κοφάγους τους και αποκαλύφθηκαν οι τρόποι ταριχεύ σεως και οι συνοδοί αλλοιώσεις, οι σχετιζόμενες με την προετοιμασία ταφής τους, σε αντιπαραβολή με τις φθορές που υπέστησαν οι μούμιες κατά τη διάρκεια των αιώνων. Αντλήθηκαν και αναλύθηκαν ενδείξεις σχετικώς με τις ασθένειες που αντιμετώπισαν οι νεκροί κατά τη διάρκεια της ζωής τους, αλλά και πληροφορίες σχετικώς με τις διατροφικές συνήθειες της εποχής τους (π.χ.: έντονη φθορά των οδόντων). Συγκεκριμένα, η ιατρική μελέτη, μεταξύ άλλων, κα τέδειξε τα εξής:
1. Ευρήματα σχετιζόμενα με παθήσεις και παρεμ βάσεις.
2. Ανακαλύφθηκαν σημεία αποδεικτικά δολιχοεκτα σίας της σπονδυλικής αρτηρίας, μονοαρθρίτιδας της αυχενικής μοίρας της σπονδυλικής στήλης, χρόνιας ιγ μορίτιδας με συρρίκνωση του ιγμορείου άντρου, καθώς και χαρακτηριστική εικόνα συμμετρικής λεπτύνσεως των βρεγματικών οστών.
3. Ευρήματα λίαν σημαντικής αξίας είναι το ανακα λυφθέν οδοντιατρικό σφράγισμα, το οποίο αποτελεί το αναντίρρητο 2ο δημοσιευόμενο στη διεθνή βιβλι ογραφία, αλλά και η ανακάλυψη ότι μία εκ των σο ρών αποτελείται από οστά διαφορετικών ανθρώπων (περιέχουσα τρία μηριαία), ανάρχως τοποθετημένα και στερεωμένα με τη βοήθεια καλάμων και κλάδων φοινίκων (παρόμοια αιγυπτιακή μούμια ενήλικος δεν έχει έως τώρα δημοσιευθεί).
4. Εξηγήθηκε η σχετικώς ελλιπής ταρίχευση της ιέ ρειας, καθώς και το γεγονός ότι η αποσύνθεση του σώ ματός της είχε ήδη αρχίσει τουλάχιστον μερικές ημέρες πριν αρχίσει η διαδικασία μουμιοποιήσεως.
— Τι ήταν αυτό που σας έκανε ιδιαίτερη εντύπωση; Οι ομάδες έρευνας συζήτησαν εκτενώς τα ιατρικά και αρχαιολογικά ευρήματα (π.χ. υπολείμματα δικτυωτού σαβάνου εκ φαγεντιανής, κανωπική συσκευασία των τεσσάρων ζωτικών και «ιερών» εσωτερικών οργάνων) σε σχέση με τα αιγυπτιολογικά δεδομένα των σορών και των φερέτρων τους, με έμφαση στις αιγυπτιολογικώς μελετηθείσες σαρκοφάγους και στις επιγραφές τους (που αποτελούν ως επί το πλείστον Επωδούς Προσφο ράς των νενομισμένων). Εδείχθησαν η σπουδαιότητα και ο εντόνως μεταφυσικός συμβολισμός της διαδικα σίας ταριχεύσεως, και η ισορροπημένη

144 |
ένταξή της στη δέσμη
εθίμων και τελετουργιών.
οι Λίγο πριν από την άφιξη των πέντε σορών στο Ιατρικό Κέντρο Αθηνών τον Οκτώβριο του 2016. Από αριστερά, ο κ. Εμμανουήλ Μαρκόπουλος (γεν. οικονομικός διευθυντής του Ομίλου Ιατρικό Αθηνών), η Δρ Αλίκη Μαραβέλια (πρόεδρος του ΕΙΑ) και ο Δρ Νικόλαος Μποντόζογλου, διευθυντής του Αξονικού Τομογράφου του Ιατρικού Κέντρου. © Copyright Hellenic Institute
Egyptology.
των ταφικών
Όλες
of
ο διευθυντής Εταιρικών και Διεθνών Σχέσεων του ομίλου Κωστής Χατζηγιαννάκης, ο γενικός διευθυντής Θεόδωρος Χα


τις πέντε μούμιες του Εθνικού Αρχαιολογικού Μουσείου που εξετάσθηκαν με μη επεμβατική απεικόνιση, χωρίς το ειδικό προστατευτικό υλικό, κατά την αρχή της σαρώσεώς της στον αξονικό τομογράφο. Φαίνονται καθαρά οι κειρίες από λινό με τις οποίες οι ταριχευτές την περιτύλιξαν. © Copyright Hellenic Institute of Egyptology.

μακιώτης, ο Δρ Κώστας Νικολέντζος, αρχαιολόγος και τμηματάρχης Κυπριακών και Ανατολικών Αρχαιοτήτων ΕΑΜ , η Δρ Μαρία Λαγογιάννη, αρχαιολόγος και πρώην διευθύντρια ΕΑΜ, η εξειδικευμένη Εταιρεία Μεταφορών Ορφεύς Μπεϊνόγλου, καθώς και η Ελληνική Αστυνομία που ανέλαβε την ασφαλή συνοδεία των σορών. ΚΥΦ Ι
— Δρ Μαραβέλια, τι ακριβώς είναι το κυφί και πώς συνδέεται με το κομμάτι της Φαρμακευτικής και της Ιατρικής; Το αρχαίο αιγυπτιακό κυφί ήταν περίφημο είδος θυμιά ματος (σημαντικές αναφορές υπάρχουν στον Πλούταρ χο, στον Γαληνό και στον Διοσκορίδη), αρωματική αλλά και φαρμακευτική ουσία. Αποτελείτο από 16 συστατι κά, μεταξύ των οποίων: αρωματικός κάλαμος (Acorus calamus L.), άνθη ακακίας (Acacia nilotica L.), μαστίχη (Pistacia lentiscus L.), σταφίδες και οίνος (Vitis vinifera L.), μύρο (Commiphora myrrha Engl.), μέλι κ.λπ. Οι αρ χαιότερες συνταγές παρασκευής του απαντώνται σε επιγραφές στο Ναό του Ωρου στο Edfu (δύο συνταγές: 2ος αι. π.Χ.) και στο Ναό της Ισιδος στη Συήνη (Aswan, μία συνταγή: 3ος αι. π.Χ.), ενώ η ιατρική του χρήση αναφέρεται και στο φημισμένο Ιατρικό Πάπυρο Ebers (περ. 1555 π.Χ.). — Και πού εμπλέκεστε ως ερευνήτρια σε αυτό το κομμάτι; Το Ελληνικό Ινστιτούτο Αιγυπτιολογίας, σε στενή συνερ γασία με ειδικούς από την Αιγυπτιολογία, τη φαρμακευ τική
| 145 | ΣΥΝΕΝΤΕΥΞΗ μούμιες σχετίζονται με το Ιερατείο της Πανοπόλεως της Μέσης Αιγύπτου, δηλαδή ανήκαν σε ανθρώπους που συνέβαλαν ιδιαιτέρως στην αιγυπτιακή κοινωνία κατά την πτολεμαϊκή περίοδο. — Εκτός των προαναφερόμενων επιστημόνων, ποιοι άλλοι έλαβαν μέρος στο ερευνητικό σας πρόγραμμα; Είναι η Αργυρώ Γρηγοράκη, έφορος της Αιγυπτιακής Συλλογής του ΕΑΜ, η Δρ Άννα-Βασιλική Καραπαναγιώ του,
αρχαιολόγος και διευθύντρια ΕΑΜ, ο πρόεδρος του Ομίλου Ιατρικό Αθηνών Γεώργιος Αποστολόπουλος και ο διευθύνων σύμβουλος του Ομίλου Ιατρικό Αθηνών Βασίλειος Αποστολόπουλος, ο οικονομικός διευθυντής του ομίλου Εμμανουήλ Μαρκόπουλος,
Ερευνητικού
Μία από τις πέντε μούμιες του Εθνικού Αρχαιολογικού Μουσείου που εξετάσθηκαν με μη επεμβατική απεικόνιση, περιτυλιγμένη με ειδικό προστατευτικό υλικό,
την αρχή της σαρώσεώς της στον
©
Άλλο στιγμιότυπο από τη διαδικασία καταγραφής των αποτελεσμάτων της αξονικής τομογραφίας για τη Μούμια 3344 της Αιγυπτιακής Συλλογής του ΕΑΜ. ©
Hellenic
of Egyptology.
ΚΑΙ ΑΡΧΑ Ι Α ΑΙΓΥΠΤΙΑΚ Η ΧΛΩΡ Ι ΔΑ
και την ιατρική επιστήμη, προέβη στην ανάπτυξη συνεχώς ανανεούμενου
Προγράμματος
κατά
αξονικό τομογράφο.
Copyright Hellenic Institute of Egyptology. Μία άλλη από
Copyright
Institute
Αρχαιοβοτανικής, σκοπός του οποίου είναι η αναπαρα σκευή του κυφίου εργαστηριακώς (in vitro) και η πειρα ματική εφαρμογή (στο πλαίσιο των διεθνών συνεργειών μας και των δράσεων Πειραματικής Αρχαιολογίας) των αντιμικροβιακών, αντιβακτηριδιακών, αντιμυκητιακών και άλλων ιατροφαρμακευτικών ιδιοτήτων του σε μι κροοργανισμούς, όπως το Gram αρνητικό βακτήριο Escherichia coli M. και ο μύκητας Candida parapsilosis L. & T.
— Το κυφί, αν καταλαβαίνω καλά, έχει σημαντικές αντιμικροβιακές ιδιότητες. Ακριβώς. Προσφάτως μάλιστα, έγιναν πειράματα και με τους Gram θετικούς κόκκους Staphylococcus albus/ epidermidis R./W. & W. και Staphylococcus aureus R., τα αποτελέσματα των οποίων (τουλάχιστον προς το παρόν) βρίσκονται υπό επεξεργασία. Η περαιτέρω ανά πτυξη και εξέλιξη του Ερευνητικού μας Προγράμματος θα πραγματοποιηθεί σε συνεργασία με συναδέλφους από την Ουγγαρία και θα επιστεφθεί με τη δημιουργία Βάσεως Δεδομένων για την αρχαία αιγυπτιακή (ιδίως ιατροφαρμακευτική)
Δείγμα καλλιεργειών E. coli and C. parapsilosis, επί τρυβλίων Mac Conkey Agar Petri, με τα αποτελέσματα του υποκαπνισμού τους από το παρασκευασθέν κύφι, το οποίο φαίνεται ότι καθυστερεί και εμποδίζει την ανάπτυξή τους. Το πείραμα έγινε το 2022 στο Εργαστήριο της Δρος Έλσας Φαβίου.


© Copyright Hellenic Institute of Egyptology.
σκευή και πλήρη μελέτη του, καθώς και την εξέταση των ιατροφαρμακευτικών ιδιοτήτων των συστατικών του δημοσιεύθηκε επιτυχώς σε διεθνή τόμο Πρακτικών Συνεδρίου (βλ. Maravelia & Filianos 2020, Archaeopress Egyptology 30, Oxford, σσ. 257-303). Στο εν λόγω άρ θρο επιχειρήθηκε επιπλέον, για πρώτη φορά, συγκριτική μελέτη των εννέα κοινών συστατικών του κυφίου με το Άγιον Μύρον (που περιέχει 57 συστατικά, εκ των οποίων τα 55 φυτικά). Η εργασία μας για την επίδραση του κυφί ου, μέσω υποκαπνισμού, στις καλλιέργειες μικροοργανι
σμών επί τρυβλίων Petri είναι υπό δημοσίευση επίσης σε διεθνή τόμο πρακτικών Συνεδρίου (βλ. Maravelia, Faviou & Filianos 2022, in press | πρβλ. επίσης http://ibisz.iif.hu/ ozirisz/2021/07/23/abstracts-2021/). Ας σημειωθεί ότι ο υποκαπνισμός των καλλιεργειών μικροοργανισμών διά του κυφίου συντελεί σημαντικά στην καθυστέρηση της αναπτύξεώς τους. Προς το παρόν, λόγω του ότι είναι υπό δημοσίευση η εργασία μας δεν θα δώσουμε περισσότερες λεπτομέρειες. — Ποιοι επιστήμονες έλαβαν μέρος στην εργασία αυτή; Στα μέλη της επιστημονικής μας ομάδας, εκτός από εμένα την ίδια, έλαβαν μέρος η Δρ Έλσα Φαβίου, μι κροβιολόγος και βιοπαθολόγος και μέλος του Ινστιτού του, καθώς και ο Μάρκος Φιλιάνος, φαρμακοποιός, ειδικός στην Ιατρική Βοτανολογία, επίσης μέλος του Ινστιτούτου. Ενώ στους υπόλοιπους συντελεστές του ερευνητικού αυτού προγράμματος συμπεριλαμβάνο νται η Δρ Hedvig Győry, γενική γραμματέας HEFS/AEC (Ουγγαρία) - αιγυπτιολόγος του Μουσείου Καλών Τε χνών της Βουδαπέστης, ειδική στην Αρχαιοβοτανική, ακούραστη διοργανώτρια σχετικών συνεδρίων και μέ λος του Ινστιτούτου, καθώς και ο Κωνσταντίνος Θάνος, φοιτητής Σεμιναρίου Αιγυπτιολογίας του Ινστιτούτου και φοιτητής Αρχιτεκτονικής Πολυτεχνείου Πατρών, επίσης μέλος του Ινστιτούτου. ■
146 |
—
χλωρίδα.
Έχουμε αποτελέσματα από αυτήν την εργασία; Ήδη η εκτενής εργασία μας για το κυφί, την αναπαρα
Δείγμα του in vitro αναπαρασκευασθέντος κυφίου. Αυτό το εγχείρημα Πειραματικής Αρχαιολογίας έγινε αρχικώς το 2017 στο Εργαστήριο του κ. Μάρκου Φιλιάνου. © Copyright Hellenic Institute of Egyptology.
δομή υγείας στην Ελλάδα με ISO ΕΝ 15224:2016 αποδόθηκε από το Φορέα Πιστοποίησης TUV NORD (TUV HELLAS) στη Στεφανιαία Μονάδα (Μονάδα εμφραγμάτων) και στο Aιμοδυναμι κό Εργαστήριο της Πανεπιστημιακής Καρδιολογικής Κλινικής του ΠΓΝ Αλεξανδρούπολης για την παροχή Υπηρεσιών Υγείας που προσφέρει (δ/ντής καθηγητής Καρδιολογίας Δημήτριος Ν. Τζιακάς). Επίσης πιστοποιήθηκε με ISO 900:2015 η συμμετο χή της Πανεπιστημιακής Καρδιολογικής Κλινικής σε πα γκόσμιες πολυκεντρικές κλινικές μελέτες (η μοναδική πιστοποίηση στην Ελλάδα σε αυτόν τον τομέα). Μεταξύ άλλων στην έκθεση αξιολόγησης επισημαίνεται ότι η

καρδιολόγους, δίνεται έμφαση σε πρωτοπόρες μεθό δους διαδραστικής διδασκαλίας και στην προώθηση της σταδιοδρομίας των νέων συναδέλφων, τόσο στο προπτυχιακό όσο και στο μεταπτυχιακό επίπεδο. Η επίτευξη της ποιότητας των θεραπευτικών υπη ρεσιών μέσα στο καθημερινό περιβάλλον μιας «ενερ γούς και μαχόμενης» Κλινικής, αν και δυσχερής, οφεί λει να είναι πολύ καλά τεκμηριωμένη και επίσης πρέπει να αποδεικνύεται κατ’ αρχάς με την πιστοποίησή της από συγκεκριμένες διαδικασίες και ελέγχους από θε σμοθετημένα όργανα της Πολιτείας. Παράλληλα, η αξιολόγηση της ποιότητας στην παροχή Υπηρεσιών Υγείας αποτελεί θέμα ζωτικής σημασίας τόσο για τους εργαζόμενους ιατρούς και νοσηλευτές όσο και για το ευρύτερο κοινωνικό σύνολο. Η διοίκηση της Μονάδας προχώρησε στο σχεδια
Στο διδακτικό της έργο, που αφορά προπτυχιακούς και μεταπτυχιακούς φοιτητές, υποψήφιους διδάκτορες και ειδικευόμενους
| 147 | ΕΙΔΗΣΕΙΣ Η ΠΡ ΩΤΗ ΠΙΣΤΟΠΟ Ι ΗΣΗ σε
ον
ανακαινισμένα Αιμοδυναμικά Εργαστήρια, Στεφανιαία Μονάδα, Ηλεκτροφυσιολογικό και Υπερηχοκαρδιογρα φικό Εργαστήριο
δημόσια
Πανεπιστημιακή Καρδιολογική Κλινική διαθέτει τις πλέ
σύγχρονες υποδομές με δύο πρόσφατα, πλήρως
(2D,3D), καθώς και αυτόνομο Εργα στήριο Βασικής Έρευνας. Στο Εργαστήριο Βασικής Έρευνας αναπτύσσεται έντονη ερευνητική δραστηριότητα με διεθνούς απή χησης ερευνητικές εργασίες και δημοσιεύσεις στην Αθηροσκλήρωση και Στεφανιαία Νόσο, στην Καρδιακή Ανεπάρκεια, στις Βαλβιδικές Παθήσεις και τη Θρόμ βωση -Αντιθρομβωτική Θεραπεία.
σμό του Συστήματος Ποιότητας σύμφωνα με τα Πρό τυπα ΕΝ 15224: 2016/ISO9001:2015, αντιλαμβανόμενη ότι το προσωπικό είναι ευαισθητοποιημένο και διαθέ σιμο να χρησιμοποιήσει συστηματικές προσπάθειες για την καλύτερη και αποδοτικότερη χρησιμοποίηση των διαθέσιμων ανθρωπίνων και υλικών πόρων, ενώ παράλληλα έπρεπε να τεκμηριωθεί η άριστη και υψη λών προδιαγραφών λειτουργία της. Τέλος, κρίθηκε ως αναγκαία μία βελτιωμένη οργάνωση των διαδικασιών και επικοινωνιών της με όλα τα εμπλεκόμενα στη λει τουργία της μέρη. ■ ΠΑΝΕΠΙΣΤΗΜΙΑΚΟ ΓΕΝΙΚΟ ΝΟΣΟΚΟΜΕΙΟ ΑΛΕΞΑΝΔΡΟΥΠΟΛΗΣ Πιστοποίηση Αιμοδυναμικού Εργαστηρίου και Στεφανιαίας Μονάδας
από την 1η Οκτω βρίου τα καθήκοντα του προέδρου και γενικού διευθυ ντή της GSK στην Ελλάδα και είναι πλέον υπεύθυνος για το σύνολο της εταιρικής δραστηριότητας της εταιρείας στη χώρα μας. «Είναι εξαιρετική τιμή για εμένα η δυνατότητα που μου δίδεται να επιστρέψω στην Ελλάδα και να συμβά λω ξανά στην επιτυχία της δυναμικής ομάδας της GSK Ελλάδας, αξιοποιώντας την εμπειρία μου από άλλες αγορές. Στην GSK ενώνουμε καθημερινά την επιστήμη, την τεχνολογία και το ταλέντο για να ξεπεράσουμε μαζί τις ασθένειες. Στόχος μας είναι να επηρεάσουμε θετικά, σε παγκόσμιο επίπεδο, την υγεία 2,5 δισ. ανθρώπων τα επόμενα 10 χρόνια. Η Ελλάδα είναι μία χώρα στρατη γικής σημασίας για την GSK, και η δέσμευση όλου του ελληνικού οργανισμού, αλλά και η δική μου προσωπικά είναι να εντείνουμε τις προσπάθειές μας στη δημιουργία βιώσιμων υγειονομικών


και διδακτορικού διπλώματος στη Χημεία και στη Φαρ μακευτική Τεχνολογία από το Πανεπιστήμιο Universita degli Studi di Messina στην Ιταλία, ενώ έχει εκτεταμένη εμπειρία στη φαρμακευτική αγορά, έχοντας αναλάβει θέσεις ευθύνης σε διάφορες φαρμακευτικές εταιρεί ες. Στην GSK ξεκίνησε την καριέρα του το 2015 στην Ιταλία ως Business Unit Director για το χαρτοφυλάκιο των εμβολίων και στην πορεία ανέλαβε θέσεις στρατη γικής σημασίας σε διαφορετικές αγορές, αποκτώντας σφαιρική εμπειρία σε τοπικό, περιφερειακό, αλλά και παγκόσμιο επίπεδο. Επόμενος σταθμός στην ευρωπαϊκή πορεία του ήταν η Ελλάδα το 2016, οπότε και ανέλαβε για περίπου 3 χρόνια το ρόλο του Business Unit Director διαδοχικά για όλα τα εμπορικά τμήματα του ελληνικού οργανισμού (εμβόλια, αναπνευστικά νοσήματα, HIV κ.λπ.), αποκτώντας πολυδιά στατη εμπειρία και εξοικείωση με την ελληνική αγορά. Την καριέρα του ακολούθησε η στρατηγικής σημασίας αγορά της Ισπανίας, όπου διατέλεσε Business Unit Director για το χαρτοφυλάκιο των ειδικών θεραπειών και εμβολίων, ενώ στη συνέχεια η ανάληψη ρόλου σε παγκόσμιο επί πεδο, υπηρετώντας από την GSK Σιγκαπούρης τη θέση του Vice President & Global Commercial Lead για το αναπνευστικό χαρτοφυλάκιο της εταιρείας. Η GSK είναι μια παγκόσμια βιοφαρμακευτική
πολλά, για την εκπλήρωση του οράματός μας», τόνισε κατά την ανάληψη των νέων του καθηκόντων. Ο Antonino Biroccio είναι κάτοχος πτυχίου Χημείας
148 |
συνθηκών μέσα από στρατηγι κές συμμαχίες με τους εταίρους μας στο οικοσύστημα της υγείας, ώστε η πρόσβαση των ασθενών
Ο ANTONINO BIROCCIO ΑΝ Ε ΛΑΒΕ
στις και νοτόμες θεραπείες και στην πρόληψη να είναι άμεση και απρόσκοπτη. Είμαι ενθουσιασμένος για αυτή τη νέα πρόκληση και ανυπομονώ να συνεργαστώ με μια τόσο ικανή και αφοσιωμένη ομάδα, με την οποία ήδη μας ενώνουν
εται ρεία με σκοπό να ενώσει την επιστήμη, την τεχνολογία και το ταλέντο ώστε να ξεπεράσουμε τις ασθένειες μαζί. Για περισσότερες πληροφορίες, επισκεφθείτε τη διεύθυνση gsk.com/company. ■ Ο ANTONINO BIROCCIO νέος πρόεδρος και γενικός διευθυντής της GSK Ελλάδος
φως της δημοσι ότητας το τελευταίο διάστημα, η Γραμμή Βοήθειας του Ελληνικού Κέντρου Ασφαλούς Διαδικτύου (Help-line.gr) του Ιδρύματος Τεχνολογίας και Έρευνας δίνει χρήσιμες συμβουλές σε γονείς για την πρόληψη της σεξουαλικής αποπλάνησης ανηλίκων μέσω Διαδικτύου (grooming). Με τον όρο διαδικτυακό grooming εννοούμε τη διαδι κασία της σεξουαλικής αποπλάνησης παιδιών, όπου ο θύτης δημιουργεί αρχικά μια σχέση εμπιστοσύνης με το παιδί και το εισάγει αργά και σταδιακά στο σεξουαλικό στοιχείο. Ο απώτερος σκοπός είναι η σεξουαλική εκμε τάλλευση του ανηλίκου. Το grooming και η σεξουαλική παρενόχληση μέσω Διαδικτύου αποτελούν ποινικά κο λάσιμες πράξεις (Αρθρο 337-Ποινικός κώδικας, Νόμος 4619/2019). Χρήσιμες συμβουλές για γονείς: • Τα παιδιά είναι σημαντικό να μάθουν από νωρίς ότι το Διαδίκτυο είναι ένας υπέροχος κόσμος στον οποίο θα πρέπει να είμαστε προσεκτικοί, όπως ακριβώς και στην πραγματική ζωή. • Ενημερώνουμε και συμφωνούμε με τα παιδιά ότι δεν πρέπει να επικοινωνούν με αγνώστους και ούτε να κανονίζουν διά ζώσης συναντήσεις με ανθρώπους που γνώρισαν διαδικτυακά. • Ενημερώνουμε τα παιδιά ότι η σεξουαλική δραστη ριότητα μεταξύ ενηλίκων και ανηλίκων απαγορεύεται
αυστηρά και αποτελεί κακούργημα. • Είμαστε σε επιφυλακή για τυχόν ενδείξεις, όπως για παράδειγμα ακραία αλλαγή συμπεριφοράς του παι διού, κρύψιμο διαδικτυακών συνηθειών και παραλαβή ακριβών δώρων που δεν δικαιολογούνται. • Ενημερώνουμε το παιδί για τα διαθέσιμα εργα λεία ασφαλείας. Αν κάποιος το ενοχλήσει διαδικτυακά, είναι σημαντικό να ξέρει ότι μπορεί να αποθηκεύσει το μήνυμα ή τη συζήτηση. Ένας εύκολος τρόπος να το κάνει αυτό είναι να χρησιμοποιήσει το print screen και να αποθηκεύσει την εικόνα σε ένα αρχείο. Πολλές υπηρεσίες έχουν εργαλεία που δίνουν τη δυνατότητα να μπλοκάρει και να αναφέρει χρήστες που γίνονται ενοχλητικοί. • Το σημαντικότερο όλων: Διατηρούμε μια καλή, στενή και δυνατή σχέση με τα παιδιά, ούτως ώστε να απευθυνθούν σε εμάς ακόμα και σε περίπτωση που κάνουν κάποιο λάθος. Για ψυχολογική υποστήριξη και συμβουλές μπορείτε να απευθυνθείτε στους εξειδικευμένους ψυχολόγους της Γραμμής Βοήθειας Help-line.gr διαθέσιμη δωρεάν τηλε φωνικά στο 210-6007686. Ακόμα, οι ειδικοί της Γραμμής είναι διαθέσιμοι μέσω του e-mail: info@help-line.gr και μέσω chat συμβουλευτικής καθημερινά 14:00-17:00. Όλες οι κλήσεις και οι αναφορές είναι ανώνυμες και εμπιστευτικές. ■
| 149 | ΕΙΔΗΣΕΙΣ ΓΕΝΙΚΟ ΝΟΣΟΚΟΜΕ Ι Ο «ΒΕΝΙΖ Ε ΛΕΙΟ-ΠΑΝ Α ΝΕΙΟ» Bronze βραβείο στα Healthcare Business Awards 2022 ΜΕ ΤΟ BRONZE ΒΡΑΒΕ Ι Ο ΤΙΜ Η ΘΗΚΕ το Γενικό Νοσοκομείο Ηρακλείου «Βενιζέλειο-Πανάνειο» στη διοργάνω ση Healthcare Business Awards 2022. Το νοσοκομείο ξεχώρισε στην κατηγορία «Αποτελεσματική Διοίκηση Δημοσίου Νοσοκομείου», αποσπώντας το βραβείο για τη διαδικτυακή πλατφόρμα «e-praktiki» που δημιουργήθηκε για την υποστήριξη των διαδικασιών πρακτικής άσκησης φοιτητών/σπουδαστών στο Γ.Ν. «Βενιζέλειο-Πανάνειο» και τη συνεργασία με τους φορείς εκπαίδευσης. Η πλατφόρμα στοχεύει στην ενίσχυση της δικτύωσης, της επικοινωνί ας και παράλληλα στην εξοικονόμηση ανθρώπινων και υλικών πόρων μέσω του τρίπτυχου «λιγότερος χρόνος, λιγότερο χαρτί, λιγότερα χρήματα». Η πλατφόρμα «e-praktiki» αποτελεί ένα προϊόν σύμπραξης του Γραφείου Εκπαίδευσης Νοσηλευτικής Υπη ρεσίας, του Τμήματος
Διαχείρισης Ανθρώπινου Δυναμικού που
και
Η εν λόγω διάκριση είναι μια σημαντική ένδειξη αναγνώρισης και ηθικής επιβράβευσης της προσπάθειας των εργαζομένων και της Διοίκησης του νοσοκομείου για τη συνεχή βελτίωση της ποιότητας των παρεχόμενων υπηρεσιών και την
ΜΕ ΑΦΟΡΜ Η ΤΑ ΟΣΑ Ε ΧΟΥΝ
Πληροφορικής και του Τμήματος
υλοποιήθηκε πρωτοβούλως
χωρίς κόστος.
αποτελεσματική προσαρμογή στις σύγχρονες απαιτήσεις και συνθήκες, θέτοντας τον πήχυ ολοένα και πιο ψηλά σε κάθε επίπεδο. ■
ΔΕΙ το
Πώς να προλάβετε τη διαδικτυακή αποπλάνηση των παιδιών σας
ΠΟΛΥΪΑΤΡΕ Ι Α MEDIFIRST είναι ιατρικές μονάδες πρωτοβάθμιας φροντίδας υγείας της INTERAMERICAN. Λειτουργούν 24 ώρες το 24ωρο, 365 ημέρες το χρόνο και μπορούν να καλύψουν τις ανάγκες σας για υψηλής ποιότητας υπηρεσίες πρόληψης, διάγνωσης, θεραπείας και διαχείρισης χρόνιων ασθενειών, είτε αυτές αφορούν προγραμματισμένα ή έκτακτα περιστατικά. Όλες οι ειδικότητες και τα διαγνωστικά κέντρα που χρειάζεστε, την ώρα που τις χρειάζεστε. Μπορείτε να κλείσετε ραντεβού με γιατρούς δια φόρων ειδικοτήτων από νωρίς το πρωί μέχρι αργά το απόγευμα, ενώ μπορείτε να εξεταστείτε από γιατρούς ειδικότητας Γενικής Ιατρικής, οποιαδήποτε ώρα της ημέρας, οποιαδήποτε ημέρα της εβδομάδας, χωρίς ραντεβού. ΔΙΑΓΝΩΣΤΙΚ Α ΤΜ Η ΜΑΤΑ Ακτινολογικό • Ακτινογραφίες • Μαγνητικές τομογραφί ες (Medifirst Αμαρουσίου) • Ψηφιακές μαστογραφίες • Καρδιολογικό • Μικροβιολογικό • Υπερήχων • Μέτρη ση οστικής
για να είστε σίγουροι ότι τίποτα δεν θα ξεφύγει από την προσοχή του γιατρού σας.
6. Στο MEDIFIRST μπορείτε να πραγματοποιήσετε προληπτικό έλεγχο, ειδικά διαμορφωμένο για εσάς, ανάλογα με την ηλικία και το φύλο σας.
7. Στο MEDIFIRST μπορείτε να κάνετε το ετήσιο Check Up σας και το Σάββατο.


8. Το MEDIFIRST σάς εξασφαλίζει ταχύτατη εξυπη ρέτηση και πλήρη εργαστηριακό έλεγχο σε ένα από τα πλέον αξιόπιστα διαγνωστικά βιοχημικά εργαστήρια.
9. Με 15 χρόνια επιτυχημένης λειτουργίας στα νότια προάστια της Αθήνας, το MEDIFIRST διαθέτει σήμερα δύο μονάδες πρωτοβάθμιας φροντίδας, στην Αργυ ρούπολη και στο Μαρούσι.
10. Στο MEDIFIRST θα βρείτε προσωπική φροντίδα και φιλική αντιμετώπιση από άριστα εκπαιδευμένο ια τρικό και διοικητικό προσωπικό, σε άνετο, μοντέρνο περιβάλλον.
σας 24 ώρες το 24ωρο, 365 ημέρες το χρόνο, για την αντιμε τώπιση έκτακτων περιστατικών από ιατρούς ειδικότη τας Γενικής Ιατρικής.
4. Το MEDIFIRST μπορεί να σας προσφέρει τη δια χείριση, παρακολούθηση και υποστήριξη που χρειάζο νται οι χρόνιες παθήσεις.
5. Το MEDIFIRST φυλάσσει το ιατρικό σας ιστορικό
Τα πολυϊατρεία Medifirst είναι ανοιχτά 24 ώρες το 24ωρο, 365 μέρες το χρόνο Πολυϊατρείο MEDIFIRST Αργυρούπολη Μαρίνου Γερουλάνου 1 & Πολεμιστών, T 210 9919222 Πολυϊατρείο MEDIFIRST Μαρούσι Λεωφόρος Κηφισίας 16 & Χαλεπά 1, T 211 1054900
150 |
πυκνότητας
Μαρούσι) • Τμήμα Check Up 10 ΛΟ ΓΟΙ ΓΙΑ ΝΑ ΕΜΠΙΣΤΕΥΤΕ Ι ΤΕ ΤΗ ΦΡΟΝΤ Ι ΔΑ ΤΗΣ ΥΓΕ Ι ΑΣ ΣΑΣ ΣΤΟ MEDIFIRST 1. Στο MEDIFIRST θα βρείτε στον ίδιο χώρο άρι στους γιατρούς όλων σχεδόν των ειδικοτήτων. 2. Στο MEDIFIRST έχετε τη δυνατότητα να κάνετε άμεσα τις διαγνωστικές εξετάσεις που θα σας συστή σει ο γιατρός 3. Το MEDIFIRST βρίσκεται στη διάθεσή
ΤΑ
(MEDIFIRST
Παύλου Μελά
■ Ο ΜΙΛΟΣ IΝΤΕRAMERICAN-ΠΟΛΥΪΑΤΡΕ Ι Α MEDIFIRST Γιατροί και διαγνωστικές εξετάσεις σε ένα σημείο
Πολυϊατρείο MEDIFIRST Περιστέρι
5, T 211 1075300
Αθη νών (ΕΚΠΑ) και το Εθνικό Κέντρο Αξιολόγησης της Ποιό τητας & Τεχνολογίας στην Υγεία (ΕΚΑΠΤΥ) προσφέρουν για πρώτη φορά ένα πλήρες, εξ αποστάσεως, εκπαι δευτικό πρόγραμμα εξειδίκευσης στα Ιατροτεχνολογικά Προϊόντα (Medical Devices). Η Βιοϊατρική Τεχνολογία αποτελεί τομέα αιχμής με υψηλή ζήτηση στην αγορά εργασίας και απαιτεί σύγ χρονες επαγγελματικές γνώσεις και δεξιότητες. Μέσω του καινοτόμου αυτού προγράμματος θα εξειδικευ τείτε στο κανονιστικό πλαίσιο και τις απαιτήσεις στην έρευνα, στην ανάπτυξη, στην αξιολόγηση, στην πιστο ποίηση, στη διαχείριση και την εμπορία των ιατροτε χνολογικών προϊόντων (Ι/Π). Το πρόγραμμα απευθύνεται σε επαγγελματίες και στελέχη επιχειρήσεων /οργανισμών που δραστηριο
Στο πρόγραμμα αυτό θα μάθετε:
• Ποιες είναι οι διεθνείς τάσεις στη βιοϊατρική τε χνολογία.
• Πώς διεξάγονται οι κλινικές μελέτες των Ι/Π.
• Πώς οργανώνεται και ελέγχεται η αγορά των Ι/Π.
• Ποιο είναι το κανονιστικό πλαίσιο των Ι/Π (MDR, πιστοποίηση, συμμόρφωση, σήμανση CE κ.λπ.).
• Πώς υποβάλλονται και αξιολογούνται ο τεχνικός και ο κλινικός φάκελος ενός Ι/Π.
• Ποιες είναι οι απαιτήσεις των πρότυπων συστημά των διαχείρισης Ι/Π ISO 9001 και 13485.

• Πώς διεξάγονται οι εσωτερικές επιθεωρήσεις ποιότητας των Ι/Π.
• Ποιες είναι οι διαδικασίες διαχείρισης της ποιό τητας και της ασφάλειας της βιοϊατρικής τεχνολογίας.
• Ποιες είναι οι βασικές αρχές των οικονομικών της υγείας.
• Τι προβλέπει η νομοθεσία για την προστασία των προσωπικών δεδομένων (GDPR).
Υγεία, τον Εθνικό Οργανισμό Παροχής Υπηρεσιών Υγείας (ΕΟΠΥΥ), τον Εθνικό Οργανισμό Διαπίστευσης (ΕΣΥΔ) και άλλους φορείς του δημόσιου και ιδιωτικού τομέα, από την Ελλάδα και το εξωτερικό. Το πρόγραμμα διαρκεί 12 εβδομάδες και με την επιτυχή ολοκλήρωσή του απονέμεται Πιστοποιητικό Εξειδίκευσης με 8 πιστωτικές μονάδες (ECVET).
• Ποιες είναι οι διαδικασίες υλικοεπαγρύπνησης, αποζημίωσης και διάθεσης Ι/Π στην αγορά. Ακαδημαϊκός υπεύθυνος του προγράμματος: Θεό δωρος Παπαϊωάννου, καθηγητής Βιοϊατρικής Τεχνο λογίας, Ιατρική Σχολή ΕΚΠΑ. Περισσότερες πληροφορίες σχετικά με το εκπαι δευτικό πρόγραμμα, την εγγραφή, το κόστος συμ μετοχής και την έναρξη των μαθημάτων παρέχονται στην ιστοσελίδα https://biotech.cce.uoa.gr | e-mail: biotech-cce@uoa.gr | alexandratos@ekapty.gr ■
| ΕΙΔΗΣΕΙΣ | 151 TΟ ΕΘΝΙΚΟ ΚΑΙ ΚΑΠΟΔΙΣΤΡΙΑΚΟ
Εκπαιδευτές είναι καταξιωμέ νοι επιστήμονες και επαγγελματίες στον τομέα των τεχνολογιών και υπηρεσιών υγείας από την Ιατρική Σχολή του Πανεπιστημίου Αθηνών, το Εθνικό Κέντρο Αξιολόγησης της Ποιότητας & Τεχνολογίας στην
Πανεπιστήμιο
ποιούνται στον τομέα της βιοϊατρικής τεχνολογίας και των υπηρεσιών υγείας.
ΕΚΠΑ Νέο πρόγραμμα εξειδίκευσης online στα ιατροτεχνολογικά προϊόντα!
αποκατάστασης για καρκίνο μαστού. Ήταν μια πολύωρη χειρουργική επέμβαση με την άψογη συνεργασία δύο χειρουργικών ομάδων, όπου νεαρός ασθενής με με ταστατικό γονιδιακό καρκίνο μαστού, έπειτα από προ εγχειρητική χημειο - ακτινο - θεραπεία, υποβλήθηκε σε σύγχρονη αμφοτερόπλευρη ολική μαστεκτομή και πλαστική αποκατάσταση μαστών, σε ένα χειρουργείο. Ειδικότερα συνεργάστηκαν η Ελένη Ι. Ευφραιμίδου, καθηγήτρια Χειρουργικής ΔΠΘ, εξειδικευμένη στη χει ρουργική μαστού, που υπηρετεί στην Α' Πανεπιστημια κή Χειρουργική Κλινική του ΠΓΝΑ υπό τη διεύθυνση του Αλέξανδρου Χ. Πολυχρονίδη, καθηγητή Χειρουργικής & πρύτανη του ΔΠΘ, και ο Νικόλαος Παπαδόπουλος, καθηγητής Πλαστικής Χειρουργικής ΔΠΘ & διευθυντής
για την αντιμετώπιση του ασθενούς υπήρξε ιατρική μέριμνα και συνεργασία από τους ιατρούς της Κλινικής Παθολογικής Ογκολογίας ΔΠΘ, της Κλινικής Ακτινοθεραπευτικής Ογκολογίας ΔΠΘ, της Παν/κής Αναισθησιολογικής Κλινικής & του Αναισθησιολογικού Τμήματος, του Εργαστηρίου Διαγνωστικής και Θερα πευτικής Ακτινολογίας ΔΠΘ & ΕΣΥ, του Εργαστηρίου Παθολογικής Ανατομικής ΔΠΘ, καθώς και από τους νοσηλευτές των Γενικών Χειρουργείων και του Αναι σθησιολογικού Τμήματος του ΠΓΝ Αλεξανδρούπολης. Η πραγματοποίηση τέτοιων σημαντικών επεμβάσεων στο Πανεπιστημιακό Γενικό Νοσοκομείο Αλεξανδρού πολης αποτελούν το πιο αισιόδοξο μήνυμα για το μήνα της ενημέρωσης και της πρόληψης του καρκίνου του μαστού. ■
152 | ΓΕΝΙΚΟ ΝΟΣΟΚΟΜΕ Ι Ο «ΕΡΥΘΡ ΟΣ ΣΤΑΥΡ ΟΣ» Αναβάθμιση υπηρεσιών με το σύστημα DRG ΤΗΝ Ε ΝΤΑΞΗ ΤΟΥ ΓΕΝΙΚΟΥ ΝΟΣΟΚΟΜΕ Ι ΟΥ «Ερυθρός Σταυρός» στο νέο σύστημα DRG ανακοίνωσε το Κέντρο Τεκμηρίωσης και Κοστολόγησης Νοσοκομειακών Υπηρεσιών (ΚΕΤΕΚΝΥ)-Ελληνικό Ινστιτούτο DRG. Αποδεικνύο ντας στην πράξη πως βρίσκεται μπροστά από τις εξελίξεις, ο «Ερυθρός Σταυρός» είναι το πρώτο νοσοκομείο της 1ης ΥΠΕ που υιοθετεί το σύστημα DRG και προχωρεί στην ψηφιακή αναβάθμιση των υπηρεσιών του. Ήδη, το νοσοκομείο βρίσκεται στη διαδικασία προσαρμογής των πληροφοριακών του συστημάτων και της διασύνδεσής του με τον grouper του Ελληνικού Ινστιτούτου DRG. Επίσης, το ΚΕΤΕΚΝΥ έχει ήδη ολοκληρώσει την πρώτη φάση των εκπαιδεύσεων του ιατρικού προσωπικού. Με τις συντονισμένες προσπάθειες της διοίκησης και του ιατρικού προσωπικού του νοσοκομείου και τη ση μαντική συμβολή της υποδιοικήτριας της 1ης ΥΠΕ Μ. Οικονόμου, πραγματοποιήθηκαν σε πολύ σύντομο χρονικό διάστημα όλες οι απαιτούμενες αλλαγές στα πληροφοριακά συστήματα, αλλά και στις διαδικασίες λειτουργίας του νοσοκομείου. Το προσεχές διάστημα με Κοινή Υπουργική Απόφαση θα ενταχθεί το σύνολο των νοσοκομείων στο σύστημα DRG. Η ένταξη αυτών των νοσοκομείων θα ακολουθήσει το πολύ επιτυχημένο μοντέλο της 7ης ΥΠΕ. Ο οργανισμός δεσμεύεται για ακόμη περισσότερες δράσεις προς την πλήρη και καθολική ένταξη όλων των νοσοκομείων της χώρας στο σύστημα DRG, καθώς και την ψηφιακή αναβάθμιση των υπηρεσιών υγείας στα νοσοκομεία ολόκληρης της χώρας. ■ ΣΤΑ ΓΕΝΙΚ Α ΧΕΙΡΟΥΡΓΕ Ι Α ΤΟΥ ΠΓΝ Αλεξανδρούπο λης πραγματοποιήθηκε για πρώτη φορά συνδυασμέ νη επέμβαση ογκολογικής
ΠΑΝΕΠΙΣΤΗΜΙΑΚΟ ΓΕΝΙΚΟ ΝΟΣΟΚΟΜΕΙΟ ΑΛΕΞΑΝΔΡΟΥΠΟΛΗΣ Συνδυασμένη επέμβαση ογκολογικής χειρουργικής και πλαστικής αποκατάστασης για καρκίνο μαστού της Κλινικής Πλαστικής Χειρουργικής και Εγκαυμάτων του ΠΓΝ Αλεξανδρούπολης. Επίσης
χειρουργικής και πλαστικής
ασθενή
συνεργασί
να προσφέρει στον
και αποδοτικότερη
υγείας στο χώρο όπου αυτός διαμένει, βελτιώ νοντας την ποιότητας ζωής τόσο των ίδιων των πασχό ντων όσο και των συγγενών και των φροντιστών τους. Η κατ’ οίκον υποστήριξη παρέχεται παράλληλα με τις χημειοθεραπείες των ασθενών ή ανεξάρτητα από τη νοσοκομειακή περίθαλψη. Στο πλαίσιο αυτό προ σφέρονται ιατρικές, νοσηλευτικές, ψυχολογικές, αλλά και κοινωνικές υπηρεσίες. Οι κύριες ιατρονοσηλευτικές υπηρεσίες περιλαμβάνουν: την κλινική εξέταση, την εκτίμηση και αντιμετώπιση του πόνου, τη διαχείριση των επιπλοκών της φαρμακευτικής αγωγής ή της ίδιας της νόσου, τη λήψη βιολογικών υγρών (προς ανάλυ ση), την περιποίηση ελκών κατακλίσεων κ.ά. Βασικό στοιχείο της κατ’ οίκον νοσηλείας είναι η εκπαίδευση τόσο του ίδιου του ασθενούς στην αυ το-φροντίδα όσο και των φροντιστών του, οι οποίοι εκπαιδεύονται στη σωστή χορήγηση της φαρμακευτι κής αγωγής, στην περιποίηση και φροντίδα του ασθε νούς κ.ά. Επιπρόσθετα, παρέχεται ψυχολογική και κοινωνική υποστήριξη στους ασθενείς και τις οικογένειές τους με στόχο την αποδοχή της διάγνωσης και τη διαχείρι ση του άγχους, την ενδυνάμωση των διαπροσωπικών τους σχέσεων και την αντιμετώπιση των καθημερινών απαιτήσεων που σχετίζονται με τη φροντίδα ενός ογκο λογικού ασθενούς σε προχωρημένο στάδιο της νόσου. Ιδιαίτερα, η λειτουργία του προγράμματος της κατ’ οίκον νοσηλείας ογκολογικών ασθενών είναι βαρύ νουσας σημασίας την τρέχουσα περίοδο που αντιμε τωπίζουμε μια πανδημία, αφού δρα προστατευτικά ως προς τον ασθενή, περιορίζοντας δραστικά τόσο την πιθανότητα νόσησης από τον Covid-19 όσο και από κάθε είδους ενδονοσοκομειακή λοίμωξη, στην οποία θα μπορούσε να εκτεθεί ο ασθενής κατά την εισαγωγή του σε ένα νοσηλευτικό ίδρυμα. Συνεπώς τα οφέλη για τον ασθενή είναι πολλαπλά, ενώ επωφελείται και το οικογενειακό περιβάλλον αποφεύγοντας τις μετακινή σεις, βιώνοντας πιο ομαλά την ασθένεια στο οικείο τους περιβάλλον, ενώ και η ικανοποίηση των ασθενών και των φροντιστών από τις παρεχόμενες υπηρεσίες
υγείας είναι υψηλότερη. Ταυτόχρονα, και το σύστημα υγείας επωφελείται μέσω της αποσυμφόρησηw των νοσοκομειακών κλινών, αλλά και της εξοικονόμησης πόρων. Από τα απολογιστικά δελτία του προγράμματος κατ’ οίκον νοσηλείας ογκολογικών ασθενών Λασι θίου για το έτος 2020 προκύπτει ότι 35 ασθενείς εξυπηρετήθηκαν από το πρόγραμμα, ενώ συνολι κά πραγματοποιήθηκαν 190 κατ’ οίκον επισκέψεις. Στις επισκέψεις αυτές διενεργήθηκαν περισσότερες από 1.800 παρεμβάσεις ιατρικής, νοσηλευτικής ή άλλης φύσης από τους επαγγελματίες υγείας που στελεχώνουν τη διεπιστημονική ομάδα. Επιπρόσθετα, προσφέρθηκαν και κάποιες υπηρεσίες σε χώρο του Γ.Ν.-Κ.Υ. Νεάπολης σε ογκολογικούς ασθενείς που δεν πληρούν τις προϋποθέσεις για να ενταχθούν στο πρό γραμμα της κατ’ οίκον νοσηλείας. Το πρόγραμμα απευθύνεται σε ογκολογικούς ασθε νείς προχωρημένου ή τελικού σταδίου που κατοικούν εντός της περιοχής του Δήμου Αγίου Νικολάου και πα ρακολουθούνται από το ογκολογικό ιατρείο του ΓΝΑΝ. Η ένταξη στο πρόγραμμα γίνεται κατόπιν ενημέρωσης της επιστημονικής ομάδας σχετικά με το περιστατικό, την κατάσταση και τις ανάγκες του και αφού πληροί σχετικά κριτήρια. Για περισσότερες πληροφορίες σχε τικά με το πρόγραμμα μπορείτε να καλείτε Τρίτη και Πέμπτη πρωινές ώρες στο 2841340814. Τις υπόλοιπες ημέρες μπορείτε να απευθύνεστε στο Γραφείο Κίνησης του

| 153 | ΕΙΔΗΣΕΙΣ ΤΟ ΠΡ Ο ΓΡΑΜΜΑ ΚΑΤ’ Ο Ι ΚΟΝ ΝΟΣΗΛΕ Ι ΑΣ ογκολογικών ασθενών
είναι
Λασιθίου
το αποτέλεσμα της
ας του ΓΝΑΝ και του Γ.Ν.-Κ.Υ. Νεάπολης «Διαλυνάκειο». Στόχος του προγράμματος είναι
ογκολογικό
ποιοτικότερη
φροντίδα
στο
Γ.Ν.-Κ.Υ. ΝΕΑΠΟΛΗΣ ΛΑΣΙΘΙΟΥ «ΔΙΑΛΥΝΑΚΕΙΟ» Υπηρεσία κατ’ οίκον νοσηλείας ογκολογικών ασθενών
Διαλυνάκειου Νοσοκομείου
2841340831. ■
τον έλεγχο της ακοής σε όλα τα νεογνά πριν ακόμη εξέλθουν από το μαιευτήριο και οπωσδήποτε πριν την ηλικία των 3 μηνών. Στόχος είναι να υπάρξει έγκαιρος εντοπισμός ενός πιθανού προβλήματος, ώστε εντός του πρώτου εξαμήνου της ζωής του βαρήκοου νεο γνού να έχει ολοκλη ρωθεί ο απαραίτητος διαγνωστικός έλεγχος και να ακολουθήσει έγκαιρα η παρέμβαση αποκατάστασης της ακοής. Στην περίπτωση που εντοπισθεί πιθανό τητα βαρηκοΐας, τότε προγραμματίζεται η εξέταση των αυτόμα των ακουστικών προ κλητών δυναμικών. Εφεξής ο προληπτικός αυτός έλεγχος θα πραγμα τοποιείται σε όλα τα νεογνά που γεννιούνται στη Μαι ευτική Κλινική του Γ.Ν. Κομοτηνής. Τα Ακουστικά Προκλητά Δυναμικά του εγκεφαλικού στελέχους, καθώς και της σταθερής απόκρισης αποτε λούν ηλεκτροφυσιολογική μέθοδο που χρησιμοποιεί ται για την εκτίμηση της ακοής: • σε ασθενείς που δεν μπορούν να συνεργαστούν για τη διενέργεια συμβατικής ακοομετρίας, • σε ασθενείς που πιθανόν υποκρίνονται κατά την εκτέλεση του ακοογράμματος για προσωπικούς σκο πούς, • σε όλα τα νεογνά που έχουν προδιαθεσικούς πα ράγοντες για ανάπτυξη βαρηκοΐας και σε αυτά που απέτυχαν στον αρχικό έλεγχο με Ωτοακουστικές Εκπο μπές • και πλέον είναι απαιτητό από τις επιτροπές των ΚΕΠΑ σε ασθενείς πάσχοντες από μεγάλου βαθμού βα ρηκοΐα, για την αντικειμενική επιβεβαίωση της ύπαρ ξης ή μη βαρηκοΐας ή/και κώφωσης. Ασθενείς, καθώς και γονείς νεογνών που επιθυ μούν τη διενέργεια των εξετάσεων αυτών μπορούν να επικοινωνούν με την ΩΡΛ Κλινική του Γ.Ν. Κομοτηνής για τον

προγραμματισμό του ραντεβού τους. Τηλέφω

154 | Μ Ι Α ΜΕΓΑ ΛΗ ΔΩΡΕ Α ΤΗΣ Ε ΝΩΣΗΣ «ΜΑΖΙ ΓΙΑ ΤΟ ΠΑΙ ΔΙ», με την ευγενική υποστήριξη του Trafigura Foundation & της Trafigura Maritime Ventures Ltd, δέχτηκε το Γενι κό Νοσοκομείο Κομοτηνής «Σισμανόγλειο». Πρόκειται για τη φορητή συσκευή Ωτοακουστικών ΕκπομπώνΑκουστικών Προκλητών Δυναμικών και ASSR, μέσω της οποίας μπορεί να πραγματοποιηθεί πλέον στο Γενικό Νοσοκομείο Κομοτηνής ο ακοολογικός έλεγχος. Οι Ωτοακουστικές Εκπομπές αποτελούν μια σύγ χρονη, μη επεμβατική διαγνωστική μέθοδο, η
χρησιμοποιείται ευρέως τα τελευταία 30
να επικοινωνίας: 2531351537
οποία ■ ΓΕΝΙΚΟ ΝΟΣΟΚΟΜΕ Ι Ο ΚΟΜΟΤΗΝ Η Σ «ΣΙΣΜΑΝ Ο ΓΛΕΙΟ» Δωρεά φορητής συσκευής για ακοολογικό έλεγχο σε παιδιά
χρόνια για τη μελέτη
της λειτουργίας του κοχλία (έσω ους), ιδιαίτε ρα στο πρόγραμμα πρώιμης ανίχνευσης της παιδικής βαρηκοΐας, που αν δεν ανιχνευθεί και αντιμετωπιστεί έγκαιρα, προκαλεί σημαντική καθυστέρηση στην ανά πτυξη του λόγου και σοβαρές διαταραχές στη διαδι κασία της μάθησης. Ο Παγκόσμιος Οργανισμός Υγείας συνιστά πλέον
& 2531351538.
ήταν ο
καρδιοχειρουργός Απόστολος Ρουμπελάκης, ο αγγει οχειρουργός, καθηγητής Ιωάννης Κακίσης, ο επιμελη τής Αναισθησιολογίας Κωνσταντίνος Παπαμιχαήλ και ο προϊστάμενος του Αιμοδυναμικού και συντονιστής ειδικότητας Νοσηλευτικής Δημόσιας Υγείας 1ης ΥΠΕ Θεόδωρος Πεσιρίδης. Η επέμβαση διακαθετηριακής αντικατάστασης αορτικής βαλβίδας (ΤΑVI) αποτελεί μια ιδιαίτερα αποτελεσματική, αλλά και απαιτητική επέμβαση που πραγματοποιείται σε ασθενείς με σοβαρή στένωση της αορτικής βαλβίδας και υψηλό χειρουργικό κίνδυ νο, που καθιστά τη χειρουργική αντικατάσταση υψηλού κινδύνου ή και απαγορευτική. Πραγματοποιήθηκε στην υβριδικών προδιαγραφών αίθουσα του Αιμοδυναμι κού Εργαστηρίου, που είναι εξοπλισμένη με εξωσω ματική κυκλοφορία. Το τελικό αποτέλεσμα ήταν άριστο και ο ασθενής
| 155 | ΕΙΔΗΣΕΙΣ ΣΤΟ Ν ΕΟ ΑΙΜΟΔΥΝΑΜΙΚΟ ΕΡΓΑΣΤ Η ΡΙΟ της Γ' Πανεπι στημιακής Καρδιολογικής Κλινικής της Ιατρικής Σχολής του ΕΚΠΑ στο ΓΝΝΘΑ «Η Σωτηρία» πραγματοποιείται από τις αρχές του 2021 πληθώρα επεμβάσεων που αφορούν όχι μόνο τη στεφανιαία νόσο, αλλά και την αντιμετώπιση δομικών καρδιακών παθήσεων (σύγκλειση ανοικτού ωοειδούς τρήματος, μεσοκολπικής επικοινω νίας, παραβαλβιδικής ανεπάρκειας,
επιτυ χημένη επέμβαση διακαθετηριακής εμφύτευσης αορ τικής βαλβίδας (TAVI) σε συμπτωματικό ασθενή με σο βαρή στένωση αορτικής βαλβίδας από τους καρδιολό γους της Γ' Πανεπιστημιακής Καρδιολογικής Κλινικής με επικεφαλής τον διευθυντή,
βαλβιδοπλαστκές αορτικής βαλβίδος, ηλεκτροφυσιολογικές μελέτες κ.ά.). Πρόσφατα πραγματοποιήθηκε και η πρώτη
καθηγητή Εμμανουήλ Βαβουρανάκη, τον καθηγητή και πρόεδρο της Ιατρικής Σχολής Αθηνών Γεράσιμο Σιάσο, τον επιμελητή καρ διολόγο Κωνσταντίνο Καλογερά και τον καρδιολόγο Ευστράτιο Κατσιάνο. Αρωγοί στην επέμβαση
μεταφέρθηκε προς παρακολούθηση και ολοκλήρωση της νοσηλείας του στη Μονάδα Εμφραγ μάτων του νοσοκομείου. ■ ΓΝΝΘΑ «Η ΣΩΤΗΡ Ι Α» Πρώτη διακαθετηριακή εμφύτευση αορτικής βαλβίδας (TAVI)

156 | ΩΣ ΑΦΕΤΗΡ Ι Α ΤΗΣ Ι ΔΡΥΣΗΣ του Θεραπευτηρίου «Ο Ευαγγελισμός» θεωρείται η προσπάθεια που έγινε το 1872 από εξήντα δύο γυναίκες για τη σύσταση του «Συλλόγου Κυριών υπέρ Γυναικείας Παιδεύσεως». Με τη συνδρομή της βασίλισσας Όλγας, εγκρίθηκε με το από 27 Απριλίου 1872 Βασιλικό Διάταγμα
νοσο κόμων. Ειδικά για τη μόρφωση των αδελφών νοσο κόμων, και πάλι με την ηθική και υλική βοήθεια της βασίλισσας Όλγας, ιδρύθηκε το 1875 το «Νοσοκομικόν ΙΣΤΟΡΙΚΗ ΑΝΑΔΡΟΜΗ Γενικό Νοσοκομείο Αθηνών «Ο Ευαγγελισμός»* Γράφει ο ΒΑΣ Ι ΛΕΙΟΣ Α. ΚΟΜΠΟΡ ΟΖΟΣ, ειδικός χειρουργός, διευθυντής Γ' Χειρουργικής Κλινικής ΓΝΑ «Ο Ευαγγελισμός»
(ΦΕΚ-ΤΑ αρ. φύλλου 22/15-6-1872) η σύσταση στην Αθήνα του «Συλλόγου Κυριών υπέρ Γυναικείας Παιδεύσεως» και τέθηκε υπό την προστασία της. Ο σκοπός του Συλλόγου ήταν φιλανθρωπικός, κοι νωφελής, καθώς και η μόρφωση των αδελφών
Γ. Μακκά και Α. Θε οφιλά, για τη συγκέντρωση οικονομικών πόρων. Η επι τροπή αυτή έκανε έκκληση στο λαό στις 25 Ιανουαρίου 1880 για τη συλλογή συνδρομών για την ανέγερση του νοσοκομειακού κέντρου. Συγχρόνως, βρίσκεται και το κατάλληλο οικόπεδο και η Ιερά Μονή Ασωμάτων ή Πε τράκη το προσφέρει τμηματικά από το έτος 1880 μέχρι το 1890. Η όλη έκταση του οικοπέδου ήταν (όπως και
σήμερα) 38.185,36 πήχεις. Στις 20 Μαρτίου του 1881 εκδόθηκε Βασιλικό Διά ταγμα, που δημοσιεύθηκε στο υπ’ αριθμόν 39/4-5-81 τεύχος της Εφημερίδος της Κυβερνήσεως, με το οποίο εγκρίθηκε η ίδρυση του θεραπευτηρίου ως φιλανθρω πικού ιδρύματος, με την ονομασία «Θεραπευτήριον ο Ευαγγελισμός», υπό την προστασία της ΑΜ βασιλίσ σης Όλγας, η οποία στη διαθήκη της, της 12ης/2/1922, παρακαλεί τη βασίλισσα Σοφία «ως και κατά την δια δοχήν ταύτης εκάστοτε βασίλισσας των Ελλήνων, να αναλάβει υπό την προστασίαν της το προσφιλές τούτο Ίδρυμα». Επιπλέον έγραφε: «Παρακαλώ την διάδοχόν μου βασίλισσαν να περιφρουρήση και προστατεύση τον “Ευαγγελισμόν” από πάσης αναμίξεως της Πολιτεί ας και των Δημοσίων Αρχών εν τη διοικήσει αυτού και τη διαχειρήσει της περιουσίας του και να μην επιτρέψη την συγχώνευσιν αυτού μετ’ άλλου Ιδρύματος και την εξυπηρέτησιν αλλοτρίων σκοπών και αναγκών». Στις 25 Μαρτίου 1881 κατατέθηκε ο θεμέλιος λίθος για την ανέγερση του νοσοκομείου από τον βασιλέα Γεώργιο Α’. Στις 25 Μαρτίου 1884, μετά από τρία έτη ακριβώς από την κατάθεση του θεμέλιου λίθου, γίνο νται τα εγκαίνια του Θεραπευτηρίου. Το 1897 αρχίζει να λειτουργεί επιστημονικό ερ γαστήριο, που αποτελείται από χημείο και ακτίνες Roentgen. Το 1903 αρχίζουν να λειτουργούν τα πρώτα εξωτερικά ιατρεία: Παθολογικό, Χειρουργικό και Γυναι κολογικό. Την πρώτη ημέρα εξετάζονται 60 ασθενείς. Ο αγιασμός ψάλλεται από τον μητροπολίτη Αθη νών Προκόπιο και ο αρχίατρος Γεώργιος Α. Μακκάς εκ φωνεί τον πανηγυρικό λόγο της ημέρας. Την ίδια μέρα, 25 Μαρτίου 1884, η επιτροπή ανέγερσης παραδίδει τυ πικώς το ίδρυμα σε εφορεία κυριών, που αποτελεί και το πρώτο Δ.Σ. του Θεραπευτηρίου και που απαρτίζεται από την πρόεδρο Ιφιγένεια Α. Συγγρού και τα μέλη: Αλεξάνδρα Παπποδώφ, Ειρήνη Ρεβελάκη, Ελένη Μαυ ροκορδάτου, Ειρήνη Σ. Μαυρομάτη, Σοφία Δάλλα και Βαρβάρα Ρέινεκ.
Στις 16 Απριλίου 1884 λειτουργεί αρχικά το Θερα πευτήριο με δύο Κλινικές, που έχουν δύναμη 48 κρε βάτια: Η Παθολογική, με διευθυντή τον Ν. Γ. Μακκά, παθολόγο, και η Χειρουργική, με διευθυντή τον οφθαλ μίατρο Ιούλιο Γαλβάνη.
Το 1885 δημοσιεύθηκε στην Εφημερίδα της Κυβερ νήσεως (ΦΕΚ-ΤΑ 85/29-7-1885) ο πρώτος «οργανι σμός» του «Ευαγγελισμού», που εγκρίθηκε με το από 24-7-1885 Βασιλικό Διάταγμα.
Το 1888 κτίστηκε το Α' Χειρουργείο και το 1897 θε μελιώθηκε ο Οίκος Αδελφών, ο οποίος τελείωσε το 1898, με δωρεά του Ανδρέα Συγγρού. Σύμφωνα με τον οργανισμό του Θεραπευτηρίου, όπως τροποποιήθηκε υπό των διαταγμάτων της 24ης

| 157 | ΙΣΤΟΡΙΑ Παιδευτήριον» για την κατάρτισή τους στην τέχνη της νοσηλείας και στις 5 Φεβρουαρίου του 1875 επικυρώ θηκε ο οργανισμός λειτουργίας του. Μόλις λειτούργησε το «Νοσοκομικόν Παιδευτή ριον», διαπιστώθηκε η αδυναμία για την εκπλήρωση του σκοπού του και κρίθηκε απαραίτητη η
του
επιτροπή
τον τότε μητροπολίτη Αθηνών Προκόπιο ως
και μέλη τους Λ. Μελά,
σύσταση ενός νοσοκομειακού κέντρου, όπου θα «διαιτώνται και θα εκπαιδεύονται» οι αδελφές νοσοκόμες. Τον Απρίλιο
1876, συγκροτήθηκε
με
πρόεδρο
Μ. Ρενιέρη,
ΠΙΝΑΚΑΣ 1 Αριθμός των αδελφών νοσοκόμων που υπηρέτησαν κατά διάφορες χρονικές περιόδους Έτος Αριθμός Έτος Αριθμός
1912 50 1948 244 1913 68 1949 238 1914 68 1950 347 1915 57 1951 352 1916 65 1952 350 1917 69 1953 456 1918 52 1954 459 1919 66 1955 452 1920 72 1956 463 1921 64 1957 487 1922 87 1958 477 1923 84 1959 497 1924 98 1960 477 1925 99 1961 525 1926 102 1962 376 1927 111 1963 396 1928 110 1964 389 1929 125 1965 379 1930 142 1966 384 1931 148 1967 399 1932 141 1968 406 1933 150 1969 430 1934 149 1970 450 1935 167 1971 465 1936 169 1972 498 1937 210 1973 441 1938 195 1974 585 1939 240 1975 523 1940 225 1976 511 1941 225 1977 484 1942 202 1978 521 1943 183 1979 539 1944 222 1980 564 1945 227 1981 544 1946 203 1982 627 1947 229 1983 691
Απριλίου 1925, της 8ης Νοεμβρίου 1930 και της 26ης Ιανουαρίου 1934, «οι πόροι του ιδρύματος αποτε λούνται εκ των εισοδημάτων της περιουσίας αυτού, εκ τακτικών και εκτάκτων συνδρομών ή κρατικών και
δημοτικών εισφορών, εκ δωρεών, κληρονομιών και κληροδοτημάτων και εισπράξεως δικαιωμάτων νοση λείας ή άλλων συναφούς φύσεως». Το ιατρικό προσωπικό του Θεραπευτηρίου απο τελείτο από τους διευθυντές των Κλινικών και Εργα στηρίων, τους επιμελητές και τους βοηθούς α’ και β’ τάξεως. Η θητεία των διευθυντών ήταν πενταετής, δυ νάμενη να ανανεώνεται με απόφαση του Δ.Σ. Η θητεία των επιμελητών ήταν τριετής, επίσης με δυνατότητα ανανέωσης. Απαραίτητη προϋπόθεση για την εκλογή τους ήταν να είναι διδάκτορες Ιατρικής ελληνικού ή ξένου πανεπιστημίου και να έχουν το δικαίωμα άσκη σης του ιατρικού επαγγέλματος επί τρία τουλάχιστον έτη, εκ των οποίων τα δύο τουλάχιστον να είναι προ ϋπηρεσία σε κλινική του ιδίου ή άλλου νοσοκομείου. Οι βοηθοί ήταν α’ και β’ τάξεως, τα προσόντα των οποίων κανονίζει το Δ.Σ. Τα πρώτα 15 έτη της λειτουργίας του ιδρύματος, οι γιατροί ήταν έξι (3 παθολόγοι και 3 χειρουργοί). Ο αριθμός των κλινών κατά το 1884 ήταν 48. Το 1885 οι κλίνες ανήλθαν σε 95. Το 1887 ο αριθμός των κλινών ήταν 111. Δύο έτη αργότερα ο αριθμός των κλι νών ανήλθε σε 133, λόγω επισυμβάσης επιδημίας και έγινε εγκατάσταση κεντρικής θερμάνσεως στα κτίρια του Θεραπευτηρίου. Το 1902 ο αριθμός των κλινών ήταν 215. [Ο αριθμός των νοσηλευομένων ασθενών ήταν 145, εκ των οποίων οι 100, όσος ήταν ο αριθμός των κλινών των κληροδοτημάτων, νοσηλεύονταν δω ρεάν (Συνεδρίαση 265 του Δ.Σ. της 14/4/1900).] Πού χειρουργούσαν κατά τα πρώτα χρόνια δεν φαίνεται από τα πρακτικά. Θα πρέπει να ήταν κάποιος κοινός χώρος, δεδομένου ότι στην 118η συνεδρίαση του Δ.Σ. της 9ης/2/1888 αναφέρεται ότι «την 25η Μαρ τίου θα τεθεί ο θεμέλιος λίθος της αιθούσης των εγχει ρήσεων», που τελικά πραγματοποιήθηκε την 26η Μαρ τίου του 1888. Το έργο ανέλαβε ο αρχιτέκτων Μπούκι ος, «επί τη βάσει του Γαλλικού διαγράμματος, όπερ τη προτάσει του ιατρού κ. Γαλβάνη, εγένετο αποδεκτόν». Η δαπάνη ανήλθε σε 27.660,89 δραχμές. Η κατάσταση στο χειρουργείο περιγράφεται αρ κετά καλά στη συνεδρίαση 206 του Δ.Σ. (6/11/1895), στην οποία ο χειρουργός κ. Γαλβάνης «παρεκάλεσεν την εφορείαν να σκεφθεί και να αποφασίσει περί του καλλιτέρου τρόπου θερμάνσεως του εγχειρητηρίου, δι ότι η πήλινη θερμάστρα ήτις υπάρχει νυν δεν θερμαίνει όσο είναι αναγκαίον εν καιρώ των εγχειρήσεων». Κατά το 1890 πραγματοποιήθηκε η εγκατάσταση κεντρικής θερμάνσεως και το 1894 η εγκατάσταση απολυμαντικού κλιβάνου.
Από το 1895, με τη βοήθεια φιλανθρωπικών συν δρομών, ξεκινά η νέα οικοδομική εξέλιξη του Θερα πευτηρίου. Έτσι, το 1895 ανεγέρθη το περίπτερο του
158 |
Αγίου Στεφάνου. Το 1898 τελέσθηκαν τα εγκαίνια του Οίκου των Αδελφών, που περατώθη το 1929. Από το 1938 έως το 1953 το κτίριο της Σχολής Αδελφών χρη
σιμοποιήθηκε καθ’ ολοκληρίαν για νοσηλεία ασθενών
και απεδόθη στη Σχολή το 1953. Στον Πίνακα 1 φαίνεται ο αριθμός των αδελφών νοσοκόμων που υπηρέτησαν κατά διάφορες χρονικές περιόδους. Σήμερα, οι προβλεπόμενες θέσεις του νοσηλευτι κού προσωπικού ανέρχονται σε 1.298 και υπηρετούν 1.045 νοσηλεύτριες και νοσηλευτές. Το 1916 αποπερατώθηκε η πτέρυγα «Ανδρέου Συγ γρού» και ο δεύτερος όροφος του Αγίου Στεφάνου. Το 1927 άρχισε η λειτουργία της κάτω βορείας πτέρυγας. Το 1929 αποπερατώθηκε και άρχισε να λειτουργεί το Β' Χειρουργείο. Το 1930 αποπερατώθηκε η άνω βόρεια πτέρυγα, αυξάνοντας τον αριθμό των κλινών σε 514. Το 1939 άρχισαν οι εργασίες για την ανέγερση της πτέρυγας «ΑΧΕΠΑ», που διεκόπησαν από τον πόλεμο του 1940 και την Κατοχή. Το 1950 έγιναν τα εγκαίνια της πτέρυγας «ΑΧΕΠΑ» (8 όροφοι) και το 1964 έγιναν τα εγκαίνια του 9ου, του 10ου ορόφου και του δώμα τος. Το 1969 εγκαινιάστηκαν τα νέα χειρουργεία. Σημει ωτέον ότι στο συγκρότημα αυτό συμπεριελήφθη και το Τμήμα Κεντρικής Αποστείρωσης, που είναι το πρώτο κέντρο αποστείρωσης που λειτούργησε στην Ελλάδα με αυτόματα μηχανήματα καθαρισμού των εργαλείων, ενώ έγινε κέντρο για την εκπαίδευση πολλών αδελφών διαφόρων νοσοκομείων της χώρας. Το 1977 έγινε η θεμελίωση της νέας πτέρυγας των «Ναυτικών», με δωρεά του Ιωάννη Διαμαντή Πατέρα. Τα εγκαίνιά της έγιναν το 1983 και αποδόθηκε πλήρως το 1986. Το 2004 αποδόθηκε η νέα πτέρυγα των εργαστη ρίων και το 2016 η πτέρυγα των νέων χειρουργείων (22 αίθουσες), που ανεγέρθηκε με δωρεά της Εθνικής Τραπέζης. Στο νοσοκομείο υπάρχουν δύο Μονάδες Εντατικής Θεραπείας, Μονάδα Αυξημένης Φροντίδας, Μονάδα Τεχνητού Νεφρού, Μονάδα Μεταμοσχεύσεων Συμπα γών Οργάνων και Μονάδα Μεταμοσχεύσεως Μυελού των Οστών, καθώς και σημαντικός αριθμός εξειδικευ μένων τμημάτων. Αποτέλεσμα
ΠΙΝΑΚΑΣ 2 Αριθμός κλινών κατά την ανάπτυξη του νοσοκομείου Έτος Κλίνες Έτος Κλίνες
1884 48 1938 630 1885 95 1942 654 1888 111 1947 680 1889 133 1953 1.050 1890 133 1954 1.050 1891 133 1960 1.099 1893 138 1966 1.228 1899 171 1970 1.214 1902 215 1972 1.126 1916 321 1974 1.215 1920 320 1977 1.172 1924 400 1979 1.152 1926 420 1980 1.133 1927 474 1981 1.103 1930 514 1982 1.089 1933 546 1984 1.089 1934 550 2017 950
9/10/1902 έως 1/4/1914. Την 1η/4/1914 ιδρύθηκαν η Α’ και η Β’ Χειρουργική Κλινική. Διατελέσαντες διευθυντές της Α’ Χειρουργικής Κλι νικής ήταν κατά χρονολογική σειρά οι:
1. Μ. Μάκκας (1914-1930)
2. Γ. Καραγιαννόπουλος (1931-1942)
3. Δ. Ξανθοπουλίδης (1943-1956) 4. Ν. Γιαννόπουλος (1957-1962)
5. Μ. Παρασκευάς (1963-1968) 6. Π. Μίχας (1969-1982) 7. Π. Σακελλαριάδης (1983-1985)
8. Π. Γιαννόπουλος (1986-1989)
9. Ε. Χατζηγιαννάκης (1989-2002)
10. Σ. Μπαράτσης (2002-2007) 11. Σ. Δρακόπουλος (2007-2016) 12. Β. Βουγάς (2017 - ) Διατελέσαντες διευθυντές της Β' Χειρουργικής Κλι νικής ήταν κατά χρονολογική σειρά οι:
1. Ν. Κωτσονόπουλος (1914-1926)
2. Ν. Βρυώνης (12/7/1926 - 10/9/1926)
3. Γ. Καραγιαννόπουλος (1926-1930)
4. Ν. Σμπαρούνης-Τρίκορφος (1931-1941)
μέχρι την 1η/4/1914 υπήρχε μία Χειρουργική Κλινική, στην οποία διετέλεσαν διευθυντές οι: Γαλβάνης Ιούλιος από 25/3/1884 έως 2/9/1901 και Γερουλάνος Μαρίνος από
5. Χ. Τουλ (1942-1943)
6. Α. Μάνος (1944-1970)
7. Ο. Παπαστρατής (επιμελ.) (1971)
8. Α. Παπαϊωάννου (1972-1982)
| 159 | ΙΣΤΟΡΙΑ
όλων αυτών των επεκτάσεων, ήταν και η προοδευτική αύξηση των κλινών του νοσοκομείου (Πίνακας 2). ΔΙΑΤΕΛ
ΚΛΙΝΙΚ Ω Ν Από
Ε ΣΑΝΤΕΣ ΔΙΕΥΘΥΝΤ Ε Σ ΤΩΝ ΧΕΙΡΟΥΡΓΙΚ Ω Ν
τις ιδρύσεως του Θεραπευτηρίου και
Το νοσοκομείο κατά το έτος 1884.

9. Α. Κάτσας (1983-1989)
10. Χ. Πισιώτης (1989-1995) 11. Π. Γιαννόπουλος (1995-2003)
12. Γ. Παπαγεωργίου (2003-2012)
13. Σ. Κλημόπουλος (2013-2017)
14. Γ. Στυλιανίδης (2018 - ) Η Γ' Χειρουργική Κλινική ιδρύθηκε το 1926, με δι ευθυντή τον Α. Παππά, αλλά το ίδιο έτος ανεστάλη η λειτουργία της και επανιδρύθηκε το 1935 με διατελέ σαντες διευθυντές τους κάτωθι:
1. Π. Κόκκαλης (1935-1942) 2. Κ. Παληός (1943-1964) 3. Ν. Γεωργιάδης (1965-1982) 4. Δ. Κιντζονίδης (1983-1989) 5. Σ. Μηλίγγος (1989-1992) 6. Γ. Διαμαντόπουλος (1992-2004) 7. Θ. Μαυρομμάτης (2005 - ) Η Δ' Χειρουργική Κλινική ιδρύθηκε το 1965 με διευ θυντή τον Π. Μίχα. Η λειτουργία της ανεστάλη το 1968 και επανιδρύθηκε το 1985 με την έναρξη του ΕΣΥ, με διατελέσαντες διευθυντές τους κάτωθι: 1. Γ. Παρασκευάς (1986-1989) 2. Ι. Πουλαντζάς (1989-1995) 3. Δ. Κιντζονίδης (1995-2003) 4. Σ. Στυλογιάννης (2004-2006) 5. Σ. Πρίγγουρης (2007-2013) 6. Χ. Κονταξής (2014) 7. Ν. Ανδρομανάκος (2015 - 14/3/2017)
8. Β. Κομπορόζος (2017 - ) Σημείωση: Το 1943-1945 λειτούργησε στο νοσοκο
μείο Πανεπιστημιακή Χειρουργική Κλινική με διευθυντή τον Β. Κούργια. Το Θεραπευτήριο «Ο Ευαγγελισμός» αποτελούσε Νομικό Πρόσωπο (Ίδρυμα Κοινωφελές) Ιδιωτικού Δικαί ου, όπως αυτό αναγνωρίστηκε με τις υπ’ αριθ. 98/1942, 347/1944 και 1133/1957 αποφάσεις του Συμβουλίου της Επικρατείας και την υπ’ αριθ. 168/1949 απόφαση του Αρείου Πάγου. Με το υπ’ αριθ. 305/17-8-1983 9108α0, ο «Ευαγγελισμός» έγινε Νομικό Πρόσωπο Δημοσίου Δι καίου, που υπάγεται στις διατάξεις του Ν.Δ. 2592/53. Από το 2012 λειτουργεί ξεχωριστό Τμήμα Επειγό ντων Περιστατικών (ΤΕΠ), στελεχωμένο με διευθυντή και δέκα ειδικευμένους επιμελητές (4 χειρουργούς, 4 παθολόγους και 2 καρδιολόγους). Οι υπηρετούντες ειδικευμένοι χειρουργοί σε κάθε Κλινική από το 1985, σύμφωνα με το οργανόγραμμα του Θεραπευτηρίου, είναι ο διευθυντής, δύο επιμελη τές Α’, τρεις επιμελητές Β’ και εννέα ειδικευόμενοι. Σύμφωνα με τον νέο Οργανισμό του νοσοκομεί ου (ΦΕΚ 3485/31-12-2012), προβλέπονται 959 θέσεις ιατρικού προσωπικού: 449 ειδικευμένων ιατρών ΕΣΥ, εκ των οποίων 23 γενικοί χειρουργοί και 510 ειδικευό μενοι ιατροί. Σήμερα υπηρετούν συνολικά 803 ιατροί όλων των ειδικοτήτων (318 ιατροί ΕΣΥ, 49 επικουρικοί και 436 ειδικευόμενοι). Ο αριθμός των κλινών σε κάθε Χειρουργική Κλινι κή, από το 1985, είναι: 27 κλίνες Γ’ θέσεως και 7 κλίνες Β’ θέσεως. Ο αριθμός και το είδος των χειρουργικών επεμ βάσεων ήταν συνάρτηση της χρονικής περιόδου, της
160 |
Το νοσοκομείο κατά το έτος 1934.

ανάπτυξης των κλινών του νοσοκομείου και κατά συ νέπεια των χειρουργικών κλινών, της εξέλιξης της Χει ρουργικής και της ιδρύσεως κλινικών χειρουργικών ειδικοτήτων. Από το 1970 αναπτύχθηκε σημαντικά ο τομέας της Χειρουργικής Ογκολογίας, η Χειρουργική του μαστού, των χοληφόρων και του παγκρέατος, του παχέος εντέ ρου, του οισοφάγου, των φλεγμονωδών νόσων του εντέρου από το 1985, η Λαπαροσκοπική Χειρουργική από το 1989, η Χειρουργική της ακράτειας από το 1995, η Χειρουργική των μεταμοσχεύσεων συμπαγών οργά νων από το 1989, οι μεταμοσχεύσεις καρδιάς από το 1990 έως το 2000. Σήμερα, ο χειρουργικός τομέας καλύπτει όλο το φάσμα των επεμβάσεων Γενικής Χει ρουργικής, καθώς και επεμβάσεων από τα τμήματα των χειρουργικών ειδικοτήτων. Ήδη από τις αρχές του 20ού αιώνα άρχισε η ανά πτυξη κλινικών χειρουργικών ειδικοτήτων, με πρώτη τη Γυναικολογική Κλινική, η οποία ιδρύθηκε το 1902, λειτούργησε μέχρι το 1925, επανιδρύθηκε το 1933 και λειτούργησε μέχρι το 1935, όταν ανεστάλη η λειτουρ γία της και επανιδρύθηκε το 1951, για να ανασταλεί εκ νέου η λειτουργία της το 1998. Η Ουρολογική Κλινική ιδρύθηκε το 1927, ανεστάλη η λειτουργία της το 1933 και επανιδρύθηκε το 1935. Η ΩΡΛ Κλινική ιδρύθηκε το 1933. Η Οφθαλμολογική Κλινική ιδρύθηκε το 1944. Η Νευροχειρουργική Κλινική ιδρύθηκε το 1951. Η Θωρακοχειρουργική Κλινική ιδρύθηκε το 1951 και το 1957 προστέθηκαν το Καρδιοχειρουργικό και το
Αγγειοχειρουργικό Τμήμα και μετονομάσθηκε σε Χει ρουργική Θώρακος, Καρδιάς και Αγγείων. Από το 1986 ιδρύθηκαν δύο Καρδιοχειρουργικές Κλινικές, οι οποίες από το 2012 συγχωνεύθηκαν σε μία και συμπεριέλαβαν το Θωρακοχειρουργικό και το Αγ γειοχειρουργικό Τμήμα. Από το 1944 έως το 1950 λειτούργησε η Χειρουρ γική Παίδων και η Ορθοπαιδική Κλινική. Το 1950 ανε στάλη η λειτουργία της και το 1970 επανιδρύθηκε ως Ορθοπαιδική Κλινική, η οποία δύο έτη αργότερα χωρί στηκε στην Α’ και τη Β’ Ορθοπαιδική Κλινική, οι οποίες το 2012 συγχωνεύθηκαν σε μία. Το 1984 ιδρύθηκε η Γναθοχειρουργική Κλινική. Σήμερα, ο «Ευαγγελισμός» διαθέτει 34 Τμήματα (Κλινικές), εκ των οποίων 12 είναι χειρουργικά τμήμα τα, μεταξύ των οποίων 4 τμήματα Γενικής Χειρουργι κής. Ο αριθμός των κλινών του ΓΝΑ «Ο Ευαγγελισμός» σήμερα ανέρχεται σε 950. Ο αριθμός των κατ’ έτος νοσηλευομένων ασθενών ανέρχεται κατά μέσο όρο σε 55.000 - 60.000, εκ των οποίων 25% είναι έκτακτες εισαγωγές. Ο αριθμός των εκτελουμένων χειρουργικών επεμ βάσεων ανέρχεται σε 10.000 περίπου κατ’ έτος και ο αριθμός των επεμβάσεων Γενικής Χειρουργικής σε 3.500 - 4.000 κατ’ έτος. ■ *Απόσπασμα από το βιβλίο «Η ΧΕΙΡΟΥΡΓΙΚΗ ΤΩΝ ΕΛΛΗΝΩΝ ΔΙΑ ΜΕΣΟΥ ΤΩΝ ΑΙΩΝΩΝ» των εκδόσεων ΜΙΛΗΤΟΣ.
| 161 | ΙΣΤΟΡΙΑ

Φιλελλήνων 3, 10557, Σύνταγμα, Αθήνα press@spiroueditions.gr nextdeal.gr Στο ΕΠΟΜΕΝΟ ΤΕΥΧΟΣ ΙΑΝΟΥΑΡΙΟΣ 2023 Αποκτήστε το έντυπο περιοδικό και κρατήστε το ή διαβάστε ΙΝΤΕΡΝΕΤΙΚΑ όσα σας ενδιαφέρουν στο nextdeal.gr ▶ Τα Νοσοκομεία Παίδων και οι Παιδιατρικές Κλινικές στον δημόσιο και τον ιδιωτικό τομέα. ▶ Τα εμβόλια που είναι απαραίτητα για τα παιδιά και τους εφήβους. ▶ Οι λοιμώξεις που προσβάλλουν τα παιδιά. ▶ Η παιδική παχυσαρκία και ο παιδικός διαβήτης. ▶ Ασφαλιστικά προγράμματα που αφορούν τα παιδιά. …Και πολλά άλλα ΟΛΑ ΟΣΑ ΠΡ Ε ΠΕΙ ΝΑ ΓΝΩΡ Ι ΖΟΥΜΕ ΓΙΑ ΤΑ Θ Ε ΜΑΤΑ ΥΓΕ Ι ΑΣ ΠΟΥ ΑΦΟΡΟΥ Ν ΤΑ ΠΑΙΔΙ Α